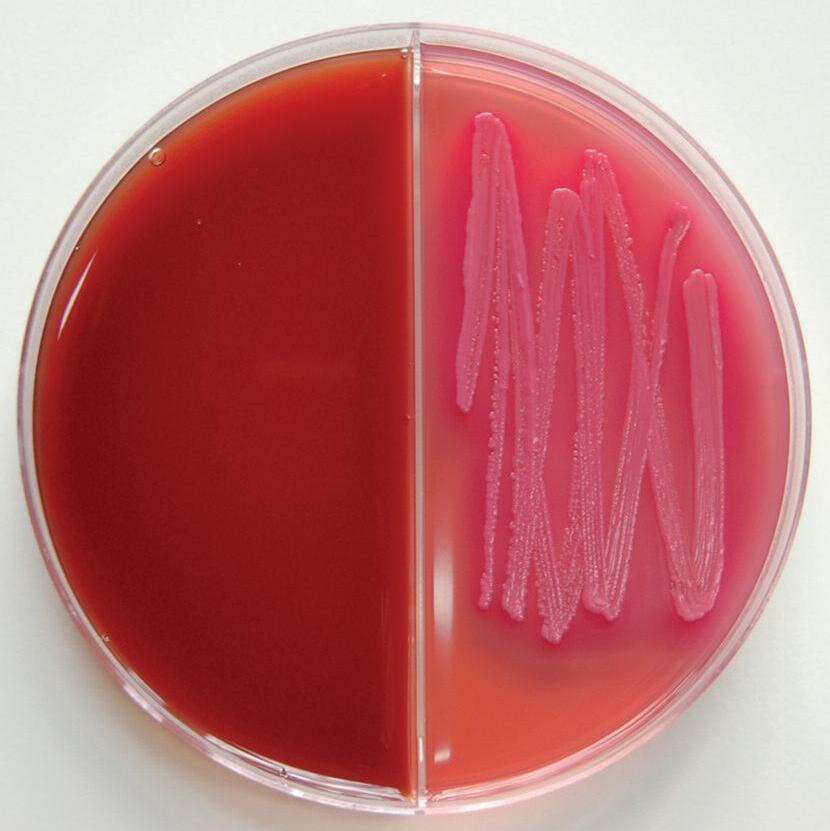

Julio/Agosto 2018 - XXXVIII Año - Núm. 226

• Escuela de Preparadores CONAFE 2018
• Concurso Regional de Cantabria

• Ganadería More Holstein
• Resumen de la Memoria de Actividades CONAFE 017
• Resultados de la evaluación genética CONAFE/MACE
• Bienestar de los trabajadores en la granja
• Reducción del uso de antibióticos
• Silos horizontales y verticales
• Mycoplasma bovis


Julio/Agosto 2018 nº 226
Tercera página....................................................................................3
Noticias del sector..............................................................................4
Calendario de actuaciones del Concurso Nacional....................6
REPORTAJES
•13º Escuela de Preparadores CONAFE’18...................................8
•Concurso Regional de Cantabria
23º Memorial José Ruiz Ruiz.........................................................16
•Concursos locales:
- 24º Concurso de Feiradeza.....................................................24
- 19º Campeonato de ganado frisón de Irún ........................25
- 24º Concurso de ganado frisón del Valle de Carriedo.......25
•Ganadería More Holstein............................................................26
OPINIÓN
• Javier Blanco, jefe del Servicio de Clínica de Rumiantes del Hospital Clínico Veterinario UCM ..........................................32
CONAFE
• Vacas Medalla de Oro y Vacas Estrella (Evaluación CONAFE junio 2018)..............................................38
•Resumen de la Memoria CONAFE 2017..................................42
GENÉTICA
•Pruebas CONAFE-MACE junio/agosto’18................................54
•Análisis del nivel genético de la granja.
Dpto. Técnico de CONAFE .........................................................60
•Evaluaciones genómicas de las mejores novillas genómicas con edad inferior a 18 meses.
Dpto. Técnico de CONAFE..........................................................63
•Nuevos toros en reparto..............................................................66
ESCUELA DE JUECES SOBRE PAPEL
•Resultados sección 86ª.................................................................68
•Sección 87ª....................................................................................69
CALIFICACIÓN
•Animales calificados EX y MB durante los meses de mayo y junio de 2018...................................................................72
ANEMBE RESPONDE
• Bienestar de los trabajadores en la granja. M. V. Morales 84
TEMARIO
• “Cultivo en granja” y reducción del uso de antibióticos. L.M. Jiménez .............................................................86
• Conservación de forrajes (VIII): Silos horizontales y verticales A. Callejo .....................................................................92
• Mycoplasma bovis, una bacteria de moda.
J.V. González ...................................................................................98
y además...
•Guía Comercial...........................................................................102
•Índice de anunciantes...............................................................102




g
p.8 p.16 p.26 p.92
www.conafe.com

Valoración genómica de hembras para seleccionar las futuras mejores productoras de la explotación.
El genotipado de las novillas permite tomar decisiones rápidas y fiables sobre qué animales comprar o vender, detectar enfermedades genéticas, corregir errores de genealogía oconsanguinidad...
ConafeMat es un programa de acoplamientos al que se puede acceder a través de SinBad.
Su objetivo es facilitar al ganadero la selección de los toros más adecuados para sus objetivos de selección.
Programa de recogida de información sobre salud podal para el control y prevención de cojeras.
Con la colaboración de un grupo de podólogos, se recogen datos sobre dermatitis digital e interdigital, úlcera plantar, flemón interdigital, lesión de la línea blanca, laminitis crónica e hiperplasia interdigital.


Las benjaminas de More Holstein (Bétera, Valencia) toman su merienda
PUBLICACION BIMESTRAL AÑO XXXVIII NUM. 226
Julio/Agosto 2018
Directora: Pilar López Caño
Subdirector: Baldomero Fernández Fernández
Redactor: Manuel Caro Jiménez
Diseño y Publicidad: Departamento propio
Suscripciones: Charo García Tovar
Redacción, Publicidad y Suscripciones Revista Frisona Española - CONAFE Apdo. de Correos 31 28340 Valdemoro (Madrid) Ctra. de Andalucía Km. 23,600
Tlfs: 91 895 24 12/62/68 - Fax: 91 895 14 71
Correo Electrónico: publicidad@revistafrisona.com suscripciones@revistafrisona.com conafe@conafe.com
Páginas Web: www.revistafrisona.com www.conafe.com
Precio Suscripción 2018
España.............48 Euros (IVA incluido) Europa..............77 Euros (IVA incluido) Resto Mundo...90 Euros (IVA includio)
Edita: Confederación de Asociaciones de Frisona Española
Junta de Gobierno de CONAFE
Presidente:
Germán de la Vega Delgado, AFCA
Vicepresidente:
José Emilio García Suárez, ASCOLAF
Secretario:
José Carlos Vega Rodríguez, FEFRIGA
Tesorero:
José Antonio Hernández Martín, FEFRICALE
Interventor:
Jaime Olascoaga Enseñat, AFB
Vocales:
Antonio García Ruiz, AFA
Benita Irurita Loiarte, AFNA
Carlos Manuel Sánchez García, AFRIARA
José García Rojas, AFRICAMA
Miguel González de Parla, AFRIDEMA
Valentín Novales Elejalde, EFRIFE
Josep Rebés González-Nandín, FEFRIC
Sofia Alday Martínez de Cestafe, Directora Gerente
Impresión: Monterreina
ISBN. 9211-3767
Depósito Legal: M-5.568-1981
CONAFE no se responsabiliza del contenido de los artículos, anuncios y otros escritos firmados, así como tampoco, necesariamente, comparte los criterios de sus autores. Se permite la reproducción total o parcial de los artículos, informaciones y fotografías de esta revista citando el origen.
tercera página
Leche cruda
El 17 de julio, la Generalitat de Cataluña aprobó el Decreto que autoriza la venta directa de leche cruda de vaca y que regula la actividad comercial de este producto entre el ganadero y el consumidor final Según el comunicado del gobier no autonómico, esta nor mativa pretende “ayudar a la diversificación” de la producción ganadera catalana, un sector “ muy tecnificado y altamente profesionalizado” y “fomentar la economía circular, la valorización de los productos del territorio y la venta de proximidad”
Que el consumo doméstico de leche cruda es una moda –y como tal, será probablemente pasajera– no se le escapa a nadie y como sucede con otras tendencias, podemos caer en el error de no darle mayor importancia Sin embargo, sí la tiene Desde hace años venimos hablando del consumidor como el cuarto eslabón –junto con ganaderos, industria y distribución– del sector lácteo Por él y para él, el productor de leche se esfuerza cada día en obtener un producto que cumpla todos los requisitos sanitarios y organolépticos que hagan de la leche y los productos lácteos unos artículos de calidad y absoluta seguridad alimentaria Años de trabajo e inversión en instalaciones, maquinaria, for mación, asesoramiento, control lechero para que un influencer decida que es más foodie tomar la leche de la ubre al vaso porque es más “auténtico”
La comunidad científica está alertando del riesgo que implica este consumo y afir man que solo la pasteurización y otros procesos tér minos aseguran la completa eliminación de los patógenos en la leche Advierte también este colectivo sobre el peligro de pasar al consumidor la responsabilidad de tratar la leche cruda adecuadamente Es decir, hervirla antes de su consumo y conservarla a una temperatura de entre 1 y 4 grados centígrados Si preferimos los bricks de leche UHT porque se almacenan estupendamente y son de larga duración; si en los lineales los envases de leche fresca ocupan un espacio testimonial; si las máquinas expendedoras de leche pasteurizada no acaban de encontrar su lugar por falta de demanda Cuesta pensar que vamos a ir todos los días a comprar leche cruda a la ganadería más cercana y vamos a dedicar el tiempo y el esfuerzo en prepararla Sin embargo si la nor mativa está ahí en respuesta a la realidad del mercado, será verdad
El escenario legislativo, por otro lado, es algo confuso A nivel nacional existe un Real Decreto (640/2006), que prohíbe el suministro directo por parte del productor de pequeñas cantidades de leche cruda al consumidor final o a establecimientos de venta al por menor que suministran directamente al consumidor final A nivel europeo, el Reglamento (CE) 853/2004 sí per mite este suministro si el ganadero se convierte en una industria y cumple con deter minados requisitos en cuanto a controles microbiológicos, ausencia de ciertas enfer medades, etiquetado, etc Nor mativa a la que se suma ahora la catalana y la reglamentación que parece estar preparando el Ministerio de Agricultura
Partiendo de la premisa de que toda iniciativa dirigida a abrir nuevas líneas de negocio y a maximizar la rentabilidad de la ganadería, es buena La promoción del consumo de leche y productos lácteos es vital para el sector y si la venta de este tipo de leche –convenientemente reglamentada– y su consumo –convenientemente realizado– hacen que la demanda aumente y facilitan que algunos ganaderos encuentren un nicho de mercado para su producto, bienvenida sea
Por supuesto, mejor esta campaña que la promovida por algunas organizaciones vegetarianas (“Semana Sin Lácteos”) que indica como alter nativas las bebidas de soja, almendra o avena –calificadas como leche (¡!) de plantas– y cuyos organizadores califican a las vacas lecheras como animales inteligentes, afectuosos e inquisitivos que tienen vidas cortas en las que soportan el estrés y las condiciones que muchos consideran inhumanas” como el ordeño diario que, “ se cree, es el equivalente energético de correr una maratón todos los días”
Como dice el refrán, ni tanto, ni tan calvo Debemos ser prudentes e insistir desde todos los estamentos en la for mación del consumidor y en facilitarle una infor mación veraz. De nada servirá que produzcamos leche de comprobada calidad si, en el peor de los casos, ocurre una intoxicación. Entonces, lamentablemente, la responsabilidad no recaerá sobre el consumidor, sino en el ganadero
noticias del sector
Jornadas de formación de CONAFE
Asociación Fr isona de Ávila
Los ganaderos de la Asociación Frisona de Ávila (AFRIAB), perteneciente a FEFRICALE (Federación Frisona de Castilla y León), participaron el martes 3 de julio en una jor nada de for mación práctica sobre el programa CONAFEMAT, impartida por José Antonio Jiménez del Dpto Técnico de CONAFE en la localidad abulense de San Pedro del Arroyo.


Asociación Fr isona Balear
Días después, ll miércoles 18 de julio, el responsable del Dpto Técnico de la Confederación dirigió una jor nada sobre la aplicación de la genómica en las granjas de vacuno de leche para la Asociación Frisona Balear (AFB) (foto sobre estas líneas) que se llevó a cabo en la Granja del Consell Insular de Menorca.


La jor nada sobre genómica se completó con una for mación sobre el programa de acoplamientos para la raza frisona CONAFEMAT, que se impartió por la tarde en la Escuela de Capacitación Agraria menorquina Astur iana de Control LecheroAsociación Fr isona (ASCOLAF), Finalmente José Antonio Jiménez impartió el 30 de julio en las instalaciones del Centro de Selección de ASCOL en Gijón, una jor nada sobre aplicación de la genómica en las granjas de vacuno de leche para el personal de Asturiana de Control LecheroAsociación Frisona (ASCOLAF), a la que asistieron unas 30 personas La jornada se completó durante la tarde con una nueva charla de for mación sobre genómica para los ganaderos de la zona occidental de Asturias, que
se celebró en la cooperativa Campoastur Los ganaderos de esta cooperativa (foto abajo) mostraron un gran interés por las valoraciones que saldrán en próximos meses el Programa de Salud Podal I-SAP, nueva evaluación genética para la salud podal de la cabaña bovina en España Tener un programa de mejora genética competitivo en cuanto a calidad de la infor mación recogida (genealogía, control de rendimientos, calificaciones y otros) y de la fiabilidad de las evaluaciones publicadas tiene como resultado un progreso genético patente y, por tanto, la obtención de reproductores machos y hembras realmente mejoradores gracias a la genómica Disponer del servicio de genotipado en CONAFE, ahora permite a los ganaderos aprovechar al máximo las ventajas de esta herramienta.

Javier Álvarez Lastra, juez del 39º Concurso Nacional CONAFE’18
Álvarez Lastra (Ribadeo, Lugo), es Ingeniero Técnico Agrícola en Explotaciones Agropecuarias en la Escuela Politécnica uperior de la USC en Lugo En la actuadad trabaja como encargado en el equipo del Centro de Investigación Blanca From The Pyrenees, manejando un rebaño de 347 cabezas de Pondeosa Holsteins, incluido dentro del proyecto Combina esta labor con la gestión de una granja familiar de 24 cabezas de aptitud cár nica
Es habitual participante en los concursos mor fológicos en distintos ámbitos de coordinación y preparación. Ha for mado parte de equipos de trabajo tanto a nivel nacional como inter nacional, en las Confrontaciones Europeas de Friburgo 2013 y Colmar 2016
Juez de CONAFE en activo desde 2006, for ma parte del panel oficial de Jueces Europeos EHRC desde 2013 En la actualidad for ma parte del Comité de Jueces de CONAFE Ha juzgado certámenes de distintos ámbitos, destacando el Catalán 2008 y el Nacional de Primavera CONAFE 2011 A nivel inter nacional ha juzgado en Portugal y Suecia También ha participado como profesor en las Escuelas de Preparadores de CONAFE y la XXII Escuela de Jueces Ganaderos FEFRIGA 2017, entre otras.
Josep Usall y Rodié, nuevo Director General del IRTA
El pasado 10 de julio, el Consejo de Administración del IRTA propuso a Josep Usall como nuevo Director General del Instituto de Investigación y Tecnología Agroalimentarias (IRTA), tomando el relevo de Josep M Monfort Bolívar, quien ha estado al frente del Instituto desde septiembre de 2008 Josep Usall y Rodié es Ingeniero Agrónomo por la UPC y se incorporó al IRTA como investigador en 1992 Ha sido director del Servicio Técnico de Poscosecha del IRTA desde 2002 y Jefe del programa de Poscosecha desde 2012


4 Frisona Española 226 j/a
noticias del sector
CONAFE alcanza el genotipo 100 000 de raza frisona


El consejero de Medio Rural, Pesca y Alimentación, Jesús Oria y el presidente de la Asociación Frisona de Cantabria (AFCA) Ger mán de la Vega renovaron a mediados de julio el convenio de colaboración mediante el cual la Consejería aportará en este 2018 y mediante subvenciones nominativas la cantidad de 25 000 euros para el Concurso Regional de ganado Frisón y otros 40 000 euros para apoyar la labor de AFCA en el control de la calidad de la leche y mejora genética
Jesús Oria resaltó la contribución del sector lácteo a la economía y al sostenimiento demográfico de los pueblos de Cantabria indicando que el Gobierno seguirá apoyando a los productores que apuestan por la mejora genética de su ganado frisón
Por su parte, el presidente de la Asociación Frisona de Cantabria explicó que este convenio les per mite no solamente continuar con el programa de mejoras sino también estar al día sobre las novedades a nivel internacional, implantando cuestiones como la mejora genética a través de la genómica y todos los caracteres nuevos que se van implementando para poner en marcha nuevos programas de control genómico.
Asimismo, el Gobierno de Cantabria y AFCA están estudiando la puesta en marcha de una orden para facilitar y promocionar el genotipado de las hembras, menores de 24 meses, que for man parte del control lechero La orden podría estar en marcha en los próximos meses para aplicarse en ganaderías de control lechero que hayan hecho su prueba genómica en el plazo que marque dicha orden.
El Gobierno de Cantabria renueva su apoyo a AFCA para la mejora genética de la raza frisona

Ca lenda rio
Septiembre
22 XXXV Concurso Regional de Ganado Vacuno Selecto. Pola de Siero. Asturias
28/30 39º Concurso Nacional de la Raza Frisona CONAFE 2018
29 18º Campeonato Nacional de Manejadores CONAFE 2018 Gijón, Asturias
Octubre
2/6 World Dairy Expo Madison (EE UU )
26/27 4º Curso de Podología CONAFE-I-Sap Ribadeo, Lugo
CONAFE alcanzó en el mes de julio el genotipo 100 000 de su base de datos de animales de la raza frisona, que corresponde concretamente a la ter nera Gurí Coconut G-Force 7093 con nº de registro ESPH1704528912 perteneciente a la ganadería Mas Gurí SAT Nº 4756 situada en la localidad gerundense de Cassá de la Selva. En el número total se incluye lo genotipado en España y el extranjero
El genotipado per mite obtener una infor mación mucho más precisa del animal para obtener reproductores machos y hembras mejores genéticamente Entre otras cosas, obtendremos, si es compatible con su padre y con su madre, la infor mación de sus recesivos y otros genes de interés y lo más importante su prueba genómica para los distintos caracteres combinada con el índice de pedigrí
Los 100 000 genotipos alcanzados por CONAFE se reparten en un 70% de machos y un 30% de hembras Un 36% corresponde a animales con código de Registros ESP Respecto al origen del genotipo destaca que más de la mitad de los mismos proceden de Toros del Consorcio Eurogenomics (56%) mientras que los animales genotipados en España alcanzan un 39% y los genotipos recibidos de otros orígenes el 5% del total.
Más en detalle el país de registro de los animales genotipados se distribuye de la siguiente manera, con una clara mayoría de genotipos de España (36%), seguidos por Holanda (16%), Alemania (15%) y Francia (14%), y en segunda instancia por Dinamarca (6%), Estados Unidos y Polonia (en ambos casos con un 3%) Con un 1% de los genotipos se encuentran países como Suecia, Finlandia, Canadá, Italia, Bélgica o Reino Unido Asimismo, los chips utilizados para el genotipado se dividen de la siguiente manera: 50K (63%); EuroG10K (33%), 6K (3%) y 1% de otros
ABS adquiere el negocio de Progenex
ABS ha comprado la división de genética y cuidado de ubres de Progenex, que durante más de 50 años ha distribuido en España los productos de la fir ma americana El nuevo negocio se conocerá como ABS Progenex, todos los empleados serán transferidos a ABS y per manecerán en la sede actual de Madrid
Salvador Rodríguez Martínez, Gerente de Operaciones de Progenex, comenta: "El equipo de Progenex está satisfecho con esta adquisición Proporcionará muchos beneficios para nuestros distribuidores y clientes ABS está a la vanguardia de las nuevas tecnologías en nuestra industria y continúan desarrollando soluciones pioneras como Sexcel ™ y DeNovo para cumplir con los requisitos cambiantes de nuestros clientes Nosotros somos apasionados de nuestro negocio y estamos comprometidos a ayudar y servir a nuestros clientes, por lo que deseamos seguir juntos en el futuro"
Para Andrew Thompson, Director Regional de ABS, "Esta adquisición per mitirá brindar a los clientes acceso a una gama aún mayor de genética y nuevas innovaciones"

j/a 226 Frisona Española 5
39º Concurso Nacional CONAFE’18 de la Raza Frisona
Recinto Ferial de Asturias “Luis Adaro”. Gijón, 27 al 30 de septiembre
Calendario de Actuaciones
Jueves, día 27 de septiembre: Entrada de ganado. La entrada de ganado deberá realizarse hasta las 20 horas del día 27 de septiembre.
Viernes, día 28 de septiembre:
Descanso del ganado.
Sábado, día 29 de septiembre:
15:00 h
Concurso de Terneras y Novillas
Juzgamiento de las secciones: 1, 2, 3, 4, 5, 6, 7, 8 y 9.
18:00 h XVIII Campeonato Nacional de Manejadores
Domingo, día 30 de septiembre:
10:00 h
Concurso de Vacas en lactación y grupos
Juzgamiento de las secciones: 10, 11, 12, 13, 14, 15, 16, 17, 18, 19, 20, 21, 22, 23 y 24.
NOTA: Todos los actos comenzarán rigurosamente a las horas fijadas.
XVIII Campeonato Nacional de Manejadores CONAFE 2018
Recinto Ferial de Asturias “Luis Adaro”. Gijón, 29 de septiembre Reglamento del Campeonato
Objetivo
CONAFE organizará durante su Concurso Nacional en Gijón, el XVIII Campeonato Nacional "CONAFE 2018" de Manejadores. Se pretende con este Campeonato:
1º Fomentar la profesionalidad y autoestima de ganaderos y profesionales.
2º Estimular a los manejadores en la formación de las técnicas de presentación de los animales en concursos, subastas, exposiciones de su ganado, etc.
Bases del Campeonato
1. Podrán participar en el Campeonato todas las personas que lo deseen sin ninguna distinción específica.
2. Se establecerán tres categorías:
•Infantil: Hasta 11 años
•Júnior: De 12 a 17 años
•Sénior: De 18 a 30 años
3. Los que deseen participar deberán inscribirse antes de las 15:00 horas del día 29 de septiembre, provistos con su D.N.I.
Condiciones de Participación
1. Todos los manejadores deberán presentarse uniformados con pantalón y camisa blancos.
2. Presentarse con un animal suficientemente domado, de tal forma que no perturbe las acciones del resto de participantes.
3. Aceptar estas norma y las decisiones del Juez.
Condiciones de Juzgamiento
1º El Juzgamiento se basará fundamentalmente en:
1.Presentación del manejador
2.Preparación del animal: doma, limpieza, etc.
3.Habilidades del manejador en la conducción del animal
4.Atención al Juez y a sus indicaciones
2º No se valorará la morfología del animal ni su extrema preparación.
Títulos
Se concederán los títulos de:
•Campeón Nacional Infantil de Manejadores CONAFE18
•Subcampeón Nacional Infantil de Manejadores CONAFE18
•Campeón Nacional Júnior de Manejadores CONAFE18
•Subcampeón Nacional Júnior de Manejadores CONAFE18
•Campeón Nacional Sénior de Manejadores CONAFE18
•Subcampeón Nacional Sénior de Manejadores CONAFE18
Programa
Sábado, día 29 de septiembre.
•A las 17:45 horas se presentarán todos los participantes inscritos en la pista del Concurso con la indumentaria exigida.
•A las 18:00 horas el Juez del Concurso explicará:
1º)las normas para una buena presentación en pista de los animales y 2º)las reglas para ser un buen manejador.
3º)A continuación tendrá lugar el desarrollo de las secciones.
6 Frisona Española 226 j/a

El futuro ya está aquí


La Escuela de Preparadores de CONAFE celebró su 13ª edición el pasado mes de julio en las instalaciones del I.E.S. de Luces, en Colunga (Asturias). Un total de 21 alumnos procedentes de ocho comunidades autónomas aprendieron durante cinco días a trabajar como gestores y profesionales de ganaderías de vacuno de leche.
El futuro del sector Eso es lo que representa cada año la Escuela de Preparadores de CONAFE, cita ineludible para aquellos jóvenes que deseen prepararse para dirigir o trabajar en ganaderías de vacuno de leche, y que ha celebrado su decimotercera edición en el I E S Luces de Colunga, Asturias
El director de la escuela este año ha sido el calificador Santiago Mato, que contó con la ayuda como coordinadores de Juan Manuel Fer nández, Jefe de Mor fología de CONAFE y Ángel Amandi, responsable de la ganadería en el centro y excelente colaborador desde el inicio de la escuela
El profesorado de esta edición volvió a estar for mado por Jaume Serrabassa, Bonet Cid y Javier Álvarez, jueces inter nacionales de CONAFE y grandes profesionales de la ganadería de vacuno de leche.
Entre las novedades de este año

está la realización de una sesión de for mación sobre el programa de acoplamientos CONAFEMAT, que ya tuvo su prólogo el primer día tras la bienvenida a los participantes con la ponencia titulada Iniciación al mundo de la genómica y del programa de acoplamientos de CONAFE”, impartida por José Antonio Jiménez, Jefe del Departamento Técnico de CONAFE
For mación teór ica y práctica Durante los cinco días que duró el programa, los participantes de la Escuela de Preparadores recibieron formación teórica y práctica sobre amarre de animales, encamado, alimentación, lavado, doma y paseo, ordeño, pelado, bienestar de las vacas, manejo y juzgamiento de los animales en la pista de competición genética genómica, programa de acoplamientos CONAFEMAT y mor fología de la

vaca frisona por parte de los profesores, así como nociones de podología bovina a cargo de Ángel Fer nández, de Servicios de Podología Pura y colaborador habitual en estas jor nadas
Este año la Escuela contó con la participación de 21 alumnos de entre 11 y 20 años de edad que, como cada edición, fueron divididos en cuatro grupos para la realización de un proyecto de ganadería que presentaron al resto de participantes y monitores durante la tarde del jueves
La organización en grupos fomenta el trabajo en equipo, parte importante en la valoración que los profesores hacen de los participantes cada tarde en el llamado “confesionario”, donde se repasa el trabajo realizado cada día y se escucha, corrige y aconseja
Cada grupo debe cuidar de sus animales 24 horas al día, de modo que deben organizarse también en tur nos

8
226 j/a
Frisona Española
13ª Escuela de Preparadores CONAFE 2018





de noche para continuar con las rutinas de alimentación y cuidado
Todo ello sumado al trabajo de diseñar y preparar el stand así como la presentación de sus proyectos para la tarde del jueves. Los días por tanto son divertidos pero también intensos y largos,ya que empiezan a las 5,30 de la mañana y ter minan siempre tarde
Los gr upos
Los cuatro grupos que se for maron fueron “Ganadería Hierbabuena” integrado por Marc Vilaró, Llorenç Bosch, Joxan Etxeberria, Miguel Rodríguez y Pau Sabrià; “Can Pultru”, formado por Xabier Montes, Eduardo Ávila, Hugo González, Lluis Femenias, Nerea Otza y Alba Carreira; “S A T El Valle”, comprendido por Jon Vivanco, Sebastià Marquès María Mon Aner Peñagarikano y Marcos Miyar; y Son Turqueta , compuesto por Abril Sabrià;

Alberto Ríos; Xuban Peñagarikano; David Pons y Aida Moll
Todos los equipos destacaron por una combinación per fecta de desparpajo y seriedad en la presentación de sus respectivos proyectos, cuyos argumentos defendieron con habilidad ante las preguntas de los profesores y de otros alumnos Finalmente, el Mejor Grupo de la Escuela fue Son Turqueta, mientras que el Segundo Mejor Grupo fue S A T El Valle Repasamos en qué consistían los proyectos de cada una de estas ganaderías virtuales .
Son Turqueta
“Son Turqueta” está for mado por cinco her manos, que sucedieron en el negocio a sus padres y se dedican a la agricultura ecológica, al estar situados cerca de una cala virgen de Menorca definida como espacio natural protegido. Todos los forrajes que consumen

sus animales provienen de su granja y son totalmente ecológicos Un 70% de la leche la transfor man en queso y el 30% restante la dedican a la venta Con la genética que es muy importante para esta ganadería, buscan vacas con muy buenas patas y excelentes ubres, además de buenas estructuras, para producir leche de muy buena calidad para triunfar en el mercado También participan en concursos locales y regionales de raza frisona con gran éxito
S.A.T. El Valle
“S A T El Valle”, situada en Siero (Asturias), es una ganadería for mada por tres her manos y dos obreros T ienen 171 animales, de los cuales 95 son vacas en ordeño, 65 de recría y 11 secas Cuentan con tres naves una para vacas en ordeño, otro para novillas y vacas secas y otra para maqui-

j/a 226 Frisona Española 9
Sebastià Marqués (20 años, Baleares), campeón absoluto de la escuela 2018
Marc Vilaró (18 años, Barcelona), subcampeón absoluto de la escuela 2018
Abril Sabrià (13 años, Girona), Mención de Honor de la escuela 2018





“Tenemos una quesería donde realizamos quesos artesanos de Mahón, a los que dedicamos el 70% de la leche producida”





“Los socios fundadores son naturales de Toledo, pero descendientes de menorquines, de ahí el nombre de la ganadería”
10
Mejor Equipo
226 j/a
Frisona Española
Son Turqueta
Can Pultru


“Las visitas a la granja nos producen muchos ingresos, realizando 3 tur nos de visitas a la semana en invier no y 4 tur nos en verano ”





“No se debe tener miedo al fracaso y a la innovación Invertir en genética es invertir en futuro”



j/a 226 Frisona Española 11
Segundo Equipo
Hierbabuena
S.A.T. El Valle

















 Lorenç Bosch 16 años (Baleares)
Miguel Rodríguez, 16 años (Córdoba)
Alberto Ríos, 12 años (Pontevedra)
Joxan Etxeberría, 13 años (Guipúzcoa)
Eduardo Ávila, 18 años (Toledo)
Hugo González, 15 años (Toledo)
Jon Vivanco, 17 años (Cantabria)
Aner Peñagaricano 14 años (Guipúzcoa)
Xubán Peñagaricano 15 años (Guipúzcoa)
Nerea Otza, 15 años (Cantabria)
David Pons, 18 años (Baleares)
Xabier Montes 11 años (Pontevedra) Pau Sabrià 14 años (Girona) 12 Frisona Española 226 j/a
Lluís Femenías, 20 años (Baleares)
Marcos Miyar, 16 años (Asturias)
María Mon, 15 años (Asturias)
Aida Moll 15 años (Baleares)
Alba Carreira, 20 años (A Coruña)
Lorenç Bosch 16 años (Baleares)
Miguel Rodríguez, 16 años (Córdoba)
Alberto Ríos, 12 años (Pontevedra)
Joxan Etxeberría, 13 años (Guipúzcoa)
Eduardo Ávila, 18 años (Toledo)
Hugo González, 15 años (Toledo)
Jon Vivanco, 17 años (Cantabria)
Aner Peñagaricano 14 años (Guipúzcoa)
Xubán Peñagaricano 15 años (Guipúzcoa)
Nerea Otza, 15 años (Cantabria)
David Pons, 18 años (Baleares)
Xabier Montes 11 años (Pontevedra) Pau Sabrià 14 años (Girona) 12 Frisona Española 226 j/a
Lluís Femenías, 20 años (Baleares)
Marcos Miyar, 16 años (Asturias)
María Mon, 15 años (Asturias)
Aida Moll 15 años (Baleares)
Alba Carreira, 20 años (A Coruña)
naria La sala de ordeño es de 8x2 y realizan dos ordeños al día. La leche la venden en su totalidad a una cooperativa asturiana Apuestan por la genética para mejorar a sus vacas y conseguir embriones y buenos resultados en los concursos Para ello realizan pruebas genómicas y utilizan semen nacional y extranjero También organizan visitas guiadas a la granja durante 3 días a la semana en invier no y 4 días semanales en verano
Hierbabuena
“Hierbabuena” es una explotación for mada por cinco socios, situada en Villaviciosa (Asturias) T iene 280 cabezas de ganado de las cuales 130 están en lactación; disponen de dos robots de ordeño Su media de calificación es de 84,2 puntos T ienen 200 hectáreas de cultivo y hacen visitas guiadas para escuelas, grupos, etc También realizan compra-venta de embriones e invierten en genética porque consideran que es “invertir en futuro . For man parte de un proyecto de investigación por el cual comercializan su leche gracias a un contrato con una empresa para la fabricación de fár macos
Can Pultru
“Can Pultru” es una ganadería formada por tres socios y tres empleados situada en Talavera de la Reina (Toledo) Alberga 275 animales, de los cuales 130 vacas son en ordeño, 85 novillas y 60 secas Disponen de una sala de 12x2 en paralelo y realizan dos ordeños diarios T ienen dos naves: la más grande la de las vacas y otra para novillas y vacas secas con distintos patios donde también se encuentran las ter neras divididas en boxes Entregan el 70% de la leche a una central y con el 30% restante hacen
yogur Apuestan claramente por la genética para mejorar su cabaña.
Concur so de Manejadores y Preparadores
Tras las presentaciones de los proyectos en la tarde del jueves, al día siguiente llegó el tur no del concurso Para el Campeonato de Manejadores y Preparadores los alumnos de la escuela se distribuyen en tres secciones según su edad (infantil, de 12 a 14 años; junior, de 15 y 16 años; y sénior, de 17 a 21 años) y participan con los animales que han preparado durante toda la semana, juzgándose su preparación (pelado) y manejo en pista Tras elegir los dos mejores por sección se proclamó al campeó y subcampeón absolutos y una mención de honor
Jaume fue el profesor encargado de actuar como juez del concurso de manejadores, mientras que Bonet y Javier juzgaron paralelamente el Concurso de Pelado para elegir al mejor y segundo mejor pelador de cada sección. Los monitores también contaron con el apoyo técnico de Santiago Mato, director de la Escuela de Preparadores, y de Juan Manuel Fer nández y Ángel Amandi como coordinadores
Por categorías, en la sección Infantil los ganadores fueron los her manos Sabrià con Abril como campeona y Pau, subcampeón. En opinión del juez, ambos demostraron una ligera ventaja respecto al grupo ” seguramente debido a “ su experiencia y conocimiento de las reglas del manejo en pista” Jaume Serrabassa destacó que Abril aventajó a su her mano “ por un mayor control de la cabeza cuando intenta manejar a una mano siempre con la derecha, más cerca de la papada” Recordó y subrayó además que “los dos han hecho cambios de patas cuando el animal está parado
muy correctos controlando al animal de una manera exquisita .
Entre las menciones a los mejores peladores de la sección, el ganador fue Pau Sabrià, seguido por el benjamín de la edición, Xabier Montes
En cuanto a la sección Junior, “ muy competida” en opinión del juez, la campeona fue María Món y la subcampeona fue Nerea Otza. Destacó la colocada en primera posición por tratarse de “ una manejadora que no ha cometido ningún fallo y que ha sabido reaccionar al cambio de animal” “Aventaja a la segunda y tercera posición por haber hecho los giros siempre de una for ma correcta” apostilló
Dentro de esta categoría Nerea Otza también destacó por el Mejor Pelado, mientras que la segunda mejor peladora fue Aida Moll
Por último, en la sección Sénior el campeón fue Marc Vilaró, mientras que el subcampeón fue Sebastià Marquès El juez subrayó que en esta categoría había “5 o 6 participantes con un nivel muy parecido, en las que las diferencias son casi inapreciables, cuyo trabajo ha sido exquisito, prácticamente sin errores, sabían per fectamente lo que estaban haciendo y demostraban un gran nivel de concentración” “Las diferencias entre el primer y segundo clasificado son mínimas, solo dar más ventaja al brío que muestra Marc a la hora de manejar el animal”, añadió el juez
El ganador al Mejor Pelado en esta categoría fue Jon Vivanco, seguido por David Pons, segundo pelador
Finalmente, los campeones y subcampeones de cada sección volvieron a desfilar con sus animales para que el juez tomase la decisión final. Por sorpresa, como campeón absoluto de la 13º Escuela de Preparadores fue proclamado Sebastià Marquès, que-

j/a 226 Frisona Española 13

1.Alumnos y cuadro técnico en la puerta del I.E.S. Luces. 2. Los alumnos de Baleares bromean con Javier. 3. Jaume Serrabassa, Bonet Cid y Javier Álvarez. 4. Elsa Carbonell, directora del I.E.S. Luces; Sofía Alday, gerente de CONAFE; José Emilio García, presidente de ASCOLAF; y Virginia, responsable de la residencia.

dando en segunda posición Marc Vilaró y la Mención de Honor para Abril Sabrià. El juez justificó su decisión de intercambiar los puestos de la sección senior porque el ganador mostró más habilidad con su animal y con el animal de Marc, “un poco problemático para parar en pista, con unas patas que siempre deja un poco atrás” y que “Sebastià ha sabido sacarle un poco más de provecho, estacionarlo de una forma más natural y caminar mucho más fluido respecto a Marc”.
A la finalización del concurso, el juez alabó el excelente nivel de los

participantes y ofreció una recomendación: “Cuando estéis en una pista intentad controlar las vallas y el perímetro de la pista, intentando dejar una distancia de seguridad. Si sabéis controlar el espacio en el que os estáis moviendo, esto os hará merecedores de una posición u otra”, señaló.
Entrega de diplomas y trofeos Los participantes recogieron su Diploma de participación y los campeones recogieron sus trofeos de manos de la directora del I.E.S. de Luces, Elsa Carbonell; del Presidente de ASCOLAF,

José Emilio García; y de la Directora Gerente de CONAFE, Sofía Alday. Además, los profesores reconocieron el trabajo realizado por todos, pero quisieron reconocer especialmente la labor de Alba Carreira y Aida Mol, por su evolución durante la semana, la convivencia y la responsabilidad. “Cada una aportó grandes esfuerzos dentro de su grupo y de la escuela y son merecedoras de este premio”, concluyó Javier Álvarez.
Campeonato de Manejadores y Preparadores
Sección Infantil 12-14 años

1º Abril Sabrià Liaño+ Mención de Honor
2º Pau Sabrià Liaño + Mejor Pelador
3º Xabier Montes Vilar+
Segundo Pelador
4º Alberto Ríos Crespo
5º Joxan Etxebarría Ruiz
6º Aner Peñagaricano Aizpurua
Sección Junior 15-16 años

1º María Món Sánchez
2º Nerea Otza Sainz + Mejor Pelador
3º Aída Moll Marqués+
Segundo Pelador
4º Miguel Rodríguez Madueño
5º Rubén Peñagaricano Aizpurua
6º Lorenç Bosch Pons
7º Marcos Millar Sánchez
8º Hugo González Martín

Sección Senior 17-21 años

Campeón absoluto
3º David Pons Fedelich + Segundo Pelador
4º Jon Vivanco Hernáiz + Mejor Pelador
5º Lluís Femenías Taltabull
6º Alba Carreira Vidal
7º Eduardo Ávila Martín
14 Frisona Española 226 j/a

SÁBADO
29 SEP 111.30 H.
SalóndeactosdelPalaciode Congresos del Recinto Ferial de Asturias Luis Adaro, Gijón
Como ya viene siendo habitual durante estos últimos años. CENTRAL LECHERAASTURIANA S.A.T. celebrará, en elmarco deAGROPEC 2018, en colaboración con CONAFE y coincidiendo con el 39 CONCURSO NACIONAL DE LA RAZA FRISONA. los VI ENCUENTROS PROFESIONALES.
La Unión Europea quiere que la actividad agrícola de sus miembros sea compatible con la protección del medio ambiente y la lucha contra el cambio climático. aspectos con un gran peso especifico en la propuesta de reforma de la PAC para el periodo 2020-2027, recientemente presentada en Bruselas.
Central Lechera Asturiana (CLAS) se enorgullece de tener un sistema de producción tradicional. plenamente compatible con el planteamiento de la futura PAC. Así, y con esta idea en elhorizonte. acaba de crear el SELLO DE GARANTÍA GANADERA que aseguraa los ganaderos y consumidores la sostenibilidadde las explotaciones y la producción de la mejor leche a través de la Gestión de los Servicios Agrarios. La garantía, que abarca toda la cadena productiva. certifica 5 programas: nutrición, para mejorar la calidad de la alimentación del ganado incentivando el uso de forrajes de calidady de producción propia (autoabastecimiento), y materias primas nobles: control de calidad de La Leche; programa sanitario (ADSG) encaminado a garantizar la máxima salud de nuestras vacas: programa de control reproductivo para la mejora de la fertilidad del ganado: y la herramienta de gestión técnico-económica TAGEL, que proporciona un diagnóstico rápido y fiable de la gestión empresarial para la toma de decisiones adecuadas.


EL SELLO DE GARANTÍA GANADERA permite aCLAS incorporar a su sistema productivo el concepto de "ONE HEALTH" (una sola salud) que representa La interacción entre La salud humana, animal, vegetal y medio ambiente, y que está auspiciado por La OMS, La FAO y La Organización Mundial de La SaludAnimal.
De esta forma, CLAS avalaun completo abanico de servicios agrarios que. basado en la salud de nuestras vacas. una alimentación naturaly el bienestar animal. permite la conservación del modelo de producción tradicional de la casería asturiana, ygarantiza la sostenibilidad de sus explotaciones ofreciendo la mejor leche a sus consumidores. contribuyendo a la conservación de nuestro Paraíso Natural.
Además, reforzando su estrategia de coherencia con las exigencias medioambientales de la nueva PAC, para facilitar a sus socios soluciones a la problemática del manejo de los purines. CLAS aboga asimismo por la economía circulara través de su participación en BIOGASTUR. la mayor planta de biogás agroindustrial de España con una potencia de 4,5 megavatios.
Por su parte. Corporación Alimentaria Peñasanta (CAPSA) ha visto reforzado su liderazgo en elmercado españolen leche líquida, nata y mantequilla el pasado año 2017, gracias a la comercialización de productos sin aditivos.
ni conservantes artificiales. ni estabilizantes. Y, como comentamos anteriormente. desde el respeto al origen y al entorno natural. minimizando el impacto ambiental de sus explotaciones y centros productivos.
En la jornada de este año, la ponencia de Francisco Sanmartín, Director General de C.L.A.S., S.A.T., nos permitirá comprender el camino recorrido desde el concepto productivo más tradicional hasta la situación actual. a través de la adaptación a las nuevas exigencias impuestas por una sociedady nuevos mercados más profesionalizados. pero manteniendo las esencias que hacen que la calidad de los productos de CLAS sea reconocida y avalada por su posición en el mercado actual.
Complementando su exposición, y teniendo presente que nuestro objetivo es la calidad y seguridad alimentaria de la leche en origen, Susana Casado, especialista en calidad de leche del CentroVeterinario de Tineo. expondrá las próximas mejoras incorporadas al programa de calidad de leche y su ejecución práctica.Por su parte.Javier Moral. veterinario especialista en ADS de la Sociedad Veterinaria del Eo. nos proporcionará una visión general del programa ADSG de CLAS, que gracias adisponer de un censo actualizado en tiempo real y a su elevado grado de informatización, garantiza la bioseguridad de la explotación.
Para finalizar. José Armando Tellado, Director General de CAPSA FOOD, nos hará una exposición sobre "La Responsabilidad Social Corporativa y la estrategia de negocio: el modelo CAPSA". Una Responsabilidad que obliga al cuidado de nuestro sector y de nuestro entorno natural. minimizando elimpacto ambiental de las explotaciones y centros productivos. con el firme compromiso de ofrecer la mejor leche para la elaboración de productos de la máxima calidad. Porque pertenecemos a una asociación de ganaderos que nunca deben olvidar cuál es nuestro origen ni el de nuestro trabajo: las vacas. Asturias y la propia naturaleza.
�
"-...-/
Gestión de ServiciosAgrarios
APPROVEO ServiCert'..
www.sgs.com
Ter nera Campeona
Glor ia Brady Katia - Glor ia Hols tein
Ter nera Subcampeona
Cudaña Azalea Solomon - Cudaña
Novilla Campeona
Celis Es tela Hero - Hnos . Celis Gutiérrez, S.C.
Novilla Campeona
Glor ia Solomon Ir ina - Glor ia Hols tein
Gran Campeona de Novillas
Glor ia Brady Katia - Glor ia Hols tein
Gran Campeona de Novillas Reser va
Cudaña Azalea Solomon - Cudaña
Vaca Joven Campeona
Llera Savior Ar tica - Llera Her., S.C.
Vaca Joven Subcampeona
Llera Beemer Betsy - Llera Her , S C
Vaca Inter media Campeona
Tezanillos Braxton Toscana - S.A.T. Tezanillos
Vaca Inter media Subcampeona
Llera Door man Belsita - Llera Her , S C
Vaca Adulta Campeona
Llinde Ar iel Jordan - S.A.T. Ceceño
Vaca Adulta Subcampeona
Tezanillos Stanleycup Mirona - S A T Tezanillos
Gran Campeona Regional de Vacas
Llinde Ar iel Jordan - S.A.T. Ceceño
Gran Campeona Regional de Vacas Reser va
Tezanillos Stanleycup Mirona - S A T Tezanillos
Mejor Ubre
Llinde Ar iel Jordan - S.A.T. Ceceño
Mejor Rebaño Regional
S A T Tezanillos
Segundo Mejor Rebaño Regional
Llera Her., S.C.
Mejor Cr iador Regional
S A T Tezanillos
Segundo Mejor Cr iador Regional Cudaña
Mejor Ganadería Nueva Par ticipación
Ganadería Canas tr illas SC
El Cerrón de Quintana



Concurso Regional de
José Ruiz Ruiz

Segunda Mejor Ganadería Nueva Par ticipación



Llinde
Ariel Jordan... Memor ial
Cuando en el mes de ma yo Llinde Ariel Jordan consiguió los títulos de Vaca Adulta Campeona Gran Campeona y Mejor Ubre del concurso de Galizano, inició una larga y exitosa carrera repitiendo títulos en Treceño, Renedo y, ahora, en el Regional celebrado en Torrelavega Sin duda es el año de esta gran vaca de S.A.T. Ceceño
El fin de semana del 7 y 8 de julio la cita de la ganadería frisona fue en Torrelavega para celebrar una nueva edición del Concurso Regional José Ruiz Ruiz, organizado por la Asociación Frisona de Cantabria, y toda una serie de actividades que giraron alrededor de la leche
El tradicional marco del Mercado Nacional de Ganados acogió a las veinticuatro ganaderías que presentaron ciento seis animales Unos

Santiago García Souto, Juez del Concurso
Finca La Asunción (Quion-Touro, A Coruña): 180 vacas; media de producción a 305 días de 11 900 litros; media de calificación de 85 puntos
Santiago es Juez Nacional de CONAFE desde 1995 y miembro del Comité de Jueces de la Confederación Ha juzgado los concurso nacionales de Primavera (2000) y Otoño (2007), además de numerosos regionales y escuelas de jueces. En 2000 representó a España en el grupo inter nacional de jueces de la Confrontación Europea Ha juzgado también en otros países como Portugal, Francia, Italia y Holanda
García Souto recibe una placa conmemorativa del juzgamiento Le acompañan de izq. a drc.: Carlos Ugarte (Aberekin), Sofía Alday (Directora Gerente de CONAFE) y Ger mán de la Vega (Presidente de CONAFE y AFCA)
16 Frisona Española 226 j/a


Ganado Frisón de Cantabria 2018 ¡¡Imparable!!
ejemplares que a pesar del calor, fueron capaces de mostrar toda su calidad, como afirmó en varias ocasiones el juez del certamen, Santiago García Souto.
Secciones de Terneras y Novillas
El sábado se dedicó a las secciones de los animales más jóvenes, comenzando con la bonita categoría de terneras de 8 a 10 meses, encabezada por dos estupen-




das terneras. En primera posición se colocó Cudaña Azalea Solomon (Solomon x Fever), de la ganadería Cudaña, de la que el juez destacó su mejor inserción de la cola y la costilla más abierta. Azalea fue elegida más tarde Ternera Subcampeona y Gran Campeona Reserva de Novillas. El segundo puesto fue para Cantón Yanta Superstar (Altasuperstar x Seaver), de El Cantón, gracias a su carácter lechero, mejores patas y mejor movilidad.

 Sarabia Rubia Kingboy (Sarabia Isla)
Cudaña Azalea Solomon (Cudaña)
Sarabia Rubia Kingboy (Sarabia Isla)
Cudaña Azalea Solomon (Cudaña)
j/a 226 Frisona Española 17
Ternera Subcampeona y Gran Campeona de Novillas Reserva






En la sección de ter neras de 11 a 13 meses, otra bonita clase con las primeras posiciones caracterizadas por la mejor unión y carácter lechero, se colocó en primer puesto Sarabia Rubia Kingboy (Kingboy x Fever) de Sarabia Isla una ter nera muy ar mónica que mostraba mejores patas posteriores y limpieza de hueso. La segunda posi-


ción fue para Llera Glor ia Diamondback Ada (Diamondback x Sid), de Gloria Holstein, un animal más potente en su tercio anterior, el pecho más abierto, mejor colocación de grupa y mayor fortaleza de lomo
Entre las trece magníficas participantes de la sección de ter neras de 14 a 16 meses García Souto encontró la que sería Ter nera Campeona y Gran Campeona Regional de Novillas: Glor ia Brady Katia (Brady x Mayfield), de Gloria Holstein, una fácil ganadora muy armónica en general, con mas carácter lechero y potencia en el tercio anterior, muy buena estructura lechera, con las costillas bien arqueadas y destacable colocación de isquiones y movimiento de las patas posteriores. El segundo puesto de sección, gracias a su colocación de isquiones e inserción de la cola, fue para Cudaña Mandela Atwood (Atwood x Mascalese), de la ganadería Cudaña
La primera sección de novillas de 17 a 19 meses la ganó Glor ia Solomon Ir ina (Solomon x Atwood), con su costi-



lla mejor arqueada, los corvejones más limpios y mejor inserción de la cola, cualidades que per mitieron a la ganadería Gloria Holstein añadir a los anteriores títulos el de Novilla Subcampeona El segundo puesto de sección fue para Sarabia Nancy High Octane (High Octane x Delete) una novilla de Sarabia Isla que destacó con su tamaño más deseable, mejor equilibrio y unión entre sus partes y mayor fortaleza en la línea dorso lumbar
En la sección de novillas de 20 a 22 meses consiguió el primer puesto Quintana Rebeca Estate (Esther Estate x Fortune), de El Cerrón de Quintana, un animal muy ar mónico, con mejor línea dorso lumbar y grupa y mejores patas posteriores Por su parte Jado Galia Beemer ET (Beemer x Dolman) consiguió para Granja Jado Gutiérrez el segundo puesto de la sección gracias a su mejor desarrollo, carácter lechero y fortaleza en el tercio anterior
La última sección de la mañana, novillas de 23 a 26 meses, contó con nueve participantes entre las que sobresalió la que sería Novilla Campeona, Celis Estela Hero (Hero x Champion), con muy buena estructura lechera, la costilla más profunda y arqueada y mejor inserción de la cola. Su compañera de establo y her mana de madre de la Novilla Gran Campeona CONAFE 17 Celis Mar len Bulería Mccutchen (Mccutchen x Windbrook), un ejemplar muy expresivo, más fuerte en el tercio anterior y con la
Ter nera Campeona y Gran Campeona de Novillas
Ter nera Subcampeona
Novilla Campeona
Quintana Rebeca Estate (El Cerrón de Quintana)
Gloria Solomon Irina (Gloria Holstein)
Celis Estela hero (Hnos Celis Gutiérrez)
Gloria Brady Katia (Gloria Holstein)
226 j/a
18 Frisona Española


Par ticipantes en la sección especial infantil de ter neras de hasta 7 meses
grupa más ancha, consiguió para los her manos Celis Gutiérrez este segundo puesto de sección.
Antes de los campeonatos se celebró la sección especial infantil con ter neras de hasta 7 meses de edad, en la que los manejadores más jóvenes tuvieron la oportunidad de demostrar su buen hacer y, sobre todo, su gran afición Fue elegida mejor ter nera Tezanillos Emilio Tarantina (S A T Tezanillos) presentada en pista impecablemente por su propietaria y Manejadora Campeona de la sección, Car men Gómez García.
Vacas en lactación
La mañana del domingo se celebraron las secciones de vacas, comenzando con la de animales hasta 30 meses de edad, una magnífica sección en palabras de García Souto, con mucha rivalidad entre las seis participantes entre las que destacó el grupo de las tres primeras por la calidad de hueso y la estructura lechera que mostraban. A estas cualidades Llera Beemer Betsy (Beemer x Door man), de Llera Her, añadía su fortaleza de lomo, la buena inserción posterior de la ubre y la colocación de las patas posteriores, siendo elegida mas tarde como Vaca Joven Subcampeona El segundo puesto fue para Cudaña Great Smog 1stclass (Alta1stclass x Altaextreme), de Cudaña por su buen tamaño y potencia en el tercio anterior. Completó la ter na ganadora Trespandio Alicia Link Up (Link Up x Sid), de Sarabia Isla, una vaca muy armónica y con mucho carácter lechero que fue elegida como mejor sistema mamario de la sección
El primer puesto de la clase de 31 a 35 meses y el título de Joven Campeona fue para Llera Savior Ár tica (Savior x Gold Chip), de Llera Her, una vaca muy bien unida, fuerte en la línea dorso lumbar y con la mejor ubre de la sección Ocupó el segundo puesto Tezanillos Envious Vega (Envious x Sid), de S.A.T. Tezanillos, una vaca con destacable calidad de hueso, estilosa y expresiva y con muy buena textura e inserciones de ubre










 Vaca Joven Subcampeona
Vaca Joven Campeona
Vaca Inter media Subcampeona
Llera Beemer Betsy (Llera Her )
Llera Savoir Ártica (Llera Her )
Llera Door man Belsita (Llera Her )
Tezanillos Mincio Galia (S A T Tezanillos)
Vaca Joven Subcampeona
Vaca Joven Campeona
Vaca Inter media Subcampeona
Llera Beemer Betsy (Llera Her )
Llera Savoir Ártica (Llera Her )
Llera Door man Belsita (Llera Her )
Tezanillos Mincio Galia (S A T Tezanillos)
j/a 226 Frisona Española 19









Estas dos ganaderías repitieron posiciones en la sección de 36 a 41 meses situándose primera Llera Door man Belsita (Door man x Goldwyn) por su tercio anterior más fuerte y mejores inserciones de ubre, tanto anterior como posterior, siendo elegida más tarde Vaca Inter media Subcampeona El segundo puesto fue para Tezanillos Doorman Chismosa (Door man x Fever), una vaca muy expresiva en cabeza y cuello, con mejor movimiento en pista y mejores patas y cuartillas
S A T Tezanillos continuó con su extraordinaria partici-

Con casi siete años Llera Ariel ha finalizado tres lactaciones con un total de 37 716 kg de leche, 1 129 kg de grasa y 1 199 kg de proteína


pación colocando a tres de sus animales en los primeros puestos de las tres siguientes secciones Comenzó con Tezanillos Mincio Galia (Mincio x Magot), primera de las inter medias de 42 a 47 meses gracias a su estructura y carácter lechero, la costilla más profunda y arqueada y mejor ubre La colocada en segunda posición fue La Huer ta Goldwyn Sofía (Goldwyn x Shottle), de S A T Ceceño y la Huerta C B , que destacó por su mejor grupa y mejor colocación de isquiones
A continuación Tezanillos Braxton Toscana (Braxton x
 Tezanillos Braxton Toscana (S A T Tezanillos)
Llinde Ariel Jordan (S A T Ceceño)
Tezanillos Stanleycup Mirona (S A T Tezanillos)
Vaca Adulta Subcampeona y Vaca Gran Campeona Reserva
Vaca Inter media Campeona
Vaca Adulta Campeona, Vaca Gran Campeona Regional y Mejor Ubre
Ger mán de la Vega, Jesús Oria, Consejero de Medio Rural, Pesca y Alimentación de Cantabria y José Manuel Cruz, Alcalde de Torrelavega
Tezanillos Braxton Toscana (S A T Tezanillos)
Llinde Ariel Jordan (S A T Ceceño)
Tezanillos Stanleycup Mirona (S A T Tezanillos)
Vaca Adulta Subcampeona y Vaca Gran Campeona Reserva
Vaca Inter media Campeona
Vaca Adulta Campeona, Vaca Gran Campeona Regional y Mejor Ubre
Ger mán de la Vega, Jesús Oria, Consejero de Medio Rural, Pesca y Alimentación de Cantabria y José Manuel Cruz, Alcalde de Torrelavega
20
j/a
Santiago García Souto junto al Mejor Manejador del concurso, Ramón Sainz.
Frisona Española 226


Mejor Rebaño: S A T Tezanillos
Fever) se impuso como primera de la sección de 4 años y como Vaca Inter media Campeona gracias a su estructura lechera, capacidad, mejor arqueamiento de costilla y mayor fortaleza en el tercio anterior El segundo puesto y el título de mejor ubre de la sección fue para H Tobías lavanguard Albay (Lavanguard x Rubens), de La Flor, que presentaba el hueso más plano, mejores patas posteriores y mayor carácter de la raza
En la sección de vacas de 5 años Tezanillos Stanleycup Mirona EX-90 (Stanleycup x Bolivia) destacó por su extraordinario esqueleto, bien unido, con la grupa bien colocada, fuerte en el lomo y con mejor movilidad y sistema mamario, grandes cualidades con las que obtuvo los títulos de Vaca Adulta Subcampeona y Gran Campeona Regional Reserva El segundo puesto de sección fue para Cudaña Debora Stanleycup (Stanleycup x AxiomTwin), de Cudaña, por su mejor ubre en la que destacaba su textura y la inserción posterior
La protagonista de las secciones de 6 o más años y de mejor ubre fue Llinde Ar iel Jordan 2EX y Sistema Mamario EX-95 (Jordan x Genos Gavor), de S A T Ceceño, de la que el juez dijo que su mayor virtud era la ausencia de defectos Así, la que sería Vaca Adulta Campeona y Gran Campeona Regional y Mejor Ubre de Cantabria 2018 se presentó en pista muy equilibrada, con mejor estructura lechera mejor movilidad y un estupendo sistema mamario, con buen piso de la ubre, buenas inserciones y mejor colocación y longitud de pezones. El segundo puesto de esta magnífica sección fue para Llarr iba Windbrook Ir ina (Windbrook x Park Talent), de La Marina de Retortillo, una vaca con mejor estructura y carácter lechero de la que el juez también destacó la calidad de sus patas posteriores y su movilidad
En las secciones de grupos S A T Tezanillos lo tuvo fácil después del papel que habían hecho sus animales a lo largo del certamen y alcanzó los títulos de Mejor Rebaño



Llera Her


Fer nando Sarabia Gerente de AFCA entrega el banderín de Mejor Criador al representante de S A T Tezanillos (arriba) y el de Segundo Criador a Ivón Entrecanales, de Cudaña


Ger mán de la Vega junto a la representante de Canastrillas SC, Mejor Ganadería de Nueva Participación


 Segundo Mejor Rebaño:
Segundo Mejor Rebaño:
j/a 226 Frisona Española 21
Ramón Sainz, de El Cerrón de Quintana, Segunda Ganadería de Nueva Participación junto al Presidente de Afca
Los ganadores del concurso de quesos, quesadas y sobaos

y por puntos, Mejor Criador. Por su parte, Llera Her consiguió el premio al Segundo Mejor Rebaño y Cudaña, el de Segundo Mejor Criador.
Los premios de la sección especial a la mejor ganadería de nueva participación –otra de las novedades de esta edición del regional de Cantabria– fueron para Ganadería Canastrillas y, en segundo lugar, para El Cerrón de Quintana. También de esta ganadería es Ramón Sainz, elegido por el juez Mejor Manejador del concurso.
Concurso de productos de Cantabria elaborados con leche de vaca
Dentro de las actividades del “Fin de Semana de la Leche” AFCA organizó este certamen para eligir el Mejor
Queso de Vaca en cada una de las categorías, la Mejor Quesada y el Mejor Sobao de mantequilla. Para ello se realizó una cata ciega con un jurado formado por 20 perso-

nas de diferentes ámbitos que valoró un total de 36 quesos presentados por 14 queserías, resultando ganadores los siguientes:
-Mejor Queso de Vaca Joven: Siete Villas Tierno.
-Mejor Queso de Vaca Curado: Cudaña Supra.
-Mejor Queso de Vaca Pasta Blanda: La Jarradilla Divirín.
-Mejor Queso de Vaca Azul: Javier Campo.
-Mejor Queso de Vaca Ahumado: Pido Peña Remoña.
-Mejor Queso de Vaca Absoluto: La Jarradilla Divirín.
-Mejor Sobao: Los Pasiegos.
-Mejor Quesada: Casa el Macho.
Finalizó esta gran edición del Regional de Torrelavega y del “Fin de Semana de la leche”, que completó su programa con la jornada técnica organizada por Nanta y Zoetis celebrada la tarde del sábado.
Resultados del Concurso
En las categorías de vacas en lactación, se indica con un asterisco (*) la mejor ubre de la sección
Sección 1ª. Terneras de 8 a 10 meses
1 Cudaña Azalea Solomon Cudaña
2 Canton Yanta Superstar El Canton, S.C.
3 Quintana Reina Monterey El Cerrón de Quintana
Sección 2ª. Terneras de 11 a 13 meses
1 Sarabia Rubia Kingboy Sarabia Isla, S.C.
2 Llera Gloria Diamondback Ada Gloria Holstein
3 Cudaña Areneta Jacoby Cudaña
Sección 3ª. Terneras de 14 a 16 meses
1 Gloria Brady Katia Gloria Holstein
2 Cudaña Mandela Atwood Cudaña
3 Cudaña Amorak Solomon Cudaña
Sección 4ª. Novillas de 17 a 19 meses
1 Gloria Solomon Irina Gloria Holstein
2 Sarabia Nancy High Octane Sarabia Isla, S.C.
3 Cudaña Bunte Defiant ET Cudaña
Sección 5ª. Novillas de 20 a 22 meses
1 Quintana Rebeca Estate El Cerrón de Quintana
2 Jado Galia Beemer ET Granja Jado Gutiérrez S.C.
3 Oyambre Bea Baily Chen S.A.T. Cabo Oyambre
Sección 6ª. Novillas de 23 a 26 meses
1 Celis Estela Hero Hnos. Celis Gutiérrez, S.C.
2 Celis Marlen Bulería Mccutchen Hnos. Celis Gutiérrez, S.C.
3 El Tragüezo Noe Bambi El Tragüezo
Sección Especial Terneras hasta 7 meses
1 Tezanillos Emilio Tarantina S.A.T. Tezanillos
2 Mode Nalioa Goldday Ganad. Pelayo Sarabia
3 Jado Sheila Windhammer Granja Jado Gutiérrez

Sección 10ª. Vaca joven lactación hasta 30 meses
1 Llera Beemer Betsy Llera Her., S.C.
2 Cudaña Great Smog 1stClass Cudaña
3 Trespandio Alicia Link Up * Sarabia Isla, S.C.
Sección 11ª. Vaca joven lactación de 31 a 35 meses
1 Llera Savior Artica * Llera Her., S.C.
2 Tezanillos Envious Vega S.A.T. Tezanillos
3 Gloria Bradnick Albana ET S.A.T. Ceceño & Gloria Hosltein
Sección 12ª. Vaca intermedia lactación de 36 a 41 meses
1 Llera Doorman Belsita * Llera Her., S.C.
2 Tezanillos Doorman Chismosa S.A.T. Tezanillos
3 Cudaña Rock And Roll Meridian Cudaña
Sección 13ª. Vaca intermedia lactación de 42 a 47 meses
1 Tezanillos Mincio Galia * S.A.T. Tezanillos
2 La Huerta Goldwyn Sofia S.A.T. Ceceño & La Huerta
3 Tezanillos Aftershock Caramelo S.A.T. Tezanillos
Sección 14ª. Vaca intermedia lactación de 4 años
1 Tezanillos Braxton Toscana S.A.T. Tezanillos
2 H.Tobías Lavanguard Albay * La Flor
3 Campo Megagenio Dora Ganadería Canastrillas, S.C.
Sección 15ª. Vaca adulta lactación de 5 años
1 Tezanillos Stanleycup Mirona * S.A.T. Tezanillos
2 Cudaña Debora Stanleycup Cudaña
3 Sarabia Isabela Lauthority Sarabia Isla, S.C.
Sección 16ª. Vaca adulta lactación de 6 años o más
1 Llinde Ariel Jordan * S.A.T. Ceceño Nº 39093
2 Llarriba Windbrook Irina La Marina de Retortillo
3 Celis Bulería Marlen Windbrook La Marina de Retortillo
22 Frisona Española 226 j/a
Referentes en genómica
















TOP 10 GENÓMICO. Pruebas Conafe Junio 2018 NOMBRE PRODUCCIÓN TIPO RASGOS FUNCIONALES GICO KG L. KG G. KG P. IPP ICU IGT RCS LONG. D.A. FAC. PARTO 1.º CLUN 2.º RISK 3.º DONSIMON 4.º FLORIN 5.º SALVAT RED 6.º ############### #.### ## ## #,## #,## #,## #,## ### ### ### #.### 7.º EXTEN 8.º PRINCI P RED 9.º SHARAD 10.º SUPERMARIO
oncursos
XXIV Concur so de Ganado Fr isón Feiradeza 2018

Manteiga Shottle Luna, Vaca Gran Campeona, con su propietario
El juez de CONAFE Pol Collell, juzgó la XXIV edición del concurso de Feiradeza
Luna, de la ganadería Manteiga fue la campeona absoluta del 24º
Concurso de ganado frisón Feiradeza 2018 celebrado el pasado 8 de julio en Lalín (Pontevedra).
En el concurso, organizado por Africor Pontevedra con la colaboración del Ayuntamiento de Lalín, participa-
ron 18 ganaderías con 77 animales.
El concurso fue juzgado por Pol Collell, Juez de CONAFE, que destacó la organización del mismo, sorprendido gratamente por la numerosa participación de gente joven y la calidad de los animales participantes sobresaliendo las vacas adultas.
Fue precisamente una vaca adulta de siete años, Manteiga Shottle Luna, de la Ganadería Manteiga, a la que Pol haría Gran Campeona del Concurso Una vaca con muy buen sis-
Resultados de los Campeonatos
Ter nera Campeona
Baroncelle Brady Golondrina - RATO
Ter nera Subcampeona
Carballeiras Solomon Concava 3 – Carballeiras
Novilla Campeona
Baroncelle Mallinger Soraya – Rato
Novilla Subcampeona
Carballeiras Beemer Niura – Carballeiras
Novilla Gran Campeona
Baroncelle Mallinger Soraya – Rato
Vaca Joven Campeona
Midon Edur ne Maximus - Ganadería Midón
Vaca Joven Subcampeona
Blanco Alizee Star - Ganadería Blanco
Vaca Inter media Campeona
Anila Lemos Alcira - Ganadería Anila
Vaca Inter media Subcampeona
Baronelle Xacobeo Paula – Ganadería Rato
Vaca Adulta Campeona
Manteiga Shottle Luna - Ganadería Manteiga
Vaca Adulta Subcampeona
Anibal Royal T ina ET - Ganadería Carballeiras
Vaca Gran Campeona
Manteiga Shottle Luna - Ganadería Manteiga
Mejor Cr iador: Ganadería Manteiga
Segundo Mejor Cr iador: Ganadería Blanco
Mejor Cr iador de Novillas: Ganadería Rato (Rodeiro)
2º Mejor Criador de Novillas: Ganadería Carballeiras (Lalín)
Mejor Descendencia Vacas: Ganadería Carballeiras
Mejor Manejador del Concurso: Avelino Souto
2º Mejor Manejador: Abel Carballo
tema mamario y gran estructura lechera, aventajando a la Campeona Reserva del concurso y vaca campeona de la sección de 5 años, Anibal Royal T ina, de la ganadería Carballeiras por esa mejor estructura lechera y ser un animal con más presencia en pista.
Collell hizo mención especial a la Vaca Joven Campeona, Midon Edur ne Maximus, Ganadería Midón, un animal con un futuro brillante, dijo, y que seguro estaría en las primeras posiciones en nuestro concurso nacional
Ter neras y Novillas
En cuanto a las jóvenes, la Gran Campeona de Novillas, fue Baroncelle Mallinger Soraya de ganadería Rato, una novilla angulosa, con gran estructura lechera y mucho estilo; apreciando Pol, la buena preparación y el trabajo previo y bien hecho en casa
Su compañera de establo, Baroncelle Brady Golondrina, Ter nera Campeona, presentaba mejor calidad de hueso, con una cabeza y cuello y un estilo espectacular
Mejor Criador del concurso fue la ganadería Manteiga y la Mejor Ganadería criadora de novillas la ganadería Rato.
Para finalizar el concurso Pol Collell nombró a los mejores manejadores del mismo que no fueron otros que Avelino Souto y Abel Carballo
Concur so de Jóvenes Manejadores
Sección 1ª Jóvenes entre 21 a 30 años
1ª María Manteiga 2º Manuel Junquera
Sección 2ª Jóvenes entre 16 y 20 años
1º Avelino Souto 2º Abel Carballo
Sección 3ª Jóvenes entre 10 y 15 años
1º Bris Oro 2º Xavier Montes
Sección 4ª Jóvenes menores de 9 años
Jesús Villaverde, Mauro Fer nández, Felipe Meijone, Alberto Nogueira, Pablo Pereira, Zaira González, Bris Donsión, Daniel Santomé Iria Donsión

24 Frisona Española 226 j/a
xposiciones
oncursosexpoc
e
subastasferiasconcursosexposicionessubastasferiasc
Baroncelle Mallinger Soraya Novilla Gran Campeona
Concur so de Irún 2018
Quim Sabriá juez de CONAFE de la 19ª edición del concurso de Irún,(Guipúzcoa), celebrado el 1 de julio
Concurso de ganado frisón organizado por GIFE con la colaboración de EFRIFE y del Ayuntamiento de Irún.
En la edición de este año participaron 46 animales (39 de Vizcaya y 7 de Guipúzcoa) de las ganaderías Ardeo, El Arroyo, Murrieta, Casa Nueva y Ondazarte Esta ganadería, Ondazarte Gain, de Igueldo (Gipuzkoa), fue la gran triunfadora al llevarse el premio a la Novilla Campeona, Ondazarte Expander Dultzea y el de Vaca Campeona con Ondazarte Sid Tximistar que fue también elegida por el juez de Conafe, Quim Sabriá, como Mejor Ubre del Concurso. Destacar que la media de calificación mor fológica de las vacas participantes era de 86,5 puntos, con tres de ellas calificadas EX 90 puntos
Resultados
1ª Sección : Novillas menores que 12 meses
1ª Ondazarte Expander Dultzea Ondazarte Gain y Novilla Campeona
2ª El Arroyo Douglas Rocio El Arroyo y Novilla Campeona Reserva
3ª C.Nueva Douglas Luna. Casa Nueva
2ª Sección: Novillas entre 12 y 18 meses
1ª C Nueva Capital G Sirenita Casa Nueva
2ª Ondazarte Solomon Zeina Ondazarte Gain
3ª C Nueva Mogul Angy Casa Nueva
3ª Sección: Novillas entre 18 y 30 meses
1ª Ondazarte Cinderdoor Aldubide Ondazarte Gain
2ª Casa Nueva Meridian Indie. Casa Nueva
3ª C.Nueva Sneaker Barbie E.T. Casa Nueva
5ª Sección: Vacas en producción menores de 36 meses
1ª C Nueva Gold Chip Money Casa Nueva

Arriba, Ondazarte Expander Dultzea. Abajo, Ondazarte Sid Tximistar

2ª Murrieta Dude Valira Murrieta
3ª C Nueva Mccutchen Kalinda Casa Nueva
6ª Sección: Vacas en producción entre 3 y 4 años
1ª Ondazarte Sid Tximistar. Ondazarte Gain. Vaca Campeona
2ª Murrieta Dreams Roxy Murrieta
3ª C Nueva Lauthority Dulce Casa Nueva
7ª Sección: Vacas en producción mayores de 4 año
1ª C Nueva Xacobeo Melissa Casa Nueva Campeona Reserva
2ª Ondazarte Atwood Bardoa Ondazarte Gain
3ª Quintana Nagore Jett Air. Casa Nueva
Mejor hija toro de ABEREKIN: EL Arroyo Douglas
Bonet Cid, juez de CONAFE, juzgó la 24ª edición del concurso del Valle de Carriedo (Cantabria), con 21 ganaderías y 116 animales
El pasado 4 de agosto se celebró en La Canal de Villafufre (Cantabria) el concurso local de raza frisona Valle de Carriedo 2018, organizado por el Ayuntamiento de Villafufre con la colaboración de AFCA y juzgado por Bonet Cid
La vaca adulta de cinco años, Tezanillos Stanleycup Mirona, actual Gran Campeona Reserva Regional de Cantabria, propiedad de la ganadería S A T Tezanillos, fue elegida Vaca Gran Campeona del certamen, después de haber sido nombrada Vaca Adulta Campeona También se llevó el título de Mejor Ubre del concurso
Este animal se impuso a sus compañeras de cuadra, la Vaca Joven Campeona, Tezanillos Capital Gain Tundra, y a la Vaca Inter media Campeona, Tezanillos Braxton Toscana (ganadora de este concurso en la edición anterior
El premio al Mejor Rebaño fue también para S A T Tezanillos, seguido por SAT La Redonda y Granja Perejil “El Macho” El premio al Mejor Criador fue también para S A T Tezanillos
Ter neras y Novillas
En cuanto a las jóvenes, el título de Gran Campeona de Novillas fue para la Ter nera Campeona, Reto Anastasia Kingboy, de la ganadería Sdad Coop Reto a la Esperanza La Novilla Campeona fue Perejil Luna Llena, de Granja Perejil “El Macho”

Reto Anastasia Kingboy
Tezanillos
Stanleycup
Mirona Vaca
Gran Campeona
Carriedo 2018

ganado fr isón Valle
24º Concur so de
de Carr iedo 2018
j/a 226 Frisona Española 25
oncursos
xposiciones
concursosexpoc
e
subastasferiasconcursosexposicionessubastasferias


“Hay que ser ganadero, pero también empresar io”
En el año 2003 visitamos More Holstein (Bétera, Valencia), en la que Ramón Morla, junto a su padre , manejaba un rebaño que sobrepasaba con creces el millar de cabezas Quince años después, muchas cosas han cambiado en la explotación, pero otras se mantienen, como la impor tancia que dan tanto al bienestar de los animales como a las condiciones de trabajo de los empleados
De todo ello hablamos con Ramón y con su mujer, Lidia Entrecanales
Llegamos a More Holstein una calurosa tarde de mediados de agosto y nos sorprenden dos cosas: el tamaño de la ganadería y la tranquilidad que respiran los animales desde la sala de ordeño donde comenzamos la visita, hasta cada uno de los 22 parques, desde las ter neras a las vacas en producción. Y más teniendo en cuenta que la temperatura y la humedad son un hándicap, sobre todo para mantener la producción y la fertilidad, como nos dice Ramón
Con 1 800 vacas en lactación, la sala de ordeño es el punto neurálgico de esta ganadería, que optó por un modelo de rotativa con 50 puntos donde se realizan tres ordeños diarios. Una sala que, según su propietario, puede aguantar bien 4 o 5 años más. ¿Y después? le preguntamos “A mi el robot me encanta, porque la vaca va a su aire Desde luego este tipo de tecnología va a imperar en el futuro y hay que tenerlo muy presente La cuestión es ver qué sistema poner y tener claro que si se pasa a robot o sala robotizada, la persona que esté al frente tendrá que estar más cualificada”
Tal vez el mayor problema de esta ganadería sea la estacionalidad de los partos, una situación que esperan minimizar con el sistema de duchas con el que empeza-
ron a trabajar hace tres años y que han duplicado actualmente Como mencionábamos antes, la fertilidad es uno de los aspectos que quieren mejorar; según nos cuentan ahora tienen muchos partos concentrados en siete u ocho meses y luego ninguno. En febrero disminuyen y hasta junio apenas hay. Muchos partos y mucha vaca seca; vacas recién paridas y vacas en cola de lactación; esto unido a una media alta de días en leche, hace que haya momentos en que baja la producción
Instalaciones y rebaño
Las ter neras al nacer pasan a unas casetas individuales donde están unos días hasta pasar a otras, con capacidad para cuatro animales. De ahí van pasando a distintos lotes hasta los 12 meses, que van al parque para inseminar Los grupos se hacen por edad y como nos cuenta Lidia, pasan de un lote a otro de for ma natural y si hay alguna que se queda algo retrasada en tamaño, se queda en el lote anterior En More Holstein el bienestar animal es vital
Otra gran diferencia en el manejo de las ter neras nos dice Ramón, es el confort que tengan. Dales una buena materia prima, una ración correcta y equilibrada, y el ani-
26 Frisona Española 226 j/a
Lidia Entrecanales y Ramón Morla





















mal crece solo, pero el confort es también la base principal del crecimiento del animal”
More Holstein tiene 22 naves: en las más grandes hay 170 vacas y las demás unas 100 o 110 Aunque hay capacidad para 195 vacas, siempre dejan colleras de sobra para que tengan más espacio y estén más cómodas
No tienen lotes de preparto ni posparto Los parques están distribuidos por días en leche entran las recién paridas y salen las que se van secando.
Con un total de 3 100 animales, la capacidad de crecimiento empieza a ser limitada, aunque todavía podrían aumentar el rebaño en unas 300 o 400 cabezas “Aquí en la granja, afir ma Ramón, crecer significa comprar, tienes que ir comprando campos de naranjos cercanos para ir haciendo parques ” La ganadería ocupa 19 hectáreas a las que hay que sumar otras dos donde ponen el estiércol y hacen el compost.
En 2013 compraron una finca de casi 130 ha, toda de regadío, de la que sacan el 50 o 60% del forraje que necesitan para las vacas No está muy cerca, a unos 130 kilómetros, pero es importante por la producción agrícola y para ligar la granja a la tierra, para la PAC y el medio ambiente Aquí apenas se hace purín, es todo estiércol seco del que gran parte se utiliza para autoconsumo y el resto se vende para la huerta. Mantenemos la intención de comprar hectáreas alrededor de la granja –dice Ramón–para plantar maíz y reutilizar los lixiviados que genera la explotación”
Con esta climatología y este tamaño de rebaño, el consumo de agua es elevado En la granja disponen de dos pozos con agua más que suficiente para abastecer a la ganadería y en la finca agrícola también hay dos pozos los cuales sacan 100 litros por segundo





j/a 226 Frisona Española 27
Miguel Morla, fundador de la ganadería, junto a su hijo Ramón

La producción agrícola se destina completamente a la alimentación de los animales. Como nos explica Ramón, tienen cosecha de maíz en verano y cosecha de cebada en invier no Están consiguiendo unos 4 o 5 millones de kilos de cada producción
La alimentación
La ración sobre todo gestión y costes la hace Octavi Fargas desde 2003 y con Emili Calvet trabajan en calidad de leche y están muy contentos con ellos ya que los resultados están ahí El coste de producción del litro de leche varía en función del precio de las materias primas y de las exigencias de la central Actualmente Danone, donde entregan, esta exigiendo un mínimo de 3,40% de grasa, lo que supone un aumento del coste de la alimentación que ha pasado de 4 5 euros por vaca y día a 5 5 euros Aunque el precio de la leche también ha subido un poco, el problema, como apunta Ramón, son los 9 euros por tonelada que te quitan si no alcanzas los mínimos
El cualquier caso, la relación con Danone es de 37 o 38 años y según Ramón, las exigencias cada vez son mayores, “ pero nuestro mayor problema, hoy por hoy, es que la industria nos limita la producción, cosa que hasta ahora no había ocurrido nunca eso supone un hándicap Se producía sin límites y eso ayudaba a reducir los costes fijos . Ahora tienen fir mado un contrato que da tranquilidad, aunque va a depender de los costes de produc-
ción. Nos cuentan que el maíz ha subido en un mes de 175 €/tn a 195€/tn, también está subiendo la alfalfa, la soja y la cascarilla, mientras que la paja sale mejor que el año pasado Por eso van ajustando la ración según el precio y disponibilidad de las materias primas y procuran utilizar recursos que tengan cerca y abaratar el transporte Aprovechan, por ejemplo, la naranja durante los meses de temporada que en fresco hace muy apetitosa la ración para la vacas.
La ración se hace dos veces al día , prácticamente igual en verano y en invier no, salvo pequeños retoques según la necesidad del animal Para vacas en lactación se compone de 5 kg de alfalfa, 1 kg de paja picada, 1 kg de soja, 12 kg de bagazo de cerveza, 1 kg de cascarilla, 2 kg de colza, 400 gr de corrector, algo de sal marina, 13 kg de silo de maíz y 6 kg de silo de cebada La de ter neras y novillas está hecha casi toda en base a paja (6 kg) algo de colza para darles proteína y un poco de maíz.
Las vacas secas comen 7 kilos de paja, 3 de cascarilla de soja,10 kilos de cebadilla y corrector
Hace un tiempo montaron en la finca una planta mezcladora con la que han conseguido una ración más homogénea Pero el mayor ahorro fue el energético Además haciendo la comida para tantos animales los errores se minimizan y se ahorra tiempo El objetivo sobre todo en verano, sería dar la comida las 24 horas del día, echar menos cantidad pero con más frecuencia y así
28 Frisona Española 226 j/a

controlar más las sobras e incentivar al animal al consumo Que finalmente lo hagan o no, pasa por los resultados que obtengan con las duchas, consiguiendo controlar el consumo, ya no sería necesario cambiar el régimen de reparto de la ración con el consiguiente ahorro en personal.
Recursos humanos
La plantilla de More Holstein es también grande Además de Miguel y Ramón, trabajan Lidia, un encargado, dieciséis empleados que se encargan de las vacas en cuatro tur nos de cuatro personas, tres empleados para la comida otros tres para los ter neros tres personas en la oficina tres conductores una persona más en cada uno de las dos fincas agrícolas. Sin olvidar a tres veterinarios. Para Ramón el personal es lo importante, por eso siempre intentan que los trabajadores estén donde mejor se adapten y por eso tienen empleados que llevan más veinte años en la casa
La gran apuesta:
sistema de duchas y mejora de la fertilidad
En More Holstein controlan la temperatura de todas las vacas recién paridas en los primeros 15 días. Con esta infor mación rutinaria están comprobando que si el año pasado la temperatura media nor mal era de 39,5º o 39,6º este año con las duchas todas las vacas están por de-
More Holstein en cifras
DATOS GENERALES


VACAS


bajo de los 38,7º Además, están pendientes de implantar en cada vaca un ter mómetro registrador de datos para controlar la temperatura las 24 horas y así saber cuándo la vaca acumula calor El sistema de duchas se complementa con el de ventiladores, controlan el indice de temperatura y humedad (ITH) y cuando están por debajo del 68%, se paran Con estas medidas están consiguiendo mejoras espectaculares en el bienestar de los animales
Recientemente se ha incorporado un sistema de detección de celos nuevo, detectando y sugiriendo el punto álgido para la inseminación y esto ha hecho que la fertilidad a celo visto haya aumentado Consiste en collares individuales y antenas repartidas por toda la granja. El objetivo final es reducir la programación de los celos.
El manejo reproductivo en situaciones de estrés calóricos también ha llevado a esta ganadería a realizar transferencia de embriones, más que por mejora genética, por mejora de la fertilidad Comenzaron a hacerla haces tres años, siempre con vacas de la propia finca, y el resultado ha sido satisfactorio teniendo ahora congelados más de cien embriones.
Las vacas están en estabulación libre con cama caliente en sistema de rotavatado, que airea el estiércol sobre la paja, y que proporciona mucha comodidad a los animales, que no presentan problemas de mamitis ni de patas Este aspecto, además lo tienen controlado con la visita quincenal del podólogo de la empresa Rodagri, que hace recorte funcional
A la espera de los datos reproductivos lo que están comprobando ya con las duchas es que las vacas aprovechan más el espacio del que disponen, están más relajadas y pasan más tiempo rumiando “Ha sido toda una experiencia nos comenta Lidia, los primeros días no entraban y ahora van todas corriendo a mojarse Lo agradecen mucho”
De momento han puesto las duchas en dos naves, calculando unas 200 vacas Si todo va bien se pondrá una tercera para duchar tres patios a la vez, más veces o durante más tiempo. Ahora son 45 minutos de duchas con intervalos de menos de 4 horas, que según los expertos es el tiempo a partir del cual las vacas empiezan a acumular calor
Para Ramón, el resultado de las duchas, por lo que están viendo de momento, es espectacular Las vacas están pariendo bien se levantan enseguida y están haciendo calostros. Solo hay que ver que lo que llevamos de agosto;
y aquí cada grado cuenta” La mejora
80%
Nº total de animales 3.052 Nº de vacas 1 827 Vacas en lactación 1 648 Intervalo parto-1ª IA 95 Intervalo parto-IA fecundante 163 Días a primera IA 95 Edad a 1ª IA 13,5 Edad al parto 23,3 Fertilidad a 1ª IA 59% Fertilidad general 55% Servicios por concepción 2,05
estamos en una media de 82% ITH y el año pasado era del
REPRODUCCIÓN
REPRODUCCIÓN NOVILLAS j/a 226 Frisona Española 29
la están apreciando sobre todo en las vacas secas y si hubiera que establecer un orden, la prioridad en las duchas sería para secas, seguidas por las recién paridas y las vacas de alta producción
Como insiste Ramón, su esfuerzo se centra en minimizar la estacionalidad, llegando al verano con la mayor cantidad de animales preñados, y con una media de partos de 2,4 y entre el 25 y el 27% de reposición anual, el objetivo es sacar unos buenos resultados económicos
Manejo genético
Lidia, la mujer de Ramón, es de la familia Entrecanales, de la conocida ganadería Cudaña (Cantabria), en la que se ordeñan 130 vacas Un salto geográfico, climatológico y ganadero el que dio hace más de una década y al que se adaptó rápidamente “Aquí lo que vi pronto –nos dice Lidia– es que prácticamente daba igual ordeñar 1 000 vacas que 1 500 Cuando vienes de una granja pequeña eso te asombra un montón porque allí ordeñar 20 vacas más es un mundo, pero aquí ordeñar 300 más supone lo mismo Es el enfoque, el sistema de trabajo, allí es todo muy individual y aquí es todo muy global” La mentalidad de esta joven ganadera, como confiesa ella misma, cambió muchísimo, sobre todo con el tema de la genética de la que es la encargada A la hora de elegir un toro mira siempre las necesidades que tengan en cada momento y ahora, también, parámetros nuevos, como la fertilidad de las hijas, pero respetando

siempre el tipo (la media de calificación es de 80 puntos)
“Creo que es un poco de lógica: si tienes buenos animales, te van a durar más s en la granja”, afir ma
Con una base de origen canadiense, que se remonta a 1996 cuando crearon la ganadería, en la actualidad los toros que utilizan ocho o diez al menos son casi todos americanos y en un 70% genómicos
Ser ganadero en Valencia
En la Comunidad Valenciana hay varias ganaderías lecheras, unas 15 o 16 nos dice Ramón, pero solo tres están en control lechero y son socias de Afrival y CONAFE y dos de ellas More Holstein y San Ramón reúnen más del 50% del censo
Aunque en esta comunidad el sector agrícola con el cultivo de naranjas, tiene más peso, Ramón considera que la Administración tiene bien atendidos a los ganaderos y tienen un trato bastante directo
Tampoco por parte de la industria, que está muy cerca de la granja, ha habido nunca problemas de recogida De hecho, como decíamos antes, llevan más de treinta años trabajando con Danone, una empresa que ha sabido valorar el trabajo de More Holstein otorgándo-

les varios premios al bienestar animal en base a diferentes parámetros entre los que se incluyen las medidas para disminuir el estrés por calor, el espacio para recreo y descanso, el protocolo de descor nado, el secado selectivo de las vacas y un largo etcétera La industria y el consumidor nos dice Ramón cada vez están más concienciados con el bienestar animal y con la reducción del uso de antibiótico y de hor monas.
La empresa ganadera
Rentabilidad es uno de los tér minos que más se emplean hoy en ganadería y así lo defiende Ramón, para quien hay que ser ganadero, pero también empresario, porque al final es un negocio y “los negocios tienen que ser rentables si no desaparecen” Para él el hándicap de una explotación para pasar de familiar y grande es el personal. Si sabes manejar el personal, que es lo complicado, ya te da igual ordeñar mil, dos mil o tres mil Lo que hay que cambiar es la mentalidad, uno se piensa que si no lo hace él, nadie lo va a hacer bien “Es un error, hay que pensar que tienes que buscar la gente adecuada, enseñarla y marcar las pautas que tiene que llevar El ganadero tiene que aprender a ser empresario y empezar a
30 Frisona Española 226 j/a


manejar al personal más que a las vacas El éxito está en saber manejar al personal; si sabes hacerlo, el número de vacas es el que te quieras proponer ” , aunque reconoce que “cuantas más tengas, más dolores de cabeza tendrás ”
De cara al futuro
De momento, Ramón y Lidia esperan a que acabe el verano para tener los resultados del sistema de duchas y ver qué otros objetivos se plantean. Cuando tengan la estacionalidad más repartida, puedan inseminar en verano y tengan más regulado el espacio al tener más repartidos
los partos se plantearían otras cuestiones Ahora afir ma Ramón, nuestro objetivo principal es maximizar el rendimiento de la explotación, que está al 70%; nos faltan unos 300 o 350 animales para llegar al menos al 90% En ese momento, el factor limitante será la sala de ordeño
¿Entonces pararéis de crecer?, les preguntamos para finalizar “Depende de lo que vea en nuestros hijos, responde Ramón, y ahora son muy pequeños Cuando lleguemos a las 2 100 pararemos queremos diversificar también un poco con los campos de naranjos que hemos comprado y quién sabe, nunca se puede decir de este agua no beberé ”
j/a 226 Frisona Española 31

Javier Blanco Murcia es profesor de Medicina y Cirugía de la Facultad de Veterinaria de la UCM y jefe del Servicio de Clínica de Rumiantes del Hospital Clínico Veterinario de la misma universidad.
Colabora con CONAFE en la organización y desarrollo de los cursos de Podología del programa I-SAP de la Confederación desde su primera edición, en octubre del 2015 y en el proyecto de Diploma en Podología Bovina promovido por la UCM en colaboración con CONAFE.
Hablamos con él sobre estas actividades y sobre la salud podal de la cabaña frisona española.
Salud podal: bienestar
¿Cuál ha sido la evolución del estado sanitario en ganadería de leche en los últimos diez años?
En ganadería de leche a nivel mundial y especialmente en la UE lo que vemos es que hay tres grandes problemas que son los que generan pérdidas económicas y que más influencia tienen en el bienestar animal, que son la fertilidad, las mastitis y los problemas podales, más o menos por este orden en cuanto impacto económico y en cuanto impacto en los animales. La salud podal ha tomado una fuerza enorme en los últimos años porque tiene un impacto más claro y más determinante sobre el bienestar animal y la economía del ganadero.
¿Qué problemas podales son los más frecuentes en las ganaderías españolas?
A nivel de estadísticas, tanto españolas como de la UE, la dermatitis digital e interdigital, la úlcera de suela y la enfermedad de la línea blanca. Estas enfermedades se dan siempre y están relacionadas con las instalaciones, la alimentación y la limpieza. Evidentemente, si hay zonas o épocas del año donde hay un aumento de la humedad ouna falta de limpieza, tendremos un aumento exponencial de las dermatitis de origen infeccioso transmisible; si tenemos granjas donde las camas o el suelo son de goma, tendremos problemas mayores por hipoconsumo... pero en general esas son las tres enfermedades más co-
rrientes. Hay que decir que especialmente la laminitis está presente en el 40-50% de las vacas que los podólogos examinan; es una enfermedad muy importante que no es solo podal, sino que tiene características que afectan a la estructura de las pezuñas y está relacionada con la alimentación.
La laminitis se da en el 40% de las vacas tratadas ¿es una cifra muy alta comparada con otros países de la UE?
Esta cifra lo que muestra es que la laminitis está presente o puede existir en todas las ganaderías y es un problema generalizado a nivel europeo. Probablemente, cuanto más intensivas son las producciones, más problemas de laminitis existirán, incluso con el uso de cereales. En el caso del modelo español, de alimentación con altas cantidades de concentrado, es probable que haya más laminitis que en un sistema basado en forrajes y pastos, donde se dará menos. Pero la utilización de silos de maíz en toda la cornisa cantábrica, también es un factor determinante; es decir, no solo el concentrado de cereal, sino los silos. Es una cuestión de la cantidad de almidones presentes en la ración; vamos a tener granjas con un nivel muy bueno, con poca presencia de laminitis y otras con mucha presencia de laminitis, y dependerá del manejo nutricional y de la cantidad de almidones y cómo se administran en la ración.
32 Frisona Española 226 j/a

y renta bilidad
¿Se puede variar la ración de for ma generalizada para disminuir los casos de laminitis?
El problema de la laminitis es cómo conseguir que los animales consuman concentrado y forraje sin que el pH ruminal entre en la frontera de los 5,5 puntos; este es el quid de la cuestión Cuando la fer mentación a nivel ruminal se mantiene en el ámbito del 5,5 puntos, la fisiología del rumen no genera ningún problema de laminitis Es decir no va a generar mortalidad de las bacterias que hay en el rumen, no va a provocar que se produzcan endotoxinas que van a alterar la circulación del corion de la pezuña y esa circulación a nivel del corion, produciendo trombos o alteraciones, es la que hace que la pezuña crezca alterada y de mala calidad Por tanto, la relación entre la laminitis, acidosis y alimentación es el reto a conseguir Que los animales coman suficientes cantidades de almidones –es decir la fuente energética– pero que en su rumen las fer mentaciones se mantengan alrededor del 5,5 y quenunca bajen de ahí. Eso va a garantizar que no haya riesgos de laminitis Es un tema que estamos viendo en ganado de cebo, donde están apareciendo muchos animales jóvenes con laminitis y problemas Hay ganaderías bien manejadas donde la ración con los carbohidratos en el carro unifeed está muy bien balanceada, muy bien unifor mada donde prácticamente este problema no existe
La transmisión de infor mación entre nutricionista, veterinario podólogo y ganadero tiene que ser constante
T iene que ser total; la relación entre el nutricionista el veterinario, el podólogo y el propietario de la granja es la clave Muchas veces, los primeros que ven que hay problemas en la granja son los podólogos, son los primeros que te dicen “hay muchos signos de laminitis” La uña de la vaca cuando crece es como un lienzo donde quedan reflejados todos los eventos que van ocurriendo Cuando empiezan a aparecer manchas color rojizo-amarillento que van saliendo hacia fuera hemorragias difusas es el podólogo, al hacer el arreglo preventivo, quien lo empieza a ver; sabe que hay un problema de laminitis crónica o aguda; una inflamación del corion
¿Dónde se suele dar mucho? En las novillas, a las que el ganadero, tradicionalmente, da menos importancia en la alimentación, juega más con piensos o con una ración de peor calidad; las novillas generalmente comen grandes cantidades de concentrado con forrajes de mala calidad y son los animales que primero empiezan a padecer los problemas. Hay que prestar más atención a las novillas, a la suplementación con carbohidratos y, por supuesto, a las vitaminas, minerales y al forraje de buena calidad Por eso son tan importantes hoy día los periodos de transición, para los que hay medicaciones que aplican la monensina en for ma de bolos Lo mismo ocurre cuando la vaca pasa al periodo seco donde se cambia la ración; ahí es donde si los ajustes nutricionales no son los adecuados, habrá alteraciones de la flora ruminal y del pH y se producirán problemas sistémicos, patologías que ya conocemos y al final, la patología podal La clave es tener en cada etapa una alimentación que optimice la fer mentación ruminal y el mantenimiento de la flora ruminal nor mal
¿El ganadero es receptivo a la aplicación de estos procedimientos?
El ganadero hoy en día es un profesional y un empresario que busca asesoramiento y, nor malmente, hace caso a lo que se le está diciendo Lo interesante es saber for mar y explicar al ganadero la influencia que tienen todos estos factores en la producción y en la sanidad de los animales y al final, en sus beneficios Porque no se trata de bienestar animal enfocado solamente a que las vacas no tengan problemas, sino a que las vacas que no tienen problemas den más leche y, por tanto, sean más rentables De hecho, hoy día hay muchos centros y ganaderías que ya dan la importancia que tiene a la recría de las novillas, que nor malmente son las primeras que traen problemas como la der matitis interdigital y digital
¿Debido a la alimentación o influyen otros factores?
También influye la suciedad y las instalaciones En las novillas la fuente de entrada de der matitis digital e interdigital, que está producida por gér menes, viene nor malmente por el parque donde están las novillas, con poca limpieza, acúmulo de estiércol y fluidos Estos animales empiezan a tener este problema y cuando pasan a los parques de producción, lo transmiten a las vacas Por lo tanto las novillas nor malmente son la primeras que sufren procesos infecciosos y pueden empezar a tener cambios en la estructura y en la calidad de la pezuña motivados por la alimentación.
CONAFE participa en este proceso con la recogida de infor mación con los programas I-SAP e I-ISA ¿cómo se puede implicar a más ganaderos y podólogos en estos programas?
La toma de datos por parte del podólogo en una ganadería de leche es fundamental y en podología especialmente. Este mismo impulso se está haciendo en otros países porque es la base, primero porque nos per mite diferenciar los problemas que tenemos y segundo, podemos ir a la causa de esos problemas para su prevención y
j/a 226 Frisona Española 33
tratamiento; nos va ayudar mucho a tomar decisiones desde el punto de vista genético, de manejo y de diseño de explotaciones. Además, tener el historial de cada vaca ayudará a tomar decisiones de tipo económico, de tratamientos e incluso ver la influencia de ese tipo de animal en su manifestación de problemas podales.
¿Cuál es el protocolo establecido para la toma de datos?
Lo que están haciendo en otros países como Francia oAustria es lo que se está haciendo aquí con el programa I-SAP, con mucho acierto en mi opinión, que es dotar a los podólogos de una herramienta fácil, una tablet instalada en el potro de trabajo, con unos criterios muy básicos sobre la patología que se trata y la zona en la que se encuentra, de tal forma que sin alterar su trabajo, el podólogo, va a poder marcar la lesión. Lo bueno para el podólogo es poder tener el historial de sus vacas con problemas, una úlcera, una enfermedad en la línea blanca… es vital a la hora de tomar una decisión. Para ellos es importantísimo saber que la vaca a la que están tratando en ese momento, es una vaca a la que ya han tratado y muchas veces son animales que requieren una supervisión veterinaria, una cirugía, o no seguir tratando esa vaca problemática. Es vital para el ganadero y vital para el podólogo. Una vaca coja, o la curas rápidamente o se convierte en crónica y es una fuente de pérdida económica brutal para la explotación, no solo por el bienestar animal.
Habría que trasladarlo a euros: una vaca coja supone tantos litros menos, tantos euros menos
Estamos en ese proceso en la UE y se está avanzando mucho, hay mucho publicado a nivel mundial. En España, Noureddine Charfeddine (CONAFE) y esta facultad de veterinaria, han publicado cosas muy interesantes, cuantificando claramente el coste que suponen estas lesiones para la explotación. Ya hemos establecido lesiones moderadas y lesiones graves; es decir, cogidas a tiempo oa destiempo, con una cuantificación de entre los 30 € en lesiones leves, hasta más de 500 € en lesiones graves. Muy parecido a lo que estiman los americanos, entre 40 y 50 €, incluso llegando a los 600 €. Hay muchas formas de mirarlo, pero al final tiene una implicación económica brutal en la ganadería.
Desde tu experiencia en las ganaderías y en cursos ¿hay uniformidad de criterios entre los podólogos?
Es una cuestión interesante; hemos pasado de tener al podólogo solo en las grandes explotaciones y en la mayoría de las granjas no tener un sistema de trabajo definido e incluso a que el ganadero hiciera sus propios recortes, a tener los mismos datos que se manejan en EE UU y en la UE. Aproximadamente el 70% de las granjas tienen tratamiento por podólogo y en el 30% restante, o bien el propio ganadero ha hecho cursos y lo hacen ellos o no hacen nada, que son los menos.
Dentro de eso, los podólogos en la UE (Francia, Austria, países nórdicos) establecen distintos conceptos. Ellos tienen una profesión regulada con una formación que se podría equiparar aquí a una formación profesional. En España existen profesionales que desde hace tiempo se dedican a la podología y que con la práctica han ido aprendiendo y veterinarios que han decidido llevar su trabajo a la podología. La situación es que hay equipos muy profesionales sentando ciertos conceptos de trabajo que están incluso por encima de lo que tenemos en nuestro alrededor, caso de los grupos ANKA y SERAGRO, donde trabajan podólogos con una formación muy buena. Pero también hay personas que como complemento a su trabajo en la ganaderíay sin ningún tipo de formación y ni experiencia, compran un potro, se van al campo y empiezan a trabajar en granjas.
Además tenemos otro problema, en la UE el uso de
medicamentos y los actos veterinarios están muy controlados y van a estarlo muchísimo más. En otros países, las lesiones que afectan al corion, al tejido interno, no se pueden tocar por parte de un podólogo. Este es un debate que hay que tratar con mucho sosiego, porque un podólogo puede hacer recesiones de corion, de hueso, lo cual va a generar un problema de bienestar animal y sobre todo un problema con la UE.
Ahora ¿qué hace el podólogo que no puede suministrar medicamentos si, llegado el caso ,fuera necesario?
Se ha estado haciendo de muchas formas, unas adecuadas y alguna no. El podólogo que ve una vaca que cree que requiere una cirugía, un tratamiento específico,

debe manifestárselo al ganadero para que le ponga en contacto con el veterinario, incluso que la visita se haga en conjunto, porque la pericia del podólogo ayuda mucho al veterinario y el veterinario, en cuanto a la anestesia y conocimiento de la anatomía interna, va a ayudar al podólogo. Por tanto, se trata de establecer una sinergia entre los tres. No se trata de que los podólogos sean veterinarios o que los veterinarios se especialicen en podología; pueden coexistir perfectamente, lo que no debe ser es que se produzcan usurpaciones de unos o de otros, como veterinarios que conociendo la anatomía, intentan arreglar las pezuñas y lo que no conocen son las bases del arreglo funcional.
¿Qué consejos darías a los ganaderos a la hora de implantar un protocolo de prevención en salud podal? Yo lo primero que diría es que la coordinación entre el veterinario de explotación, el veterinario nutricionista, el podólogo e incluso si hay algún técnico que está diseñando explotaciones o el manejo, debe ser determi-
34 Frisona Española 226 j/a
nante Se tiene que establecer claramente, en función de la zona la alimentación el clima y el tipo de animales qué protocolo vamos a realizar No es lo mismo que las vacas estén saliendo a pasto en la zona norte de España, que se mueven y desgastan, que en una ganadería intensiva en la zona de Navarra, por poner un ejemplo, con suelos abrasivos
Ese diseño pasa por cada cuánto tiempo revisamos y hacemos el recorte funcional y qué protocolo usamos para los animales que detectamos con cojera Es decir cómo protocolizamos que en el plazo más breve posible sea explorado bien por el veterinario de explotación, bien por el podólogo, o bien por los dos; dónde hacemos los arreglos preventivos Muchas veces no interesa hacerlos

“
La uña de la vaca cuando crece es como un lienzo donde quedan reflejados todos los eventos que van ocurriendo

cada seis meses sino antes del periodo seco o durante la recría de las novillas. Cada ganadería tiene que establecer sus protocolos y para eso, lo mejor es que el veterinario, el nutrólogo y el podólogo, en función del tamaño y tipo de instalación, deter minen qué es lo que se debe hacer
Hablemos del proyecto para la for mación reglada de los podólogos mediante un Diploma en Podología Bovina expedido por la UCM ¿ayudaría al establecimiento de estos protocolos, de otras prácticas mejoradas?
De hecho, el proyecto de crear un Diploma en Podología Bovina es dar for ma a una solicitud del sector Es el propio sector el que demanda for mación y son los propios podólogos los que han pedido que una institución como la Universidad Complutense, como podrán ser otras, empiece a establecer las bases de for mación que necesita un podólogo Hay una cosa muy importante: en la UE, por mucho que las circunstancias sean distintas en cada país, si un podólogo en Francia necesita un periodo
de for mación de once meses, y aquí se trabaja sin título, está muy claro que tarde o temprano va a llegar la regularización de la for ma de trabajo Si empezamos a dotar de una for mación básica sobre la anatomía y fisiología, seguridad en el trabajo, los problemas más habituales, etc , a los profesionales que están en el campo, estos profesionales van a ir adquiriendo una homogeneización de la for mación –que la titulación no es lo importante–, y desde ahí se va a poder trabajar luego sobre el intrusismo o sobre la capacitación, desde el punto de vista del bienestar animal para trabajar –o no– sobre animales No hablamos de un peluquero canino sino de una persona que con un cuchillo, una legra o una radial puede cortar estructuras vivas de un animal y esto la UE lo tiene claro: el bienestar animal es una de las puntas de lanza Empieza a haber una creciente preocupación por parte de los profesionales que llevan muchos años trabajando –y hablo de podólogos, no de veterinarios– sobre la problemática de que cualquier persona pueda meterse en este campo y pueda provocar la invalidez o la muerte de un animal, con pérdidas económicas importantísimas. Seudoprofesionales que, además, van de granja en granja utilizando potros y herramientas, que son vectores de transmisión de enfer medades si no se tratan adecuadamente
¿En que fase encuentra ese proyecto?
El proyecto está diseñado por la Universidad Complutense de Madrid con CONAFE como co-organizadora Se trata de dotar de un título a los profesionales que se dedican ya a la podología, con experiencia y, en algunos casos, sin titulación El curso –al que se podrán apuntar tanto los veterinarios como los podólogos con experiencia demostrada–consta de varios módulos en los que se tratan aspectos básicos como la anatomía, la fisiología, las enfer medades, el recorte funcional y la seguridad en el trabajo Es un embrión mínimo no el óptimo que nos gustaría pero sí suficiente para dar el primer paso hacia una for mación más reglada y asimilar nos más a países de nuestro entor no. Está muy claro que nos dirigimos a podólogos en ejercicio y a personas que quieran hacer este trabajo porque, a petición del sector, lo que queremos es regularizar, no generar un negocio por parte de la Complutense o usurpar funciones a ningún equipo que ya esté funcionando Simplemente consideramos que es una obligación por parte del sector público, de las universidades, dar solución a esta demanda de for mación En este curso tienen cabida todos los profesionales que quieran participar; aprovecho desde aquí para que todo el que lo considere, se apunte Se trata de nor malizar conocimientos y dotar de una herramienta a los podólogos, no solo de título, sino de for mación: qué es lo que puede hacer o no, lo que debe saber hacer y por qué hace lo que hace
¿Los profesores serán de la Universidad Complutense?
No hay cinco o seis profesores de la facultad de Veterinaria de la UCM que van a dar clase de ámbito general, de la anatomía fisiológica de la pezuña y de algunas enfer medades, pero los profesores que van a llevar el peso del curso son podólogos y/o veterinarios especializados, personas que llevan mucho tiempo en esto Es claramente un curso en especialización La idea es que empiece en febrero de 2019 para un máximo de 30 personas y ya están las bases en la web de la UCM como Diploma en Podología
¿Sería la culminación de los cursos de podología promovidos hasta ahora por CONAFE?
Más que la culminación, es que el curso de podología ha contribuido a satisfacer una demanda por parte de los profesionales del sector que ha sido muy bien acogida y ahora estos profesionales demandan la profesionalización mediante el establecimiento de algún requisito de título o de deter minada for mación. Lo hemos acogido desde la universidad Complutense, pero se va a ver multiplicado en los próximos años, seguro
n j/a 226 Frisona Española 35

Ya han pasado cuatro meses desde el lanzamiento del Lely Astronaut AS y ya se ha instalado el primero en España en la Ganadería Inclán en Cabo de Peñas, Avilés (Asturias). El sector ha sabido reconocer muy rápido el auténtico hito que supone este robot y los pedidos en fábrica están superando nuestras mejores expectativas. El AS ya es una realidad que ayuda y ayudará a miles de ganaderos de todo el mudo a encontrar el equilibrio entre su vida privada y laboral, al mismo tiempo que desarrollan una actividad rentable que les permita sacar sus granjas adelante. Este es el compromiso que Lely se ha marcado y que nos ha llevado a ocupar el lugar en el que nos encontramos hoy dentro del ordeñoautomatizado. La innovación hasido siempre la seña de identidad de la casa y el AS es en sí mismo unainnovación que va camino de convertirse en una de las más importante de lasúltimasdécadasen nuestrosector. En esteartículo trataremos de dos de los muchos aspectos que hacen del AS el robot de ordeño más rentable y eficaz del mercado.
Facilidad de uso y mantenimiento
Un robot de ordeño, además de eficaz y rentable, tiene que adaptarse al ganadero de formaque este pueda usarlo sin problemas ensu día a día. Es en este marco que Lely ha rediseñado la interfaz haciéndola más intuitiva y comprensible para todo el mundo. Usar la pantalla del robot para ver las distintasfuncionesse ha convertido en una tareaigual de fácil que mirar losmensajes en un teléfono móvil. Muestra toda la información pertinente de un solo vistazo y permite acceder con rapidez a las funciones importantes.

También se ha mejorado el procedimiento del primer ordeño de una vaca. La primera vez que una vaca entra en un robot después del parto siempre es un momento que merece más atención por parte del ganadero. La vaca está inquieta y un proceso rápido, silencioso y tranquilo redunda en un ordeño suave, sin interrupciones que hará que lavacavuelva sola al robot sin necesidad de que nadie la empuje. Con el nuevo Astronaut AS todas lasfunciones ligadas al primer ordeño están en una sola pantalla y tan solo hay que acercar el brazo a la ubre. Cuando el brazo detecta
los pezones delanteros, basta con pulsar el botón de acoplamiento. Si fuera necesario se puede usar el botón de alimentación para suministrar concentrado extra para que lavaca se sienta más cómoda. Tanto la vaca como el ganadero viven este primer ordeño como una experiencia carente de tensión: el animal porque ve como todo ocurre de una manera tranquila, con un solo movimiento del brazo y el ganadero porque ordeña un animal por primera vez nada másque presionando un botón.

Para facilitar el mantenimiento de la máquina el Astronaut AS está diseñado para ofrecer facilidad de acceso a todas sus partes. De esta manera, el tiempo de mantenimiento se reduce y el tiempo de actividad aumenta.Se da también al ganadero un plus de autonomía ya que él mismo puede acceder fácilmente a todas las piezas del robot y realizar ciertas tareas de mantenimiento fácilmente.
Se ha cuidado también la fiabilidad y durabilidad de los componentes para alargar la vida útil del robot y disminuir los tiempos de parada ligados a cambios de piezas no programados.
Confort de las vacas
Está demostrado que las vacasse desenvuelven bien en nuestro sistema de libre circulación además de sentirse más cómodas gracias al concepto 1-flow y al box espacioso. El nuevo brazo híbrido del Astronaut AS nos ha permitido ir un paso más allá en todo lo relativo a la comodidad de las vacas. Hemos desarrollado un brazo que aúna neumática y electricidad, aprovechando las ventajas de cada una de ellas: es mássilencioso, más rápido y más resolutivo, lo cual mejora el comportamiento en las visitas y elrendimiento del robot, y por consiguiente su capacidad.
Se ha buscado un brazo que potencie el confort de la vaca sin olvidar el concepto de ahorro de energía.
Por esta razón el peso del brazo se ha transferido a un cilindro neumático de grandes dimensiones para que los accionamientos eléctricos requieran muy poca energía para mover el brazo al mismo tiempo que el sistema garantiza facilidad de movimiento en todas las posiciones del brazo. Su nueva estructura permite al Astronaut ordeñar todo tipo de pezones y ubres en vacas de todos los tamaños. El rediseño del brazo con puntos pivotantes garantiza una posición vertical de las pezoneras para ofrecer una superficie de gran extensión, un factor fundamental para lograr un acoplamiento preciso.
Todo el confort de la vaca sería inútil si el brazo no fuera capaz de soportar las patadas de un animal de 600 kg.Ya en modelos precedentes de robot Lely, el brazo impide, algo únicoen el mercado, que la vaca pise y golpee los tubos de leche u otros componentes porque la carcasa del brazo los protege. En el AS, el brazo sigue protegiendo tubos y componentes eléctricos, pero además se ha integrado un sistema articulado dotado de dos muelles neumáticos que absorben la energía de patadas y golpes. Este sistema deja margen de maniobra al brazo, protegiendo a los componentes eléctricos y a la vaca, que podría lesionarse si golpeara un brazo rígido que no cediera.
El ordeño pues, se convierte en algo natural y fluido que ocurre de una manera natural tanto para la vaca
como para el ganadero, que ve como pasa a ser dueño de su tiempo, sin estar sometido a la rigidez de horarios del ordeño tradicional. A la vez, incrementa la rentabilidad de la explotación dándole mayor tranquilidad y autonomía en la gestión de su negocio y mejora de una manera global su economía y su calidad de vida.
El Lely Astronaut AS, al mismo tiempo que ha integrado numerosas novedades que lo hacen único en el mercado se ha "alimentado" de la experiencia de más de un cuarto de siglo que Lely tiene en el ordeño automatizado: ordeño individualizado por cuarto, box amplio que no ajusta a la vaca, brazo que acompaña los movimientos de la vaca en el box, tubos de leche y componentes del robot inaccesibles a las patadas de la vaca, pezoneras que nunca caen al suelo, limpiezade pezones con cepillos que impiden que entre estiércol en el sistema de conducción de leche, análisis de temperatura, conductividad, colorimetría, grasa y proteína, recuento de células somáticas, limpieza de pezoneras a 170 °C, etc
Avanzarpues hacia el futuro apoyándonos en nuestra experiencia y en la de los ganaderos para seguir dando al mercado las mejores herramientas que mejoren la gestión y la rentabilidad de las explotaciones.

Conafe
Títulos a vacas
Tras cada evaluaciones genética, CONAFE concede los títulos de Vaca Medalla de Oro y Vaca Estrella para reconocer a aquellas vacas que combinan una alta producción, una conformación superior y una adecuada longevidad.
Vaca Medalla de Oro (VMO)
El título de VMO se concede a las vacas que han conseguido tres estrellas o más, ya sea del aporte de datos de hijas nacidas de partos naturales o de trasplante de embriones.
Vaca Estrella (VE)
Es aquella cuyas hijas cumplen con los requisitos que se exigen en producción, tipo y longevidad, con los que sumarán méritos a los datos obtenidos por la madre.
Obviamente, la madre y Vaca Estrella en cuestión también cumple con las exigencias que se piden a sus hijas. En el caso de Vaca Estrella por hijas procedentes de trasplante de embriones (VEE), aparece un asterisco (*) junto al nombre.
Los requisitos necesarios para obtener estos títulos se pueden consultar en www. conafe.com. (Raza Frisona, Normativa para la obtención de Méritos).
Las vacas vivas en el momento de calcular la evaluación aparecen resaltadas en color. Se indica el criador y propietario actual o último conocido y su provincia; en caso de no coincidir, se especifican ambos.
A continuación aparecen los títulos correspondientes a la evaluación de junio de 2018

38 Frisona Española 226 j/a
BOS CHAMPION TARA ET ESPH1502351832 14 2004 CHAMPION x SKYCHIEF UTE DE BOS / SAT SAN VICENTE DE NIVEIRO A Coruña LERON ESPH0102153518 7 2003 LHEROS x SCOTT LARREA S.C. Alava LAKESIDE SNOWMAN PAYA ESPH2503653065 7 2011 SNOWMAN x BOLTON IMPORTADO / PONDEROSA HOLSTEINS Lleida TEC VENTURO MORTY ROSIE ET ESPH3302318137 7 2004 MORTY x CONVINCER GANADERÍA CASA VENTURO, S.C. Asturias H.LOS TOBIAS GIBSON 235 ESPH1402288375 6 2004 GIBSON x HUERTA LOS TOBÍAS Córdoba POZO LEE 9378 ESPH2702346450 6 2004 LEE x RUDOLPH CASA POZO, S.C. Lugo QUINTEIRO OUTSIDE MANILA ESPH3602408592 6 2004 OUTSIDE x AEROLINE JOSÉ LUIS MEIJOME FERNÁNDEZ Pontevedra ARSUAGA AINE LEDUC ESPH3902230728 6 2003 LEDUC x STORM S.A.T. ALVEAR 7606 / GRANJA JADO Cantabria GE-GLEN-D-HAVEN BIFFY PLANE ET ESPH1703245783 6 2009 PLANET x O MAN MAS GENER S.C.P. Girona GENER BIFFER HUMA 1048 ET ESPH1703610926 6 2011 BEACON x PLANET MAS GENER S.C.P. Girona BENIGNO BOTAFOGO 5669 ESPH2702076565 6 2002 BOTAFOGO x LANDOI BENIGNO / S.A.T. LADEIRA Lugo TEIXEIRO GOLDWYN GLIA ET ESPH2703324095 6 2010 GOLDWYN x SEPTEMBER S.A.T. TEIXEIRO Lugo CIGUÑUELA FREDERICK KITA ESPH1402623999 5 2006 FREDERICK x CEVIS CIGUÑUELA Córdoba VIEITES LORA LHEROS ESPH1502407321 5 2004 LHEROS x RUDOLPH VIEITES A Coruña ASUNCION GOLDWYN ROSETA ESPH1502645840 5 2006 GOLDWYN x LHEROS FINCA LA ASUNCION /SAT CASA CARBALLO Lugo MANTOÑO MENDEL CS DAISY ET ESPH2702271369 5 2003 STORMATIC x RUDOLPH MANTOÑO HOLSTEIN Lugo CASEIRO DE ERNES GIBSON UXI ESPH2702405689 5 2004 GIBSON x RUDOLPH CASEIRO DE ERNES Lugo VEIGUEIRO GOLDWYN GOLDA ESPH2702652071 5 2006 GOLDWYN x DATABASE VEIGUEIRO SDAD. COOP. GALEGA Lugo CID STORMATIC DRAMATICA ESPH2702701171 5 2006 STORMATIC x FONTANS GANDEIRIA CID, S.C. Lugo VALDENEBRO 079 ESPH2802919610 5 2008 BLITZ x LEE EXP. GANADERA VALDENEBRO, C.B. Madrid PANDIO NEGRY GOLDWYN ESPH3403338263 5 2010 GOLDWYN x TALENT SDAD. COOP. EL PANDÍO Palencia FRAGA GOLDWYN BOTACA ESPH3602893538 5 2007 GOLDWYN x OUTSIDE FRAGA, S.C. Pontevedra CELIS CHABELA CHAMPION ESPH3902458123 5 2005 CHAMPION x CLEIT HNOS.CELIS GUTIÉRREZ / GRANJA LA MARINA Cantabria ARENAS NADIA CHAMPION ESPH3902459204 5 2005 CHAMPION x MARTY S.A.T. ARENAS Nº 39119 Cantabria HERRADURA SHOTTLE LOLA ESPH4002922246 5 2007 SHOTTLE x OKENDO TORRES SDAD. CIVIL Segovia HS BOLTON LAUBOL ET ESPH0502924090 5 2007 BOLTON x TITANIC AGROP. HNOS. SENOVILLA, S.L. Avila BOS IGNITER ROSE ET ESPH1502139062 5 2003 IGNITER x MANDEL UTE DE BOS A Coruña BOS JET STREAM MISSY ET ESPH1502835647 5 2007 JET STREAM x BW MARSHALL UTE DE BOS / GANAD. OS AMERICANOS Pontevedra BOS BAXTER DONNA ESPH1503060663 5 2008 BAXTER x GOLDWYN UTE DE BOS / GAN. CANDENDO, S.C. A Coruña BOS PLANET MIRTA ET ESPH1503110918 5 2009 PLANET x O MAN UTE DE BOS / PONDEROSA HOLSTEINS Lleida 0247 ESPH2402463416 5 2004 OUTSIDE x HNOS. SIMÓN PÉREZ / BLANCO Pontevedra PG SNOW ICECREAM ET ESPH2503609523 5 2011 SNOWMAN x SHOTTLE IMPORTADO / PONDEROSA HOLSTEINS Lleida BOS MANTOÑO JOLT DUNA ET ESPH2702029674 5 2002 JOLT x WADE MANTOÑO HOLSTEIN Lugo BOS TEIXEIRO SEPT.GLINDIÑA ET ESPH2702713358 5 2006 SEPTEMBER x IGNITER S.A.T. TEIXEIRO Lugo

BLANCO ALIZEE IRENE ET ESPH3603262687 5 2009 SHOTTLE x CHAMPION BLANCO Pontevedra MTOTO-BOLA ESPH0101916633 4 2002 MTOTO x LEAD COOP. LAGUNAK Alava
NERVIA TITANIC ESPH0802692519 4 2006 TITANIC x FINLEY EL PINOS NOU Barcelona ISERN TONCHU GALA ESPH0803195499 4 2009 TONCHU x EDDIE MAS ISERN Barcelona ESPAÑOLA ESPH1502336544 4 2004 CUBEIRO x SKYLARK CAREIXO / GANADERÍA OS LOUREIROS, S.L. A Coruña PORTOBELLO DANUTA EMERSON ET ESPH1502468836 4 2004 EMERSON x PORTOBELLO A Coruña SAN VICENTE MAIL. EXTREMA 482 ESPH1502701770 4 2006 MAILING3 x S.A.T. SAN VICENTE DE NIVEIRO A Coruña G.DUBRA.S.C. 185 ESPH1502702541 4 2006 GOLDWYN x LHEROS GANADERÍA DUBRA, S.C. A Coruña SAN VICENTE BUCKEYE DORISA 531 ESPH1502774264 4 2007 BUCKEYE x ACTUEEL S.A.T. SAN VICENTE DE NIVEIRO A Coruña PERILLA 418 7802 ORDES ESPH1502945945 4 2008 ORDES x LEREZ S.A.T. PERILLA Nº 1031 XUGA A Coruña GRC 455 TOYSTORY ESPH1503051805 4 2008 TOYSTORY x TITANIC LANDEIRA SDAD. COOP. GALEGA A Coruña GENER BAMBONETA BOLTON 795 ESPH1702875952 4 2007 BOLTON x MARMAX MAS GENER S.C.P. Girona ABEL NERY CASH 9567-60 ESPH2702275807 4 2003 NERY CASH x HENU MAS ESTEBA S.A.T. 1336 XUGA Lugo 1818 BLITZ LUIS SAA ESPH2702335563 4 2004 BLITZ x CASA DA SAA, S.C. Lugo UKRAINE 5260 ESPH2702523470 4 2003 MANSART x JOJOBA IMPORTADO / LA NAVE, S.C. Lugo MARTINA BLITZ SELENA ESPH2702525909 4 2005 BLITZ x LEADER MARTINA / CONCHADOS, S.C. Lugo CHUSCO GOLDWYN SELA ESPH2702647113 4 2006 GOLDWYN x IGNITER CHUSCO, S.C. Lugo VEGA TOLORIU TORA ESPH2702647144 4 2006 TOLORIU x MASON GANDERIA VEGA Lugo XEPE GOLDWYN SOMBRA ESPH2702897653 4 2007 GOLDWYN x SEPTEMBER CASA XEPE / LUCHO, S.C. Asturias BERLAI BUCKEYE 2692 ESPH2702899333 4 2007 BUCKEYE x LOURO S.A.T. BERLAI Lugo MONTERROSO BUCKEYE PACA ESPH2702903876 4 2007 BUCKEYE x OUTSIDE GAN. MONTERROSO / VILA PALACIO S.C. Lugo XERCAS CAV AROUSANA ROUMARE ET ESPH2703013546 4 2008 ROUMARE x MTOTO CAVADAS S.A.T. XUGA 941 Lugo VALDENEBRO 1226 ESPH2802354171 4 2004 LARINO x DEL EXP. GANADERA VALDENEBRO, C.B. Madrid VALDENEBRO 1321 ESPH2802680632 4 2006 DUPLEX x LEE EXP. GANADERA VALDENEBRO, C.B. Madrid VALDENEBRO 048 ESPH2802854390 4 2007 BOLTON x RUDOLPH EXP. GANADERA VALDENEBRO, C.B. Madrid
LHEROS ANDY ESPH3302314840 4 2004 LHEROS x MEGANO LUCHO, S.C. Asturias LHEROS CENIZA ESPH3302317960 4 2004 LHEROS x MALOYA LEO CASA GUILLERMO, S.C. Asturias
ALLEN PEPITA ESPH3302497933 4
ALLEN x
S.A.T. LLUISA Asturias
PINOS
LUCHO
LLUISA
2005
MTOTO
ESPH3302670433 4 2005 GOLDWYN x FORMATION GAN. DIPLOMADA BADIOLA, S.L. Asturias
ROY LAURY ESPH3302914739 4 2007 ROY x RUBENS GAN. DIPLOMADA BADIOLA, S.L. Asturias PETO AS BASIA BAXTER ET ESPH3303045582 4 2008 BAXTER x FREELANCE CASA PETO, S.C. Asturias CASCAJERA 181 JESTHER 370 ESPH3402460550 4 2004 JESTHER x AEROSTAR LA CASCAJERA Palencia PANDIO AUSTRALIA OMAN ESPH3402814649 4 2007 O MAN x PANDIO EMERSON LANE S.C. EL PANDÍO/ BLANCO DE VILLALBA S.C. A Coruña MEL-FER 189 ESPH3403235758 4 2009 BAXTER x JOCKO BESN MEL-FER, S.C. Palencia VIEITEZ JAMES CASANDRA ESPH3602080229 4 2002 JAMES x RUDOLPH VIEITEZ / JOSÉ ANTONIO DOBALO LÓPEZ Pontevedra MOURISCADE BLITZ 0539 PETRA ESPH3602579104 4 2005 BLITZ x JAMES D.PROV.PONTEVEDRA-FINCA MOURISCADE Pontevedra MAJOSE SIX SHEILA ESPH3602947167 4 2006 SIX x CUBEIRO GANADERÍA SEIXAS, S.C. Pontevedra XILO XACOBEO CAPERUCITA ESPH3603272266 4 2010 XACOBEO x CHAMOSO GANADERÍA XILO, S.C. Pontevedra MORENA INQUIRER ESPH3902234563 4 2003 INQUIRER x STORM S.A.T. DISAMA Nº 39014 Cantabria SIRA CHAMPION REBOLLO ESPH3902747978 4 2006 CHAMPION x FORBIDDEN EL REBOLLO Cantabria ARENAS NAYRA DUPLEX ESPH3903284427 4 2010 DUPLEX x CHAMPION S.A.T. ARENAS Nº 39119 Cantabria HERRADURA CASHMERE GERLA ESPH4003037949 4 2008 CASHMERE x TOUCHDOWN TORRES SDAD. CIVIL Segovia BOS IGNITER SACHA ET ESPH1502039591 4 2002 IGNITER x RUDOLPH UTE DE BOS A Coruña BOS FREELANCE AFRICA ET ESPH1502482752 4 2005 FREELANCE x BW MARSHALL UTE DE BOS / PORTALOUSA Lugo BOS CUNDINS CRISTINA GOLDW. ET ESPH1502946044 4 2008 GOLDWYN x WADE CUNORDAM, S.C. A Coruña BOS PRONTO LIZIPAINA ET ESPH1503096829 4 2008 PRONTO x ZENITH UTE DE BOS / S.A.T. BUSTO-CORZÓN A Coruña BOS HOWIE PRISCILA ET ESPH1503205073 4 2009 HOWIE x SHOTTLE UTE DE BOS / PONDEROSA HOLSTEINS Lleida BOS SHOTTLE SELENA ET ESPH1503217715 4 2009 SHOTTLE x GOLDWYN UTE DE BOS / PONDEROSA HOLSTEINS Lleida BOS JEEVES SHERICE ET ESPH1503329884 4 2010 JEEVES x GOLDWYN UTE DE BOS / S.A.T. CARBALLEIRAS Pontevedra BOS GERARD SELENIA ET ESPH1503520752 4 2011 GERARD x SHOTTLE UTE DE BOS / SAT SAN VICENTE DE NIVEIRO A Coruña BOS MASEDA GOLDWYN 225 ET ESPH2702950233 4 2008 GOLDWYN x INQUIRER LÓPEZ TELLADO, MASEDA, S.C. Lugo BOS MOURISCADE F.0336 TELLA ET ESPH3602302626 4 2003 FORBIDDEN x RONALD D.PROV.PONTEVEDRA-FINCA MOURISCADE Pontevedra LANDA GAM MOSCOW ESPH0103125563 3 2009 MOSCOW x ODIN LANDA GAMBOA, S.L. Alava TALFA GARVER ESPH0501970767 3 2002 FATAL x HELDOSTAR HNOS. GARCÍA VERDUGO, S.C.P. Avila HM OUTSIDE SUSI ESPH0502179654 3 2003 OUTSIDE x HM STARDUST HUGO HERNÁNDEZ MARTÍN Avila BINILLOBET SANDRA NOULET-GIB ESPH0702550168 3 2005 NOULET GIB x STARKY BINI LLUBET Baleares PINOS HORTEA BUCKEYE ESPH0802763018 3 2007 BUCKEYE x TITANIC EL PINOS NOU Barcelona CAMPGRAN LETI SPIRTE ESPH0802870888 3 2007 SPIRTE x IGNITER EXP. PECUARIAS COVE,S.L. (EL CAMPGRAN) Barcelona THOS MICKEY MENTA ESPH0803194754 3 2009 MICKEY x BLITZ RAMADERIA CAN THOS, S.L. Barcelona SANJUAN 2589 BLITZ-ROTA ESPH1102865310 3 2007 S.JUAN 2246 BLITZ MTOTO x DUPLEX SAN JUAN DE PUERTO RICO Cádiz CAÑADA CARRIZAL ALEX BOND 557 ESPH1402282147 3 2003 KENDALL x MTOTO CAÑADA EL CARRIZAL Córdoba CIGUÑUELA TOYSTORY LARISSA ESPH1403433039 3 2011 TOYSTORY x TITANIC CIGUÑUELA Córdoba MANEIRO NURIA LHEROS ESPH1502416097 3 2004 LHEROS x RUDOLPH JUAN MANEIRO CIVES / SAT IGLESIAS 1040 A Coruña AUGA DE RIVERA ESPH1502471066 3 2005 THRONE x RUDOLPH GRANXA RIVEIRA, S.C. A Coruña A ESTIVADA INQ. LOURO ANATHEMA ESPH1502658858 3 2006 LOURO x INQUIRER A ESTIVADA SDAD. COOP. GALEGA A Coruña A ESTIVADA LOOSTER IC. ARKADIA ESPH1502701957 3 2006 ICESHOW x LOOSTER A ESTIVADA SDAD. COOP. GALEGA A Coruña MANEIRO 117 BLITZ ESPH1502904540 3 2007 BLITZ x DUCADO MANEIRO A Coruña A DEVESA DARTER A-54 ESPH1503160179 3 2009 DARTER x TITANIC DEVESA LANGUEIRÓN, S.L. A Coruña VILASUSO RODA XACOBEO 8024 ESPH1503222657 3 2009 XACOBEO x IGNITER VILASUSO SDAD. COOP. GALEGA A Coruña 6749 SIX LEBON ESPH2702408318 3 2004 SIX x LARIÑO GANADERÍA LEBÓN, S.C. Lugo VEGA OUTSIDE PRIMERA ESPH2702472422 3 2005 OUTSIDE x BUSTER GANDERIA VEGA Lugo ALAMBRERO FORD RAIÑA ESPH2702706087 3 2006 FORD x NELSON ALAMBRERO, S.C. Lugo j/a 226 Frisona Española 39
BADIOLA GOLDWYN MEGANDREA ET
BADIOLA
ANDRESIN MIRALLO PALMERA
GUARIN
BALDOMERO CHENIA ROUMARE
CHIQUERO

ET ESPH1502909106
BOS GOLDWYN MALVA ESPH1503021831
BOS PRONTO EVERYTHING ET ESPH1503103561
BOS ALEXANDER MAHE ESPH1503277566
BOS BAXTER PACHA ROJA ET ESPH1503277570
BOS NIAGRA DESIRÉ ET ESPH1503425580
SPEZI 1144 ET ROJA ESPH1503894133
A CAMPAZA SNOWMAN WENDY ET ESPH2703590726
BADIOLA SHOTTLE MEGADONNA ET ESPH3303471038
LLERA GOLDWYN BLISS 2 ET ESPH9402792062
3 2007 HARTLINE x AFFINITY UTE DE BOS / GAN. OS AMERICANOS, S.L. Pontevedra
3 2008 GOLDWYN x INQUIRER UTE DE BOS / GAN. CANDENDO, S.C. A Coruña
3 2009 PRONTO x DURHAM UTE DE BOS / GAN. MANTEIGA, S.C. Pontevedra
3 2010 ALEXANDER x BOLTON UTE DE BOS / CASA FLORA. SDAD.CIVIL Asturias
3 2009 BAXTER x SEPTEMBER UTE DE BOS/D.P.PONTEVEDRA-F. MOURISCADE Pontevedra
3 2011 NIAGRA x GOLDWYN UTE DE BOS / LANDEIRA S.C. GALEGA A Coruña
3 2012 EPIC x OMAN OMAN IMPORTADO / S.A.T. A CAMPA A Coruña
3 2011 SNOWMAN x GOLDWYN A CAMPAZA, S.C. Lugo
3 2011 SHOTTLE x GOLDWYN GAN. DIPLOMADA BADIOLA, S.L. Asturias
3 2006 GOLDWYN x MORTY LLERA HER, S.C. Cantabria

SON SUAU INQUIRER SILVIA ESPH0702387833 2 2004 INQUIRER x AARON SON SUAU Baleares BARRANCO OUTSIDE RAIFLATE ESPH1402618628 2 2006 OUTSIDE x RAIDER GUADARRAMILLA Córdoba BOS REGGIE LEONOR ET ESPH1502537499 2 2005 REGGIE x BW MARSHALL UTE DE BOS / QUINTIÁN, S.C. Lugo 4623 ESPH1502658044 2 2003 ENEMY x BELLER IMPORTADO / S.A.T. O FERREIRO 977 XUGA A Coruña EL RODIÑO BAXTER RAMA ESPH1503330013 2 2010 BAXTER x BEST EL RODIÑO / ESPASANDÍN A Coruña GENER MODEST APOLLO 746 ESPH1702689715 2 2006 MODEST x DIPUTACIO ZEUS BES MAS GENER S.C.P. Girona PLANAS SUDOKU MOLA 1367 ESPH1702959409 2 2008 SUDOKU x RUDOLPH GRANJA CAN PLANAS,S.L. Girona REGIDOR LUPPY BOND-2741 ESPH1803335562 2 2010 LUPPY x BOND GANADERÍA REGIDOR, SAL NAG Granada B.RIU RUDOLPH 632 - 843 ESPH2502665504 2 2006 RUDOLPH x MOSAR FINCA BORDA DEL RIU, S.L. Lleida CASANA BLITZ 1614 ESPH2703005486 2 2008 BLITZ x STARTIT CASANA, S.C. Lugo XERCASPORTA ULISES TOXA ESPH2703113265 2 2009 XERCASPOR. ULISES SAM x CADOS PORTALOUSA Lugo MORADO XACOBEO 0753 ESPH2703315701 2 2010 XACOBEO x BOTAFOGO GANADERÍA MORADO, S.C. Lugo CID DUPLEX RACHELLE ESPH2703414321 2 2010 DUPLEX x GOLDWYN GANDEIRIA CID, S.C. Lugo PLANILLO AARON RIMULA ESPH3102431338 2 2005 AARON x PASION PLANILLO HOLSTEIN Navarra FERREIRO TALENT PINTA ESPH3302596739 2 2006 TALENT x EMINENZ ET GANADERÍA FERREIRO, S.C. Asturias BALDOMERO CAROLAIN GOLDWYN ESPH3302803583 2 2007 GOLDWYN x SEPTEMBER GANADERÍA BALDOMERO, S.C. Asturias PERITOP GOLDWYN CAMPANILLA ESPH3602954315 2 2008 GOLDWYN x STORMATIC PERITO Pontevedra OTOXAL CHISPO PERICA ESPH3603005553 2 2008 CHISPO x OUTSIDE O TOXAL, S.C. Pontevedra RUTH ESPH3902378255 2 2004 TIDY-BROOK x HIGHLIGHT S.A.T. CRUZ LEZAMA 39120 Cantabria MELISA ESPH3902564413 2 2005 STARTIT x FINCA LA PEÑA Cantabria MODE CHENOA IGNITER ESPH3902745367 2 2006 IGNITER x MUSCHIO GANADERÍA PELAYO-SARABIA, S.C. Cantabria BENERAPEREDA TEA BAXTER ESPH3902999794 2 2008 BAXTER x FREELANCE GANADERÍA BENERA Cantabria BOS LUCKY STAR MINA ET ESPH1502835641 2 2007 LUCKY STAR x BLITZ UTE DE BOS / GAN. CANDENDO, S.C. A Coruña BOS ANDURIÑA CLAUDIA SEPTEM.ET * ESPH1502910902 2 2008 SEPTEMBER x IGNITER ANDURIÑA A Coruña GAND-BATALLA BETABEL GOLDWYNET * ESPH1503385793 2 2010 GOLDWYN x BLITZ GANADERÍA BATALLA, S.C. A Coruña BOS COCHERO XACOBEO JESSICA ET * ESPH2703271029 2 2009 XACOBEO x GOLDWYN CASA COCHERO / GAN. SIXTO, S.C. A Coruña MOURISCADE GOLDWYN TREVI * ESPH3602904185 2 2007 GOLDWYN x FORBIDDEN DIP.PROV.PONTEVEDRA-F. MOURISCADE Pontevedra FOROS BETANZOS CARETA ESPH2703112345 1 2009 BETANZOS x LEE S.A.T. OS FOROS Lugo PRIEGOLA KARNVIEW MASCOL ESPH2802812885 1 2007 MASCOL x FORBIDDEN GANADERÍA PRIEGOLA S.A. Madrid VALLINES NAAT LHEROS ESPH3302594543 1 2006 LHEROS x PICARD GANADERÍA VALLINES Asturias TONJOVI SIREX BAILARINA ESPH3302967461 1 2008 SIREX x TONJOVI Asturias ARGELINA ESTEBAN ROMERA 43 ESPH3602590750 1 2006 ESTEBAN x HARRISON GANADERÍA ARGELINA Pontevedra ZORRILLA MILI 6 ESPH3902744523 1 2006 HIGHLIGHT x EMERSON S.A.T. ZORRILLA Cantabria CERCA LOVE 7932 (9657) ESPH4102862154 1 2007 LOVE x PATRON JIMÉNEZ DE LA ROSA, S.C. Sevilla Nombre Número Genealógico Año nac. Padre x Abuelo Materno Criador - Propietario actual o último conocido Provincia POZOSAA MARION TANI ET ESPH2702709572 3 2006 MARION x LEE CASA POZO, S.C / CASA PETO, S.C. Asturias LAR DE GRACOZA SPIRTE ACUARELA ESPH2702948963 3 2008 SPIRTE x GOLDWYN LAR DE GRACOZA, S.C. Lugo TENDEIRO TALENT 0113 ESPH2703096218 3 2008 TALENT x CHAMPION TENDEIRO,S.C. Lugo CASILMOURE ROUMARE MATILDE ESPH2703104545 3 2008 ROUMARE x XINZO CASILMOURE Lugo MENORA GOLDWYN 294 ESPH2703262901 3 2010 GOLDWYN x INCOME MENORA, S.A.T. 1208 XUGA Lugo
SHOTTLE 293 ESPH2703418113 3 2010 SHOTTLE x MOSCOW LÓPEZ TELLADO, MASEDA, S.C. Lugo
1231 ESPH2802354176 3 2004 AEROCERF x RECKLESS EXP. GANADERA VALDENEBRO, C.B. Madrid VALDENEBRO 216 ESPH2803308191 3 2010 BUCKEYE x BLITZ EXP. GANADERA VALDENEBRO, C.B. Madrid BERNABE MEGAN MEGATRIX ESPH3302156887 3 2003 MEGATRIX x LEE GANADERÍA BERNABÉ, S.C. Asturias BONITA ESPH3302158097 3 2003 NICOL x LEE GANADERÍA CIMA, S.C. Asturias LAURELES FRACY JUROR ESPH3302158516 3 2003 JUROR x SKYCHIEF S.A.T. GANADERÍA
MASEDA
VALDENEBRO
LOS LAURELES Asturias
ESPH3302730152 3
2006 MIRALLO x EWERTON ANDRESIN, S.C. Asturias
ESPH3303040747 3
GOLDWYN PALOMA
2008 GOLDWYN x JESTHER GANADERÍA GUARÍN, S.C. Asturias
ESPH3303466808 3
2010 ROUMARE x PRONTO GANADERÍA BALDOMERO, S.C. Asturias
ESPH4503294368 3
BAXTER MALU ESPH4802991249 3
BAXTER x THRONE FISURE
BALEAR
ET ESPH0503240385 3
AGROP.
TOM LOLA
AUGUST LION KING ET
2010 LION KING x CLASSIC CHIQUERO Toledo FISURE.CB
2008
PORTILLO, C.B. Vizcaya HS SHOTTLE
TWINE
2010 SHOTTLE x ALLEN
HNOS. SENOVILLA, S.L. Ávila BOS
40 Frisona Española 226 j/a





El programa de recogida de información de salud podal para la prevención y el control de cojeras en las ganaderías de vacuno de leche (I-SAP) cumple 7 años.
Un éxito rotundo que se debe en gran parte al compromiso incondicional de todos los podólogos adheridos al programa, liderados por ANKA y SERAGRO.
En estrecha colaboración con SERAGRO y la Facultad de Veterinaria de la Universidad Complutense de Madrid, CONAFE organiza, el próximo otoño, el IV Curso de Podología y la VII Unificación de Criterios entre Podólogos.
Para ello, con el patrocinio de ZOETIS, hemos invitado al Dr. Johann Kofler, profesor de la Fa-

Curso de dos días de duración destinado a profesionales de la podología
Precio de inscripción:
cultad de Veterinaria de la Universidad de Viena, especialista de reconocido prestigio internacional en salud podal bovina, que nos visita de nuevo, despues de haber participado en la II edicion de este curso, con gran éxito
Ribadeo (Lugo), 26 y 27 de octubre de 2018
El objetivo de esta edición del curso de podología es combinar el aprendizaje y la unificación de criterios entre los profesionales que se dedican a la podología. Por ello, las metas son:
• Una aproximación a la podología a nivel internacional.
• La unificación de criterios a través de la formación y el reciclaje de los podólogos participantes en la recogida de información de salud podal.
• La introducción de nuevos profesionales al programa.


*Comprende: Curso, alojamiento 2 días en habitación doble, almuerzos y cenas.
-Alojamiento en habitación individual, suplemento de 10 €.
-Días adicionales de hotel, consultar precios y disponibilidad en CONAFE.
Podología
Curso de
Plazas limitadas Información e inscripciones en CONAFE Tlf.: 91 895 24 12 conafe@conafe.com 4º
C o n a f e Resumen de la Memor ia CONAFE 2017

INTRODUCCIÓN
Iniciamos el año 2017 con el famoso indulto a la vaca Carmen en la Comunidad de Madrid, que tanta polémica suscitó por el agravio comparativo que supuso frente a las exigencias que se imponen a las ganaderías, de sacrificio de animales,
Se mantiene la tendencia al alza de la media de reproductoras por explotación, que en 2017 fue de 83 vacas
cuando surge algún positivo a tuberculosis, aunque posterior mente no se confir me en matadero
En cuanto al sector, poco ha cambiado el panorama respecto a años anteriores: hubo intentos de proporcionar un valor añadido a los lácteos producidos en nuestro país añadiéndoles un distintivo que pretendía mostrar, además del origen, el esfuerzo que se hace por parte de la industria en la sostenibilidad del sector; lamentablemente, estos mismos productos se siguen vendiendo a pérdidas en los lineales de la distribución Tampoco el déficit de mantequilla en el mercado mundial ha contribuido de manera importante a incrementar los precios
A efectos del Libro Genealógico 2017 ha supuesto un mantenimiento en el número de reproductoras, con 479.165 a finales de año (953 menos que en 2016), y un descenso en el número de ganaderías, hasta las 5 794, lo que resulta en un incremento del tamaño medio de las mismas hasta las 82 reproductoras (cuadros 1 y 2)
Los esfuerzos en CONAFE se han concentrado en dar un mejor servicio de evaluación genómica a los asociados, de manera que se han evaluado 10.300 hembras, 4.800 más que en 2016. Para aprovechar esta herramienta se han realizado mejoras en el programa de acoplamientos, CONAFEMAT, en el sistema de infor mación, SINBAD, y en el gestor de la base de datos, GESLIB, y se han organizado un

buen
de jor nadas de for mación para el aprovechamiento de la Genómica, tecnología desarrollada por los ganaderos para los ganaderos
Por otra parte, continuamos con el proyecto ISA incrementando el número de ganaderías participantes. Estamos convencidos de que, a través de la Mejora Genética, podemos contribuir a usar de for ma prudente los antibióticos Por otra parte, nos hemos involucrado en un proyecto de investigación, con INIA y Neiker, a través del cual obtendremos infor mación de emisiones de metano y de eficiencia energética porque la sostenibilidad ambiental es también una de nuestras responsabilidades
En definitiva, los ganaderos son los que pueden ayudarse a sí mismos, invirtiendo sus esfuerzos en ser más rentables y en contribuir con su esfuerzo a la sostenibilidad Está claro que no pueden confiar en que otros vengan a solucionar sus problemas
LIBRO GENEALÓGICO
Desde el año 2009 el Real Decreto 2129/2008, de 26 de Diciembre, por el que se establece el Programa Nacional de Conser vación y Mejora de las Razas Ganaderas, constituye la base legal del Libro Genealógico y de las actividades que su desarrollo conlleva Nuestro actual Reglamento del Libro Genealógico para adaptarse a las exigencias del Real Decreto, ha sido objeto de modificaciones que recogen los avances que hay que introducir para el mejor desarrollo de la actividad ganadera de selección y fue aprobado por Resolución de la Dirección General de Recursos Agrícolas y Ganaderos el 27 de junio de 2011

42 Frisona Española 226 j/a CC AA Explota Reproductoras Andalucía 161 = 26 175 ↑ Aragón 12 ↓ 7 206 ↑ Baleares 147 ↓ 9 718 ↓ Cantabria 759 ↓ 45.853 ↓ Castilla y León 307 ↓ 45 074 ↑ Castilla-La Mancha 80 ↓ 13 490 ↑ Cataluña 274 ↓ 49 359 ↓ Cdad Madrid 21 ↓ 4 500 ↑ Cdad Valenciana 3 = 1.979 ↑ Extremadura 2 ↓ 229 ↑ Galicia 2 693 ↓ 188 883 ↑ Navarra 110 ↓ 17 626 ↓ País Vasco 249 ↓ 18 962 ↓ Ppado de Asturias 877 ↓ 49.394 ↓ Varios 99 ↓ 717 ↓ Totales 5 794 479.165 ↓
número
Tauste Ganadera (Aragón) Frisona Española Enero/Febrero 2017

Estas reglamentaciones, se complementan con las nor mas y directrices que emanan de los órganos de gobier no de CONAFE, autorizada legalmente para la gestión y desarrollo del Reglamento del Libro Genealógico de la Raza
El Libro Genealógico es pilar básico e imprescindible para desarrollar cualquier programa de mejora y de selección de la raza, y en él se inscribe y se mantiene toda la infor mación relacionada con genealogías, calificaciones mor fológicas, producciones, índices de mejora, filiaciones genéticas, consanguinidad, premios, méritos y otros, con el fin de que toda esta infor mación esté integrada en una base de datos única lo que constituye la referencia integradora más amplia de cualquier proceso infor mático para el desarrollo de la raza frisona
La infor mación de las genealogías se viene infor matizando desde el año 1979 a la base de datos del Libro Genealógico Desde el año citado, también se vienen incorporando a esta misma base de datos la calificación mor fológica las producciones y otros datos relativos a la actividad productiva individual de los animales de raza frisona de las explotaciones incluidas en el Libro Genealógico La infor mación del Libro Genealógico, anterior a esa fecha, se encuentra en poder de CONAFE, en los documentos que en cada provincia se habilitaron para la llevanza del Libro Genealógico
Registros Genealógicos
El Registro de Animales es una de las actividades de la gestión del Libro Genealógico, cuyo servicio se presta a los ganaderos, bien directamente por CONAFE, o bien a través de las Asociaciones/ Federaciones integradas en la Confederación tales como: AFA (Andalucía); AFB (Baleares); AFCA (Cantabria); AFNA (Navarra); AFRICAMA (Castilla-La Mancha); ASCOLAF (Asturias); EFRIFE (País Vasco); FEFRIC (Cataluña), FEFRICALE (Castilla y León) y FEFRIGA (Galicia).
Los registros en el Libro Genealógico de la Raza Frisona Española se dividen en dos secciones: Auxiliar (RA) y Principal (RP) En 2017 el número de animales inscritos y vivos fue de 735 755, de los que 2 794 eran machos
Registros en el año 2017
La inscripción en el año 2017 ha sido de un total
de 165 629 animales, lo que indica un descenso respecto al año anterior, de 3 197 animales, es decir, un 1,9% menos (Cuadro 3)
Por registros, aumenta en 97 animales el Registro Auxiliar “A” disminuye en 235 el Registro Auxiliar “B”
Cuadro 3 Registros del año 2017 por CC AA


CC AA N º d e G a n a d . Hembras Machos TOTAL Registro Auxiliar “A” Registro Auxiliar “B” Registro Principal Total Hemb Sin Calif Con Calif Total Mac Crías Repro Total Crías Repro Total Crías Repro Total Andalucía 161 268 2 211 2 479 743 1 787 2 530 10 431 22 177 32 608 37 617 149 56 205 37 822 Aragón 12 132 197 329 86 250 336 4 498 6 759 11 257 11 922 4 2 6 11 928 Baleares 147 25 619 644 77 448 525 2 786 8 651 11 437 12 606 113 22 135 12 741 Cantabria 759 475 4 899 5 374 1 716 4 099 5 815 21 618 36 855 58 473 69 662 268 34 302 69 964 Castilla y León 307 404 3.582 3.986 1.526 2.205 3.731 24.447 39.287 63.734 71.451 52 16 68 71.519 Castilla-La Mancha 80 252 1 734 1 986 617 1 168 1 785 6 234 10 588 16 822 20 593 53 23 76 20 669 Cataluña 274 387 4 497 4 884 2 079 3 533 5 612 23 825 41 329 65 154 75 650 224 33 257 75 907 Cdad de Madrid 21 92 621 713 146 277 423 1 592 3 602 5 194 6 330 4 0 4 6 334 Cdad Valenciana 3 0 11 11 5 22 27 920 1 946 2 866 2 904 0 0 0 2.904 Extremadura 2 0 3 3 1 4 5 135 222 357 365 0 0 0 365 Galicia 2 693 1 590 10 144 11 734 4 633 11 979 16 612 97 506 166 760 264 266 292 612 631 151 782 293 394 Navarra 110 301 1 179 1 480 528 933 1 461 9 396 15 514 24 910 27 851 47 7 54 27 905 País Vasco 249 354 1 006 1 360 317 607 924 10 057 17 349 27 406 29 690 68 5 73 29 763 Principado de Asturias 877 298 3 186 3 484 1 099 2 885 3 984 21 242 43 323 64 565 72 033 273 83 356 72.389 Varios 99 40 67 107 67 68 135 851 582 1.433 1.675 456 20 476 2.151 Total nacional 2017 5 794 4 618 33 956 38 574 13 640 30 265 43 905 235 538 414 944 650 482 732 961 2 342 452 2 794 735 755 Total nacional 2016 6 086 5 211 34 238 39 449 14 153 33 005 47 158 238 002 412 875 650 877 737 484 3 106 728 3 834 741 318
2. Animales inscritos y vivos al 31 12 17 j/a 226 Frisona Española 43
Cuadro
CC AA Reg Auxiliar Reg Principal Total Rg "A" Rg "B" Nacim Import Machos Andalucía 824 539 5 720 826 70 7 979 Aragón 74 57 2 877 66 3 074 Baleares 79 33 1 615 25 25 1.777 Canarias 107 107 Cantabria 1 673 1 058 13 008 384 141 16 264 Castilla y León 1 075 928 13 874 154 11 16 042 Castilla-La Mancha 684 368 3 733 220 7 5 012 Cataluña 1 459 1 430 15 129 819 160 18.997 Cdad. de Madrid 244 100 1.034 49 1.427 Cdad Valenciana 1 650 17 668 Extremadura 57 57 Galicia 3 156 2 640 57 704 1 768 271 65 539 Navarra 339 321 5 588 132 8 6.388 País Vasco 360 187 5 818 154 27 6 546 Principado de Asturias 972 668 13 027 487 96 15 250 Varios 45 28 381 33 15 502 Total nacional 2017 11 091 8 358 140 215 5 134 831 165 629 Total nacional 2016 10.994 8.593 143.959 4.362 918 168.826
El Carrizal (Córdoba) Frisona Española Enero/Febrero 2017
Resumen de la Memoria 2017

y aumenta en 772 el Registro de Importadas. Disminuye en 87 la inscripción en el Registro de Machos y disminuye en 3.744 animales en el Registro Principal de Hembras.
a)Sección Auxiliar
En el Registro Auxiliar se inscriben las hembras que, poseyendo las características étnicas de la raza, carecen total o parcialmente de documentación genealógica que acredite su ascendencia o incumplen la normativa de la gestión del Libro.
El Registro Auxiliar se clasifica en: Registro Auxiliar “A” y Registro Auxiliar “B”. En el año 2017 se han re-
Cuadro 4. Evolución del Libro Genealógico en los últimos 5 años


gistrado 11.091 animales en el Registro “A” y 8.358 en el “B”. El número total de animales registrados en el Registro Auxiliar a final del año ha sido de 19.449 animales, de los que el 57% son de Registro Auxiliar “A” y el 43% de Registro Auxiliar “B”. Ambos representan el 13,90% de todos los animales registrados en el año 2017 en el Libro Genealógico.
Con respecto al año anterior se han registrado 138 animales menos en el Registro Auxiliar, lo que representa un decremento del 1%.
b)Sección Principal
La sección Principal del Libro Genealógico se subdivide en varios registros: Principal, Importadas, Toros y Méritos.
1.Registro Principal. En él se inscriben las hembras que provienen de padres y abuelos inscritos en el mismo registro. El registro ha sido ligeramente superior al del año anterior.
En el ejercicio de 2017 se han registrado 140.215 hembras. Ha sido la C.A. de Galicia la que, con 65.539 animales (el 46,74%), más registro ha tenido. Siguen a ésta en orden creciente de animales de registro principal registrados en 2017 Cataluña con 18.997, Cantabria con 16.264, Castilla y León con 16.042 y Asturias con 15.250.
2.Importadas. Se registran las hembras procedentes de la UE y terceros países. En 2017 se ha producido un aumento en la inscripción de 772 animales frente a 2016.
3.Toros. Se inscriben en este registro los toros que provienen de otros Libros Genealógicos y los nacidos de padres y madres del Registro Principal. En 2017 se registraron 831 machos, lo que representa un decremento sobre el año anterior de 87 toros.
Toros-Padres de los animales registrados en 2017
De las 149.464 animales registrados en 2017 (sin incluir RAA e importadas), el 43% son hijas de toros nacionales y el 57% extranjeros.
Evolución del L. G. en los últimos cinco años
El Cuadro 4 refleja la evolución de los datos de Registro y los de Calificación Morfológica. Se observa el incremento de la media de reproductoras por ganadería.
Fiabilidad del Libro: Pruebas de Filiación y Huellas Genéticas por ADN
El Laboratorio de Genética Molecular de Xenética-Fontao, es el laboratorio designado por CONAFE para realizar las pruebas de filiación mediante la determinación de 17 loci (en algunos casos hasta 30), todos ellos normalizados y homologados por la Sociedad Internacional de Genética Animal (ISAG).
El objetivo a conseguir es conocer la fiabilidad de las genealogías del Libro Genealógico y detectar fallos o posibles fraudes en el mismo.
En el año 2017 la Junta de Gobierno aprobó la realización de 600 muestras aleatorias. La distribución de los análisis se ha llevado a cabo por CC.AA., tendiendo a una proporcionalidad por C.A. en relación con los registros y reproductoras.
Se han realizado un total de 446 muestras y los resultados del muestreo aleatorio han sido de un 4,24% de negatividad. Aparte del muestreo aleatorio en 2017, se han comprobado la filiación en 10.979 muestras de SNP. Por otra parte las evaluaciones genómicas permiten el chequeo de la genealogía a través de los SNPs.
2017 2016 2015 2014 2013 Ganaderías 5.794 6.086 6.500 6.813 7.052 Reproductoras 479.165 480.118 494.900 500.500 491.896 Vacas/ganadería 83 79 76 73 70 Registro 165.629 168.826 168.205 169.841 164.618 Auxiliar “A” 11.091 10.994 10.895 12.430 10.763 Auxiliar “B” 8.358 8.593 9.243 9.921 10.428 Principal Machos 831 918 927 1.261 1.279 Principal Hembras 140.215 143.959 141.975 140.474 137.152 Importadas 5.134 4.362 5.165 5.755 4.996 Ganaderías visitadas 5.871 6.457 7.077 6.917 7.388 Animales calificados 132.726 127.951 132.340 127.477 126.145 Excelentes 339 289 248 235 191 Muy Buenas 8.318 7.000 6.127 5.988 4.945
44
226 j/a
Frisona Española
Cudaña (Cantabria) Frisona Española Marzo/Abril 2017
Itzibar (Guipúzcoa) Frisona Española Marzo/Abril 2017



En las fotos sobre estas líneas, reunión anual de los técnicos calificadores en las ganaderías Somapando y Mijares, ambas en el Valle de Soba (Cantabria) Abajo, durante la reunión de diciembre, en las ganaderías Teixo-Lamas, Berlai y Casa do Cabo, las tres en la provincia de Lugo


CALIFICACIÓN MORFOLÓGICA
Se comenzó el año con once meses de intervalo y se ha mantenido en la misma cifra, calificándose 132 578 hembras y visitado 5 871 fincas
Durante el año también se calificaron 148 machos y se valoraron 8.841 hembras como Aptas en el registro auxiliar (Cuadro 5)
Como en años anteriores, Ávila, Cádiz, Lugo, Cantabria, Girona, Lleida, Navarra, Vizcaya y Asturias son las más interesadas en el servicio de calificación a petición de parte, habiéndose calificado durante este año 819 animales en 38 ganaderías (petición de parte conjunta) y 281 animales en 15 ganaderías (petición de parte individual).
En el trascurso del año 2017 se ha realizado dos reuniones de unificación de cr iter ios de la calificación mor fológica con la participación de los técnicos calificadores y los del Dpto Técnico y TIC, la primera tuvo lugar en el mes de abril en las gana-





derías Somapando y Los Mijares del Valle de Soba (Cantabria) La segunda unificación se realizó en el mes de diciembre en la provincia de Lugo en las ganaderías Teixeiro-Lamas, Berlai y Casa de Cabo

CC AA Fincas visitadas Machos Hembras Total animales EX MB BB B R IN Total EX MB BB B R IN RA Aptas Total Andalucía 160 1 9 10 3 0 0 23 33 544 3 558 2 772 259 2 617 7 785 7 808 Aragón 16 0 1 0 0 0 0 1 0 68 924 750 48 1 66 1.857 1.857 Baleares 42 0 2 8 3 0 0 13 18 326 1 272 770 37 0 134 2 557 2 570 Cantabria 738 0 4 12 11 0 0 27 47 746 5.638 4.774 353 5 1.368 12.931 12.958 Castilla y León 300 1 1 2 0 0 0 4 22 733 5 873 3 779 213 1 850 11 471 11 475 Castilla-La Mancha 96 0 1 0 1 0 0 2 2 104 1 578 1 377 127 6 480 3 674 3 676 Cataluña 307 0 6 10 0 0 0 16 34 727 6 454 5 365 383 16 1 347 14 326 14 342 Cdad de Madrid 21 0 0 0 0 0 0 0 32 465 316 22 1 140 976 976 Cdad Valenciana 4 0 0 0 0 0 0 0 1 20 247 307 21 0 2 598 598 Extremadura 2 0 0 0 0 0 0 0 0 3 37 12 1 0 0 53 53 Galicia 2 860 0 4 23 7 0 0 34 89 2 931 25 140 20 859 1 470 43 2 462 52 994 53 028 Navarra 134 0 1 1 1 0 0 3 20 282 2 171 1 758 170 6 272 4 679 4 682 País Vasco 244 0 0 0 0 0 0 0 13 416 2 723 2 067 135 2 326 5 682 5 682 Principado de Asturias 847 0 9 13 3 0 0 25 58 1 348 7 021 3 677 112 2 777 12 995 13 020 Total nacional 2017 5.871 2 38 79 29 0 0 148 337 8.280 63.101 48.583 3.351 85 8.841 132.578 132.726 Total nacional 2016 6 457 4 46 122 29 2 0 203 285 6 954 59 399 48 817 3 518 60 8 715 127 748 127 951 Cuadro 5 Calificaciones por autonomías y categorías en el año 2017 j/a 226 Frisona Española 45
Resumen de la Memor ia 2017
Cuadro 6 Lactaciones ter minadas y válidas en el período de enero a diciembre de 2017 Total nacional

CONTROL LECHERO
CONAFE es la organización responsable de la gestión de la Base de datos nacional de Control Lechero de la raza frisona, según lo establecido en el Real Decreto 368/2005, de 8 de abril, por el que se regula el Control Lechero Oficial del Rendimiento Lechero para la Evaluación Genética en las especies bovina, ovina y caprina, modificado por la Resolución de 22 de octubre de 2013, de la Dirección General de Producciones y Mercados Agrarios, por la que se publican las recomendaciones publicadas por el Comité Inter nacional para el Control de Rendimiento Animal, de acuerdo con las instruccio-



nes de aplicación de las mismas establecidas por la Comisión Nacional de Control Lechero Oficial En este sentido, a lo largo del 2016 se han realizado diferentes trabajos en cuanto a la gestión y mantenimiento de la Base de Datos nacional de Control Lechero, entre ellos: recibir e integrar en la base de datos los ficheros bimestrales de lactaciones y controles mensuales procedentes de las distintas CC.AA, con el fin de actualizar la Base de datos nacional; recibir e integrar en la base de datos los datos de facilidad de parto, velocidad de ordeño e inseminaciones, que se reciben cada dos meses; corrección de errores de inseminaciones, facilidad de parto y velocidad de ordeño y mejoras en la integración de los datos de Control Lechero histórico con los datos de control lechero asentados en la base de datos.
Las lactaciones finalizadas y válidas de 2017 aparecen en el Cuadro 6 La evolución fenotípica en nuestro país se muestra en el Cuadro 7
Estructura del Control Lechero
Con algunas pequeñas modificaciones que se hayan podido producir reproducimos la estructura de controladores, explotaciones y cantidad de reproductoras (Cuadro 8). Las reproductoras son consideradas como tales a partir de 24 meses aunque no tengan lactación alguna Recordamos que todas las reproductoras están obligadas a estar en Control Lechero, así como todas las ganaderías del L G
EVALUACIONES GENÉTICAS EN 2017
Evaluaciones Genéticas Nacionales
En los siguientes cuadros se muestra el número de lactaciones y calificaciones utilizadas en las evaluaciones genéticas de Noviembre’16 Noviembre’17 y la variación en la misma de una evaluación a otra En todos los casos se incorporan más cantidad de infor mación que en la evaluación del año anterior
Evaluaciones genómicas
Las pruebas genómicas de la raza frisona española se obtienen gracias a la aportación de los si-
Cuadro 9. Lactaciones y calificaciones utilizadas en las evaluaciones genéticas


Cuadro 10 Vacas vivas evaluadas y con índices
Nov.’16 Nov.’17 Variación Producción 360 040 360 682 642 T ipo 324.048 323.347 -701 RCS 358 774 359 444 670 Lactaciones Nov.’16 Nov.’17 Variación Producción 5 792 275 6 083 153 290 878 Longevidad 5.167.645 5.237.211 291.288 RCS 5 347 566 5 637 860 286 638 Días abiertos 1 485 926 1 570 922 85 835 Velocidad ordeño 858 651 945 458 90 671 Calificaciones Nov ’16 Nov ’17 Variación 2 098 676 2 212 865 110 388 Período Nº Lact Edad meses Días Kg Leche Grasa Proteína Rendt diario Kg % Kg % 2012 347.317 47 369 11.115 409 3,68 362 3,26 30,16 2013 344 764 46 370 11 172 414 3,71 365 3,71 30,23 Cuadro 7 Evolución fenotípica en España
46 Frisona Española 226 j/a Estación de Monells (Girona) Frisona Española Mayo/Junio 2017 Autonomías Controladores Media de Gan./ Controlador Media de Repr./ Controlador Andalucía 7 23 3 744 Aragón 1 12 7 213 Baleares 7 21 1 389 Cantabria 24 32 1 912 Castilla-La Mancha 3 27 4 502 Castilla-León 16 19 2 820 Cataluña 25 11 1 976 Cdad de Madrid 2 11 2 252 Cdad Valenciana 1 3 1 981 Extremadura - -Galicia 94 29 2 011 Navarra 5 22 3.527 País Vasco 14 18 1 356 Ppado. de Asturias 26 34 1.901 Lactaciones Nº lactac. Edad meses Medias lactación natural Medias lactación 305 días Días Kg Leche Grasa Proteína Rendimiento diario Kg Leche Grasa Proteína Kg % Kg % Kg % Kg % Primera 119 715 26 370 11 029 407 3,69 363 3,29 29,77 9 196 333 3,63 297 3,23 Segunda y sig 224 341 56 368 12 329 458 3,71 403 3,26 33,55 10 662 391 3,67 341 3,20 Total 344.053 46 369 11.877 44 3,71 389 3,27 32,23 10.152 371 3,65 326 3,21
guientes organismos, empresas y particulares:
• Ministerio de Agricultura, Alimentación y Medio Ambiente (MAGRAMA), que por convenio con CONAFE, hizo posible el genotipado de una gran parte de los toros de la población de referencia española. Estos animales se genotiparon en el Laboratorio Central de Veterinaria de Algete.
• Instituto Nacional de Investigación y Tecnología Agraria y Alimentaria (INIA), que mediante los convenios firmados con CONAFE, ha desarrollado las ecuaciones de predicción de los valores genómicos y trasferido esta tecnología a CONAFE.
• Xenética Fontao, S.A. que, por convenio con CONAFE, ha cedido a CONAFE los genotipos de sus toros para incorporarlos a la población de referencia y ofrece a CONAFE un servicio laboratorio de genotipado a precios competitivos.
• Aberekin, S.A.; Ascol, S.Coop.L. y Genétical, S.Coop., que aportaron muestras de sus toros para la población de referencia.
• FEFRIGA y ganaderos particulares que proporcionaron muestras de semen de toros para la población de referencia española.
• Casas comerciales que proporcionaron pajuelas de semen de toros para la población de referencia española (Semex, Albaitaritza, CRV, World Wide Sires, Progenex, Eurofomento, CRI y Global Genetics).
• Aberekin, S.A.; Ascol, S.Coop.L.; Genétical, S.C. y Xenética Fontao, S.A. que han acordado con CONAFE la incorporación al acuerdo de EuroGenomics, donde CONAFE representa a los ganaderos españoles y a los programas de testaje españoles, con el objetivo de incrementar la población de referencia y hacer más fiables las evaluaciones genómicas españolas.
Las ecuaciones de predicción de los valores genómicos se han obtenido utilizando la población de referencia del acuerdo de EuroGenomics, formada por más de 30.000 toros. Este acuerdo está suscrito por las siguientes empresas: Evolution y Genes Diffusion (Francia), CRV (Países Bajos), Viking Genetics (Dinamarca, Suecia y Finlandia), BRS (Alemania), Vit (Alemania), Genomika Polska (Polonia) y CONAFE, junto con Aberekin S.A., Ascol S.Coop.L, Fefricale Soc. Genética S.L. y Xenética Fontao S.A.

Evaluaciones Internacionales
Las pruebas de descendencia de los toros obtenidas en la evaluación genética nacional se han integrado en las evaluaciones MACE y evaluaciones GMACE que ha realizado INTERBULL en 2017 para producción, conformación, recuento de células somáticas, longevidad y fertilidad.

En los cuadros 12 y 13 (siguiente pagina) se muestran las correlaciones genéticas utilizadas por INTERBULL en el MACE de Diciembre de 2017 entre España y los principales países exportadores de semen para los 5 grupos de caracteres considerados (producción, conformación, recuento de células somáticas y longevidad funcional). Se aprecia un alto grado de semejanza entre las pruebas de los distintos países incluido España. Las pruebas MACE de Interbull en la base y escala española se combinan en CONAFE con su información genómica cuando se dispone de ella y estas pruebas combinadas son oficiales en nuestro país para aquellos toros extranjeros sin prueba en el Catálogo de Sementales de CONAFE. De forma similar las pruebas GMACE de los toros jóvenes de otros países que no tienen prueba oficial en España también son oficiales. Todas las pruebas oficiales se muestran en la web de CONAFE (www.conafe.com).
Programa de Mejora en 2017
En 2017 se han realizado mejoras en evaluacio-

Cuadro 12. Correlaciones genéticas entre España y los principales países exportadores de semen. (Centro de Interbull diciembre 2017)

2017 Carácter CAN ALE FRA ITA HOL EEUU Kg proteína 0,90 0,86 0,88 0,86 0,87 0,90 RCS 0,92 0,95 0,96 0,95 0,91 0,91 Longevidad 0,84 0,83 0,54 0,85 0,61 0,84 Días Abiertos 0,87 0,88 0,95 0,87 0,87
Los Jerónimos (Toledo) Julio/Agosto
Autonomía Total Andalucía 1.105 Baleares 58 Cataluña 2.824 Galicia 1.835 Cantabria 249 Castilla y León 1.304 Castilla-La Mancha 135 Navarra 565 País Vasco 1.805 Principado de Asturias 168 Total 10.046
j/a 226 Frisona Española 47
Mas Gener (Girona) Frisona Española Mayo/Junio 2017
Resumen de la Memor ia 2017
Cuadro 13 Correlaciones genéticas para caracteres de tipo

nes genéticas en cuanto a la longevidad, con un nuevo estudio de caracteres con influencia en Longevidad Combinada y la publicación de nuevos valores genéticos de longevidad de las vacas; y en cuanto a la rutina en control de calidad de genotipos, con la mejora en la gestión de genotipos (duplicados, identificaciones), el análisis de nuevos SNPs para valoración (validación de resultados y se-


lección de SNPs) y el seguimiento de inclusión de infor mación y mejoras en el chip de baja densidad. También se han llevado a cabo nuevas evaluaciones de Fertilidad (con mejora de la infor mación relativa al tipo de inseminación), Facilidad de Parto Genómica y Salud Podal (evaluación e índice)
Entre otros trabajos, se ha dado comienzo a los relacionados con la elaboración del ICO 2018: longevidad salud podal facilidad de parto (mater na) y caracteres de óptimo inter medio.
Entre los proyectos con nuevos caracteres destacan el ISA-Salud Animal, ISAP-Salud Podal, eficiencia alimentaria (con Granja Mouriscade) y el proyecto RTA de emisiones de metano y eficiencia (INIA y Neiker)
PROMOCIÓN
38º Concurso Nacional de Otoño CONAFE 17
Coincidiendo con la celebración de Agropec en el Recinto Ferial de Asturias “Luis Adaro”, de Gijón, CONAFE organizó del 28 de septiembre al 1 de octubre una nueva edición del Nacional de Otoño en la que participaron 41 ganaderías y 134 animales
El Nacional de 2017 tuvo dos novedades Por un lado la celebración de las secciones tanto de terneras y novillas como de vacas, en un solo día (el sábado 30 de septiembre), pasando la celebración del Campeonato de Manejadores a la mañana del domingo, 1 de octubre La segunda novedad fue el desfile de campeonas que tuvo lugar la mañana del domingo
Se aprovechó el desfile de las campeonas para dedicar un recuerdo a Domnino Garrote Director Gerente de la Confederación hasta 2009, que falleció en junio de 2017. También rindió un homenaje a Gabriel Blanco del Campo con motivo de su jubilación
Se encargó del juzgamiento Jean-Baptiste Decheppe, Juez de la Prim Holstein Francia, quien eligió como Gran Campeona Nacional de Novillas a Celis Andrea Bulería Atwood de Hnos Celis Gutiérrez (Cantabria) elegida también Novilla Campeona.
La Vaca Adulta Campeona y Gran Campeona Nacional fue Badiola Atwood Koketa, de Gand Diplo Badiola (Asturias)
ASCOLAF, con 98 puntos, consiguió para Asturias el título de Mejor Autonomía y AFCA, con 88 puntos, alcanzó para Cantabria el premio de Segunda Autonomía
En las secciones de Mejor Rebaño y Mejor Criador, Casa Flora y Gan. Dipl. Badiola empataron con


 Ganadería Badiola (Asturias) Septiembre/Octubre 2017
La Novilla Gran Campeona Celis Andrea Bulería Atwood (Hnos Celis Gutiérrez, Cantabria) y la Vaca Gran Campeona, Badiola Atwood Koketa (Ganadería Badiola, Asturias)
Ganadería Badiola (Asturias) Septiembre/Octubre 2017
La Novilla Gran Campeona Celis Andrea Bulería Atwood (Hnos Celis Gutiérrez, Cantabria) y la Vaca Gran Campeona, Badiola Atwood Koketa (Ganadería Badiola, Asturias)
Carácter CAN ALE FRA ITA HOL EEUU Estatura 0,98 0,98 0,98 0,96 0,96 0,96 Anchura pecho 0,93 0,82 0,86 0,81 0,86 0,86 Profundidad corporal 0,89 0,91 0,85 0,87 0,90 0,90 Angulosidad 0,88 0,74 0,84 0,84 0,75 0,85 Ángulo grupa 0,97 0,98 0,97 0,96 0,97 0,96 Anchura grupa 0,97 0,94 0,95 0,87 0,94 0,88 Vista lateral patas traseras 0,95 0,95 0,90 0,90 0,92 0,95 Vista posterior patas traseras 0,86 0,87 0,86 0,79 0,85 0,78 Ángulo podal 0,86 0,85 0,85 0,74 0,80 0,85 Inserción anterior 0,88 0,82 0,83 0,86 0,86 0,88 Altura inserción posterior 0 82 0 90 0 88 0 91 0 91 0 89 Ligamento suspensor 0,87 0,79 0,83 0,91 0,89 0,91 Profundidad de ubre 0 97 0 96 0 97 0 98 0 96 0 97 Coloc pezones anteriores 0,97 0,97 0,92 0,86 0,95 0,93 Longitud pezones 0 93 0 98 0 92 0 93 0 98 0 96 Coloc pezones posteriores 0,98 0,98 0,98 0,93 0,98 0,96 Miembros y aplomos 0,82 0,72 0,75 0,69 0,66 0,72 Movilidad 0,71 0,74 0,75 0,73 0,68 0,70
48 Frisona Española 226 j/a


90 puntos. Sin embargo, Casa Flora consiguió el primer puesto en ambas categorías al haber conseguido más primeros puestos de sección, como se indica en el Reglamento del Concurso, siendo para Badiola los estandartes de Segundo Rebaño y Segundo Criador.
En cuanto a los mejores manejadores del Nacional, fueron elegidos, por este orden: Adrián Entrecanales, Javier Ranero y Gregorio Blanco.
XVII Campeonato Nacional de Manejadores CONAFE`17
El 1 de octubre se celebró una nueva edición del Campeonato de Manejadores, juzgada por los jueces internacionales de CONAFE, Bonet Cid y Jaume Serrabassa.
Participaron veinte manejadores, siendo los resultados los siguientes:
Categoría sénior:
- Campeón: Guillermo Orfila (Baleares)
- Subcampeona: Cristina Truyol (Baleares)
Categoría júnior:
- Campeón: Abel Carballo (Galicia)
- Subcampeona: Jon Vivanco (Cantabria)
Categoría infantil:
- Campeona: Elsa Planillo (Navarra)
- Subcampeona: Lorena Iglesia (Galicia)

V Unificación de Criterios entre Podólogos I-SAP Durante los días 27 y 28 de octubre, coincidiendo con el 3º Curso de Podología de CONAFE, tuvo lugar el VI Encuentro para la Unificación de criterios entre podólogos I-SAP. Se contó con la participación de varios especialistas y se visitaron las explotaciones navarras Cooperativa San Miguel de Aralar y S.C.L. Aldapa.
Títulos a animales y ganaderías
Como es habitual, CONAFE otorgó los diferentes títulos y reconocimientos a las hembras y explotaciones que se conceden después de cada evaluación genética.
A continuación aparece la relación de ganaderías, ordenadas alfabéticamente, a las que se ha concedido el título de MAESTRO CRIADOR en la evaluación de noviembre de 2017. Aparecen con asterisco las ganaderías que ya obtuvieron este título en 2007. Este título solo se puede obtener cada diez años.
* Gandeiria Cid, S.C. - Lugo
* Granja Raquel, S.C. - Palencia
La Mesquería, S.C. - Cantabria
La Nave, S.C. - Lugo
López Lunar – Córdoba
Los Mijares - Cantabria
Los Parronales – Córdoba
Lucho, S.C. - Asturias
Marjal Vella - Baleares
O Coto – A Coruña


Los Caserinos (Asturias) Septiembre/Octubre 2017
Reciclaje de Jueces en S.A.T.Rey de Miñotelo
j/a 226 Frisona Española 49
Guillermo Orfila, Elsa Planillo y Abel Carballo, ganadores sénior, infantil y júnior del Campeonato de Manejadores CONAFE’17
Resumen de la Memoria 2017

Hnos. Celis Gutiérrez (Cantabria) Septiembre/Octubre 2017
* Outeiro, S.C. - Lugo
* Ramaderia Can Thos, S.L. - Barcelona
* Rosado Hontanilla, S.L. - Toledo
* S.A.T. Lodos e Pérez N.940 Xuga - Lugo Santa Lucía, S.C. – A Coruña
Jueces de CONAFE en activo
El mes de marzo el panel de jueces de CONAFE se reunión para su habitual jornada de reciclaje. En esta ocasión fue la ganadería Rey de Miñotelo (A Pastoriza, Lugo), la que colaboró con esta actividad facilitando sus instalaciones y animales.
A continuación se relacionan los Jueces Activos: Javier Álvarez Lastra, José Ramón Arronte Diego, Paulino Badiola Fernández, José Ramón Badiola García, Bonet Cid Salgado, Pol Collell Sabaté, Francisco Javier Freije Freije, Santiago García Souto, Conrado González Antón, Jordi Juanola Codina, José Manuel Paz Conde, Joaquim Sabrià Pujol, Luis Saiz Río, Roberto Saiz Río y Jaume Serrabassa Vila.
FORMACIÓN
12ª Escuela De Preparadores
ºLa 12ª edición de la Escuela de Preparadores se celebró del 3 al 7 de julio en las instalaciones del I.E.S. de Luces (Colunga, Asturias), con la participación de 24 alumnos que formaron cuatro equipos: “Son Rulla”, elegido Mejor Equipo; “SAT La Élite”, Segundo Equipo; “Holstein Star” y “G. L’Heura”.
Para la organización y desarrollo de la Escuela se contó con la colaboración, además del I.E.S. de
Preparadores CONAFE 2017


Luces, de Servicio de Podología Pura, Fundación Caja Rural y ASA.
En esta edición, el director de estas jornadas fue Juan Manuel Fernández Ahedo, tomando el relevo de Gabriel Blanco tras la jubilación de este, y el cuadro técnico lo formaron Bonet Cid y los hermanos Jaume y Quim Serrabassa. Contaron con la colaboración de Ángel Amandi, de la ganadería Los Caserinos y profesor del I.E.S. de Luces, y Santiago Mato, técnico calificador.
El último día de la Escuela se celebró el Concurso de Preparadores y Manejadores, con los siguientes resultados:
Concurso de Manejadores:
Mejor Manejador Infantil: Abril Sabrià
Segundo Mejor Manejador Infantil: Alberto Ríos
Mejor Manejador Juvenil: Julia Serrabassa
Segundo Mejor Manejador Juvenil: Jon Vivanco
Mejor Manejador Júnior: Peio Lecúe
Segundo Mejor Manejador Júnior: David Pons
Resultó campeona absoluta Julia Serrabassa, seguida por Jon Vivanco, Subcampeón, y Abril Sabrià, Mención de Honor.
Concurso de Preparadores:
En el concurso de Preparadores fueron ganadores de la categoría infantil Abril Sabrià y Alberto Ríos; en la categoría juvenil, Julia Serrabassa Batalla y Jon Vivanco Hernáiz y en la categoría júnior, Peio Lecue de la Hoz y Toni Sintes Gomila.


50 Frisona Española 226 j/a
Participantes en el curso de Podología de CONAFE
Escuela de


3º Curso de Podología de CONAFE
El 3º Curso de Podología organizado por CONAFE se celebró en Navarra, los días 27 y 28 de octubre, realizándose las sesiones prácticas en las ganaderías Cooperativa San Miguel de Aralar y S.C.L. Aldapa.
Como en la primera edición, CONAFE contó con la colaboración de la Facultad de Veterinaria de la Universidad Complutense de Madrid y las empresas Anka, Seragro y Zoetis.
Participaron como ponentes en el apartado teórico los siguientes especialistas:
Eugenia Peralta, veterinaria del departamento técnico de rumiantes de Zoetis, que habló sobre la terapéutica de procesos podales de etiología infecciosa.
Javier Blanco, Jefe del Servicio de Rumiantes del Hospital Clínico Veterinario de la Universidad Complutense de Madrid, colaboró un año más en esta iniciativa de CONAFE, dando en esta ocasión un nuevo enfoque al protocolo de diagnóstico, centrándose en las cojeras altas.
Marc Delacroix, doctor veterinario del equipo de formación de recortadores del Centro de Formación Profesional y de promoción Agrícola de Rennes-le Rheu (Francia), habló de la etiología y los tratamientos de las patología podales.
Antoni Dalmau, investigador del IRTA especialista en bienestar animal, que habló sobre los indicadores del bienestar de la vaca y el comportamiento de esta, revisando aspectos como la alimentación, el sistema inmunitario, la condición corporal y el estrés.
Almudena Molinero, experta en salud podal, basó su intervención en la recogida y uso de los datos en la granja a la hora de realizar una sesión podal y la interpretación y uso de la aplicación ISAP.
Marc Pineda, especialista en salud podal, explicó las condiciones ideales que debería tener las instalaciones ganaderas (tipo de cama, suelos, sistemas de ventilación, diseño de cornadizas…) para simular las condiciones de hábito naturales y maximizar así la producción y el bienestar animal.
Noureddine Charfeddine, del departamento técnico de CONAFE y director del curso de podología, habló, entre otros temas, de las nuevas patologías introducidas en la valoración: las pezuñas en tirabuzón y la lesión de talón.

Otras Actividades Internas
CONAFE también está presente en todas aquellas actividades propias del desarrollo del Libro Genealógico. También interviene en foros cuyo objeto es el desarrollo, promoción e intereses de la ganadería de leche. En 2017 CONAFE ha formado parte del Comité Técnico de FEAGAS, la Mesa de Acuerdos, en la que participan los programas de testaje y CONAFE y el Foro de Control Lechero de CONAFE.
En el apartado práctico se contó con la colaboración de los podólogos franceses Lucie Galopin y Gilles Thomas. El Teso (Cáceres) Frisona Española Noviembre/Diciembre 2017

j/a 226 Frisona Española 51
La Laguna (Cáceres) Frisona Española Noviembre/Diciembre 2017
Resumen de la Memoria 2017
Externas
La presencia de CONAFE en el extranjero también es importante. Durante el año 2017, CONAFE ha formado parte de los siguientes Comités y Subcomités; en los que han intervenido el personal de CONAFE especializado en cada tema:
• Comité Permanente de Secretarios Ejecutivos de la EHRC. Miembro del Comité Ejecutivo de Asociaciones Europeas (Varsovia, Polonia).
• Subcomité de Calificación y Juzgamiento de la EHRC. Miembro del Comité Ejecutivo.
• Comité Europeo de Jueces. Miembro del Comité Ejecutivo.
• Comité Mundial de Calificadores. Miembro del Comité Ejecutivo.
• Reuniones anuales de ICAR e Interbull.
• Reuniones de la cooperativa de EuroGenomics: Management Board y General Assembly (varias reuniones en Holanda).






-PresidenteAFCA (Cantabria)
Germán de la Vega Delgado
- Vicepresidente -
ASCOLAF (Principado de Asturias)
José Emilio García Suarez
-Secretario -
FEFRIGA (Galicia).
José Carlos Vega Rodríguez
-Tesorero -
FEFRICALE (Castilla y León).
José Antonio Hernández Martín
-Interventor -
AFB (Islas Baleares).
Jaime Olascoaga Enseñat
• Asistencia a la Conferencia y Asamblea General de la EHRC (Budapest, Hungría).
Socios de CONAFE y representación en votos
A 31 de Diciembre de 2017 permanecían 5.794 ganaderías dadas de Alta en el L.G. Esta cifra representa 292 ganaderías menos que en el año anterior. En cuanto a reproductoras, hay un decremento de 953 animales. De acuerdo con los Estatutos vigentes de la Confederación, la distribución de votos de las Asociaciones/Federaciones que constituyen CONAFE son los que aparecen en el Cuadro 14.
Junta De Gobierno
Tras las elecciones celebradas en Asamblea General Extraordinaria, el 28 de mayo de 2015, la Junta de Gobierno es la compuesta por las Asociaciones/Federaciones, con sus respectivos representantes, que aparecen a continuación.

- Vocales -







AFA (Andalucía).
Antonio García Ruiz
AFNA (Navarra).
Beni Irurita Loyarte
AFRIARA (Aragón).
Carlos Manuel Sánchez García
AFRICAMA (Castilla-La Mancha).
José Francisco García Rojas
AFRIDEMA (Cdad. de Madrid).
Miguel González de Parla
EFRIFE (País Vasco).
Valentín Novales Elejalde
FEFRIC (Cataluña).
Josep Rebes González-Nandín
Directora Gerente: Sofía Alday Martínez de Cestafe

Asociación Autonómica Ganaderías Reproductoras Media Repro./gan. Votos 2017 2016 2017 2016 Repro. Asoc. Ganaderías Total AFA - Andalucía 161 161 26.175 25.311 163 11 5 2 18 AFB - Baleares 147 159 9.718 10.717 66 4 5 2 11 AFCA - Cantabria 759 781 45.853 46.860 60 19 5 4 28 AFEX - Extremadura 2 3 229 220 115 1 5 1 7 AFNA - Comunidad Foral de Navarra 110 121 17.626 17.994 160 8 5 2 15 AFRIARA - Aragón 12 15 7.206 6.948 601 3 5 1 9 AFRICAMA - Castilla-La Mancha 80 83 13.490 13.461 169 6 5 1 12 AFRIDEMA - Comunidad de Madrid 21 23 4.500 4.320 214 2 5 1 8 AFRIVAL - Comunidad Valenciana 3 3 1.979 1.958 660 1 5 1 7 ASCOLAF - Principado de Asturias 877 920 49.394 51.059 56 20 5 4 29 EFRIFE - País Vasco 249 257 18.962 19.392 76 8 5 2 15 FEFRIC - Cataluña 274 285 49.359 49.697 180 20 5 2 27 FEFRICALE - Castilla y León 307 322 45.074 43.289 147 19 5 3 27 FEFRIGA - Galicia 2.693 2.834 188.883 188.048 70 76 5 4 85 C.I.A. y varios 99 119 717 844 7 - - -TOTAL CONAFE 5.794 6.086 479.165 480.118 83 198 70 30 298
52 Frisona Española 226 j/a
Cuadro 13. Socios de CONAFE y representación en votos


Pruebas CONAFE/MACE Toros mejoradores
El Catálogo Internacional de Sementales se ha elaborado utilizando las pruebas oficiales de CONAFE Junio’18 y las pruebas MACE Agosto’18 de producción, tipo, recuento de células somáticas, longevidad funcional, días abiertos y facilidad de parto, que son oficiales en España para los toros sin prueba en nuestro país para estos caracteres.
También se han incorporado los toros genómicos con una prueba oficial en las evaluaciones genómicas mensuales que transcurren desde la última evaluación semestral nacional hasta la fecha de la publicación de las pruebas MACE.
INTERBULL calcula y distribuye las pruebas MACE para estimar cómo pueden compararse los toros de otros países sin prueba española con los toros que sí tienen prueba en España.
Las listas de mejores toros se establecen según el ICO –el índice de mérito genético global oficial en CONAFE– y según requisitos de fiabilidad.
En la columna de Tipo de Prueba, se indica con una “M” cuando es una prueba MACE, "I" =

sólo indirecta, “G” = se ha utilizado su genotipo en el cálculo de la prueba y "F" = prueba faltante. En longevidad, las pruebas de los toros sin prueba nacional se calculan combinando las pruebas MACE de longevidad y las pruebas MACE de miembros y aplomos, profundidad de ubre y RCS. A continuación aparecen los primeros 200 toros mejoradores por ICO del listado internacional de sementales. Para elaborar este listado se han exigido los siguientes requisitos:
1. Estar en el percentil 90 por ICO en la última evaluación nacional realizada por CONAFE.
2. Fiabilidad igual o superior al 80% en producción y tipo.
3. En tipo, el requisito de la fiabilidad se aplica sobre la fiabilidad máxima en alguno de los países participantes en las evaluaciones MACE. Los toros registrados en CONAFE y comercializados en España aparecen con el símbolo ® junto al nombre.
Toros MEJORADORES ordenados por ICO. Pruebas CONAFE junio 2018 + MACE agosto 2018
Orden POM Nombre Registrado Año Nacimiento
Producción Tipo RCS Longev. D.A. FPD ICO
Tipo Prueba Fiabilidad Hijas Kg. Leche Kg. Grasa %. Proteína Kg. Proteína Tipo Prueba Fiabilidad Hijas IPP ICU IGT Fiabilidad RCS Tipo Prueba Fiabilidad Longevidad Tipo Prueba Fiabilidad Días Abiertos Fiabilidad Facilidad P.D. Valor
1 USA S-S-I SNOWMAN MAYFLOWER ET ® 11 M 96 4356 2512 56 0,02 83 M 98 1158 1,03 0,39 1,31 96 109 M 85 126 M 89 112 71106 4774 99 G 2 USA GLEN-D-HAVEN ALTAHOTROD ® 13 M 95 340 1702 70 0,06 62 M 97 211 1,85 2,75 2,59 94 108 M 58 117 M 80 112 58 106 4573 99 G 3 USA UECKER SUPERSIRE JOSUPER ET ® 13 M 96 3022 2467 88 -0,02 77 M 98 1099 0,11 1,06 0,93 97 107 M 81 120 M 90 98 85106 4484 99 G 4 CAN FARNEAR ALTABINGO-ET 13 M 87 182 1332 36 0,12 56 M 90 133 2,05 2,63 2,90 83 112 M 48 129 M 63 109 69 101 4443 99 5 USA MR MOGUL DELTA 1427 ET 13 M 88 2002 1579 90 0,04 55 M 94 886 1,76 2,48 2,43 85 101 M 67 128 M 76 109 70115 4433 99 6 USA LAMBRECHT SHAW AICON ET ® 13 M 92 98 2358 54 -0,01 75 M 89 32 1,72 1,64 2,18 89 96 N 42 109 M 75 101 79108 4416 99 G 7 USA MR COIN DRACO 15006 ET ® 13 M 95 407 1619 52 0,05 58 M 97 274 -0,11 2,38 1,65 94 114 M 65 132 M 82 111 81107 4392 99 G 8 USA DE-SU ALTALEAF ET 13 M 86 783 2004 81 -0,02 62 M 89 188 0,58 1,61 1,75 82 109 M 44 119 M 71 112 6697 4381 99 9 USA VIEW HOME DAY MISSOURI ET ® 13 M 96 552 1823 44 -0,02 56 M 98 532 1,19 1,81 1,34 96 120 M 73 122 M 87 108 71106 4378 99 G 10 NLD COGENT SUPERSHOT ® 13 M 96 1452 1867 43 0,03 64 M 98 984 0,39 1,38 0,86 96 118 M 80 123 M 89 111 73108 4357 99 G 11 USA CO-OP DAY TUPPERNUFF ET 12 M 89 996 2145 61 -0,02 66 M 91 189 -0,17 1,83 1,66 86 117 M 70 119 M 75 99 6896 4356 99 12 CAN SNOWBIZ LEEROY ET ® 13 M 94 144 1530 50 -0,01 48 M 90 39 1,08 2,88 1,86 91 112 N 42 125 M 77 113 8199 4349 99 G 13 USA WEBB-VUE SPARK 2060 ET ® 13 M 95 643 2210 53 -0,06 64 M 95 132 0,05 1,61 1,32 93 122 M 61 124 M 86 89 80111 4336 99 G 14 USA WINNING-WAY MADEA ET ® 12 M 85 634 2045 61 -0,14 49 M 83 80 1,22 1,13 1,14 81 116 M 63 124 M 69 114 65110 4320 99 15 USA S-S-I MOGUL REFLECTOR ET 12 M 89 2903 1433 43 0,16 63 M 94 676 1,34 1,55 1,93 89 111 M 72 129 M 79 110 72104 4308 99 16 DEU MEY Maibach 13 M 94 361 1834 45 0,02 61 M 95 149 0,56 2,18 1,54 95 116 M 72 115 M 86 105 77107 4280 99 G 17 USA DE-SU ALTAGILCREST ET ® 11 M 96 1087 2249 59 -0,06 65 M 96 195 0,38 1,94 1,07 95 101 M 81 115 M 89 102 56120 4272 99 G 18 USA MR SHOT DOZER 1491 ET ® 13 M 95 416 1125 35 0,03 40 M 97 192 1,44 2,07 1,34 94 128 N 44 136 M 83 114 82108 4260 99 G 19 CAN BRYCEHOLME BRODIE ET ® 13 M 95 215 2376 52 -0,06 69 M 96 164 1,14 0,96 1,28 93 96 N 44 115 M 79 103 83110 4232 99 G 20 USA MR EVERGREENVIEW ALTADAY ET ® 13 M 93 190 3284 87 -0,15 86 M 92 60 -0,90 0,58 1,06 90 104 N 42 98 M 80 81 79100 4216 99 G 21 USA S-S-I SNOWMAN POLICE-ET 11 M 86 972 2041 64 0,02 67 M 86 122 1,39 0,97 1,13 83 108 M 68 118 M 74 96 66105 4216 99 22 USA COYNE-FARMS BRONCO YENNY-ET 11 M 82 179 2006 59 -0,04 59 M 81 63 -0,24 1,06 0,55 77 125 M 63 124 M 62 101 65110 4212 99 23 USA MR MOGUL DENVER 1426 ET ® 13 M 95 503 1946 96 0,05 68 M 97 240 1,03 2,05 1,99 94 94 M 65 113 M 85 97 6398 4204 99 G 24 USA DE-SU 11106 JETSOM-ET 11 M 81 143 1735 57 -0,03 52 M 83 77 0,84 1,20 1,24 76 127 M 63 127 M 62 100 64110 4204 99 25 USA BACON-HILL MONTROSS ET ® 12 M 96 5644 2240 68 0,00 72 M 98 1884 0,82 1,55 1,83 96 92 M 83 112 M 90 99 85112 4196 99 G 26 USA MYR-MATT MOGUL PLATINUM 13 M 94 1481 1396 79 0,08 54 M 95 142 1,36 1,93 2,09 93 111 M 72 122 M 88 109 78106 4195 99 G 27 USA S-S-I SUPERSIRE MODESTO ET ® 13 M 94 735 1675 55 0,12 67 M 94 121 0,95 1,43 1,23 93 106 M 68 120 M 86 105 80106 4186 99 G 28 USA CO-OP DAY TWINKIE-ET 12 M 94 850 1874 60 -0,07 52 M 93 73 -0,24 1,96 1,32 93 113 M 77 124 M 87 109 79103 4184 99 G 29 USA UECKER LARGE JOCLAY ET ® 12 M 87 350 1719 62 -0,05 49 M 93 242 1,32 2,70 2,61 87 105 M 55 120 M 57 101 7189 4183 99 30 USA CO-OP UPD GREATEST LIFELONG 12 M 86 1257 1936 67 -0,06 55 M 84 95 0,99 0,82 1,06 83 117 M 66 128 M 74 98 67104 4178 99 31 ESP PETO A.S. MELVIN ET ® 13 N 96 146 1992 29 -0,13 49 N 97 153 1,05 2,36 2,24 94 115 N 56 119 N 74 96 88102 4176 99 G 32 USA SEAGULL-BAY SARGEANT ET ® 10 M 96 1534 2324 47 -0,11 62 M 98 906 0,45 1,19 1,01 96 107 M 84 116 M 91 101 66116 4168 99 G 33 NLD FORCE ® 12 M 94 4907 1599 32 0,08 60 M 97 1671 0,25 1,62 0,96 96 119 M 81 125 M 89 105 78107 4168 99 G 34 USA SEAGULL-BAY SILVER ET ® 13 N 97 190 1267 82 0,09 51 M 99 2007 2,27 2,66 2,62 95 102 M 84 122 N 74 101 82110 4168 99 G 35 USA KELLERCREST MIXER LASER-ET 12 M 86 830 1930 72 0,09 72 M 79 49 0,38 1,25 0,86 83 109 M 60 108 M 72 105 65100 4162 99 36 USA DE-SU 11620 NIRVANA ET ® 12 M 96 1088 1469 66 0,14 63 M 97 314 1,48 1,72 1,91 96 108 M 79 122 M 89 98 85105 4156 99 G 37 CAN SNOWBIZ CHANNEL 13 M 84 152 1786 66 -0,01 56 M 91 174 0,66 2,32 2,32 76 104 M 42 123 M 56 97 61103 4155 99 38 USA S-S-I SUPERSIRE TETRIS-ET 12 M 84 220 1920 80 0,01 63 M 80 61 -0,05 0,63 0,51 80 114 M 55 122 M 61 108 66104 4146 99 39 USA MR MCCUT DANTE 1407-ET 13 M 83 172 1902 77 0,11 73 G 83 0,49 1,86 1,63 78 101 F 100 M 59 108 69104 4141 99 40 USA CHARTROISE SMURF ® 11 N 99 944 1854 45 -0,02 58 N 99 717 1,97 1,56 1,86 99 111 N 70 121 N 84 88 87102 4139 99 G
Genética
TPG
Percentil
54 Frisona Española 226 j/a
Toros MEJORADORES
+
agosto
j/a 226 Frisona Española 55 Orden POM Nombre Registrado Año Nacimiento Producción Tipo RCS Longev. D.A. FPD ICO TPG Tipo Prueba Fiabilidad Hijas Kg. Leche Kg. Grasa %. Proteína Kg. Proteína Tipo Prueba Fiabilidad Hijas IPP ICU IGT Fiabilidad RCS Tipo Prueba Fiabilidad Longevidad Tipo Prueba Fiabilidad Días Abiertos Fiabilidad Facilidad P.D. Valor Percentil 41 USA OCD MCCUTCHEN DRESSER ET 12 M 88 463 1414 41 0,00 45 M 93 278 1,05 2,26 2,33 84 116 M 61 124 M 70 112 70 103 4136 99 42 USA VIEW-HOME DADDY MEXICO ET ® 13 M 93 137 1951 63 -0,02 61 M 91 28 0,58 1,71 1,52 89 104 M 60 119 M 77 98 77 105 4121 99 G 43 CAN SILVERRIDGE V ALL FOR IT ET ® 13 M 85 112 1015 54 0,17 50 M 87 91 1,21 2,71 2,45 77 120 M 40 126 M 40 100 67 90 4117 99 44 DEU Mattis 13 M 93 105 1371 70 0,28 75 M 95 214 0,41 1,68 0,99 94 104 M 69 114 M 84 107 76 105 4108 99 G 45 CAN SPEEK-NJ WALTER CRONKITE-ET 13 M 82 100 1864 60 0,02 62 M 87 87 0,28 1,13 1,03 74 113 M 46 118 M 56 105 58 109 4108 99 46 USA LADYS-MANOR OCTOBERFEST ET ® 13 M 95 315 1584 68 -0,02 49 M 95 124 0,81 1,02 1,40 92 118 M 61 124 M 81 115 80 96 4104 99 G 47 USA BOMAZ MR MAX ET 13 M 93 159 1683 32 -0,11 42 M 96 288 2,29 2,11 1,77 94 109 M 71 124 M 85 100 79 119 4101 99 G 48 CAN SNOWBIZ LITTLETON ETM ® 13 M 96 1135 2335 65 -0,12 61 M 98 617 0,01 1,12 1,36 96 108 M 69 115 M 88 99 75 89 4100 99 G 49 BEL WILLEM S HOEVE UNIVERSE ® 11 M 94 158 1730 41 -0,13 41 M 95 110 2,08 1,65 1,99 93 113 M 67 119 M 84 110 73 106 4093 99 G 50 DEU BIG POINT ® 12 M 96 6851 1555 22 0,11 62 M 98 3619 1,00 1,64 1,08 97 109 M 83 123 M 91 102 84 102 4087 99 G 51 USA ZIMMERVIEW MOGUL BUTLER-ET 12 M 86 884 1460 51 0,07 54 M 87 136 1,89 1,37 1,57 83 98 M 66 126 M 73 113 67 119 4082 99 52 USA SPRUCE-HAVEN STOIC ET ® 12 M 95 3079 1540 38 0,10 61 M 97 287 0,50 1,84 1,54 93 112 M 82 122 M 89 101 81 102 4081 99 G 53 DEU MOCON ET 13 M 93 145 1489 59 0,09 58 M 95 140 0,22 0,92 0,27 93 115 M 68 130 M 81 109 75 110 4074 99 G 54 DEU MEY Merimo 13 M 91 47 1896 25 -0,08 52 M 87 23 1,12 1,70 1,32 87 111 M 63 120 M 74 100 68 109 4069 99 G 55 USA CO-OP BOOKEM YOWZA ET ® 11 M 88 875 1033 62 0,17 51 M 95 611 0,88 2,12 1,41 92 121 M 68 126 M 75 105 72 102 4066 99 56 DEU Moll 12 M 93 154 1335 32 0,04 47 M 95 153 2,45 2,01 2,05 93 111 M 73 119 M 83 107 75 114 4063 99 G 57 CAN SNOWBIZ LIVEWIRE 13 M 89 437 1233 44 -0,03 36 M 92 224 2,06 2,55 2,46 86 122 M 49 122 M 72 104 75 88 4063 99 58 CAN DE-SU MICKELSON 11598-ET 12 M 85 199 1344 65 0,13 57 M 91 194 0,50 1,70 1,60 80 118 M 53 125 M 64 100 61 99 4061 99 59 NLD HOLBRA SANSIRE ET ® 13 M 92 291 2059 78 -0,03 63 M 96 241 1,17 1,05 0,92 94 110 N 44 114 N 64 88 78 98 4058 99 G 60 DEU KAX Murano 12 M 93 155 1752 89 0,09 67 M 93 88 1,02 1,22 1,74 92 111 M 71 109 M 81 96 71 102 4056 99 G 61 USA DE-SU MGL GREENWAY 11396 ET ® 12 N 98 194 1765 80 0,06 64 M 98 531 1,85 1,49 1,83 96 99 M 82 109 N 76 99 66 117 4055 99 G 20 USA EDG RUBICON ET ® 12 M 96 1433 1055 104 0,13 48 M 98 803 2,42 1,93 1,93 96 109 M 74 122 M 89 103 72 102 4055 99 G 63 USA DE-SU GILLESPY ET ® 07 N 99 1114 2104 56 -0,12 54 N 99 910 1,17 2,21 2,28 99 111 N 85 108 N 90 88 76 89 4051 99 G 64 USA DEBOER AMARILLO CRI-ET 13 M 80 141 1489 41 0,04 52 M 79 57 1,30 1,76 1,67 73 110 M 46 119 M 50 110 66 102 4050 99 65 USA SEAGULL-BAY SHAW ET 10 M 96 1510 2376 46 -0,11 63 M 98 577 1,13 1,26 1,32 96 97 M 85 112 M 91 93 82 104 4048 99 G 66 USA FARNEAR-BH MR MCGIRT-ET 12 M 87 751 1685 71 -0,06 47 M 87 129 1,81 1,71 2,03 83 109 M 65 116 M 72 104 70 108 4048 99 67 USA L-L-M-DAIRY ALTAPONDER ET 11 M 87 237 1609 32 -0,12 38 M 88 103 0,72 1,86 1,46 85 115 M 66 129 M 67 113 65 104 4046 99 68 USA BACON-HILL LAYNE PICARD-ET 12 M 81 195 1330 29 0,06 49 M 81 65 0,69 2,28 1,40 76 111 M 60 120 M 58 117 60 103 4043 99 69 DEU VISSTEIN HARVEY 12 M 90 52 1526 56 0,07 57 M 91 45 1,07 0,86 0,82 87 114 M 64 114 M 74 119 68 107 4042 99 G 70 USA WELCOME MOGUL HADWIN-ET 12 M 81 192 1432 50 0,03 49 M 87 126 1,11 0,90 1,77 76 110 M 60 135 M 60 111 62 117 4041 99 71 USA CO-OP PRINCENTON ET ® 13 M 94 355 2365 90 0,03 80 M 92 59 -0,30 1,43 1,50 92 108 N 43 104 M 83 74 80 109 4040 99 G 72 DEU C-HAVEN-NR KIPPER-ET 12 M 92 82 2446 59 -0,13 63 M 92 53 1,32 0,68 1,26 91 103 M 71 107 M 79 95 69 103 4033 99 G 73 USA SULLY HART MERIDIAN ET ® 10 N 99 1233 1902 32 -0,12 48 N 99 1090 0,75 3,10 2,66 99 102 N 85 116 N 92 94 92 108 4029 99 G 74 ITA FER-FARM TITANIUM MALDINI 13 M 92 29 1216 45 0,10 50 M 91 63 2,04 2,15 2,17 89 106 M 64 122 M 76 105 74 107 4024 99 G 75 USA SEAGULL-BAY DIAMOND ETS 11 M 96 2952 1445 55 0,06 53 M 98 754 1,06 1,31 1,43 96 122 M 85 123 M 91 99 82 104 4023 99 G 76 NLD COGENT DG SUPERSTYLE ® 13 M 95 486 2044 41 -0,01 65 M 97 358 0,47 0,60 1,06 96 104 M 79 121 M 77 102 80 107 4022 99 G 77 USA DE-SU ALTAJOHNSON 11 M 91 3236 1693 21 -0,11 42 M 96 1005 1,12 1,14 1,23 93 124 M 78 126 M 84 107 76 109 4022 99 78 CAN SILVERRIDGE V EXTREME ET ® 13 M 96 494 1703 58 0,04 59 M 98 503 1,11 1,56 1,36 95 96 M 69 123 M 85 101 84 104 4016 99 G 79 NLD BOUW SNOWBLAST 11 M 94 272 1575 44 -0,09 41 M 96 174 0,09 1,30 1,55 94 127 M 69 126 M 86 114 75 106 4016 99 G 80 USA BOMAZ ALTAGRAVITY ET ® 12 M 93 345 1983 53 -0,02 61 M 91 62 -0,05 1,28 0,85 91 105 M 73 119 M 82 102 77 108 4010 99 G 81 USA S-S-I BOOKEM MORGAN ET 11 M 96 3219 1367 55 0,04 48 M 98 673 0,08 1,72 1,13 96 117 M 85 128 M 91 110 84 103 4009 99 G 82 USA DE-SU ROOKIE 11057 ET ® 11 M 93 187 1115 78 0,09 46 M 94 114 0,89 1,61 1,57 90 120 M 75 127 M 81 109 79 111 4005 99 G 83 DEU GOAWAY 13 M 94 1545 1726 36 -0,16 37 M 97 971 2,13 1,98 2,01 96 116 M 75 115 M 89 104 78 115 4004 99 G 84 DEU SHARAN 13 M 92 71 2079 62 -0,07 59 M 95 169 0,07 1,62 1,54 91 102 M 64 117 M 79 97 69 103 4002 99 G 85 ESP VVH ARMONICO ® 11 N 98 299 1350 58 0,21 67 N 98 261 0,53 2,45 1,93 97 107 N 64 113 N 83 94 72 99 3996 99 G 86 USA WOODCREST MOGUL YODER ET 13 M 87 3254 1175 93 0,11 49 M 93 778 1,77 1,93 1,83 84 94 M 65 126 M 77 111 69 119 3996 99 87 USA MR DELICIOUS LIONEL ET ® 13 M 96 667 1796 70 -0,01 57 M 98 558 1,07 1,40 1,59 96 98 M 73 115 M 87 107 66 101 3990 99 G 88 DEU BOOM 12 M 94 744 1481 59 0,07 55 M 96 479 0,27 1,64 1,43 96 114 M 79 116 M 88 111 78 115 3990 99 G 89 USA MR DONALYNN MILLENNIUM ET ® 13 M 96 537 1658 42 -0,10 42 M 98 519 1,65 2,98 3,07 96 100 M 72 116 M 86 100 73 92 3989 99 G 90 USA COYNE-FARMS JACEY CRI ET ® 11 N 99 400 1287 6 0,07 49 N 99 346 0,69 1,70 1,30 98 122 N 68 123 N 78 113 81 94 3989 99 G 91 CAN GILLETTE JUSTWAY ETM ® 12 M 89 1042 1807 66 -0,01 57 M 90 174 0,32 0,67 0,47 88 112 M 70 128 M 74 98 68 94 3987 99 92 CAN ELI023 MASTERFUL ET ® 13 M 96 724 1380 65 0,10 55 M 98 567 1,46 1,92 1,96 96 104 M 79 117 M 86 104 85 114 3987 99 G 93 CAN EDG Ruby Mascalese 8148 13 M 83 99 1702 67 0,12 68 M 88 98 0,72 1,08 0,98 73 106 M 44 108 G 70 106 65 100 3986 99 94 USA SEAGULL-BAY PLATINUM ETS 11 M 96 2132 1479 56 0,07 56 M 98 1163 0,96 1,09 1,26 97 124 M 86 119 M 92 98 86 104 3986 99 G 95 CAN S-S-I PLATINUM MALLARD-ET 13 M 84 134 1513 46 0,02 50 M 90 146 0,62 1,58 1,35 75 120 M 44 121 M 56 103 57 104 3982 99 96 DEU HEIDENSKIPSTER MARKUS 12 M 92 73 1351 64 0,07 51 M 93 74 2,39 1,45 1,54 89 108 M 66 117 M 76 104 75 118 3982 99 G 97 CAN GIL-GAR SHAN MEAD-ET 13 M 84 134 1736 50 -0,04 51 M 90 146 0,80 2,25 2,14 75 104 M 43 116 M 56 101 57 108 3981 99 98 DEU WEH Swing 13 M 92 86 2222 48 -0,11 59 M 94 96 1,68 0,54 1,23 90 103 M 66 114 M 78 95 69 104 3973 99 G 99 CAN GILLETTE MR JOHNSON ETM ® 11 M 94 150 1657 30 -0,06 47 M 96 140 1,54 1,89 2,14 91 110 M 73 112 M 84 109 79 106 3972 99 G 100 USA MR OCD EPIC DRAGONHEART ET ® 12 M 96 544 1741 45 -0,13 41 M 96 211 0,61 2,26 1,97 93 99 M 77 126 M 88 109 81 113 3972 99 G 101 USA RI-VAL-RE RAGER RED ET ® 13 M 95 531 1201 62 0,04 43 M 95 120 1,22 2,04 2,19 92 111 M 61 124 M 83 111 79 107 3971 99 G 102 USA OCD MCCUTCHEN DURANGO ET ® 12 M 96 459 1243 29 0,09 50 M 96 139 0,88 2,52 2,63 96 115 M 75 123 M 86 98 64 98 3968 99 G 103 ESP RI OPSAL NISSAN ET ® 11 N 97 129 1663 53 0,00 54 N 97 119 1,25 2,36 1,98 95 104 N 58 108 N 81 100 68 105 3957 99 G 104 USA MYSTIQUE ALSACE 13 M 87 318 1213 46 0,15 55 M 90 144 1,23 2,02 1,91 82 112 M 45 115 M 66 106 68 96 3955 99 105 USA HAMMER-CREEK O-ST O-YEAH-ET 11 M 81 173 2039 33 -0,08 56 M 83 79 0,75 0,90 1,19 76 106 M 61 114 M 59 108 61 105 3954 99 106 USA LARCREST COMMANDER ET ® 12 N 97 197 1219 66 0,13 53 M 99 2071 1,73 2,07 2,79 95 109 M 83 120 N 74 95 75 106 3952 99 G 107 USA S-S-I TWIST MOMENTUM-ET 11 M 82 168 1589 46 0,01 52 M 79 49 0,08 0,78 0,06 78 107 M 64 127 M 62 120 63 95 3949 99 108 USA SANDY-VALLEY DIVO ® 13 M 83 137 1439 5 -0,05 40 M 91 181 0,98 2,87 2,58 82 100 M 52 128 M 52 108 71 106 3948 99 109 USA SULLY HARTFORD SWMN MYTH ET ® 11 M 96 2669 2179 26 -0,09 59 M 98 1134 0,92 1,60 1,82 97 92 M 85 113 M 92 100 67 106 3944 99 G 110 CAN SEAGULL-BAY ROWDY-ET 12 M 86 310 1350 44 -0,01 42 M 90 138 2,13 2,36 2,37 82 105 M 59 122 M 71 100 70 115 3943 99 111 USA RICKLAND SUPERSIRE KELBY-ET 13 M 80 153 1989 63 -0,02 61 M 84 90 0,25 1,69 1,60 74 117 F 100 M 56 95 64 98 3941 99 112 USA SANDY-VALLEY TOPLINE-ET 13 M 84 237 1569 52 -0,07 42 M 81 68 1,11 2,46 1,82 79 105 M 41 116 M 60 107 64 112 3937 99 113 CAN WOODCREST NAUGHTY BY DAY-ET 13 M 84 154 1517 45 0,03 52 M 90 148 -0,07 1,86 1,08 77 114 M 48 120 M 59 106 57 106 3933 99 114 USA S-S-I SHAMROCK MYSTIC-ET 11 M 86 236 980 53 0,06 38 M 82 63 -0,31 1,34 0,58 83 117 M 72 134 M 72 135 68 96 3931 99 115 ESP MCBANDO BANDIDO ET ® 13 N 94 68 1493 42 -0,09 38 N 93 48 1,02 2,97 3,04 89 109 N 56 118 N 73 102 57 100 3930 99 G 116 USA LANGS-TWIN-B WILD BEAST ET 12 M 95 241 1031 35 0,01 34 M 96 154 1,21 1,96 1,93 93 124 M 72 127 M 81 115 78 97 3926 99 G 117 CAN COMESTAR LAUSMART ETM ® 11 M 96 2331 2208 43 -0,09 60 M 98 1310 1,13 0,33 0,96 97 103 M 87 116 M 92 98 84 107 3925 99 G 118 ESP ALH CARMEN MIXER ® 12 N 94 69 1256 37 -0,05 35 N 92 39 1,11 1,76 1,21 90 118 N 60 127 N 74 115 60 105 3921 99 G 119 USA NO-FLA ALTAEDITION-ET 12 M 85 521 1309 63 0,15 58 M 84 107 -0,11 0,84 0,03 80 107 M 64 126 M 66 119 63 114 3919 99 120 USA SANDY-VALLEY SALOON ET ® 11 N 99 453 1778 64 0,07 65 N 99 385 0,03 2,29 2,29 98 92 N 72 108 N 80 102 77 100 3917 99 G
ordenados por ICO. Pruebas CONAFE junio 2018
MACE
2018
Toros MEJORADORES ordenados por ICO. Pruebas CONAFE junio 2018 + MACE agosto 2018
56 Frisona Española 226 j/a
Orden POM Nombre Registrado Año Nacimiento Producción Tipo RCS Longev. D.A. FPD ICO TPG Tipo Prueba Fiabilidad Hijas Kg. Leche Kg. Grasa %. Proteína Kg. Proteína Tipo Prueba Fiabilidad Hijas IPP ICU IGT Fiabilidad RCS Tipo Prueba Fiabilidad Longevidad Tipo Prueba Fiabilidad Días Abiertos Fiabilidad Facilidad P.D. Valor Percentil 121 NLD WESTENRADE ALTASPRING ® 13 M 96 1633 1113 75 0,14 51 M 98 979 1,56 2,48 2,35 96 96 M 80 118 M 90 107 66 105 3915 99 G 122 USA OPSAL NIAGRA FANG-ET 10 M 86 1402 1949 61 0,02 65 M 88 144 -0,33 0,64 0,46 83 117 M 73 115 M 76 95 66 106 3914 99 123 USA BUTZ-BUTLER SHOTGLASS ET 11 M 96 2396 1706 58 -0,10 44 M 98 1134 1,32 1,52 1,40 97 119 M 85 116 M 92 96 85 107 3913 99 G 124 USA DE-SU 11404 TOTTER-ET 12 M 80 148 1653 47 -0,11 40 M 79 54 0,88 1,55 1,23 75 110 M 58 123 M 57 110 62 113 3913 99 125 NLD FLEVO GENETICS SNOWMAN 05 M 98 2403 1873 52 -0,05 55 M 99 1465 1,42 1,14 1,81 99 108 M 93 117 M 97 91 95 104 3912 99 G 126 USA PINE-TREE ALTABARK-ET ® 13 M 83 79 2184 69 0,01 71 G 78 -0,10 0,83 0,70 77 99 F 100 M 51 107 67 97 3909 99 127 CAN STANTONS CAPITAL GAIN ET ® 13 M 96 522 1736 67 -0,09 46 M 98 581 0,71 2,10 2,28 94 109 M 74 116 M 85 97 81 101 3909 99 G 128 USA GLENN-ANN PROVIDENCE-ET 12 M 80 147 1308 44 -0,12 29 M 89 130 0,68 2,80 2,63 79 114 M 54 126 M 50 110 70 104 3900 99 129 USA CLEAR-ECHO LEXOR RACER ET 12 M 96 3341 795 21 0,14 40 M 98 1744 0,81 2,53 1,47 97 118 M 83 124 M 91 120 84 121 3900 99 G 130 ITA ALL MEI.ROYAL CHAVEZ ® 11 M 80 371 2038 60 -0,16 46 M 92 303 1,44 2,11 2,42 88 108 M 58 110 M 67 86 65 106 3899 99 131 CAN BOLDI AIRLIFT 12 M 84 140 1334 56 0,11 55 M 90 143 0,61 2,38 2,01 77 101 M 48 112 M 59 110 61 103 3899 99 132 USA QUIET-BROOK-D LASSO-ET 11 M 81 167 1598 45 0,01 52 M 79 52 1,09 1,47 1,48 76 110 M 62 118 M 60 100 62 90 3898 99 133 USA MISTY SPRINGS AMAK 11 M 81 170 1241 69 0,15 56 M 86 114 1,33 1,13 1,36 76 117 M 62 121 M 60 96 62 98 3894 99 134 USA TRIPLECROWN SS DESIRED-ET 13 M 83 201 1950 85 0,03 66 M 83 81 -0,56 1,01 0,92 77 102 M 42 116 M 57 97 66 105 3888 99 135 USA DE-SU ALTAMELHOR ET 10 M 91 1636 819 62 0,17 44 M 95 601 1,71 1,43 1,76 93 120 M 79 122 M 84 115 75 106 3887 99 136 USA S-S-I SNOWMAN MCGYVER-ET 11 M 87 1527 1559 67 -0,01 49 M 86 107 0,29 1,74 0,69 84 102 M 74 125 M 76 104 68 108 3884 99 137 CAN LOOKOUT PESCE PONDE KUDO 12 M 82 82 1515 34 0,07 56 M 86 78 1,43 1,40 0,96 72 108 M 43 108 M 53 110 55 107 3882 99 138 USA NO-FLA ALTAENTRY-ET 13 M 85 634 1459 43 0,03 50 M 84 115 0,01 1,27 0,20 81 104 M 44 124 M 68 121 65 116 3882 99 139 USA SANDY-VALLEY CASPIAN-ET 12 M 86 497 1798 48 0,16 75 M 90 162 -0,47 0,66 0,74 82 108 M 67 113 M 68 99 71 105 3881 99 140 USA CO-OP MOGUL LAWMAN ET ® 12 M 96 2740 946 59 0,24 56 M 98 647 2,04 1,95 1,94 97 104 M 81 117 M 90 103 85 111 3878 99 G 141 USA DE-SU ALTALAKER-ET 11 M 87 601 1292 35 0,01 42 M 91 194 0,81 1,83 1,04 84 109 M 72 129 M 74 109 66 113 3876 99 142 DEU MAR FERGUS ET ® 13 M 94 1218 1831 57 -0,02 57 M 97 1001 0,71 1,03 1,25 96 109 M 75 115 M 88 97 77 114 3875 99 G 143 USA SEAGULL-BAY ALLSTAR ET ® 12 M 94 288 1465 65 -0,04 43 M 95 129 1,77 2,54 2,33 92 98 M 73 119 M 84 96 82 105 3874 99 G 144 USA MR CHASSITY COLOSS ET ® 10 M 88 454 1641 41 -0,06 46 M 93 241 0,59 2,12 1,99 85 119 M 73 115 M 76 94 69 112 3873 99 145 USA NO-FLA EMULATE 30309-ET 11 M 86 675 1523 74 0,02 51 M 88 154 0,57 1,09 0,98 83 106 M 72 123 M 74 107 71 107 3871 99 146 USA DE-SU 11236 BALISTO ET ® 12 M 96 8120 824 81 0,41 69 M 99 4616 0,98 1,04 1,65 98 115 M 87 122 M 93 96 90 114 3871 99 G 147 NLD DG. INSEME MAZZARRI ET ® 13 M 92 492 1469 43 -0,05 42 M 97 373 -0,39 2,64 1,91 95 109 N 44 116 N 69 116 77 101 3871 99 G 148 CAN SANDY-VALLEY MR MIAMI-ET 11 M 85 147 1368 66 0,11 56 M 89 132 1,22 0,92 1,20 81 102 M 60 122 M 68 108 59 104 3868 99 149 USA LADYS-MANOR DOORSOPEN ET ® 13 M 95 147 860 50 0,08 36 M 96 132 1,22 2,19 2,45 92 127 M 61 129 M 77 101 82 90 3866 99 G 150 DEU DE RITH PUNTO 11 M 92 79 1634 47 -0,05 47 M 93 68 1,46 0,93 1,15 91 122 M 72 115 M 80 99 68 106 3863 99 G 151 USA KP-ACK ALTALEGAL-ET 12 M 88 456 1528 80 0,07 56 M 87 98 1,25 1,30 1,42 84 108 M 50 114 M 71 96 70 110 3862 99 152 USA UNITED-PRIDE OBSV UNIQUE-ET 11 M 89 4162 1391 34 -0,13 30 M 87 109 1,37 1,97 1,62 85 123 M 74 116 M 77 114 69 108 3862 99 153 USA EILDON-TWEED SSR BELAIR-ET 13 M 84 423 1223 79 0,15 55 M 88 175 0,93 1,97 1,89 80 98 M 47 125 M 65 97 69 107 3860 99 154 NLD RH SUPERMAN ET ® 13 M 96 447 1676 86 0,12 68 M 98 372 0,24 0,98 0,94 94 102 M 61 113 M 80 97 82 113 3859 99 G 155 CAN DE-SU MCC JENKINS 11447-ET 12 M 85 227 1611 74 0,06 58 M 91 215 0,01 1,86 1,98 81 106 M 56 114 M 66 97 63 98 3858 99 156 USA GILLETTE JANUARY 11 M 88 382 1652 34 -0,05 47 M 93 264 1,42 1,59 1,96 84 109 M 70 114 M 73 103 69 107 3856 99 157 USA SEAGULL-BAY SUPERSIRE ET ® 10 N 99 764 1854 79 0,04 64 N 99 625 -0,29 0,61 0,56 99 110 N 68 121 N 84 91 89 107 3854 99 G 158 DNK VH STARMAN ® 12 M 94 1395 1448 15 -0,03 43 M 97 615 0,79 1,27 0,56 95 127 M 73 125 M 87 100 77 113 3852 99 G 159 USA GABRIELS GROOVIN ET ® 12 M 94 136 1243 23 -0,12 27 M 95 137 1,49 2,39 2,23 90 116 M 66 123 M 80 114 76 98 3850 99 G 160 USA ROYLANE BOOKEM BOB 5170 ET 11 M 87 791 938 70 0,30 61 M 90 249 0,80 1,81 1,75 84 102 M 73 114 M 76 114 71 109 3848 99 161 USA WELCOME JACEY DONOTI-ET 13 M 81 81 1114 64 0,15 52 G 80 0,79 2,17 1,58 74 122 F 100 M 48 112 65 106 3848 99 162 ESP TOPMAX ET ® 13 N 90 39 1372 53 0,01 45 N 81 6 0,64 2,63 1,78 85 106 N 33 117 N 50 102 60 98 3847 99 G 163 USA DE-SU DAVINCI 11288 ET 12 M 90 2889 826 72 0,20 47 M 96 1178 1,05 2,56 2,19 92 111 M 74 121 M 80 103 76 108 3845 99 164 USA MR SUNVIEW COIN SUNFISH-ET 13 M 95 117 1282 48 0,03 45 M 96 149 0,70 1,77 1,60 93 121 M 65 122 M 82 99 80 109 3843 99 G 165 NLD VEN DAIRY LESSON ET ® 13 M 92 33 1256 46 0,05 46 M 93 96 1,48 1,76 1,63 91 109 M 63 123 M 77 101 78 99 3842 99 G 166 ESP BUINER MC KAYNE ® 13 N 98 234 1562 41 -0,12 37 N 98 176 2,42 1,98 2,51 96 103 N 59 116 N 75 103 81 106 3842 99 G 167 CAN BENNER SILVA ET ® 13 M 87 321 1440 26 -0,12 33 M 93 342 0,99 2,38 1,53 84 114 M 55 123 M 70 105 48 99 3842 99 168 USA ROSYLANE-LLC ALTADEFECTOR 12 M 87 1039 1364 56 0,09 53 M 91 220 1,15 1,23 1,25 88 107 M 73 109 M 78 118 71 104 3840 99 169 CAN GERANETTE LATIMER 10 M 84 134 1863 36 -0,16 41 M 89 119 1,29 2,07 1,84 80 111 M 62 111 M 67 96 58 94 3837 99 170 USA WESSELCREST ALTAANTEUP ET ® 12 M 96 801 1531 49 -0,06 43 M 98 338 1,82 1,96 2,12 95 103 M 75 117 M 89 100 82 106 3837 99 G 171 USA WELCOME SS PETERPAN ET ® 12 M 95 1260 1922 93 0,09 72 M 97 332 -0,11 0,75 0,58 93 101 M 69 109 M 87 93 81 111 3836 99 G 172 USA FROHLAND LAUMAN 11 M 89 685 2173 43 -0,09 59 M 94 433 1,26 0,39 1,13 88 103 M 73 112 M 78 95 70 104 3836 99 173 CAN LACTOMONT LAUNCH MOGUL ET ® 12 M 94 169 898 62 0,14 44 M 96 135 0,91 2,69 2,06 91 110 M 62 119 M 82 108 81 108 3835 99 G 174 USA S-S-I PARTYROCK PROFIT ET 14 M 94 171 913 41 0,18 49 M 94 95 1,33 1,76 1,40 91 113 N 43 121 M 79 110 79 107 3832 99 G 175 USA CO-OP RENEGADE ET ® 13 M 95 815 1006 74 0,05 38 M 96 150 2,95 2,35 2,54 94 95 M 66 114 M 86 114 60 105 3832 99 G 176 USA RI-VAL-RE GRAFEETI DEGO-ET 12 M 82 213 1580 32 -0,01 49 M 79 55 0,34 1,03 0,64 76 127 M 57 118 M 59 100 63 96 3831 99 177 USA REGANCREST MASCAL 10773-ET 13 M 82 138 1646 50 -0,08 44 M 81 59 0,78 2,39 1,95 76 113 F 100 M 55 109 67 94 3831 99 178 USA MORNINGVIEW BOOKEM LUCID ET 11 M 89 781 1181 37 0,05 43 M 90 222 0,87 1,41 1,65 90 120 M 73 121 M 76 113 72 110 3831 99 179 FRA HYPNOTIC 12 M 94 749 1922 56 0,05 68 M 97 290 0,27 0,78 1,51 96 106 N 44 106 M 79 98 77 105 3828 99 G 180 NLD DELTA BOOKEM DANNO ET ® 12 M 96 11295 987 31 0,16 49 M 98 8260 2,06 1,46 1,09 97 111 M 81 119 M 92 110 65 102 3827 99 G 181 USA MATT-DARI MOGUL PAYTON ET ® 12 N 98 270 793 43 0,18 44 N 98 166 0,67 2,40 1,81 96 115 N 60 124 N 75 111 67 113 3827 99 G 182 DFS VH Tirsvad Massey Milkman 13 M 92 111 1356 54 0,21 67 M 94 73 0,24 1,03 0,58 90 116 N 43 113 M 79 98 77 101 3826 99 G 183 USA EDG GANGSTER ET ® 13 M 92 124 1976 64 -0,14 47 M 93 82 0,39 1,08 0,52 88 115 M 63 119 M 77 91 76 104 3824 99 G 184 ESP SAN-RIAN NORMAN MERIDIAN ® 13 N 93 55 2056 51 -0,13 51 N 93 43 1,52 1,64 2,19 89 100 N 58 108 N 73 91 58 113 3823 99 G 185 USA CO-OP UPD HUNTER SALVINO 12 M 89 2230 1372 91 0,20 66 M 93 261 0,56 1,81 1,71 86 96 M 73 100 M 78 111 73 113 3821 99 186 USA DE-SU DORCY MOONBOY 954 ET 10 M 96 1600 735 11 0,07 31 M 97 388 1,51 3,08 2,30 96 118 M 85 122 M 91 114 82 101 3821 99 G 187 NLD NEWHOUSE ETHAN 11 M 92 146 1680 45 0,02 56 M 94 78 0,51 1,27 1,15 90 115 M 64 106 M 83 104 71 101 3816 99 G 188 USA B-HIDDENHILLS BENZO 1523-ET 11 M 81 155 1511 29 -0,09 38 M 84 89 0,54 1,69 1,55 76 126 M 62 118 M 59 104 61 109 3816 99 189 CAN TRUSTMORE ACCELERATOR ET ® 12 M 86 256 1204 49 0,04 43 M 92 250 1,65 2,45 2,19 82 109 M 58 116 M 69 99 65 111 3816 99 190 USA DE-SU 926 TICTOC-ET 10 M 81 116 1571 47 -0,02 48 M 81 59 0,44 1,66 1,33 76 116 M 62 116 M 60 99 66 94 3815 99 191 USA DE-SU SHAM MANDAN 1336-ET 11 M 83 182 1629 43 -0,06 45 M 87 108 0,71 1,91 1,51 78 107 M 66 121 M 65 97 65 100 3815 99 192 CAN COMESTAR LAUTRUST ® 12 M 94 165 1105 69 0,15 52 M 96 151 1,56 1,67 1,78 91 109 M 71 114 M 83 104 79 102 3815 99 G 193 NLD CHAMPION ALTABOOKEL ® 12 N 99 362 1445 62 0,10 58 N 98 275 1,50 1,15 1,46 98 97 N 58 118 N 78 101 69 97 3814 99 G 194 USA MR MOGUL DION 15008-ET 13 M 86 704 1043 76 0,21 55 M 88 168 1,13 2,08 1,88 83 114 F 100 M 71 111 68 116 3812 99 195 DEU CNN ALTAECHELON 12 M 91 1899 1422 52 0,01 46 M 93 331 0,88 1,61 1,77 92 110 M 74 115 M 81 109 71 108 3808 99 196 NLD JHS PARADISE ET ® 11 M 95 1022 1477 41 -0,11 36 M 98 738 2,00 1,12 1,32 96 113 M 69 120 M 87 109 58 105 3805 99 G 197 USA DEN-K ALTAGREATEST ® 09 M 96 2864 1792 47 0,00 58 M 98 1029 0,28 1,28 0,70 97 94 M 85 122 M 91 99 73 107 3803 99 G 198 USA SHEEKNOLL ALTAVITTEK 09 M 90 1826 1236 27 -0,05 34 M 93 302 0,53 1,15 0,84 89 128 M 76 128 M 79 114 68 118 3803 99 199 USA DE-SU HONEYBEE 11569 ET ® 12 M 96 1778 1327 55 0,06 49 M 98 469 0,02 1,99 1,31 96 111 M 77 121 M 88 102 73 116 3802 99 G 200 CAN MR OCD SNOWMAN DOWNTOWN-ET 11 M 83 100 2034 56 -0,02 63 M 87 89 0,53 0,95 1,36 77 103 M 54 111 M 61 89 59 102 3801 99
Pruebas CONAFE/MACE Toros con baja fiabilidad y percentil 99

El segundo listado del Catálogo Internacional de Sementales recoge la relación de toros con baja fiabilidad dentro del percentil 99 por ICO y que cumplen los siguientes requisitos:
1. Estar dentro del percentil 99 de la última evaluación nacional realizada por CONAFE, es decir, su ICO es igual o superior al del mejor 1% de los toros probados en España.
2. Fiabilidad inferior al 80% en producción o tipo.

países participantes en las evaluaciones MACE.
El resto de toros del catálogo internaciona, tanto del listado de mejoradores como del listado de baja fiabilidad, se puede consultar en la página web de CONAFE www.conafe.com.
Los toros registrados en CONAFE y comercializados en España aparecen con el símbolo ® junto al nombre.
3. En tipo, el requisito de la fiabilidad se aplica sobre la fiabilidad máxima en alguno de los
Toros BAJA FIABILIDAD ordenados por ICO. Pruebas CONAFE junio 2018 + MACE agosto 2018
j/a 226 Frisona Española 57 1 ESP PENTAGON K&L POKEMON CLUN ® 16 N 70 1257 34 0,13 55 N 70 1,75 2,55 1,66 67 140 N 46 147 N 62 113 47115 4939 99 G 2 DEU Gywer RDC 17 N 70 2008 68 0,06 72 N 70 1,65 1,81 1,98 67 114 N 44 131 N 62 113 47 114 4908 99 G 3 NLD DG COL SPARKLE 17 N 70 1692 57 0,10 66 N 69 2,26 1,94 1,81 67 118 N 45 134 N 62 118 47109 4907 99 G 4 DEU WEH WEH Outlook 17 N 70 2277 75 -0,05 67 N 70 1,24 2,25 2,13 67 121 N 44 126 N 61 102 47 95 4879 99 G 5 DEU HaS HaS Starello 17 N 70 1554 58 0,03 53 N 69 2,45 2,28 1,70 67 116 N 43 142 N 61 122 47112 4878 99 G 6 ESP VEKIS RISK ® 17 N 70 2041 79 -0,02 63 N 70 1,11 1,84 1,41 67 115 N 45 133 N 62 120 47108 4862 99 G 7 DEU Sigma 17 N 70 1860 54 0,02 62 N 70 0,83 2,60 2,18 67 127 N 45 134 N 62 109 47105 4861 99 G 8 ESP K&L JS DONSIMON ® 16 N 70 1976 69 0,06 71 N 70 1,41 1,37 1,29 67 134 N 46 135 N 62 96 48110 4855 99 G 9 ESP MEADOWHOLSTEINS K&L RM FLORIN ® 17 N 70 1964 56 -0,02 61 N 70 0,99 2,12 1,95 67 130 N 45 135 N 62 107 47106 4845 99 G 10 USA FUSTEAD SPERHERO LAVONTE-ET 17 N 70 1295 85 0,13 56 N 70 1,50 2,53 1,67 67 123 N 45 141 N 62 119 47100 4828 99 G 11 USA BLUMENFELD ZEBRA-ET 17 G 72 2137 62 -0,01 68 G 78 0,95 2,08 2,07 76 113 G 56 127 G 62 116 53109 4822 99 12 CAN WESTCOAST SEASONAL 17 G 67 2320 64 0,00 75 G 72 1,83 1,46 1,82 66 108 G 51 124 G 57 108 50107 4812 99 13 NLD R DG NEUTRON ET 17 G 78 1916 62 0,10 73 G 78 1,07 2,19 1,76 75 116 G 59 121 G 70 117 48109 4804 99 14 CAN SILVERRIDGE V TIMBERLAKE 17 G 67 1913 66 0,06 69 G 72 0,90 2,40 2,05 66 108 G 50 132 G 57 114 49111 4800 99 15 ESP SALVAT RED ET ® 17 N 70 1967 48 0,01 64 N 69 1,46 1,45 1,55 67 125 N 45 133 N 62 114 47109 4800 99 G 16 CAN PROGENESIS METROPOLIS 17 G 65 2164 77 0,02 72 G 70 0,81 1,72 1,57 65 112 G 49 124 G 57 115 48106 4772 99 17 ESP IDA JEFE ET ® 17 N 70 2181 60 -0,06 63 N 70 0,96 2,34 1,90 67 116 N 45 133 N 62 101 47104 4764 99 G 18 ESP EXTEN ET ® 17 N 70 1918 51 0,05 67 N 70 0,96 2,21 1,53 67 121 N 45 129 N 61 109 47112 4761 99 G 19 ESP TIRSVAD MISSION PRINCI P RED ® 17 N 70 2069 69 -0,01 65 N 70 0,46 2,17 1,48 67 125 N 46 133 N 62 100 47103 4758 99 G 20 USA S-S-I PR CHARLEY DEREK-ET 17 G 67 1426 67 0,10 57 G 72 1,39 2,23 1,78 66 125 G 51 136 G 57 120 49110 4756 99 21 CAN PROGENESIS PATTY CHARLY1429 17 G 71 1907 55 0,04 66 G 77 1,79 2,07 2,51 75 111 G 55 127 G 62 115 54103 4753 99 22 ESP SHARAD ® 17 N 70 2228 40 -0,06 65 N 70 1,13 2,49 2,23 67 122 N 45 122 N 62 102 47105 4751 99 G 23 ESP CAMPA SUPERMARIO ® 17 N 70 1884 42 -0,08 51 N 70 1,29 2,56 1,94 67 130 N 44 131 N 62 111 5198 4747 99 G 24 DEU WKM Suprem 17 N 70 2150 90 0,04 74 N 70 0,47 1,97 1,67 67 111 N 45 122 N 62 110 4799 4734 99 G 25 ESP ISOLDE GIGANTE ET ® 17 N 70 2070 66 -0,05 61 N 70 1,19 2,57 2,30 67 119 N 44 127 N 62 102 47107 4734 99 G 26 CAN STE ODILE MILKTIME 16 G 68 2423 79 0,03 82 G 75 0,54 1,29 1,24 66 117 G 52 119 G 57 99 53103 4727 99 27 ESP GINGER ET ® 17 N 70 1824 67 0,00 59 N 70 1,78 2,29 2,33 67 120 N 44 132 N 61 104 4798 4725 99 G 28 CAN PROGENESIS BUDGET 17 G 67 1935 78 0,00 62 G 72 0,81 2,37 2,50 66 128 G 51 129 G 57 99 4997 4724 99 29 NLD DG HS NOEL ET ® 16 N 70 1410 49 0,10 57 N 70 1,91 2,14 1,84 67 123 N 45 138 N 62 116 47105 4724 99 G 30 USA OCD CHARLEY RANGER-ET 16 G 72 1523 57 0,05 55 G 77 1,49 2,15 1,58 74 124 G 54 136 G 64 119 48113 4723 99 31 NLD HEIDENSKIPSTER SALVADOR 17 N 70 1476 92 0,06 54 N 70 1,77 2,13 1,93 67 121 N 46 137 N 62 115 47112 4722 99 G 32 USA WOODCREST GRADUAL-ET 16 G 68 1755 63 0,08 66 G 73 1,59 1,85 1,97 66 117 G 52 127 G 58 115 50107 4705 99 33 ESP SALVAME ® 17 N 70 1498 52 0,01 49 N 70 2,61 2,71 2,50 67 120 N 45 134 N 62 111 46106 4700 99 G 34 DEU WEH Charking 17 N 70 1442 81 0,07 54 N 70 0,94 1,89 1,61 67 130 N 45 143 N 62 113 4797 4698 99 G 35 ESP DG BI-BATTLE ® 16 N 71 1678 80 0,08 63 N 70 1,11 2,08 1,28 68 123 N 47 136 N 62 102 44121 4692 99 G 36 ESP SECURITY ALH STALONE ET ® 17 N 70 1274 61 0,15 57 N 69 2,33 1,61 1,14 67 121 N 44 140 N 61 120 47114 4690 99 G 37 NLD NL715952043 ET 17 G 77 1930 64 0,00 62 G 77 1,85 2,10 1,95 75 116 G 57 126 G 69 107 49114 4687 99 38 DEU RZH DECLIC ET ® 16 N 72 1453 32 0,00 47 N 72 1,14 2,16 1,74 70 128 N 44 139 N 63 129 52107 4680 99 G 39 DEU RR Sting-Red 17 N 70 1838 57 -0,04 55 N 69 1,70 1,91 1,79 66 127 N 42 140 N 60 97 4698 4679 99 G 40 ESP FIONA G VERSACE RED ET ® 17 N 70 2147 62 -0,03 66 N 69 1,85 1,53 1,43 66 119 N 44 130 N 61 94 46105 4668 99 G Orden POM Nombre Registrado Año Nacimiento Producción Tipo RCS Longev. D.A. FPD ICO TPG Tipo Prueba Fiabilidad Hijas Kg. Leche Kg. Grasa %. Proteína Kg. Proteína Tipo Prueba Fiabilidad Hijas IPP ICU IGT Fiabilidad RCS Tipo Prueba Fiabilidad Longevidad Tipo Prueba Fiabilidad Días Abiertos Fiabilidad Facilidad P.D. Valor Percentil
Toros
58 Frisona Española 226 j/a Orden POM Nombre Registrado Año Nacimiento Producción Tipo RCS Longev. D.A. FPD ICO TPG Tipo Prueba Fiabilidad Hijas Kg. Leche Kg. Grasa %. Proteína Kg. Proteína Tipo Prueba Fiabilidad Hijas IPP ICU IGT Fiabilidad RCS Tipo Prueba Fiabilidad Longevidad Tipo Prueba Fiabilidad Días Abiertos Fiabilidad Facilidad P.D. Valor Percentil 41 DNK VH Kingman Keet 17 N 70 1676 75 -0,02 52 N 69 1,76 2,42 2,09 67 118 N 46 130 N 61 115 48 112 4668 99 G 42 NLD VEENHUIZER K L JT JAKE ET ® 16 N 70 1190 45 0,19 59 N 70 1,54 2,62 2,53 67 128 N 46 141 N 62 104 48 108 4667 99 G 43 ESP ANDERSTRUP SUPERHERO HIGHWAY ® 17 N 70 1638 63 0,08 62 N 70 1,05 1,49 1,94 67 124 N 46 133 N 62 119 48 103 4664 99 G 44 USA SIEMERS CHARLEY MERRYGUY-ET 16 G 66 2021 78 0,01 66 G 71 0,93 1,85 1,82 66 115 G 51 127 G 57 108 48 108 4663 99 45 ESP ZANDENBURG EVAN MELLOR ® 15 N 73 2502 46 -0,17 60 N 72 0,61 1,24 1,06 70 126 N 48 128 N 64 105 51 110 4656 99 G 46 DEU GGA GGAKennedy 17 N 70 1475 73 0,15 64 N 70 1,48 2,13 2,38 67 121 N 46 135 N 62 104 49 103 4652 99 G 47 FRA MELPHY ® 16 N 70 1443 68 0,19 67 N 70 1,62 1,41 1,58 67 136 N 46 134 N 62 99 47 107 4649 99 G 48 CAN PROGENESIS PADAWAN ET ® 16 G 74 1426 41 0,13 60 G 79 1,71 2,06 1,79 75 114 G 57 128 G 62 131 56 104 4649 99 49 ESP JASMIN WHISKY ET ® 17 N 70 1588 80 0,09 61 N 70 0,47 1,97 1,61 67 123 N 46 133 N 62 117 47 113 4648 99 G 50 DEU COL Finality 16 N 70 741 48 0,20 45 N 70 1,82 2,40 1,48 67 135 N 46 149 N 62 121 47 115 4643 99 G 51 FRA LAGER TUAL ® 15 N 73 1742 36 0,06 63 N 72 0,74 2,37 1,88 70 114 N 50 128 N 65 120 51 110 4634 99 G 52 USA MATCREST CHARLEY CHAPLIN-ET 17 G 69 1871 66 0,02 63 G 73 0,63 1,76 1,51 66 120 G 51 127 G 57 117 49 102 4633 99 53 ESP KL KYO ET ® 17 N 70 1892 69 0,00 61 N 70 0,90 2,72 2,24 67 117 N 45 120 N 61 110 48 103 4629 99 G 54 NLD DG OH DJANGO ET 17 G 75 1656 78 0,08 62 G 77 1,27 1,63 1,42 75 117 G 58 131 G 68 117 53 105 4628 99 55 FRA NUCLEUS 17 N 71 1660 49 0,08 63 N 70 0,77 1,94 1,92 68 109 N 47 137 N 62 121 43 111 4626 99 G 56 DEU NH Solito Re 17 N 70 1315 53 0,03 46 N 69 2,02 2,76 2,29 67 118 N 44 140 N 61 115 47 110 4622 99 G 57 NLD DELTA FIRESTONE 17 N 70 1736 77 0,17 75 N 70 1,39 1,08 0,75 67 121 N 46 131 N 62 100 47 105 4620 99 G 58 DEU KAX Wonderful 17 N 70 1673 88 0,14 70 N 70 1,39 2,13 2,00 67 119 N 45 122 N 61 102 47 105 4618 99 G 59 NLD JAMESON ET ® 16 N 70 1254 66 0,18 60 N 70 1,39 2,64 2,21 67 123 N 46 139 N 62 101 48 113 4618 99 G 60 DEU DE0359925805 17 N 70 1433 73 0,09 56 N 70 1,38 2,67 2,32 67 125 N 44 126 N 61 112 48 101 4614 99 G 61 DEU HaS HaS Garido 17 N 70 1585 74 0,08 60 N 69 1,77 1,93 2,00 67 118 N 43 130 N 61 111 48 103 4612 99 G 20 ESP TIRSVAD SNIPER GIGASTAR ® 17 N 70 1625 53 0,01 54 N 70 1,50 2,58 2,29 67 113 N 46 130 N 61 118 48 114 4612 99 G 63 ESP TIRAN MISSION HUNTER CICLO P ® 17 N 70 1796 81 0,04 62 N 70 1,41 2,11 1,67 67 119 N 46 126 N 62 104 47 109 4611 99 G 64 CAN PROGENESIS PASSPORT 16 G 67 1778 50 0,04 62 G 71 1,04 1,90 1,86 66 119 G 50 125 G 58 119 50 100 4610 99 65 ESP LIEU THOMAIN BALTAZAR ET ® 17 N 70 1386 85 0,08 54 N 70 1,47 1,93 1,28 67 128 N 45 134 N 62 113 47 112 4610 99 G 66 CAN STE ODILE EXPANSION 17 G 67 1692 67 0,16 73 G 72 0,46 1,29 1,20 66 125 G 50 126 G 57 114 47 105 4607 99 67 ESP MYSELF JEREZ ET ® 17 N 70 1618 45 0,09 62 N 70 1,05 2,54 2,45 67 121 N 45 134 N 61 101 47 99 4607 99 G 68 DEU WIL HOTSPOT ET ® 17 N 70 1308 91 0,29 74 N 70 1,21 2,28 2,07 67 104 N 44 126 N 62 118 47 110 4605 99 G 69 ESP BANANA JOE ET ® 17 N 70 1489 67 0,11 60 N 70 0,99 1,83 1,47 67 126 N 46 132 N 62 115 47 106 4602 99 G 70 ITA GO-FARM MONSTER ET TV TL TY 17 G 65 1438 64 0,05 52 G 70 1,97 2,78 2,54 66 121 G 49 130 G 57 108 47 108 4600 99 71 ESP DROUNER DH DG MANO ® 16 N 73 1948 51 0,02 65 N 72 0,88 1,76 1,64 70 118 N 49 126 N 64 111 51 104 4595 99 G 72 CAN PROGENESIS PARKAVENUE 17 G 66 1650 52 0,01 54 G 71 1,06 2,20 2,19 66 121 G 50 131 G 57 118 46 102 4595 99 73 CAN PROGENESIS BENETTON 16 G 68 1618 47 0,03 55 G 73 1,19 2,41 1,81 66 116 G 51 133 G 57 116 50 104 4594 99 74 ESP NEMO G SANTI ET ® 17 N 70 1940 75 0,04 67 N 70 1,46 1,88 1,83 67 118 N 45 123 N 61 99 47 115 4589 99 G 75 FRA CAPJ NOOB 17 N 70 1435 51 0,00 46 N 70 0,94 2,61 2,21 67 116 N 45 137 N 61 128 47 99 4586 99 G 76 DEU WIL 43419 17 N 70 1152 59 0,16 54 N 70 1,53 2,66 2,27 67 129 N 45 128 N 62 117 47 109 4585 99 G 77 DNK Sting Red 17 N 70 1645 41 0,02 55 N 69 0,88 1,90 1,45 67 116 N 44 135 N 61 125 47 111 4584 99 G 78 ESP GEFRI GAVILAN ET ® 17 N 70 2052 71 0,07 74 N 70 0,63 1,45 1,48 67 110 N 44 120 N 61 114 47 102 4583 99 G 79 NLD DELTA FEDOR 17 N 70 1889 47 0,09 71 N 70 1,06 1,69 1,48 67 117 N 45 125 N 62 106 48 104 4582 99 G 80 USA PEAK HATTIE JEDI 60878-ET 17 G 68 2170 61 0,04 74 G 73 1,36 2,27 2,28 66 100 G 52 118 G 58 101 50 107 4581 99 81 USA S-S-I BG SUPERHRO DELUXE-ET 17 G 69 1427 62 0,11 58 G 72 0,96 1,79 1,43 66 126 G 51 136 G 57 115 48 105 4581 99 82 FRA NARKOI 17 N 72 1753 66 0,00 56 N 72 1,26 2,34 1,70 69 121 N 44 134 N 64 99 51 114 4578 99 G 83 CAN PROGENESIS BUCHANAN 16 G 67 1656 49 0,06 60 G 72 1,05 2,29 1,93 66 111 G 51 131 G 57 117 50 105 4577 99 84 DEU Kelvin 17 N 70 2127 80 -0,06 61 N 70 0,75 2,57 2,48 67 106 N 46 123 N 61 106 48 95 4576 99 G 85 DNK TIR-AN ECONOMY ET ® 16 N 70 1566 57 0,09 60 N 70 1,42 1,95 1,98 67 119 N 46 130 N 62 114 51 109 4576 99 G 86 DNK VH Anderstrup Sniper Snake 17 N 70 1264 61 0,07 48 N 70 1,36 2,55 2,28 67 133 N 46 134 N 61 112 48 108 4574 99 G 87 USA SANDY-VALLEY BRAVENESS ET ® 16 N 70 1612 71 0,13 66 N 70 0,69 1,64 1,49 67 118 N 45 134 N 62 111 48 102 4573 99 G 88 ESP K&L KG SUPERMAN KUGAN ® 16 N 70 1840 71 0,05 65 N 70 1,08 1,41 1,29 67 107 N 46 127 N 62 123 48 101 4571 99 G 89 DEU DE770601887 17 N 70 1477 79 0,14 63 N 70 1,95 2,78 2,48 68 106 N 46 124 N 61 109 43 106 4571 99 G 90 DEU DE0360175040 17 N 70 1299 62 0,11 54 N 70 1,69 2,21 2,17 68 118 N 47 135 N 62 118 43 110 4571 99 G 91 ESP ARION ® 15 N 73 1743 41 -0,03 53 N 72 1,28 1,93 1,49 70 114 N 49 134 N 64 121 56 113 4570 99 G 92 DEU DE0360385506 ET 17 G 77 1544 68 0,08 59 G 78 0,04 2,43 1,52 75 124 G 60 126 G 70 120 47 103 4561 99 93 DEU RR Baltic 16 N 71 955 67 0,29 61 N 70 1,34 2,47 1,51 68 124 N 47 139 N 62 108 44 105 4561 99 G 94 USA MR FRAZZLED ARISTOCRAT ET 17 G 77 1479 78 0,13 62 G 78 0,68 2,75 2,02 75 122 G 60 124 G 70 108 47 104 4557 99 95 ESP BACARDI ET ® 16 N 70 1586 41 0,08 60 N 70 1,51 2,02 2,04 67 116 N 46 133 N 62 111 48 107 4554 99 G 96 CAN PROGENESIS PIRATE 16 G 67 1966 58 0,05 69 G 72 1,11 1,56 1,64 66 111 G 51 125 G 57 109 49 105 4553 99 97 CAN PINE-TREE-I PURSUIT 17 G 67 1408 70 0,10 56 G 72 1,52 1,90 2,05 66 119 G 51 133 G 57 117 49 107 4553 99 98 DEU Hotstar 16 N 70 1553 55 0,00 50 N 70 1,12 2,39 1,62 67 118 N 39 130 N 59 123 50 107 4553 99 G 99 ESP BLANCO V. SSTAR LISBON ET ® 17 N 66 1722 68 -0,08 47 N 66 -0,09 2,72 2,30 63 133 N 42 127 N 57 115 43 99 4552 99 G 100 NLD DOWNTOWN ET ® 16 N 72 1787 75 0,06 64 N 72 0,63 1,76 2,09 69 124 N 44 130 N 63 102 53 97 4550 99 G 101 CAN PROGENESIS HEMINGWAY 17 G 64 1776 79 0,02 60 G 69 0,77 2,14 2,35 65 115 G 48 125 G 56 114 46 108 4548 99 102 CAN PROGENESIS HALLMARK 17 G 67 1555 62 0,07 58 G 72 1,08 2,38 2,01 66 112 G 50 129 G 58 118 50 106 4545 99 103 DEU RUH Sullivan 17 N 70 1521 64 0,04 54 N 70 0,36 1,68 1,10 67 122 N 45 144 N 62 116 47 108 4545 99 G 104 USA MR SPRING NOBLE-ET 16 G 72 1366 68 0,05 50 G 75 0,90 2,59 2,31 68 119 G 53 134 G 61 120 50 106 4544 99 105 DEU FINALIST ET ® 17 N 70 1543 46 0,05 55 N 70 1,61 1,37 1,46 67 129 N 46 136 N 62 111 47 109 4542 99 G 106 DEU Adlon P 17 N 70 1017 69 0,25 59 N 70 1,74 2,22 2,37 67 121 N 44 132 N 62 118 47 103 4542 99 G 107 DEU HOLDEUM000359235191 17 N 70 1588 88 0,11 63 N 70 0,68 2,20 2,14 67 114 N 46 128 N 62 112 49 102 4541 99 G 108 NLD DELTA AMAZER 17 N 70 1980 88 0,11 77 N 70 1,48 1,23 1,60 67 109 N 45 120 N 61 101 47 103 4540 99 G 109 ESP ACAJOU GH KENDO ET ® 17 N 70 1358 71 0,16 61 N 70 1,42 2,53 2,41 67 115 N 46 128 N 62 111 49 101 4539 99 G 110 CAN PROGENESIS OUTRAGEOUS 17 G 66 1757 82 0,16 75 G 72 0,59 2,28 1,98 66 103 G 51 122 G 57 108 48 106 4537 99 111 CAN PROGENESIS PROSPEROUS 17 G 72 1489 71 0,11 60 G 79 0,53 1,87 1,85 75 130 G 57 131 G 62 110 55 103 4536 99 112 USA DE-SU JEDI 14233-ET 17 G 69 1955 75 -0,02 61 G 72 0,68 2,09 1,94 66 108 G 50 126 G 58 113 49 104 4535 99 113 NLD NL663498659 17 N 70 1586 90 0,13 66 N 70 1,23 1,68 1,50 67 116 N 46 128 N 61 108 47 109 4535 99 G 114 CAN PROGENESIS FABULOUS 16 G 67 1795 66 0,00 58 G 72 1,82 2,14 2,36 66 111 G 51 126 G 58 108 50 105 4535 99 115 DEU Jagger 17 N 70 1548 44 0,09 60 N 70 1,05 2,48 2,39 67 121 N 45 134 N 61 101 47 99 4535 99 G 116 DEU KHE KHE Suleus 17 N 70 1292 74 0,15 58 N 69 2,42 1,67 1,92 67 114 N 44 130 N 61 119 47 98 4535 99 G 117 DNK Match P 17 N 70 1670 70 0,05 60 N 70 1,15 1,84 1,45 67 113 N 45 129 N 61 116 47 105 4532 99 G 118 ESP MOLENKAMP 6591 KARTEL ® 17 N 70 1847 70 -0,06 53 N 70 1,38 2,40 2,16 67 122 N 46 127 N 62 100 48 108 4532 99 G 119 ESP K&L BC SNAKE II BATERY ® 16 N 71 1583 65 -0,04 47 N 70 1,07 1,83 1,60 68 135 N 48 137 N 62 107 44 107 4532 99 G 120 USA MR SPRING NOBLE 3-ETN 17 G 70 1358 73 0,07 51 G 75 0,87 2,58 2,29 68 119 G 53 132 G 61 120 51 107 4532 99
BAJA FIABILIDAD ordenados por ICO. Pruebas CONAFE junio 2018 + MACE agosto 2018
Toros BAJA FIABILIDAD ordenados por ICO Pruebas CONAFE junio 2018 + MACE agosto 2018 j/a 226 Frisona Española 59 O r d e n P O M Nombre R e g i s t r a d o A ñ o N a c i m i e n t o Producción T ipo RCS Longev D A FPD ICO T P G T i p o P r u e b a F i a b i l i d a d H i j a s K g . L e c h e K g G r a s a % . P r o t e í n a K g . P r o t e í n a T i p o P r u e b a F i a b i l i d a d H i j a s I P P I C U I G T F i a b i l i d a d R C S T i p o P r u e b a F i a b i l i d a d L o n g e v i d a d T i p o P r u e b a F i a b i l i d a d D í a s A b i e r t o s F i a b i l i d a d F a c i l i d a d P D V a l o r P e r c e n t i l 121 USA MR SPRING NOBLE 2-ETN 17 G 70 1358 73 0,07 51 G 75 0,87 2,58 2,29 68 119 G 53 132 G 61 120 51 107 4532 99 122 NLD DELTA FITNESS 17 N 70 1311 56 0 21 65 N 70 1 85 1 63 1 58 67 123 N 45 132 N 62 107 48 109 4530 99 G 123 CAN SWISSBEC TURBOJET 17 G 65 1285 58 0 14 57 G 70 1 42 2 38 2 16 65 122 G 49 129 G 56 115 46 100 4530 99 124 DEU Slate RF 17 N 70 1271 55 0,10 52 N 69 1,44 1,93 1,45 66 120 N 44 135 N 61 125 46 115 4530 99 G 125 DEU Super Uno 17 N 70 1641 85 0,01 54 N 70 0,97 1,76 1,58 67 115 N 45 132 N 62 120 47 104 4528 99 G 126 DEU DE01082601383 ET 17 N 70 1614 71 0,06 59 N 69 1,29 2,40 2,19 67 108 N 44 123 N 61 120 47 110 4527 99 G 127 ESP BAIXO SUPERSYL ® 17 N 70 1267 29 0,11 53 N 70 1,32 2,47 1,62 67 131 N 46 134 N 62 110 51 105 4525 99 G 128 CAN STE ODILE INITIATIVE 17 G 67 1947 71 0,05 69 G 72 0,90 1,77 1,72 66 107 G 50 127 G 57 105 49 110 4524 99 129 FRA NEWSTAR 17 N 70 1251 58 0,11 52 N 70 1,30 3,20 3,37 67 123 N 44 135 N 61 101 48 101 4524 99 G 130 CAN PROGENESIS MAURICE 17 G 66 1511 64 0,07 57 G 71 1,07 2,04 1,75 66 113 G 50 132 G 57 120 49 108 4523 99 131 USA MR MONSTER ET ® 16 G 71 2155 68 0,05 75 G 74 0,90 1,39 1,55 66 110 G 52 115 G 58 108 53 97 4522 99 132 ESP WIFI ET ® 17 N 70 1314 49 0,19 63 N 70 0,55 2,62 2,15 67 122 N 45 128 N 62 113 47 104 4518 99 G 133 ESP SJONNY SUPERTORO ® 15 N 73 1729 37 -0 03 52 N 72 1 22 2 50 1 90 70 128 N 50 128 N 65 103 75 92 4518 99 G 134 DEU DKR DG BONNE 16 N 70 1333 71 0 09 53 N 70 0 79 2 26 1 39 67 119 N 38 135 N 59 120 49 104 4518 99 G 135 USA MELARRY JEDI WIRED-ET 16 G 74 1887 50 0 05 67 G 78 1 42 2 16 1 94 76 108 G 56 124 G 62 103 53 106 4517 99 136 USA DE-SU 13759 POTOSI-ET 16 G 69 1480 51 0 06 54 G 71 1 19 2 23 1 58 66 122 G 51 129 G 57 117 49 106 4517 99 137 USA AURORA SUPERTRAMP-ET 16 N 66 1478 74 0 12 61 N 66 0 28 1 91 1 54 63 121 N 41 134 N 57 114 43 103 4516 99 G 138 ESP CASQUETTA MILLAR ET ® 17 N 70 1266 100 0,19 62 N 69 1,40 2,57 2,35 67 121 N 44 126 N 61 102 47 101 4516 99 G 139 DNK Puma5 17 N 70 1418 56 0 13 60 N 70 0 86 2 11 1 59 67 123 N 44 141 N 62 100 47 118 4516 99 G 140 CAN WESTCOAST SALUKI 17 G 66 1855 69 -0 01 59 G 71 0 78 1 74 2 00 66 120 G 50 129 G 57 108 48 105 4515 99 141 CAN PROGENESIS MARIUS ET ® 16 G 67 1789 86 0,14 74 G 71 0,78 1,31 1,21 66 110 G 50 123 G 58 112 50 110 4514 99 142 CAN PROGENESIS TRIVAGO ET ® 16 G 67 2318 64 -0,06 68 G 72 1,52 1,72 1,87 66 107 G 51 116 G 58 100 50 106 4510 99 143 DNK Estador 16 N 66 1404 72 0,17 64 N 66 0,91 1,94 1,85 63 122 N 42 133 N 57 105 43 100 4508 99 G 144 DEU SHV Euclan 17 N 70 1563 65 0,08 59 N 70 1,31 2,12 2,32 67 112 N 46 130 N 61 113 47 111 4507 99 G 145 USA MR JEDI MARLOWE-ET 16 G 66 1950 64 0 05 69 G 71 1 23 1 48 1 88 66 114 G 50 121 G 58 106 49 102 4503 99 146 ESP DE VRENDT ARNO 10 ® 16 N 70 1805 56 0 07 66 N 70 1 08 1 75 1 50 67 116 N 46 127 N 62 104 49 104 4499 99 G 147 DEU 17 G 66 1596 68 0 01 53 G 71 1 21 2 35 2 24 66 109 G 50 129 G 57 120 49 109 4498 99 148 DEU HaS HaS Estragon 17 N 70 1393 59 0 03 48 N 69 1 39 1 65 1 44 67 131 N 44 142 N 61 108 47 110 4498 99 G 149 CAN SILVERRIDGE V SILHOUETTE 17 G 67 1871 60 0 03 64 G 72 1 67 2 15 2 08 66 99 G 50 126 G 57 108 49 106 4497 99 150 DEU KAX Kawasaki 17 N 70 1776 60 0,01 58 N 70 1,33 1,50 1,31 67 113 N 46 130 N 61 116 47 108 4497 99 G 151 USA CO-OP JETT TANZANITE-ET 16 G 69 1651 56 0,08 62 G 71 0,76 1,93 1,28 66 116 G 50 128 G 58 114 48 108 4494 99 152 CAN PROGENESIS MAGAZINE 17 G 67 1903 77 0,01 63 G 72 1,55 1,68 1,72 65 104 G 50 124 G 57 112 49 109 4493 99 153 ESP GIN BAHIA ET ® 16 N 71 1075 64 0,11 46 N 70 1,54 2,46 1,84 68 136 N 46 140 N 62 103 43 102 4493 99 G 154 DEU DE0359236810 16 N 70 1827 43 -0,02 57 N 70 1,99 1,69 1,23 67 112 N 46 126 N 62 113 48 110 4490 99 G 155 ESP K&L BD INDIANEL ® 16 N 70 1401 36 0 03 48 N 70 1 65 2 02 1 45 67 129 N 46 132 N 62 116 48 108 4490 99 G 156 USA 78970 17 G 69 1476 53 0 02 50 G 72 0 97 2 28 1 87 65 119 G 51 134 G 55 118 47 111 4489 99 157 USA REGANCREST BLUEDEVIL-ET 17 G 66 1327 66 0 01 44 G 71 0 80 2 65 2 27 66 129 G 50 134 G 57 115 46 104 4489 99 158 NLD VEKIS DG LIGHTMAN ET 17 G 78 1388 70 0 03 48 G 79 1 09 2 64 2 05 76 121 G 61 127 G 70 120 49 108 4486 99 159 DEU SPH My Dream P 17 N 70 1485 66 0 23 73 N 70 0 22 1 92 1 15 67 113 N 46 124 N 62 117 47 105 4485 99 G 160 CAN SILVERRIDGE V PHONE 16 G 66 2148 66 0,05 75 G 72 0,58 1,94 1,83 66 106 G 50 119 G 57 98 49 104 4483 99 161 USA COOKIECUTTER LGND HUSKY-ET 17 G 69 1496 61 0,03 52 G 71 0,33 2,07 1,44 66 117 G 50 136 G 57 123 47 104 4483 99 162 USA S-S-I MONTROSS JEDI ET ® 14 M 94 64 1980 59 0,05 70 N 72 0,82 1,67 1,57 91 109 N 50 124 M 74 105 81 108 4482 99 G 163 DEU WIL 75024 KEEPER ET ® 16 N 70 1807 69 0,02 61 N 70 1,10 2,31 2,11 67 111 N 46 123 N 61 107 47 100 4482 99 G 164 ESP HLB JANKO JUDO ® 16 N 70 1451 45 0,07 55 N 70 1,60 1,67 1,15 67 132 N 46 132 N 62 106 48 112 4482 99 G 165 ESP MERITENE ® 17 N 70 1606 66 0 04 56 N 70 1 78 2 30 2 30 67 120 N 46 128 N 62 99 47 100 4481 99 G 166 CAN PROGENESIS PRESTIGE ® 16 G 68 2353 64 0 04 80 G 74 0 41 0 88 1 18 66 106 G 52 115 G 57 109 53 104 4480 99 167 USA HOLLERMANN RAGEN SUMAC-ET ® 17 G 68 2068 66 -0 05 61 G 69 0 34 1 75 1 04 66 118 G 49 126 G 58 105 46 101 4479 99 168 GBR GB560989202462 15 N 73 1946 35 -0 01 61 N 72 0 96 1 79 1 42 70 118 N 49 127 N 64 106 51 101 4479 99 G 169 NLD VEELHORST DG MADRID ET ® 17 N 70 1633 83 0 07 61 N 70 1 17 1 81 1 52 67 114 N 46 130 N 62 107 47 114 4479 99 G 170 CAN PROGENESIS HITECH 17 G 64 1519 65 0,07 57 G 69 1,12 1,83 1,66 65 118 G 48 130 G 56 116 46 112 4478 99 171 USA T-SPRUCE 832 17 G 66 1433 66 0,22 70 G 71 0,73 1,90 1,76 65 118 G 51 123 G 57 113 48 104 4475 99 172 LUX Lis Lis Senetto 17 N 70 1657 67 -0,02 51 N 70 0,91 2,60 2,22 67 116 N 46 131 N 61 108 47 103 4475 99 G 173 DEU Supercup 16 N 71 1628 74 0,16 70 N 69 0,56 1,87 1,46 67 117 N 40 133 N 60 95 50 104 4473 99 G 174 CAN PROGENESIS BERING 17 G 67 1651 70 0 04 58 G 72 0 97 2 26 2 16 66 118 G 51 128 G 57 105 48 101 4473 99 175 DEU Gazebo 17 N 71 1750 95 0 00 56 N 70 1 28 1 55 1 44 67 116 N 46 130 N 62 108 43 106 4471 99 G 176 ESP TIRAN JETSET HORIZON ® 16 N 70 1320 68 0 19 63 N 70 0 98 2 17 2 18 67 128 N 46 129 N 62 101 48 104 4471 99 G 177 DEU DE122657479 17 G 75 1436 67 0 04 51 G 77 2 37 2 08 2 24 75 114 G 58 125 G 69 118 52 110 4470 99 178 DEU Sextant 17 N 70 1715 97 0 03 59 N 70 1 99 2 06 2 04 67 110 N 45 121 N 62 105 47 107 4469 99 G 179 DNK VH Bosman Bahrain 16 N 66 1304 78 0,27 72 N 66 1,03 0,70 0,11 63 121 N 42 131 N 57 117 43 114 4468 99 G 180 ITA CALNAGO OUTLAST TOTO 17 G 59 1514 64 -0,02 47 G 66 1,29 2,30 2,15 64 117 G 45 133 G 56 116 45 96 4466 99 181 CAN WESTCOAST GRANDPRIX 17 G 65 1250 69 0,05 46 G 70 1,52 2,86 2,50 66 121 G 49 133 G 57 110 46 98 4466 99 182 DEU Lightlife 17 N 70 1304 40 -0,03 39 N 70 1,32 2,02 1,61 68 118 N 46 147 N 62 125 43 117 4466 99 G 183 DEU Poseidon 17 N 70 1550 60 0,03 53 N 70 1,38 3,07 2,83 67 110 N 44 127 N 61 107 47 100 4464 99 G 184 USA PEAK FINN-ET 15 N 73 1606 44 0 02 54 N 72 0 74 2 39 1 72 70 123 N 50 128 N 65 111 52 100 4463 99 G 185 ESP TOTALPRO ET ® 17 N 70 1409 65 0 10 56 N 70 1 87 1 94 1 61 67 108 N 46 133 N 61 116 43 120 4463 99 G 186 ESP SANDY GH BONBON ET ® 16 N 70 1312 58 0 20 64 N 70 1 18 1 54 1 48 67 126 N 46 135 N 62 104 48 106 4461 99 G 187 ESP CAMPOLONGO ST RAYNER FIV ET ® 17 N 70 1940 35 -0 05 57 N 70 1 10 2 47 2 05 67 115 N 46 121 N 61 107 52 97 4460 99 G 188 USA TTM CHARLEY SAMSON-ET 17 G 60 1321 58 0 09 52 G 68 0 83 1 96 1 35 66 123 G 45 133 G 57 122 48 111 4459 99 189 CAN PROGENESIS FIELDTRIP 17 G 66 1536 72 0,18 70 G 71 1,45 2,21 2,15 66 105 G 50 119 G 57 111 49 105 4458 99 190 USA SANDY-VALLEY GAMEPLAN-ET 17 G 66 1461 77 0,10 58 G 71 1,38 1,86 1,75 65 113 G 50 132 G 57 112 48 110 4458 99 191 CAN CLAYNOOK DISCJOCKEY 17 G 65 1033 66 0,11 45 G 71 1,55 3,63 3,09 66 115 G 50 131 G 57 114 46 97 4458 99 192 CAN PROGENESIS HAPPYDAY 17 G 66 1641 69 0,06 60 G 71 0,58 1,21 1,10 66 115 G 50 128 G 57 127 47 108 4456 99 193 USA NO-FLA DARIO HEXER-ET 16 G 69 1606 45 0,04 56 G 70 0,19 1,73 1,15 66 127 G 49 133 G 57 115 47 116 4456 99 194 FRA NURCY 17 N 66 1590 76 0 08 60 N 66 0 28 2 41 2 05 63 116 N 42 128 N 57 109 43 110 4455 99 G 195 USA S-S-I SHI SUPERFLY YETI-ET 16 G 69 1620 41 0 07 60 G 71 0 26 2 36 1 68 66 118 G 50 132 G 57 108 47 107 4455 99 196 ESP CAMPOLONGO ST RENAN FIV ET ® 17 N 70 1857 46 -0 08 51 N 70 1 06 2 52 2 10 67 119 N 46 123 N 61 109 52 102 4455 99 G 197 CAN WESTCOAST SUPERHERO GRACE 2103 17 N 70 871 76 0 20 49 N 70 1 01 2 96 2 08 67 122 N 45 137 N 62 116 47 109 4455 99 G 198 ESP SANXURXO ET ® 15 N 73 1919 58 -0 01 61 N 72 1 06 1 48 1 15 70 112 N 50 123 N 65 116 74 101 4453 99 G 199 DEU DE539675038 17 N 70 1096 64 0,21 58 N 70 1,25 2,87 2,64 67 117 N 45 125 N 62 116 47 99 4453 99 G 200 DNK 17 N 70 1745 73 0,02 58 N 69 1,86 1,49 1,25 67 113 N 44 130 N 61 105 47 120 4452 99 G
G e n é t i c a
Análisis del nivel genético de la granja
En el siguiente artículo veremos cómo podemos analizar el nivel genético de nuestra ganadería utilizando el programa CONAFEMAT junto con la infor mación que se recibe en papel de la evaluación.

Dentro de las opciones que ofrece el programa de acoplamientos CONAFEMAT se encuentra la posibilidad de analizar los animales presentes actualmente en la granja
Para ello debemos ir al apartado Selección de Vacas, pinchando en el Botón Buscar Vacas y una vez que aparezca el listado, pinchar en Marcar Todo y posterior mente en Analizar Animales Seleccionados (Figura 1)
Nos aparecerá entonces un gráfico como el de la Figura 2 donde cada barra representa el percentil en el que se encuentran los animales seleccionados para cada carácter
En este ejemplo vemos que a nivel de ICO las vacas se encuentran en el percentil 63, los caracteres en los cuales el potencial genético es más alto son Kilos y Porcentaje de Proteína, mientras que los más bajos son los marcados en Rojo entre los que se encuentran Estatura e Inserción Posterior en el percentil 21.
De esta manera, podemos ver de for ma rápida el nivel genético de nuestras vacas respecto



94 72 83 79 75 80 67 82 74 72 64 39 53 38 44 26
ICO ICOP ICOT MA IPP ICU KgL KgG KgP ppg ppp Est Pecho ProfCorp l AncGrp AngGrp ICO ICOP ICOT MA IPP ICU KgL KgG KgP ppg ppp Est Pecho ProfCorp l AncGrp AngGrp 63 52 44 61 53 69 21 38 27 35 25 34 36 37 27 46
Figura 1 Pantalla de Selección de Vacas en CONAFEMAT
ganadería
cada carácter 83 61 75 67 66 71 52 66 68 67 74 48 59 33 50 22
Figura 2 Percentiles en los que se encuentra la media de las vacas de la
para
la media de las novillas de la ganadería para cada carácter
Figura 3.
Percentiles en los que se encuentra
Percentiles
se encuentra la media de las ter neras de la ganadería para cada carácter 60 Frisona Española 226 j/a ICO ICOP ICOT MA IPP ICU KgL KgG KgP ppg ppp Est Pecho ProfCorp l AncGrp AngGrp
Figura 4
en los que
al resto de vacas registradas en CONAFE y de esta for ma, identificar posibles puntos débiles a corregir.
El mismo análisis lo podemos realizar con las novillas Para ello en la misma pantalla marcamos el rango de edad que queremos evalua Por ejemplo, entre 13 y 30 meses; pinchamos en Buscar Novillas y a continuación de nuevo en Marcar todo y Analizar animales seleccionados (Figura 3)
Lo primero que observamos es que, obviamente en un programa de selección que funciona, los animales más jóvenes tienen un mayor potencial genético que los mayores En este caso el percentil para el ICO está en el 88 y los puntos débiles lo encontramos en Profundidad corporal (33), Ángulo de Grupa (22), lo que significa tendencia hacia isquiones altos y Longitud de pezones (23) es decir tendencia a pezones cortos Debemos recordar que en los caracteres de óptimo inter medio tampoco es deseable encontrarse en los percentiles altos En este caso, Pezones Anteriores (70) también indicaría cierta tendencia hacia pezones un juntos El carácter más destacado sería Longevidad (87)
Por último podemos repetir el análisis con las ter neras escogiendo en este caso las comprendidas entre 0 y 12 meses (Figura 4). Aquí podemos comprobar cómo de nuevo el percentil de ICO sigue subiendo hasta el 94 y los puntos débiles los encontramos en Estatura (39), como ocurría con las vacas, Profundidad Corporal (38), Ángulo de Grupa (26), Longitud de Pezones (21) y Pezones Anteriores (81) en la misma dirección que las novillas y además Vista Lateral de Patas (32) con tendencia hacia patas rectas. Los caracteres más destacados serían Kilos de Grasa (82), Inserción Anterior (84) y Longevidad (89)
Además, en el apartado Análisis de la Ganadería tenemos los gráficos de evolución de índices




32 64 71 84 75 53 73 81 59 21 61 44 89 58 74
Vlp Vpp AngPod InAnt InPost Lig ProfU PezAnt PezPos LonPez Angul RCS Long DA VOR Vlp Vpp AngPod InAnt InPost Lig ProfU PezAnt PezPos LonPez Angul RCS Long DA VOR 57 38 41 26 21 30 33 49 41 38 27 41 49 58 48 53 59 67 74 59 56 73 70 62 23 52 44 87 68 63 Vlp Vpp AngPod InAnt InPost Lig ProfU PezAnt PezPos LonPez Angul RCS Long DA VOR
Análisis del nivel genético de la granja
donde podemos comparar nuestra ganadería con la autonomía por año de nacimiento (Figura 5)para los distintos caracteres.
De esta forma en pocos minutos podemos hacer un análisis sencillo, pero muy útil, del nivel genético de la ganadería que debería servir para conocer los puntos débiles a mejorar a nivel general en la granja.
Recordamos que CONAFEMAT está disponible en la intranet de CONAFE llamada SINBAD a la que tienen acceso todos los ganaderos colaboradores. Igualmente desde las CONAFE y las Asociaciones que la componen estamos a su disposición para ayudarles con cualquier duda que les pueda surgir.
Dpto. Técnico de CONAFE

Terminología
ICO Índice de Mérito Genético Total
ICOP Puntos del ICO que proceden de los caracteres de producción
ICOT Puntos del ICO que proceden del resto de caracteres
MA Miembros y Aplomos
IPP Índice de Pies y Patas
ICU Índice Compuesto de Ubre
Kl Kilos de Leche
Kg Kilos de Grasa
Kp Kilos de Proteína
ppg Porcentaje de Grasa
ppp Porcentaje de Proteína
Est Estatura
Pecho Anchura de Pecho
ProfCorp Profundidad Corporal
AncGrp Anchura de Grupa
AngGrp Ángulo de Grupa (óptimo intermedio)
Vlp Vista Lateral de Patas (óptimo intermedio)
Vpp Vista Posterior de Patas
AngPod Ángulo Podal
InAnt Inserción Anterior
InPost Inserción Posterior
Lig Ligamento
ProfU Profundidad de Ubre
PezAnt Colocación de Pezones Anteriores (óptimo intermedio)
PezPos Colocación de pezones Posteriores (óptimo intermedio)
LonPez Longitud de Pezones (óptimo intermedio)
Angul Angulosidad RCS Recuento de Células Somáticas
Long Longevidad
Mejores toros españoles polled
ICO
A continuación aparece la relación de los diez mejores toros españoles polled por ICO, correspondientes a la evaluación genómica de junio 2018. Este listado sustituye al publicado en el nº 225 (mayo/junio).
Figura 5. Evolución del nivel genético de la ganadería y de la autonomía por año de nacimiento de las hembras






DA Días Abiertos VOR Velocidad de Ordeño
ICO Autonomía Ganadería ICOP Autonomía Ganadería 3000 2006 2007 2008 2009 2010 2011 2012 2013 2014 2015 2016 2006 2007 2008 2009 2010 2011 2012 2013 2014 2015 2016 2500 2000 1500 1000 500 0 800 600 400 200 0 -200 2006 2007 2008 2009 2010 2011 2012 2013 2014 2015 2016 500 400 300 200 100 0 -100 ICOT Autonomía Ganadería IPP Autonomía Ganadería IGT Autonomía Ganadería 2006 2007 2008 2009 2010 2011 2012 2013 2014 2015 2016 2006 2007 2008 2009 2010 2011 2012 2013 2014 2015 2016 0,6 0,4 0,2 0 -0,2 1 0,5 0 -0,5 -1 ICU Autonomía Ganadería 2006 2007 2008 2009 2010 2011 2012 2013 2014 2015 2016 1,2 1 0,8 0,6 0,4 0,2 0 -0,2 -0,4 -0,6
62 Frisona Española 226 j/a
por
Nombre Número Año N. GICO Valor TIRSVAD MISSION PRINCI P RED ESPM9204595909 2017 4758 POC TIRAN MISSION HUNTER CICLO PESPM920458612120174611POC GEFRI GAVILAN ET ESPM9204577634 2017 4583 POC SINCO P RED ET ESPM920463117420174331POC GEFRI APOLO PC ET ESPM9204383819 2016 4272 POC DIABOLO P RED ET ESPM920441511820164206POC GEFRI DG CARLYN PC ESPM9204466329 2017 4128 POC GEFRI IMAGINE PC ESPM920446633020174118POC BEEZE LAZAROXY JULE P ROJO ESPM9204521344 2016 3866 POC DESIRE ARIZONA POLLED RED ETESPM920434213520153849POC POS Homocigoto Polled / POC Portador Polled
Valoración
genómica: Evaluaciones de las mejores novillas genómicas con edad inferior a 18 meses
Evaluaciones genómicas
Julio 2018
Departamento Técnico de CONAFE
Record de animales evaluados en un mes
La reciente evaluación mensual de Julio ha incluido el genotipado y valoración de 2371 nuevos animales de los cuales 2097 son hembras registradas Hasta la fecha se trata de la mayor incorporación de genotipos a la base de datos que supera ya los 100.000 genotipos. Como curiosidad el animal que entró en esta posición tan redonda es Guri Coconut G-Force 7093 con número de registro ESPH1704528912
Top 25 Ter neras Genómicas por ICO
En esta ocasión, el primer puesto del ranking lo mantiene Candesa Yosi 7067 Lager con 4837 puntos de ICO, siendo la incorporación más destacada al listado DG Vekis lausan propiedad de Ramaderia Anibal S L
Las referencias actuales para ICO de ter neras son:
Top 25: 4438
Top 200: 4079
Top 1000: 3684


Nº Número Nombre Año nac. Índice Pedigrí VGD ICO GICO Ganadería 1 ESPH1504592109 CANDESA YOSI 7067 LAGER ET 2018 4219 5057 4837 S A T CANDESA 2 ESPH1504630457 GRILLE LAGER NITHA 1128 FIV ET 2018 4282 4977 4795 GRILLE S COOP GALEGA 3 ESPH2504623036 DG VEKIS LAUSAN 2017 3832 5021 4761 RAMADERIA ANIBAL, S L 4 ESPH2704648024 TEIXEIRO BATERY GLISPA 2018 4352 4878 4736 S A T TEIXEIRO 5 ESPH0804529382 THOS CLEVER LLUNA ET 2018 4423 4780 4689 RAMADERIA CAN THOS, S L 6 ESPH1704619261 AF TATA DECLIC JADE ET 2018 4336 4772 4675 AGRUPACION FLUVIA S L 7 ESPH0804455550 GEL 4115 SHARPE BUFFER-ET 2017 3822 5015 4662 CAN GEL, S C P 8 ESPH1704525228 GENER BLIUANS BANDARES 1683 2017 4127 4789 4621 MAS GENER S C P 9 ESPH3304500309 FREIXE HOTLINE COSMICA ET 2017 4150 4766 4600 GANADERIA Y TURISMO FREIXE S L 10 ESPH0804620463 THOS AMULET MITA 2018 3928 4838 4579 RAMADERIA CAN THOS, S L 11 ESPH1504632724 LSCG 542 DECLIC FIV ET 2018 4203 4692 4553 LANDEIRA SDAD COOP GALEGA 12 ESPH2704632573 CASANOVA DECLIC LIDIA 473 ET 2018 4390 4600 4547 GANADERIA CASANOVA 13 ESPH2704638096 XERCASPORTA SUPERTORO 0202 2018 4017 4674 4527 PORTALOUSA 14 ESPH1504589563 CAMPO LUCIN MONTROSS 7035 ET 2018 4103 4710 4525 CAMPO DE LUCIN S C 15 ESPH0804455713 CAVALLERIA SUPERTORO XAROP 2017 4316 4611 4519 MAS LA CAVALLERIA 16 ESPH1704623030 GENER BIFFS LIGHTOUSE 1749 ET 2018 4075 4633 4503 MAS GENER S C P 17 ESPH1504485023 CAMPA SUPERTORO MEGATEA 2017 4057 4683 4502 S A T A CAMPA 18 ESPH0804620467 THOS DUKE NELIZE 2018 4285 4572 4488 RAMADERIA CAN THOS S L 19 ESPH2704587517 FERREIRO SUPERTORO 3856 ET 2017 3904 4701 4487 FERREIRO RIAL S C 20 ESPH1704527484 GENER BLUMS SUPERHERO 1694 ET 2017 4085 4630 4479 MAS GENER S C P 21 ESPH2704592035 XERCAS CAV ONDANA CLEVER 2018 3321 4786 4478 CAVADAS S A T XUGA 941 22 ESPH1504635643 CAMPA CLEVER 0294 2017 4138 4578 4449 S A T A CAMPA 23 ESPH1704527485 GENER BLUSTI SUPERHERO 1699 ET 2017 4085 4584 4446 MAS GENER S C P 24 ESPH2704559760 ACILLEIROS SUPERTORO 9880 2017 3893 4671 4442 ARCILLEIROS 25 ESPH1504592071 BLANCOV 9509 SHOT DOZER ET 2017 3844 4577 4438 BLANCO DE VILLALBA, S C En negrita las nuevas incorporaciones - IP: Indice de pedigrí •VGD: Valor genómico directo • GICO: ICO con infor mación genómica
1. Listado de las 25 mejores novillas genómicas españolas de menos de 18 meses según su ICO tras la evaluación de Julio 2018
Tabla
j/a 226 Frisona Española 63 G e n é t i c a
Evaluaciones genómicas Julio 2018

Tablas 2 a 5: Listados de las cinco mejores novillas por ICO de menos de 18 meses portadoras de genes de interés especial, tras la evaluación de Julio 2018


VRF: Libre rojo dominante R&W: Homocigoto Factor Rojo
VRC: Portador rojo dominante RDF: Libre Factor Rojo

POS: Homocigoto Polled
POC: Portador Polled
Tabla 5. Mejores novillas genómicas españolas Kappa Caseina
de menos de 18 meses por

Tablas 6 a 12: Listados de las cinco mejores novillas entre las 1.000 mejores





españolas de menos de 18 meses por Kg


Número Nombre Año Nac. GICO Kg. Leche ESPH2704630253 XERCAS CAV SABRINA JEDI ET 2017 4282 2474 ESPH3604588255 MOURISCADE DUKE FATIMA ET 2017 4243 2399 ESPH1704452872 PLANAS DEN14 DENVER 2368 2017 3729 2377 Número Nombre Año Nac. GICO Kg. Gr+Pr ESPH0804620467 THOS DUKE NELIZE 2018 4488 159 ESPH1504513541 SAN-RIAN LOMANA BANDARES ET 2017 3960 157 ESPH0804620464 THOS ADAGIO MARIANA P 2018 4184 151 Número Nombre Año Nac. GICO Kg. Prot. ESPH0804620467 THOS DUKE NELIZE 2018 4488 78 ESPH2704630253 XERCAS CAV SABRINA JEDI ET 2017 4282 74 ESPH2504524100 PONDEROSA MONTROSS LIBERTY 2017 4309 73 Número Nombre Año Nac. GICO Kg. Gras. ESPH1504513541 SAN-RIAN LOMANA BANDARES ET 2017 3960 94 ESPH1504633041 F.RAPOSO PETY 4767 ET 2018 3835 91 ESPH3404461462 713 RAQUEL ROMA SILVER 2017 3826 89 ESPH3604633080 ABONXO OUTLAST DAISY RED ET 2018 4179 88 ESPH1504639831 CUNDINS CRISTECLA KING ROYAL 2018 3821 88 Tabla 7. Mejores novillas genómicas españolas de menos de 18 meses por Kilos de Grasa
Tabla 8. Mejores novillas genómicas españolas de menos de 18 meses por Kilos de Proteína
Número Nombre Año Nac. GICO Polled ESPH0804620464 THOS ADAGIO MARIANA P 2018 4184 POC ESPH0804527829 THOS MISION ALAIA P ET 2017 3763 POS ESPH0804456822 THOS MISSION ALA P ET 2017 3574 POC ESPH0804455300 1152 ROCA 1073 MISSION 2017 3511 POC
Tabla 6. Mejores novillas genómicas españolas de menos de 18 meses por Kilos de Leche
ICO Número Nombre Año Nac. GICO Beta Case. ESPH1504592109 CANDESA YOSI 7067 LAGER ET 2018 4837 A2A2 ESPH1504630457 GRILLE LAGER NITHA 1128 FIV ET 2018 4795 A2A2 ESPH0804529382 THOS CLEVER LLUNA ET 2018 4689 A2A2 ESPH1704619261 AF TATA DECLIC JADE ET 2018 4675 A2A2 ESPH0804455550 GEL 4115 SHARPE BUFFER-ET 2017 4662 A2A2
Tabla 3. Mejores novillas genómicas españolas Polled de menos de 18 meses por
A2A2 de menos de 18 meses por ICO Número Nombre Año Nac. GICO Kappa Case. ESPH1504630457 GRILLE LAGER NITHA 1128 FIV ET 2018 4795 BB ESPH2504623036 DG VEKIS LAUSAN 2017 4761 BB ESPH2704648024 TEIXEIRO BATERY GLISPA 2018 4736 BB ESPH1704623030 GENER BIFFS LIGHTOUSE 1749 ET 2018 4503 BB ESPH1704527485 GENER BLUSTI SUPERHERO 1699 ET 2017 4446 BB
Tabla 4. Mejores novillas genómicas españolas Beta
Caseina
BB
ICO Número Nombre Año Nac. GICO Color Rojo Rojo Domi.
CIAM -XF STYX R. LOIRA RED ET 2018 4412 R&W VRF
ABONXO OUTLAST DAISY RED ET 2018 4179 RDF VRC ESPH2704518963 RODASINDE ELOPED 494 8717 ET 2017 3711 R&W VRF ESPH3604633081 ABONXO FLAGSHIP SPEZI RED ET 2018 3569 RDF VRC ESPH1504519046 SAN-RIAN VALERY STEP R. RED 2017 3495 R&W VRF
ESPH1504633567
ESPH3604633080
Tabla 2. Mejores novillas genómicas españolas Rojas de menos de 18 meses por ICO
Tabla 9. Mejores novillas genómicas
de Grasa + Prot.
Número Nombre Año Nac. GICO RCS ESPH2404579588 EGIDO CRISTINA JACTIVE 2018 4030 132 ESPH1704619261 AF TATA DECLIC JADE ET 2018 4675 131 ESPH1504477400 LSCG 419 SUPERTORO FIV ET 2017 3997 131
RCS
Tabla 10. Mejores novillas genómicas españolas de menos de 18 meses por
por caracteres individuales, tras
Número Nombre Año Nac. GICO Long. ESPH0804450551 THOS SUPREM MARGARITA 2017 4007 143 ESPH1504473257 LSCG 402 CHARISMATIC FIV ET 2017 3845 142 ESPH1404545364 LENTEJARES GOVERNOR 5947 ET 2017 3750 142 ESPH1504592109 CANDESA YOSI 7067 LAGER ET 2018 4837 141 ESPH1504474916 SAN-RIAN SEMOLA BURANO 2017 4185 141
por ICO
la evaluación de Julio 2018
menos de
meses por Longevidad Número Nombre Año Nac. GICO Días Abie. ESPH1704527111 AF 7869 DETOUR 5865 2017 4406 133 ESPH3304497107 PATALLO DETOUR ARMENIA 2017 3904 131 ESPH2504621539 VIUDET MATTERS 592 TOTA 2018 3993 130 ESPH1704449930 GENER MONTANA BLUSIANA 1620 ET 2017 3923 130 ESPH1404545364 LENTEJARES GOVERNOR 5947 ET 2017 3750 130
Tabla 11. Mejores novillas genómicas españolas de
18
64 Frisona Española 226 j/a
Tabla 12. Mejores novillas genómicas españolas de menos de 18 meses por Días Abiertos

a 16: Listados de las mejores novillas por caracteres mor fologicos menores de 18 meses tras la evaluacion de Julio 2018
Tabla 13. Diez mejores novillas genómicas españolas de menos de 18 meses por IGT



Ganaderías con más novillas en el Top 200 por ICO tras el genotipado
Hasta 19 ganaderías colocan al menos tres terneras entre las 200 mejores En cabeza Mas Gener con 19 supera las 17 de Can Thos y las 15 de Landeira Sdad Coop Galega
Tabla 17. Ganaderías con 3 o más terneras entre las 200 mejores tras la evaluacion de julio 2018


Ganadería Novillas TOP 200 ICO Ganadería Novillas TOP 200 ICO MAS GENER S C P 19 4280 AGRUPACION FLUVIA S L 4 4373 RAMADERIA CAN THOS, S L 17 4299 S A T CANDESA 4 4343 LANDEIRA SDAD COOP GALEGA 15 4229 GRILLE S COOP GALEGA 4 4309 MAS LA CAVALLERIA 8 4273 FINCA RAPOSO S C 4 4269 S A T A CAMPA 7 4265 VALLS-GOL S C P 4 4204 RAMADERIA ANIBAL S L 6 4286 ANIMAL MUERTO 4 4171 CAMPO DE LUCIN,S C 6 4272 SAN RIAN SDAD COOP GALEGA 4 4136 CAN GEL, S.C.P. 6 4254 S.A.T. TEIXEIRO 3 4379 CAVADAS S A T XUGA 941 6 4221 VAZMA, S C P 3 4175 CUNORDAM, S.C. 6 4151 Nº Número Nombre Año Nac IPIGT VGD IGT IGT Ganaderia 1 ESPH0804454649 GEL 4107 EMILIO SARAH- ET 2017 3,77 4,4 3,99 CAN GEL, S C P 2 ESPH0804529023 GEL EMILIO SARONAH ET 2017 3 77 4 09 3 80 CAN GEL S C P 3 ESPH4804505757 POYU SC DOUGLAS POLITE 2018 2 65 4 02 3 71 POIU BASERRIA S C 4 ESPH3104509391 REDIN EMILIO MAITE-ET ET 2017 3,44 4,03 3,65 BARBERENA ECHARRI Y REDIN 5 ESPH0804455554 GEL 4117 EMILIO SARITAH ET 2017 3,77 3,85 3,60 CAN GEL, S C P 6 ESPH0804453424 HOLSCAT DOORMAN LAU 2017 3,03 4,03 3,57 EXP PECUARIAS COVE,S L (EL CAMPGRAN) 7 ESPH3304503539 VENTURA DOORMAN PRISMA ET 2017 3 10 3 96 3 53 GANADERIA VENTURA S C 8 ESPH3104509390 REDIN EMILIO MAITANE-ET ET 2017 3 44 3 74 3 52 BARBERENA ECHARRI Y REDIN
Número Nombre Año Nac GIGT ICAP ESPH4804504333 MURRIETA EMILIO MONICA 2017 2,81 3,52 ESPH0804454649 GEL 4107 EMILIO SARAH- ET 2017 3,99 3,41 ESPH0804529023 GEL EMILIO SARONAH ET 2017 3,8 3,35 ESPH3104509391 REDIN EMILIO MAITE-ET ET 2017 3,65 3,18 ESPH1504516219 SAN-RIAN DARLA EMILIO 2017 2 93 3 12 Número Nombre Año Nac GIGT ICU ESPH1504559405 DOBLE "S" JACOBY BOMBI 7027 ET 2017 3,28 4,11 ESPH3304495713 FERREIRO JACOBY KARIOCA 2017 2,99 3,90 ESPH3104510199 ANDALORREA JACOBY LARRAXURI 2017 3,04 3,89 ESPH2704471592 BAIXO BYWAY BIBY 2017 2 77 3 79 ESPH3304503540 VENTURA DOORMAN PRISCILA ET 2017 3,44 3,77 Número Nombre Año Nac GIGT IPP ESPH4504377830 HNOS MIGUEL 333 ATWOOD 2017 2,54 2,77 ESPH1404548532 ALEGRIA SCP GOLD CHIP CADIZ 2018 2,7 2,61 ESPH1704452022 AF 7795 HOTROD 5767 2017 2,6 2,57 ESPH2504533217 MARSINO SILVER 697-790 2017 2 25 2 50 ESPH1504586789 GRILLE JORDY R MAE 1093 FIV ET 2017 2,59 2,42
Tabla 15. Mejores novillas genómicas españolas de menos de 18 meses por ICU
Tabla 16 Mejores novillas genómicas españolas de menos de 18 meses por ICAP
Tabla 14. Mejores novillas genómicas españolas de menos de 18 meses por IPP
j/a 226 Frisona Española 65
Tablas 13
G e n é t i c a Nuevos toros en repar to
A continuación aparecen –ordenados alfabéticamente por su nombre corto– los nuevos toros puestos en reparto facilitados por los centros de Inseminación Artificial españoles propietarios de los mismos
La infor mación de cada animal es la registrada en el Libro Genealógico de CONAFE
En la primera línea aparecen el nombre completo del toro y los caracteres recesivos; la fecha de nacimiento; el código de IA y el número genealógico
En la segunda y tercera línea, se muestran los índices genéticos correspondientes a las últimas pruebas disponibles (se indica país, año y mes)
En la cuarta línea están el nombre y número genealógico del padre y del abuelo pater no
E l i t lí tá l b l ú

Claves de caracteres recesivos
BLAD Libre BLAD BLF
BULLD
CVM
DUMPS
Brachyspina
Portador BLAD BLC
Libre Bulldog BDF
Portador Bulldog BDC
Libre CVM CVF
Portador CVM CVC
Libre DUMPS DPF
Portador DUMPS DPC
Libre Brachyspina BYF
Portador Brachyspina BYC
BR Portador Factor Negro/Rojo BRC
RD Libre Factor Rojo RDF



Arkman SNIPER ET 20/03/17 2110589 ESPM9204501765 Índices kg Leche kg Grasa kg Prot IPP ICU RCS Long DA GICO Grilo Sanrecam LUCKY ET 24/05/17 2110592 ESPM2704487908 Índices kg Leche kg Grasa kg Prot IPP ICU RCS Long DA GICO ESP-18/06 1663 78 63 1,13 1,94 108 120 104 4296 DUKEFARM SILLIAN ET ESPM9204181828 SEAGULL-BAY SILVER ET USAM0072156794 HUL-STEIN LOTUS SANRECAM ESPH1504221643 COGENT SUPERSHOT NLDM0755898903 Granxa Grillo Ascol-Centro de Seleccion Inicio reparto: Agosto 2018 66 Frisona Española 226 j/a
Solamente con alimentos de alta calidad se obtienen altas producciones en las vacas lecheras. El buen ensilado de maíz es básico para la producción










Consiga máxima rentabilidad con los productos de ensilado de BONSILAGE MAÍZ
: un 5 % más de alimento digestible : un 5 % menos de pérdidas del ensilado en el frente 4 un 10 % más de energía con BONSILAGE MAÍZ
www.schaumann.info
Más energía y más leche por hectárea gracias a la estabilidad de su ensilado de maíz Con las mismas Has. más alimento y de más calidad para sus animales
En momentos en los que el precio de las materias primas aumenta sobremanera, la energía adicional que aporta BONSILAGE MAÍZ es más valiosa que nunca (de 100 a 170 €/ha. de incremento de beneficios)

MARAGATOS, 75 49600 BENAVENTE mga@mgasl.es
980 63 04 97
www.bonsilage.es

1ª: Vaca C



2ª: Vaca B



3ª: Vaca D



4ª: Vaca A

Resultados Sección 87:
Novillas de primer par to hasta 30 meses
Observaciones previas:
Bonita sección de novillas jóvenes que representan muy bien su categoría y con muy buenas ubres en general.
Colocación Oficial: C - B
- D - A


Explicación oficial:
Introducción: Vence la categoría el animal más equilibrado en todas sus partes, con una fantástica estructura lechera, fantástica ubre y buenas patas .
1ª sobre 2ª: Por esa mejor limpieza en todo su tercio anterior, espaldas y muslos, así como por una inserción posterior de la ubre algo más ancha y mejor arqueamiento del costillar.
2ª sobre 3ª: Por una mejor for ma e inserción de la ubre anterior, más alta la inserción posterior y mejor profundidad del costillar anterior que la angulosa y descar nada novilla roja
3ª sobre 4ª: Por mejor textura de ubre, inserción anterior y colocación de pezones anteriores Presenta además mejor angulosidad, mejor separación de costillas y mejor limpieza de muslos que la tremenda novilla, por su estructura y capacidad, colocada cuarta.

Ganador entre los acertantes con pleno: No ha habido ningún acertante en esta sección

Vaca A


Sección 88: Vacas inter medias de se gundo par to

Vaca B


Vaca C




Vaca D



EXPLICACIÓN DE LA COLOCACIÓN:
Es imprescindible razonar el orden elegido hablando del conjunto de la sección mencionando dos o tres características de cada posición y haciendo un comentario final Solo se admitirá una respuesta por participante
Introducción:
1ª sobre 2ª:
2ª sobre 3ª:
3ª sobre 4ª:
Conclusiones:
SECCIÓN 88
Orden Vaca

Premio: Forro polar de CONAFE
Datos del concursante:
Nombre y apellidos: ......................................................
Profesión:
Dirección: .........................................................................................
Código postal, localidad y provincia:
Teléfono:
1ª 2ª 3ª 4ª
Envíe este cupón a FRISONA ESPAÑOLA Apdo de Correos 31 - 28340 Valdemoro (Madrid) antes del 5 de octubre de 2018


Costes de servicio predefinidos
10º/o de mayor capacidad


r.�oeLaval
C a l i f i c a c i ó n Animales calificados EX y MB
A continuación aparece la relación de animales (nombre y propietario) calificados durante los meses de mayo y junio de 2018 que han obtenido las categorías de EX o MB.
Recordamos que según el Reglamento del Libro Genealógico de la Raza Frisona, la categoría de Excelente sólo se puede otorgar a partir del tercer parto La categoría nEX (con n = 2, 3, 4 ), se

MACHOS EXCELENTES
concede a todo animal que haya vuelto a ser calificado Excelente en partos diferentes
En la web de CONAFE www.conafe.com aparece esta misma relación junto con el número genealógico y el padre de cada animal
También en esta web, a través de SinbadFree, se puede ampliar la infor mación sobre genealogías, índices y producciones de estos animales

SANTAISABEL MASCALESE OLMO/S A T GRANJA SANTA ISABEL Nº - NAVARRA
MACHOS MB - 86 PUNTOS
C NUEVA OCTANE DIABOLO E/C NUEVA - VIZCAYA
MACHOS MB - 85 PUNTOS
CARRILES CASO CASUAL/AJAPALACIO S C - CANTABRIA
EL CORSO MORO IMPRESSION/S A T F J SALCINES-EL CORSO 9804 - CANTABRIA
LAUTHORITY MOISES/S A T LA GALERA HOLSTEIN Nº39158 - CANTABRIA
SERJA DANILO EXACTER/LA PLAYA S C - CANTABRIA
HEMBRAS 6 VECES EXCELENTES
KAREN SOMALERA/S A T SOMALERA Nº 39090 - CANTABRIA
HEMBRAS 4 VECES EXCELENTES
PREISLER BUCKEYE/LOS MIJARES - CANTABRIA
HEMBRAS 3 VECES EXCELENTES
VIÑA SHOTTLE BLANQUINA/CASA VIÑA S C - ASTURIAS
HEMBRAS 2 VECES EXCELENTES
AORMI FATIMA FEVER/AORMI - CANTABRIA


Técnicos Calificadores
Juan Manuel Fer nández Ahedo (Jefe Dpto Mor fología), Marcial Avelló Santiago, Domingo Ces Ares
Alejandro González del Valle Mier, Luis Mario López Vázquez, Santiago Mato Montouto, Julián Montero García, Pedro Javier Peréz Pérez y Rafael Vier na Pita
ARDEO SID 1099/C B MIREN ARDEO Y OTROS - VIZCAYA
CAMPGRAN JASMINE MILLION/EXP PECUARIAS COVE,S L (EL CAMPGRAN) - BARCELONA
FISURE CB SID LAIA/FISURE PORTILLO, C B - VIZCAYA
GUTIERREZ GOLDWYN MAYTANE/BARBERENA ECHARRI Y REDÍN - NAVARRA
LA RIA FLORA IGNITER/LA RÍA - CANTABRIA
MIJARES PERLA SPIRTE/LOS MIJARES - CANTABRIA
PLANILLO BONAIR HELEN/PLANILLO HOLSTEIN - NAVARRA
SOMOBOO SUSA FEVER/SOMOBOO - CANTABRIA
UZQUIANO-FEVER UZQUIANO-/ZALDUBITXI S COOP PEQUEÑA - ÁLAVA
ZIGA WINDBROOK 0060/S C ZIGA - NAVARRA
HEMBRAS EXCELENTES
1260 JJ MIRIAM BURNS/PAULORENA HOLSTEIN S L - LLEIDA
1353 JJ LAURA VISON/PAULORENA HOLSTEIN,S L - LLEIDA
282 RASET ANITA RICHMAN/CAN RASET, S C - GIRONA
ANDALORREA DEMPSEY 971/S A T ANDALORREA, Nº 4322 - NAVARRA
ARGOMOTA ATWOOD ROXETE ET/CASA VIÑA, S C - ASTURIAS
ARGOMOTA MOGUL DELTA/CASA VIÑA, S C - ASTURIAS
ARGOMOTA SHAMROCK SALOME/CASA VIÑA, S C - ASTURIAS
ARGOMOTA STANLEYCUP HARMONY/CASA VIÑA S C - ASTURIAS
BEDOLLO GISELA GLEN/GANADERÍA BEDOLLO S C - CANTABRIA
BRINGAS DUPLEX/LA RIGADA - VIZCAYA
CAMPGRAN CHASS CARSON/EXP PECUARIAS COVE S L (EL CAMPGRAN) - BARCELONA


72 Frisona Española 226 j/a
Karen Somalera 6X (S A T Somalera, Cantabria)
Preisler Buckeye 4EX (Los Mijares, Cantabria)
Viña Shottle Blanquina 3EX (Casa Viña, Asturias)
Campgran Sumatra Carson EX (El Campgran, Bar na)
Planillo Shottle Monalisa EX (Planillo, Navarra)
CAMPGRAN ELISE MERIDIAN/EXP PECUARIAS COVE,S L (EL CAMPGRAN) - BARCELONA
CAMPGRAN GINA EXPLODE/EXP PECUARIAS COVE,S L (EL CAMPGRAN) - BARCELONA
CAMPGRAN SUMATRA CARSON/EXP PECUARIAS COVE,S L (EL CAMPGRAN) - BARCELONA
COOP LAG LOTTA-HIL L K -HILL/COOP LAGUNAK - ÁLAVA
COOP LAG OSAKA L K OSAKA/COOP LAGUNAK - ÁLAVA
CRUZ LEZAMA LUJAN GILLESPY/S A T CRUZ LEZAMA 39120 - CANTABRIA
EMPORDANESA/FRISIONAS S L - GIRONA
G P LAUTHORITY 534/GRANJA PUIGPINOS - LLEIDA
G P XACOBEO 496/GRANJA PUIGPINOS - LLEIDA
GP WINDBROOK 690/GRANJA PUIGPINOS - LLEIDA
HERBARFER VINCE VANESA/HERBARFER - VIZCAYA
ILLINOISE/S A T CRUZ LEZAMA 39120 - CANTABRIA*
JM KAMPMAN IRON/JMD ALLUE, S L - LLEIDA
KATTABURU GABOR ARIKA/S C KATTABURU - NAVARRA
LA RIA NUBE FEVER/LA RIA - CANTABRIA
LA RIA SOLEDAD IGNITER/LA RIA - CANTABRIA
LANDA GAM FLASHBACK/LANDA GAMBOA, S L - ÁLAVA
LOS TEJOS WINDBROOK YOWIN/LOS TEJOS, C B - VIZCAYA
MIJARES ANASTASIA CHAMPION/LOS MIJARES - CANTABRIA
NOZALIN SALADA ATLANTIC/NOZALIN - ASTURIAS
ONDAZARTE ATWOOD BARDOA/ONDAZARTE GAIN S L - GUIPÚZCOA
PEÑARROYA 1240/GRANJA BARRAGUER PENA S L - HUESCA
PINOS SITA ALTA RUSH/EL PINOS NOU - BARCELONA
PLANILLO SHOTTLE MONALISA-ET/PLANILLO HOLSTEIN - NAVARRA
PLANILLO WINDBROOK IRAYA/PLANILLO HOLSTEIN - NAVARRA
Q617/AGROPECUARIA QUATRE VENTS,SL - GIRONA
Q964/AGROPECUARIA QUATRE VENTS,SL - GIRONA
SAINZ-AJA MIZUNO 254/S C MADRAZO R J Y SAINZ AJA TRUEBA - NAVARRA
SANTAISABEL PRESENT MARGOT/S A T GRANJA SANTA ISABEL Nº - NAVARRA
SOMALERA EXPLODE EXPLODE/S A T SOMALERA Nº 39090 - CANTABRIA
TRAVESÍA JETT AIR LUPITA/S A T LA TRAVESÍA 896 - NAVARRA
TRAVESÍA SID AURA/S A T LA TRAVESÍA 896 - NAVARRA
TRAVESÍA STANLEYCUP SOFI/S A T LA TRAVESÍA 896 - NAVARRA
TRAVESÍA STANLEYCUP TANA/S A T LA TRAVESÍA 896 - NAVARRA
UZQUIANO- FEVER UZQUIANO-/ZALDUBITXI S COOP PEQUEÑA - ÁLAVA
VILATORTELLA 3076 STALNLEYCUP/S A T VILATORTELLA 544 CAT - BARCELONA
VIÑA ATWOOD ALBA/CASA VIÑA S C - ASTURIAS
VIÑA JASPER CUCA/CASA VIÑA, S C - ASTURIAS
VIÑA YORICK MAJICA/CASA VIÑA, S C - ASTURIAS
ZABAL ERR FEVER 0082/ZABAL ERREKONDO, S C - GUIPÚZCOA
ZALDUBITX LAUTHORIT ZALDUBITX/ZALDUBITXI,S COOP PEQUEÑA - ÁLAVA
HEMBRAS MB DE 1º PAR TO - 88 PUNTOS
CAMPGRAN GEO DELTA/EXP PECUARIAS COVE S L (EL CAMPGRAN) - BARCELONA
GUTIERREZ ANTON BEYONSII 654/BARBERENA ECHARRI Y REDÍN - NAVARRA
QUINTANA NAGORE JETT AIR/C NUEVA - VIZCAYA
HEMBRAS MB DE 1º PAR TO - 87 PUNTOS
ARENAS HILDER STRUNK/HERBARFER - VIZCAYA
BEHI-ALDE BRICK 6881/COOPERATIVA BEHI-ALDE - ÁLAVA
C NUEVA MASCALESE PAZ E T /C NUEVA - VIZCAYA
CAMPGRAN ANUR DELTA/EXP PECUARIAS COVE,S L (EL CAMPGRAN) - BARCELONA
CAMPGRAN MOHICANA PLANET/EXP PECUARIAS COVE,S L (EL CAMPGRAN) - BARCELONA
FELE HERO JOSEFA/GANADERÍA FELE, S C - ASTURIAS
HERBARFER LAUTHORIT SUSANA/HERBARFER - VIZCAYA
KATTABURU SPUR CREMA/S C KATTABURU - NAVARRA
LOS.TEJOS SPUR MALI/LOS TEJOS C B - VIZCAYA
NODI DOORMAN SUPERSTAR ET/GANADERÍA INCLÁN S C - ASTURIAS
POU LLUNA BLAVA MCCUTCHEN/CAN POU - GIRONA
PRAT COMMANDER 874/S PRAT PRAT C F - NAVARRA
VIÑA MCCUTCHEN PEA/CASA VIÑA S C - ASTURIAS
HEMBRAS MB DE 1º PAR TO - 86 PUNTOS
1281/MAS MADIROLES - BARCELONA
5145 ATWOOD/S A T DISAMA Nº 39014 - CANTABRIA
AGIRRESOR BRAWLER 3572/AGIRRESOROAUNDI,S C - GUIPÚZCOA
ANDALORREA DELTA 1093/S A T ANDALORREA, Nº 4322 - NAVARRA
ARCE ATWOOD SUSE/S A T ARCE III - CANTABRIA
ARDEO BREKEM 1363/C B MIREN ARDEO Y OTROS - VIZCAYA
BARRIGRAN BENEDELTA 1352 ET/AGROPECUARIA CAN BARRINA S L - BARCELONA
BEHI-ALDE SAKUM 6721/COOPERATIVA BEHI-ALDE - ÁLAVA
BUSTO SEAVER SEOANE/GARCIA DEL BUSTO S C - ASTURIAS
C NUEVA LAUTHORIT DULCE/C NUEVA - VIZCAYA
CAMPGRAN CUMBA DELTA/EXP PECUARIAS COVE S L (EL CAMPGRAN) - BARCELONA
CAMPGRAN FOX COLLATERAL/EXP PECUARIAS COVE S L (EL CAMPGRAN) - BARCELONA
CAMPGRAN KIOTO COLLATERAL/EXP PECUARIAS COVE,S L (EL CAMPGRAN) - BARCELONA
CAMPGRAN NAGOYA OCTANE/EXP PECUARIAS COVE,S L (EL CAMPGRAN) - BARCELONA
CAMPGRAN NOVA DELTA/EXP PECUARIAS COVE,S L (EL CAMPGRAN) - BARCELONA
CAMPGRAN OPORTO LINK UP/EXP PECUARIAS COVE,S L (EL CAMPGRAN) - BARCELONA
CAMPGRAN ORA LINK UP/EXP PECUARIAS COVE,S L (EL CAMPGRAN) - BARCELONA
CAMPGRAN SAMOA BEEMER/EXP PECUARIAS COVE,S L (EL CAMPGRAN) - BARCELONA
CAMPGRAN YAREN BRADY/EXP PECUARIAS COVE,S L (EL CAMPGRAN) - BARCELONA
CASTILLO TESSER 438/LUIS CASTILLO VILLAFRANCA - NAVARRA
GENER RUBICON SHANOAS 1473/MAS GENER S C P - GIRONA
GP MCCUTCHEN 825/GRANJA PUIGPINOS - LLEIDA
GUTIERREZ MCCUTCHEN JANE/BARBERENA ECHARRI Y REDÍN - NAVARRA
GUTIERREZ MCCUTCHEN JINETA/BARBERENA ECHARRI Y REDÍN - NAVARRA
HERBARFER ABSOLUTE REINA/HERBARFER - VIZCAYA
HERBARFER ABSOLUTE YERA ROJA/HERBARFER - VIZCAYA
JBTOULLEC LELSIA/EXP PECUARIAS COVE,S L (EL CAMPGRAN) - BARCELONA
KATTABURU SEAVER SIBERIA/S C KATTABURU - NAVARRA
LANDA GAM DORCY/LANDA GAMBOA, S L - ÁLAVA
LAVANDE/S A T DE LA VEGA SOTA 39075 - CANTABRIA
LENGUSUEK DELTA ALAITZ/S A T LENGUSUEK Nº 356 - NAVARRA
LENGUSUEK DELTA LAIA/S A T LENGUSUEK Nº 356 - NAVARRA
LENGUSUEK DORIN TXINTXOA/S A T LENGUSUEK Nº 356 - NAVARRA
LENGUSUEK EXPLODE SU-GARRA/S A T LENGUSUEK Nº 356 - NAVARRA
LOS TEJOS ATWOOD DEFEN/LOS TEJOS C B - VIZCAYA
LOS TEJOS DEFENDER LEONDER/LOS TEJOS C B - VIZCAYA
LOS TEJOS FACEBOOK BOOK/LOS TEJOS C B - VIZCAYA
LOS TEJOS MCCUTCHEN DESAPAREC/LOS TEJOS C B - VIZCAYA
MIJARES PERLITA DOORMAN/LOS MIJARES - CANTABRIA
MIJARES PORTEÑA SNOWY/LOS MIJARES - CANTABRIA
MURRIETA LEXUS PAM/MURRIETA - VIZCAYA
PEDREGAL SNOWFALL ARIEL/EL PEDREGAL, S C - ASTURIAS
PINOS FULLA DELTA/EL PINOS NOU - BARCELONA
PLANILLO MASCALESE CONDA/PLANILLO HOLSTEIN - NAVARRA
POU GIOCONDA YORICK/CAN POU - GIRONA
PRAT 876/S PRAT PRAT C F - NAVARRA
RAMORENA FEVER EGUZKILORE/SCDAD COOP LTDA RAMORENA - NAVARRA
SABINO BRAWLER MAREN/CASA VIÑA S C - ASTURIAS

j/a 226 Frisona Española 73
SAIRETA MERIDIAN DIANA/LA SAIRETA, S C P - LLEIDA
SANTAISABEL BEHOBIA BOLERA/S A T GRANJA SANTA ISABEL Nº - NAVARRA
SARGAITZ BEEMER 505/S A T GARBIÑE Nº 6353 - NAVARRA
SARGAITZ ELUDE 511/LASTAOLA BASERRÍA - GUIPÚZCOA
TH BARRINA BLISSFUL EXPLODE/AGROPECUARIA CAN BARRINA, S L - BARCELONA
TRAVESÍA ANCHOR CHASKA/S A T LA TRAVESÍA 896 - NAVARRA
TRAVESÍA WICKHAM DILA/S A T LA TRAVESÍA 896 - NAVARRA
TRAVESÍA WICKHAM MIKY/S A T LA TRAVESÍA 896 - NAVARRA
V ARIEL EXACTER/S A T SIERRA VILLA N 39155 - CANTABRIA
VILATORTELLA 3444 SPUR/S A T VILATORTELLA 544 CAT - BARCELONA
VIÑA ATWOOD ADORA/CASA VIÑA S C - ASTURIAS
VIÑA LOOK SELVA/CASA VIÑA S C - ASTURIAS
ZABAL ERR BRAWLER 5430/ZABAL ERREKONDO, S C - GUIPÚZCOA
ZALDUBITX MCCUTCHEN ZALDUBITZ/ZALDUBITXI,S COOP PEQUEÑA - ÁLAVA
HEMBRAS MB DE 1º PAR TO - 85 PUNTOS
1252/AGROPECUARIA QUATRE VENTS,SL - GIRONA
1290/AGROPECUARIA QUATRE VENTS,SL - GIRONA
1340/AGROPECUARIA QUATRE VENTS SL - GIRONA
2293/S A T BERNALLÁN N 9127 - CANTABRIA
2434/S A T OLAGORRIA Nº 660-NA - NAVARRA
3113 BES DURBIN 2417/AGROPECUARIA MAS BES S L - GIRONA
3149 BES WICKHAM 2119/AGROPECUARIA MAS BES S L - GIRONA
3181 BES LET IT SNOW 2480/AGROPECUARIA MAS BES S L - GIRONA
3316/S A T OLAGORRIA Nº 660-NA - NAVARRA
372 RASET LIAMCCUTCHEN/CAN RASET, S C - GIRONA
540/MAS PUIG - GIRONA
719 DURAN DENZEL SECURITY/MAS GELAT VELL, S L - GIRONA
AGIRRESOR BIARRIZ 2014/AGIRRESOROAUNDI,S C - GUIPÚZCOA
ALBA ATJE JETT AIR/TAUSTE GANADERA S A - ZARAGOZA
ALBA COQUETA KRUSADER/TAUSTE GANADERA S A - ZARAGOZA
ALBA JETT AIR WICKHAM/TAUSTE GANADERA S A - ZARAGOZA
ALBA JORDAN WICKHAM/TAUSTE GANADERA S A - ZARAGOZA
ALDAPA BEHOBIA 1576/S C-L- ALDAPA - NAVARRA
ALDAPA MADOR 1594/S C-L- ALDAPA - NAVARRA
AMETSLEKU ENVIOUS AIALA/AMETSLEKU C B - VIZCAYA
ANDALORREA DELTA 1105/S A T ANDALORREA Nº 4322 - NAVARRA
ANDALORREA DELTA 1109/S A T ANDALORREA, Nº 4322 - NAVARRA
ANDALORREA EXPLODE 1083/S A T ANDALORREA, Nº 4322 - NAVARRA
AORMI DAISY BOOKEL/AORMI - CANTABRIA
AORMI MOGLI 1072 MOGUL/AORMI - CANTABRIA
AR MOLINO FAVRE INES/EL MOLINO, S C - VIZCAYA
ARCA IRUSA PIANOMAN/S A T COGU-EL REY - CANTABRIA
ARCE DOORMAN LERCHE/S A T ARCE III - CANTABRIA
ARCE GILLESPY SUSE/GANADERÍA CARRILES S L - CANTABRIA
ARCE MCCUTCHEN LERCHE/S A T ARCE III - CANTABRIA
ARDEO SPARTEN 1378/C B MIREN ARDEO Y OTROS - VIZCAYA
ARGOMOTA DOORMAN ROBIN/CASA VIÑA S C - ASTURIAS
ARTIME NEYMAR GITANA/GARCIA DEL BUSTO S C - ASTURIAS
AYMERICH 702 BEHOBIA 582/MAS CIURANA - GIRONA
AYMERICH 723 BEHOBIA 573/MAS CIURANA - GIRONA
BARRINA LINK UP 1365/AGROPECUARIA CAN BARRINA, S L - BARCELONA
BARRINA MCCUTCHEN 1301/AGROPECUARIA CAN BARRINA, S L - BARCELONA
BARRINA SILVER 1335/AGROPECUARIA CAN BARRINA, S L - BARCELONA
BASATXABA BOLET 5775/BASATXABAL BASERRÍA - GUIPÚZCOA
BATLLORI 869 WICKHAM/E A P BATLLORI, S C - GIRONA
BATLLORI 883 DONATELLO/E A P BATLLORI S C - GIRONA
BATZABALEA SEAVER ITZEL/S A T MENDICOA - NAVARRA
BEDOLLO MANUELA MASCALESE/GANADERÍA BEDOLLO S C - CANTABRIA
BEDOLLO TAMARA MOGUL/GANADERÍA BEDOLLO S C - CANTABRIA
BEHI-ALDE BEHOBIA 6857/COOPERATIVA BEHI-ALDE - ÁLAVA
BEHI-ALDE BUFALO 6703/COOPERATIVA BEHI-ALDE - ÁLAVA
BEHI-ALDE MOJITO 6887/COOPERATIVA BEHI-ALDE - ÁLAVA
BEHI-ALDE ROCKY 6877/COOPERATIVA BEHI-ALDE - ÁLAVA
BEHI-ALDE SAKUM 6760/COOPERATIVA BEHI-ALDE - ÁLAVA
BERNABE WINDBROOK WINA/GANADERÍA BERNABE, S C - ASTURIAS
BERNABE YORICK CHANEL/GANADERÍA BERNABE, S C - ASTURIAS
BIDARTE B IMPRESSIO 594/BIDARTE Baserria - GUIPÚZCOA
BUSTO SID HARMONIA/GARCIA DEL BUSTO, S C - ASTURIAS
BUSTO SID PAZ/GARCIA DEL BUSTO S C - ASTURIAS
BUSTO SID SELMA/GARCIA DEL BUSTO S C - ASTURIAS
BUSTO TWINE HILDA/GARCIA DEL BUSTO S C - ASTURIAS
C NUEVA BRAXTON ASHLEY E /POIU BASERRIA S C - VIZCAYA
C NUEVA CHELIOS DELICIA/C NUEVA - VIZCAYA
C NUEVA CHELIOS JANA/C NUEVA - VIZCAYA
C NUEVA MASCALESE MALI/C NUEVA - VIZCAYA
C V BELLA PETY/S A T N 39001 CUATROVIENTOS - CANTABRIA
C V JULIETA PETY/S A T N 39001 CUATROVIENTOS - CANTABRIA
CAL ROS BIANCA RAZOR/CAL ROS - GIRONA
CALIBER 942/HNOS VALLEJO JIMÉNEZ, C B - SORIA
CALIBER 948/HNOS VALLEJO JIMÉNEZ, C B - SORIA
CAMPGRAN ALONCAGUA DOORMAN/EXPPECUARIAS COVE,S L (EL CAMPGRAN)-BARCELONA
CAMPGRAN DEMBA OCTANE/EXP PECUARIAS COVE S L (EL CAMPGRAN) - BARCELONA
CAMPGRAN DOHA BRADY/EXP PECUARIAS COVE S L (EL CAMPGRAN) - BARCELONA
CAMPGRAN DOROTEARS DELTA ET/EXP PECUARIAS COVE S L (EL CAMPGRAN) - BARCELONA
CAMPGRAN FURIA COLLATERAL/EXP PECUARIAS COVE S L (EL CAMPGRAN) - BARCELONA
CAMPGRAN ISAURA LINK UP/EXP PECUARIAS COVE S L (EL CAMPGRAN) - BARCELONA
CAMPGRAN MURA COLLATERAL/EXPPECUARIAS COVE S L (EL CAMPGRAN) - BARCELONA
CAMPGRAN POPSTAR BRADY/EXP PECUARIAS COVE,S L (EL CAMPGRAN) - BARCELONA
CAMPGRAN SNOWBALL BEEMER/EXPPECUARIAS COVE,S L (EL CAMPGRAN) - BARCELONA
CANTEIRO ABOI 9453/TAUSTE GANADERA S A - ZARAGOZA
CASTILLO GERARD 421/LUIS CASTILLO VILLAFRANCA - NAVARRA
CAVALLERIA INSIDER PRUNA/MAS LA CAVALLERIA - BARCELONA
CAVALLERIA WICKHAM GARBELL/MAS LA CAVALLERIA - BARCELONA
DAENERIS DE LA TORMENTA/CASANUEVA GONZÁLEZ S C - CANTABRIA
DAVID ESC DOORMAN 580 DOORM/DAVID ESKUZA ARBAIZA - ÁLAVA
EGOZ-ITURRAL MADOR 1668/MIREN Y FERNANDO EGOZ- ITURRALDE - NAVARRA
EL REY CRIS ATWOOD/S A T COGU-EL REY - CANTABRIA
EL CAMPO GOLD CHIP 2434/EL CAMPO - VIZCAYA
EL CAMPO MERIDIAN REINA/EL CAMPO - VIZCAYA
ESPARZA FACEBOOK 2077/S A T 1316 ESPARZA HNOS - NAVARRA
FERRERU EMMETT FABIOLA/CASA EL FERRERU - ASTURIAS
FERRERU PEDRO 6957/CASA FERRERU - ASTURIAS
FISURE CB LAUTHORIT JULIA/FISURE PORTILLO, C B - VIZCAYA
FRANCIA CATAPULT L'HISTOIR/LASTAOLA Baserria - GUIPÚZCOA
FRANCIA SILVER GALLAIS L/BIDARTE Baserria - GUIPÚZCOA
G S 6388 STRUNK/GERMAN SARABIA - CANTABRIA
GABI/S A T GANADERÍA HERGU - CANTABRIA
GAN-ETXEBERRI 6061/S A T Nº 653 GAN ETXEBERRI - NAVARRA
GAN-ETXEBERRI METEOR 4252/S A T Nº 653 GAN ETXEBERRI - NAVARRA
GARBIÑE AIRLIFT BLANQUI/S A T GARBIÑE Nº 6353 - NAVARRA
GARBIÑE PETY 84/S A T GARBIÑE Nº 6353 - NAVARRA
GARBIÑE WICKHAM VIOLETA 75/S A T GARBIÑE Nº 6353 - NAVARRA
GENER MARININA KINGBOY 1430/MAS GENER S C P - GIRONA
GP CANCUN 736/GRANJA PUIGPINOS - LLEIDA
GP GERARD 796/GRANJA PUIGPINOS - LLEIDA
GP GULF 725/GRANJA PUIGPINOS - LLEIDA
GP IOTA 808/GRANJA PUIGPINOS - LLEIDA
GP MOGUL 814/GRANJA PUIGPINOS - LLEIDA
GREATEST 949/HNOS VALLEJO JIMENEZ C B - SORIA
GURI SERENADE SILVER 6326/MAS GURI SAT Nº 4756 - GIRONA
GURI TABA SILVA 6452/MAS GURI SAT Nº 4756 - GIRONA
GUTIERREZ DOORMAN COVADONGA 71/BARBERENA ECHARRI Y REDIN - NAVARRA
GUTIERREZ ENDURE VERO/BARBERENA ECHARRI Y REDIN - NAVARRA
GUTIERREZ MOGUL PASCUA 723/S C TORAL - NAVARRA
HERBARFER DOORMAN DANAE/HERBARFER - VIZCAYA
HERBARFER FEVER MALEN/HERBARFER - VIZCAYA
HERBARFER LAUTHORIT LETICIA/HERBARFER - VIZCAYA
HERBARFER MACAO LEZNA/HERBARFER - VIZCAYA
INCLAN AFTERSHOCK TELVI/GANADERÍA INCLÁN S C - ASTURIAS
INCLAN BEEMER BETY/GANADERÍA INCLAN S C - ASTURIAS
INCLAN HERO YENI/GANADERÍA INCLÁN S C - ASTURIAS
INDELANTE BONITA MOGUL/S A T INDELANTE 39140 - CANTABRIA
IRURZUN EPIC 866/S A T LARRATE Nº 626 - NAVARRA
IRURZUN IOTA 864/S A T LARRATE Nº 626 - NAVARRA
IRURZUN MANIFOLD 868/S A T LARRATE Nº 626 - NAVARRA
JADO GADIA OCTANE/GRANJA JADO GTRREZ,S C - CANTABRIA
JARDIN ME INTREPID INTREPID/JARDÍN MENDIZABAL S L - ÁLAVA
JM CORRAL GOLAN SANTA/EL CORRAL - VIZCAYA
KATARAN S BRAWLER 590-BRAWL/KATARAN, S C - ÁLAVA
KATARAN S IMPRESSIO 581-IMPRE/KATARAN, S C - ÁLAVA
KATARAN S KRUSADER 634-KRUSA/KATARAN, S C - ÁLAVA
KATARAN S NUMERO UN 646-N UNO/KATARAN S C - ÁLAVA
KATTABURU DEDUCTIVE OSKIA/S C KATTABURU - NAVARRA
KATTABURU JETT AIR ARIADNA/S C KATTABURU - NAVARRA
KATTABURU MCCUTCHEN LIBRE/S C KATTABURU - NAVARRA
KATTABURU MCCUTCHEN NELY/S C KATTABURU - NAVARRA
KATTABURU SEAVER JUNE/S C KATTABURU - NAVARRA
LACTEOS B FEVER 533/LACTEOS BORDATXO,S L - GUIPÚZCOA
LAISU CONTRAST BETIZU/LAISU, C B - VIZCAYA
LANDA GAM BEEMER/LANDA GAMBOA, S L - ÁLAVA
LANDA GAM DOORMAN/LANDA GAMBOA, S L - ÁLAVA
LANDA GAM EPIC/LANDA GAMBOA, S L - ÁLAVA
LANDA GAM FACEBOOK/LANDA GAMBOA, S L - ÁLAVA
LANDA GAM MERIDIAN/LANDA GAMBOA S L - ÁLAVA
LARRATE BRADNICK MAREN/S A T LARRATE Nº 626 - NAVARRA
LARREA S LET IT SN 606 JAENA/LARREA S C - ÁLAVA
LARREA S WICKHAM 599 IBERI/LARREA S C - ÁLAVA
LAVENTA BUFALO 5782/S C ENRIQUE ARIZA Y SOLA ROMANOS M - NAVARRA
LAVENTA PICK-UP 5796/S C ENRIQUE ARIZA Y SOLA ROMANOS M - NAVARRA
LAZCOZ PICK-UP 1156/S A T LAZCOZ - NAVARRA
LENGUSUEK DELTA AGURNE/S A T LENGUSUEK Nº 356 - NAVARRA
LENGUSUEK DELTA ILBETE/S A T LENGUSUEK Nº 356 - NAVARRA
LENGUSUEK DELTA KATTAZURI/S A T LENGUSUEK Nº 356 - NAVARRA
LENGUSUEK DELTA KORRIKA/S A T LENGUSUEK Nº 356 - NAVARRA
LENGUSUEK DELTA KOXKORRA/S A T LENGUSUEK Nº 356 - NAVARRA
LENGUSUEK DELTA LOREA/S A T LENGUSUEK Nº 356 - NAVARRA
LENGUSUEK DELTA TXIRRITA/S A T LENGUSUEK Nº 356 - NAVARRA
LENGUSUEK DORN IZOTZA/S A T LENGUSUEK Nº 356 - NAVARRA
LEO 121/LA MARNIA S C - CANTABRIA
LICORNE 8313/S A T OLAGORRIA Nº 660-NA - NAVARRA
LIMONADE/S A T OLAGORRIA Nº 660-NA - NAVARRA
LOLA/SOMAPANDO S C - CANTABRIA
LOS TEJOS ANCHOR MARI/LOS TEJOS C B - VIZCAYA
LOS TEJOS DEFENDER GIJI/LOS TEJOS, C B - VIZCAYA
LOS TEJOS DEFENDER NANIFE/LOS TEJOS, C B - VIZCAYA
LOS TEJOS DENVER 14 ROCKVER/LOS TEJOS, C B - VIZCAYA
LOS TEJOS MCCUTCHEN NICUT/LOS TEJOS, C B - VIZCAYA
LOS TEJOS SPUR JISASP/LOS TEJOS, C B - VIZCAYA
LOS TEJOS WICKHAM ELEGAHAM/LOS TEJOS, C B - VIZCAYA
MADI WICKHAM 989/MAS MADIROLES - BARCELONA
MARIBEL DOUGLAS OLIMPIA/MARIBEL - VIZCAYA
MARIBEL MOSTAR LIDIA/MARIBEL - VIZCAYA
MARTI SAKUM 16/CAL CUSI - GIRONA
MAZUECO PEÑISCOLA IMPRESSION/MAZUECO S C - CANTABRIA
MENDIBURU SAKUM 587/S C MENDIBURU - NAVARRA
MONTARIBE CEO EVA/UNIÓN MONTARIBE, S C A - NAVARRA
MONTARIBE DELTA LORRIE/UNIÓN MONTARIBE, S C A - NAVARRA
MONTARIBE MAXIMUS MADOTZ/UNIÓN MONTARIBE, S C A - NAVARRA
MONTARIBE MAXIMUS MENDIL/UNIÓN MONTARIBE, S C A - NAVARRA
MONTARIBE PAYTON GALDEANO/UNIÓN MONTARIBE, S C A - NAVARRA
MONTARIBE WICKHAM GREZ/UNIÓN MONTARIBE, S C A - NAVARRA
MONTERRONDO ROMEO CHENOA/EL PANDIELLO - ASTURIAS
MURRIETA ATWOOD NALA/MURRIETA - VIZCAYA
MURRIETA DUDE VALIRA/MURRIETA - VIZCAYA
MURUCUC MINA LONGTIME SNOW/EL MURUCUC S L - BARCELONA
MURUCUC PUIGCENDRA JORDAN SPUR/EL MURUCUC S L - BARCELONA
NIEVES DOORMAN NALA/LAS NIEVES S C - CANTABRIA
ONDARTZA DOORMAN 3611/ONDARTZA BITARTE SC - GUIPÚZCOA
ONDARTZA MCCUTCHEN 3602/ONDARTZA BITARTE SC - GUIPÚZCOA
ONDAZARTE BRADY PLUTO/ONDAZARTE GAIN,S L - GUIPÚZCOA
ONDAZARTE MERIDIAN OIHU/ONDAZARTE GAIN,S L - GUIPÚZCOA
PANADERO OLI LUCIO/LA PARAYA, S C - CANTABRIA
PEDREGAL ARGUERO YASMIN/EL PEDREGAL, S C - ASTURIAS
PEDREGAL MR METAL GEMMA/EL PEDREGAL, S C - ASTURIAS
PEÑAGEMIL BLISS GILLESPY/GANADERÍA PEÑAGEMIL - CANTABRIA
PINELLA MURDOCK 459/AGROPECUARIA SERRA - NOGUER SCP - GIRONA
PINOS COSILA METEOR/EL PINOS NOU - BARCELONA
PINOS IRMA SUPERPOWER/EL PINOS NOU - BARCELONA
PINOS LENI DELTA/EL PINOS NOU - BARCELONA
PINOS MAITE KIAN/EL PINOS NOU - BARCELONA
PINOS TIPENA SPUR/EL PINOS NOU - BARCELONA
PINOS XULITA DELTA/EL PINOS NOU - BARCELONA
PLANILLO BUXTON OLATZ/PLANILLO HOLSTEIN - NAVARRA
PLANILLO MASCALESE MONEGRA 2/PLANILLO HOLSTEIN - NAVARRA
PLANILLO MCCUTCHEN NEVADA/PLANILLO HOLSTEIN - NAVARRA
POU FLOR MARDI GRAS/CAN POU - GIRONA
POU INVESTIDURA PICARDUS/CAN POU - GIRONA
POU NIAGARA DEMAN/CAN POU - GIRONA
POYU SC ATWOOD KAZOIE/POIU BASERRIA S C - VIZCAYA
POYU SC SEAVER ARO/POIU BASERRIA S C - VIZCAYA
POYU SC SNOWY RIKU/POIU BASERRIA S C - VIZCAYA
74 Frisona Española 226 j/a (Pasa pág 76)
Las cosas importantes son las que se hacen con el corazón




En NUTRICOR trabajamos para ti mirando hacia el futuro
Veterinarios y nutricionistas expertos en rumiantes
www.nutricor.es
cr3ativa.com
POYU SC WICKHAM SOLLUBE/POIU BASERRIA, S C - VIZCAYA
PRAT DELTA TERESA/S PRAT PRAT C F - NAVARRA
PRAT MCCUTCHEN 851/S PRAT PRAT C F - NAVARRA
PRAT MCCUTCHEN 860/S PRAT PRAT C F - NAVARRA
PRAT MCCUTCHEN 861/S PRAT PRAT C F - NAVARRA
PRAT WICKHAM 868/S PRAT PRAT C F - NAVARRA
QUINTANA DANAEE 3 BRADY/MURRIETA - VIZCAYA
RAMORENA CASHCOIN IRINA/SCDAD COOP LTDA RAMORENA - NAVARRA
REDIN ATWOOD 2978/BARBERENA ECHARRI Y REDIN - NAVARRA
REDIN DELTA 2980/BARBERENA ECHARRI Y REDIN - NAVARRA
REDIN SPEAKER 4325/S A T SANZ ANCIN - NAVARRA
REGUERA MOJITO COQUETA/CASTIELLO - ASTURIAS
RESSOL GENEVA 1103/LA ROCA - BARCELONA
RIBATXENT TRIGGER ESTRELLA/RIBATXENTA S L - ÁLAVA
RIERA 723/S A T SERRA COLOMER 635 CAT - BARCELONA
ROQUET CHASE 2025/RAMADERIA ROQUET, S C P - LLEIDA
ROQUET GILLESPY 1974/RAMADERIA ROQUET, S C P - LLEIDA
RUCABAO PICK-UP DENISSE/RUCABAO - VIZCAYA
S.A.T. ET ASTRAKAN ETXALDE A/S A T ETXALDE - ÁLAVA
S A T ET BIARRIZ BIARRIZ/HNOS GUTIÉRREZ MADRAZO S C - CANTABRIA
S A T ET PORTU ETXALDE 6/S A T ETXALDE - ÁLAVA
SAINZ-AJA GILLESPY 349/S C MADRAZO R J Y SAINZ AJA TRUEBA - NAVARRA
SAIRETA CEO ROMEVA/LA SAIRETA S C P - LLEIDA
SAIRETA IMPRESSION ELVIRA/LA SAIRETA S C P - LLEIDA
SAIRETA LOVERMAN JAUMETA/LA SAIRETA, S C P - LLEIDA
SALBIDE B MOGUL 8234/SALBIDE Baserria - GUIPÚZCOA
SALSAMEND SUDOKU 7158/SALSAMENDI Baserria - GUIPÚZCOA
SANCIDES WICKHAM ALAVA/SANCIDES - VIZCAYA
SANJOSE DRAMA MANIFOLD/GRANJA SAN JOSÉ S A - HUESCA
SANJOSE MOGUL TRIGGER/GRANJA SAN JOSÉ S A - HUESCA
SANJOSE SUPERSIRE SUPER/GRANJA SAN JOSÉ S A - HUESCA
SANT JORDI 1592 GEAR 1150/SANT JORDI DESVALLS SAT - GIRONA
SANT MER 4870 CHALLENGE 5749/S A T SANT MER 1916 - GIRONA
SANTAISABEL BETIC UVA/S A T GRANJA SANTA ISABEL Nº - NAVARRA
SARGAITZ BEEMER 524/S A T GARBIÑE Nº 6353 - NAVARRA
SARGAITZ MCCUTCHEN 502/S A T GARBIÑE Nº 6353 - NAVARRA
SARGAITZ MOGUL 514/BORDA ZAHAR Baserria-ALZA - GUIPÚZCOA
SERJA BARBARA JORDANO/GANADERÍA CARRILES, S L - CANTABRIA
SERJA LUCERA GAMEDAY/GANADERÍA CARRILES, S L - CANTABRIA
SOLAPEÑA ENDURE SARA/SOLAPEÑA - VIZCAYA
SOMALERA CELTA XACOBEO/S A T SOMALERA Nº 39090 - CANTABRIA
SOMALERA FINAL BEHOBIA/S A T SOMALERA Nº 39090 - CANTABRIA
SOMALERA LANZA COPERNICUS/S A T SOMALERA Nº 39090 - CANTABRIA
SOMALERA MOLY 5G/S A T SOMALERA Nº 39090 - CANTABRIA
SOMALERA SISKA GOLDEN DREAMS/S A T SOMALERA Nº 39090 - CANTABRIA
SOMOBOO ALTAMIRA ATWOOD ET/SOMOBOO - CANTABRIA
SOMOBOO DANA NUMERO UNO/SOMOBOO - CANTABRIA
SOMOBOO REINA TRUENO/SOMOBOO - CANTABRIA
SWPER 123/LA MARNIA S C - CANTABRIA
THIO GAMBLER XIRUCA 904/CAN THIO DE BAIX (EFA AYMERICH S C P - GIRONA
TRAVESÍA BOMBERO DESI/S A T LA TRAVESÍA 896 - NAVARRA
TRAVESÍA BOMBERO TROYA/S A T LA TRAVESÍA 896 - NAVARRA
TRAVESÍA LIONEL PARIS/S A T LA TRAVESÍA 896 - NAVARRA
TRAVESÍA MONTROSS GUADALUPE/S A T LA TRAVESÍA 896 - NAVARRA
TRAVESÍA MONTROSS WHITE/S A T LA TRAVESÍA 896 - NAVARRA
TRAVESÍA MYSPACE PAOLA/S A T LA TRAVESÍA 896 - NAVARRA
TRAVESÍA PULSAR MATRIX/S A T LA TRAVESÍA 896 - NAVARRA
TRAVESÍA PULSAR NELI/S A T LA TRAVESÍA 896 - NAVARRA
TRAVESÍA SPEAKER MIMO/S A T LA TRAVESÍA 896 - NAVARRA
TRAVESÍA WICKHAM CLARA/S A T LA TRAVESÍA 896 - NAVARRA
TRAVESÍA WICKHAM MAYA/S A T LA TRAVESÍA 896 - NAVARRA
TRAVESÍA WICKHAM MUFI/S A T LA TRAVESÍA 896 - NAVARRA
TRAVESÍA WICKHAM TEXAS/S A T LA TRAVESÍA 896 - NAVARRA
TRAVESÍA WICKHAM TINA/S A T LA TRAVESÍA 896 - NAVARRA
TRAVESÍA WICKHAM TURRON/S A T LA TRAVESÍA 896 - NAVARRA
TRESVALLES STEADY ARACELI/GARCÍA DEL BUSTO, S C - ASTURIAS
VALVA/LA LOMBA, S C - CANTABRIA
VEARES CARLOTA BRAWLER/GANADERÍA VEARES - CANTABRIA
VILATORTELLA 3436 FACEBOOK/S A T VILATORTELLA 544 CAT - BARCELONA
VILATORTELLA 3448 PULSAR/S A T VILATORTELLA 544 CAT - BARCELONA
VILATORTELLA 3514 ELUDE/TAUSTE GANADERA S A - ZARAGOZA
VILATORTELLA 3520 ELUDE/S A T VILATORTELLA 544 CAT - BARCELONA
VILATORTELLA 3521 KIAN/TAUSTE GANADERA S A - ZARAGOZA
VILATORTELLA 3535 ELUDE/S A T VILATORTELLA 544 CAT - BARCELONA
VILATORTELLA 3546 ELUDE/S A T VILATORTELLA 544 CAT - BARCELONA
VILLANUEVA ALMUDENA X-ASTERIX/GANADERÍA VILLANUEVA, S C - ASTURIAS
VILLANUEVA EBOLA X-SNOWFALL/GANADERÍA VILLANUEVA, S C - ASTURIAS
VILLANUEVA PATRY MR METAL/GANADERÍA VILLANUEVA, S C - ASTURIAS
VILLASIERRA 1220 WICKHAM/S A T 2038 VILLASIERRA - ZARAGOZA
VILLASIERRA 1251 MAXIMO/S A T 2038 VILLASIERRA - ZARAGOZA
VIÑA ATWOOD BARONICA/CASA VIÑA, S C - ASTURIAS
VIÑA BRENDY AINOA/CASA VIÑA, S C - ASTURIAS
VIÑA DOORMAN NELY/CASA VIÑA S C - ASTURIAS
VIÑA DOORMAN PEA/CASA VIÑA S C - ASTURIAS
VIÑA HVEZDA SUA/CASA VIÑA S C - ASTURIAS
YANGOA FACEBOOK 9035/S A T YANGOA Nº 638 NA - NAVARRA
ZABAL ERR DOORMAN 6088/ZABAL ERREKONDO S C - GUIPÚZCOA
ZABAL ERR FEVER 5087/ZABAL ERREKONDO S C - GUIPÚZCOA
ZALDUBITX BLAKE ZALDUBITX/ZALDUBITXI,S COOP PEQUEÑA - ÁLAVA
ZALDUBITX DEFENDER ZALDUBITZ/ZALDUBITXI,S COOP PEQUEÑA - ÁLAVA
ZALDUBITX ESCALADE ZALDUBITZ/ZALDUBITXI,S COOP PEQUEÑA - ÁLAVA
ZALDUBITX MAXIMUS ZALDUBITX/ZALDUBITXI,S COOP PEQUEÑA - ÁLAVA
ZALDUBITX MAXIMUS ZALDUBITX/ZALDUBITXI,S COOP PEQUEÑA - ÁLAVA
ZALDUBITX SMURF ZALDUBITX/ZALDUBITXI,S COOP PEQUEÑA - ÁLAVA
ZAZPE EXPLODE GOIURI 203/ANDRES ZAZPE - NAVARRA
ZIGA ESTATE 4190/S C ZIGA - NAVARRA
ZIGA MCCUTCHEN 4193/S C ZIGA - NAVARRA HEMBRAS MB DE 2º PAR TO - 89 PUNTOS
ARCE DELETE GLADIA/S A T ARCE III - CANTABRIA
BIDARTE TIMELUX INESTA/BIDARTE Baserria - GUIPÚZCOA
C NUEVA SHOTTLE JAWVA ET/C NUEVA - VIZCAYA
LENGUSUEK FEVER OIHANA/S A T LENGUSUEK Nº 356 - NAVARRA
LOS TEJOS MILLION KASI/LOS TEJOS C B - VIZCAYA
PINOS TRITA MERIDIAN/EL PINOS NOU - BARCELONA
PLANILLO LAUTHORITY LEIRE/PLANILLO HOLSTEIN - NAVARRA
RIBATXENT FEVER BRANDY/RIBATXENTA S L - ÁLAVA
TRAVESÍA JORDAN CLARA/S A T LA TRAVESÍA 896 - NAVARRA
HEMBRAS MB DE 2º PAR TO - 88 PUNTOS
01130/AGROPECUARIA QUATRE VENTS,SL - GIRONA
234 BEACON 4222/MAS PUIG - GIRONA
30 FRADERA 483 GABOR/MAS FRADERA - GIRONA
BEDOLLO VERA BLADE/GANADERÍA BEDOLLO, S C - CANTABRIA
BEHI-ALDE STREET 6338/COOPERATIVA BEHI-ALDE - ÁLAVA
CAMPGRAN ALANA DELTA/EXP PECUARIAS COVE S L (EL CAMPGRAN) - BARCELONA
COOP LAG BOTIN L K BOTI/COOP LAGUNAK - ÁLAVA
EL SOLAR GUAPA ATWOOD/EL SOLAR - CANTABRIA
EL CAMPO LEZAMA CHANEL/EL CAMPO - VIZCAYA
FELE SNOWFALL CASANDRA/GANADERÍA FELE, S C - ASTURIAS
GARBIÑE EPIC 553/S A T GARBIÑE Nº 6353 - NAVARRA
HERBARFER ALEXANDER CORAL/HERBARFER - VIZCAYA
JM LIESL GAVOR/JMD ALLUE S L - LLEIDA
KATTABURU EXPLODE 3607/S C KATTABURU - NAVARRA
LA RIA CHAPARRA MANIFOLD/LA RÍA - CANTABRIA
LA RIA VERA FEVER/LA RÍA - CANTABRIA
LANDA GAM BRAWLER/LANDA GAMBOA, S L - ÁLAVA
LANDA GAM LAVANGUAR/LANDA GAMBOA S L - ÁLAVA
LANDA GAM LAVANGUAR/LANDA GAMBOA S L - ÁLAVA
LANDETXE PICK-UP/LANDETXE S C - ÁLAVA
LENGUSUEK DELTA SENDOA/S A T LENGUSUEK Nº 356 - NAVARRA
LENGUSUEK EXPLODE LABAINA/S A T LENGUSUEK Nº 356 - NAVARRA
LENGUSUEK EXPLODE SARIA/S A T LENGUSUEK Nº 356 - NAVARRA
LOS TEJOS DELETE DELICIOSA/LOS TEJOS, C B - VIZCAYA
LOS TEJOS DELETE TRUDE/LOS TEJOS C B - VIZCAYA
LOS TEJOS DEMPSEY BER/LOS TEJOS C B - VIZCAYA
LOS TEJOS TIME TAMARA/LOS TEJOS C B - VIZCAYA
MURRIETA SANCHEZ LASAI/MURRIETA - VIZCAYA
ONDAZARTE WINDBROOK DIADA/ONDAZARTE GAIN,S L - GUIPÚZCOA
PANADERO FLO BRADNICK/LA PARAYA, S C - CANTABRIA
PLANILLO FEVER LUCILDA/PLANILLO HOLSTEIN - NAVARRA
PLANILLO LAUTHORITY XYLVENIA/PLANILLO HOLSTEIN - NAVARRA
PLANILLO SHOTTLE GIOCONDA-ET/PLANILLO HOLSTEIN - NAVARRA
PLANILLO SID SIRI/PLANILLO HOLSTEIN - NAVARRA
ROQUET AFTERSHOCK 1611/RAMADERIA ROQUET, S C P - LLEIDA
SANJOSE MAXUM DECKER/GRANJA SAN JOSÉ S A - HUESCA
SANJOSE SUPER TOYSTORY/GRANJA SAN JOSÉ S A - HUESCA
SOLAPEÑA STEADY AROA/SOLAPEÑA - VIZCAYA
SOMALERA CATALINA DOORMAN/S A T SOMALERA Nº 39090 - CANTABRIA
SOMALERA DELETA DELETE/S A T SOMALERA Nº 39090 - CANTABRIA
SOMALERA LUNA XACOBEO/S A T SOMALERA Nº 39090 - CANTABRIA
SOMOBOO ENRICA CHELIOS/SOMOBOO - CANTABRIA
TRAVESÍA CHELIOS KENIA/S A T LA TRAVESÍA 896 - NAVARRA
TRAVESÍA DEDUCTIVE KIRA/S A T LA TRAVESÍA 896 - NAVARRA
TRAVESÍA HUNGER PUNKY/S A T LA TRAVESÍA 896 - NAVARRA
TRAVESÍA MERIDIAN TOMASA/S A T LA TRAVESÍA 896 - NAVARRA
VALIENTE ATWOOD JIMENA/SOMOBOO - CANTABRIA
VILLASIERRA 1182 GERARD/S A T 2038 VILLASIERRA - ZARAGOZA
ZALDUBITX IMPRESSIO ZALDUBITX/ZALDUBITXI,S COOP PEQUEÑA - ÁLAVA
ZALDUBITX LAUTHORIT ZALDUBITX/ZALDUBITXI,S COOP PEQUEÑA - ÁLAVA
HEMBRAS MB DE 2º PAR TO - 87 PUNTOS
03982249/ZALDUBITXI S COOP PEQUEÑA - ÁLAVA
1166/AGROPECUARIA QUATRE VENTS,SL - GIRONA
1234 JJ PAZ MANIFOLD/PAULORENA HOLSTEIN,S L - LLEIDA
1460 SPIRTE/S A T DISAMA Nº 39014 - CANTABRIA
615 EFA AYMERICH 426 CHICAGO/CAN THIO DE BAIX -EFA AYMERICH S C P - GIRONA
ALBA EMY PLANET/TAUSTE GANADERA S A - ZARAGOZA
ALBA PINTA FEVER/TAUSTE GANADERA S A - ZARAGOZA
AORMI AURORA 5101 LAUTHORITY/AORMI - CANTABRIA
AORMI CAILDA BRADNICK/AORMI - CANTABRIA
AORMI ESTHER METEOR 5669/AORMI - CANTABRIA
AR MOLINO FEVER ASONA/EL MOLINO, S C - VIZCAYA
AR MOLINO STANLEYCU ARAOTZ/EL MOLINO S C - VIZCAYA
ARAE 913 628 MARINO/SAT 3024 ALT EMPORDÀ 3648 CAT - GIRONA
ARDEO BALTIMOR 1136/C B MIREN ARDEO Y OTROS - VIZCAYA
AYMERICH 602 TRUMP 435/MAS CIURANA - GIRONA
BARCA PEDRO NIEBLA/LA BARCA, S C - ASTURIAS
BATZABALEA GULF ANGELES/S A T MENDICOA - NAVARRA
BEDOLLO CHARI SHOTTLE/GANADERÍA BEDOLLO, S C - CANTABRIA
BEDOLLO DANIELA DANCER/GANADERÍA BEDOLLO S C - CANTABRIA
BEDOLLO NOELIA GOLD CHIP/GANADERÍA BEDOLLO S C - CANTABRIA
BEHI-ALDE BONFIRE 6535/COOPERATIVA BEHI-ALDE - ÁLAVA
BEHI-ALDE HILARI 6588/COOPERATIVA BEHI-ALDE - ÁLAVA
BEHI-ALDE OSAKA 5937/COOPERATIVA BEHI-ALDE - ÁLAVA
BERBIARAN JERRICK 499/F JAVIER ANDUEZA SANZ DE GALDEANO - NAVARRA
BERBIARAN JERRICK 807/F JAVIER ANDUEZA SANZ DE GALDEANO - NAVARRA
BERNABE KNOWLEDGE PATRI/GANADERÍA BERNABE S C - ASTURIAS
C NUEVA LAUTHORIT WENDY/C NUEVA - VIZCAYA
CALSECA ADRIANA HEFTY/CALSECA - CANTABRIA
CAMPGRAN AMELIE MERIDIAN/EXP PECUARIAS COVE,S L (EL CAMPGRAN) - BARCELONA
CASABLANCA HILL MARA/S A T CASABLANCA - CANTABRIA
CASABLANCA MAGISTRATE ROMULA/S A T CASABLANCA - CANTABRIA
COMAS NOVAS DILARA DELTA/EXP PECUARIAS COVE S L (EL CAMPGRAN) - BARCELONA
COOP LAG DORCY L K -DORC/COOP LAGUNAK - ÁLAVA
CRUZ LEZAMA DEBORA MEGAGENIO/S A T CRUZ LEZAMA 39120 - CANTABRIA
CRUZ LEZAMA VILMA XACOBEO/S A T CRUZ LEZAMA 39120 - CANTABRIA
CRUZ LEZAMA YAKELIN EMMETT/S A T CRUZ LEZAMA 39120 - CANTABRIA
DENDARIÑE FEVER ZUHURRA/DENDARIÑE-BARRI - VIZCAYA
EL CIERRO ANGELA WILDMAN/EL CIERRO - CANTABRIA
ESPINELA SPIRTE LORENA/GRANJA JADO GTRREZ S C - CANTABRIA
ESTAKUA TALENT DORLETATX/ESTAKUA - VIZCAYA
FONTANA ABSOLUTE FONT ROCA/FONTFERRI S C P - BARCELONA
G P FEVER 574/GRANJA PUIGPINOS - LLEIDA
G P XACOBEO 500/GRANJA PUIGPINOS - LLEIDA
GENER EPIC 1170 ET/MAS GENER S C P - GIRONA
GENER JEEVES ASHLEY-ET 1011 ET/MAS GENER S C P - GIRONA
GUEMBE WILLROCK 8768/JORGE GUEMBE RODRIGUEZ - NAVARRA
HARMONIE/GRANJA JADO GTRREZ S C - CANTABRIA
HERBARFER TIMBER TUNA/HERBARFER - VIZCAYA
HOLSCAT MERIDIAN ROXY ET/EXP PECUARIAS COVE,S L (EL CAMPGRAN) - BARCELONA
JM KRUSADER TOYSTORY/JMD ALLUE, S L - LLEIDA
JM MERIDIAN LIESL/JMD ALLUE S L - LLEIDA
JM TOYSTORY BOND/JMD ALLUE S L - LLEIDA
JOGU HEFTY 4943/S A T JOGU N 8293 - CANTABRIA
JOLEN DE L'ORANGERIE/EXP PECUARIAS COVE S L (EL CAMPGRAN) - BARCELONA
KATTABURU GABOR ALAINE/S C KATTABURU - NAVARRA
KATTABURU GABOR DORISA/S C KATTABURU - NAVARRA
LACTEOS B WINDBROOK 1439/LACTEOS BORDATXO,S L - GUIPÚZCOA
LANDA GAM DOORMAN/LANDA GAMBOA S L - ÁLAVA
LARRATE FEVER SEANBE/S A T LARRATE Nº 626 - NAVARRA
76 Frisona Española 226 j/a
LARREA S DUPLEX GANEKA/LARREA S C - ÁLAVA
LARREA SC SPIRTE/LARREA S C - ÁLAVA
LAVENTA GABOR 14/S C ENRIQUE ARIZA Y SOLA ROMANOS M - NAVARRA
LENGUSUEK DELTA ELURRE/S A T LENGUSUEK Nº 356 - NAVARRA
LENGUSUEK SECURE RED KATTALIN/S A T LENGUSUEK Nº 356 - NAVARRA
LOLA/S A T SIERRA VILLA N 39155 - CANTABRIA
MIJARES SABRINA WINDBROOK/LOS MIJARES - CANTABRIA
MONTARIBE BRAWLER AGETE/UNIÓN MONTARIBE S C A - NAVARRA
MONTARIBE BRAWLER BARIAIN/UNIÓN MONTARIBE S C A - NAVARRA
MONTARIBE FEVER IDOCIN/UNIÓN MONTARIBE S C A - NAVARRA
MONTARIBE FEVER VARDONES/UNIÓN MONTARIBE S C A - NAVARRA
MONTARIBE WINDHAMMER AXOA/UNIÓN MONTARIBE, S C A - NAVARRA
MURRIETA ATWOOD NAVIDAD/MURRIETA - VIZCAYA
NOZALIN ROSALIN SID/NOZALIN - ASTURIAS
ONDARTZA CONTROL 9910/ONDARTZA BITARTE SC - GUIPÚZCOA
PANADERO RADENTIS BRADNICK/LA PARAYA, S C - CANTABRIA
PLANILLO BALTIMOR COMILONA/PLANILLO HOLSTEIN - NAVARRA
PLANILLO FEVER CECILIA/PLANILLO HOLSTEIN - NAVARRA
PONDEROSA WINDBROOK FILADA ET/GANADERÍA INCLAN S C - ASTURIAS
POU LLENGUETA WINDBROOK/CAN POU - GIRONA
Q924/AGROPECUARIA QUATRE VENTS SL - GIRONA
ROQUET AFTERSHOCK 1646/RAMADERIA ROQUET S C P - LLEIDA
S A T ET BITACORA ETXA-BITA/S A T ETXALDE - ÁLAVA
SAINZ-AJA IMPRESSION 309/S C MADRAZO R J Y SAINZ AJA TRUEBA - NAVARRA
SANJOSE MOGUL JORDAN/GRANJA SAN JOSÉ S A - HUESCA
SANJOSE NUMERO UNO TOYSTORY/GRANJA SAN JOSÉ S A - HUESCA
SANT MER CLARA GOLDSUN 4410/S A T SANT MER 1916 - GIRONA
SANT MER OLIGO BRADY 4490/S A T SANT MER 1916 - GIRONA
SARGAITZ METEOR 425/BIDARTE Baserria - GUIPÚZCOA
SOMOBOO STORMI SPIRTE/SOMOBOO - CANTABRIA
TRAVESÍA CHELIOS JULIA/S A T LA TRAVESÍA 896 - NAVARRA
TRAVESÍA SALOON ANTONELA/S A T LA TRAVESÍA 896 - NAVARRA
TRAVESÍA SMURF BETY/S A T LA TRAVESÍA 896 - NAVARRA
URRUELA S BIARRIZ/URRUELA, S C - ÁLAVA
UZQUIANO- FEVER UZKIANO 3/ZALDUBITXI,S COOP PEQUEÑA - ÁLAVA
UZQUIANO- SPECTRUM UZQUIANO-/ZALDUBITXI,S COOP PEQUEÑA - ÁLAVA
VILATORTELLA 3402 DEDUCTIVE/S A T VILATORTELLA 544 CAT - BARCELONA
VILLASIERRA 1036 JORDAN/S A T 2038 VILLASIERRA - ZARAGOZA
VILLASIERRA 1156 JETT AIR/S A T 2038 VILLASIERRA - ZARAGOZA
VIÑA YORICK SARA/CASA VIÑA S C - ASTURIAS
ZABAL ERR LAUTHORIT 0115/ZABAL ERREKONDO S C - GUIPÚZCOA
ZABAL ERR SUDAN 0038/ZABAL ERREKONDO S C - GUIPÚZCOA
ZC SANTI 1516/S A T NA 677 Z C - NAVARRA
ZIGA SEAVER 0151/S C ZIGA - NAVARRA
HEMBRAS MB DE 2º PAR TO - 86 PUNTOS
03878995/S C MADRAZO R J Y SAINZ AJA TRUEBA - NAVARRA
1162/AGROPECUARIA QUATRE VENTS,SL - GIRONA
1288 JJ SILVIA MANIFOLD/PAULORENA HOLSTEIN,S L - LLEIDA
2324 BES PHOENIX 1777/AGROPECUARIA MAS BES, S L - GIRONA
236/MAS MOLI DEL PERER S C - GIRONA
2790 BES SHOPPING 1876/AGROPECUARIA MAS BES S L - GIRONA
2830 BUTZE/S A T M LAVIN-LOREDO - CANTABRIA
353 RASET ISIDORA MOGUL/CAN RASET S C - GIRONA
504 GERARD 303/MAS PUIG - GIRONA
693 DURAN BUCKEYE FAX/MAS GELAT VELL S L - GIRONA
8591 JETT AIR/S A T M LAVIN-LOREDO - CANTABRIA
ACEBO DOLORES PICK-UP/S A T ACEBO CORRALES 8252 - CANTABRIA
AGIRRESOR IMPRESSIO 5274/AGIRRESOROAUNDI,S C - GUIPÚZCOA
ALBA BARBERA JORDAN/TAUSTE GANADERA S A - ZARAGOZA
ALBA COQUETA TOPSIDE/TAUSTE GANADERA S A - ZARAGOZA
ALBA SAMANTALIN JETSET/TAUSTE GANADERA S A - ZARAGOZA
ALBA TRAMPOSA SOCRATES/TAUSTE GANADERA S A - ZARAGOZA
ALDAPA BAKOMBRE 1367/S C-L- ALDAPA - NAVARRA
ALDAPA BAKOMBRE 1388/S C-L- ALDAPA - NAVARRA
ANA/S A T GANADERÍA HERGU - CANTABRIA
ANDALORREA EXPLODE 1010/S A T ANDALORREA Nº 4322 - NAVARRA
ANDALORREA EXPLODE 1033/S A T ANDALORREA Nº 4322 - NAVARRA
ANDIKOETX SUDOKU RITA/ANDIKOETXALDE, S C - ÁLAVA
AORMI LUISIANA WINDBROOK/AORMI - CANTABRIA
AORMI MATEA IMPRESSION/AORMI - CANTABRIA
ARCE AVALON TERRY/S A T ARCE III - CANTABRIA
ARCE DOORMAN ANKE/S A T ARCE III - CANTABRIA
ARCE DOORMAN GRACIAS/S A T ARCE III - CANTABRIA
ARCE DOORMAN RITA/S A T ARCE III - CANTABRIA
ARCE EXACTER ROSA/S A T ARCE III - CANTABRIA
ARCE GILLESPY RITA/S A T ARCE III - CANTABRIA
ARCE JORDAN LUNA/S A T ARCE III - CANTABRIA
ARCE SHOTTLE BIRGIT/S A T ARCE III - CANTABRIA
ARDEO FEVER 1250/C B MIREN ARDEO Y OTROS - VIZCAYA
ARDEO GARMIN 1252/C B MIREN ARDEO Y OTROS - VIZCAYA
ARMONTIN JADO DOORMAN/GANADERÍA ARMONTIN, S C - CANTABRIA
ARRAMENDI SANDOKAN 6782/ARRAMENDI Baserria APDO 50 - GUIPÚZCOA
ASI JOHN/SAN PEDRO - CANTABRIA
BARRINA HILL 1192/AGROPECUARIA CAN BARRINA, S L - BARCELONA
BATLLORI 739 STEADY/E A P BATLLORI S C - GIRONA
BAUTISTA PEDRO MELISSA/CASA BAUTISTA - ASTURIAS
BEHI-ALDE LEXUS 6608/COOPERATIVA BEHI-ALDE - ÁLAVA
BEHI-ALDE PICK-UP 6285/COOPERATIVA BEHI-ALDE - ÁLAVA
BEHI-ALDE SAKUM 6637/COOPERATIVA BEHI-ALDE - ÁLAVA
BERBIARAN PAROCAS 58/F JAVIER ANDUEZA SANZ DE GALDEANO - NAVARRA
BEREKOTXEA GOSPELL 5528/S C HNOS IRIGOYEN AGUIRRE - NAVARRA
BRADNICK 919/HNOS VALLEJO JIMÉNEZ, C B - SORIA
BRIGIDA/S A T GANADERÍA HERGU - CANTABRIA
CACHON PINTA PICARD/CASA CACHÓN,S C - ASTURIAS
CAMPGRAN DORIAN MCCUTCHEN/EXP PECUARIAS COVE,S L (EL CAMPGRAN)-BARCELONA
CAMPGRAN TETRA CARSON/EXP PECUARIAS COVE S L (EL CAMPGRAN) - BARCELONA
CAPRI 3689 CASHMERE/CAPRI - CANTABRIA
CAVALLERIA JORDAN MARBRE/MAS LA CAVALLERIA - BARCELONA
CAVALLERIA MERIDIAN XAPA/MAS LA CAVALLERIA - BARCELONA
COBOCOSTA ONTARIO 3750/HERMANOS COBO COSTA - NAVARRA
COBOSO CRISTINA GABLES/GANADERÍA CARRILES S L - CANTABRIA
COOP LAG SUDAN L K -SUDA/COOP LAGUNAK - ÁLAVA
CRUZ LEZAMA CAMILA FEVER/S A T CRUZ LEZAMA 39120 - CANTABRIA
CRUZ LEZAMA GIANNA GILLESPY/S A T CRUZ LEZAMA 39120 - CANTABRIA
CRUZ LEZAMA NOA JETT AIR/S A T CRUZ LEZAMA 39120 - CANTABRIA
CUBANA ROCKY/LA LOMBA, S C - CANTABRIA
DANIELA STRUIK/LA RIGADA - VIZCAYA
DAVID ESC CONTROL 563 CONTR/DAVID ESKUZA ARBAIZA - ÁLAVA
EDESA MANHATTAN GOLD CHIP/GRANJA LA FUENTE S C - CANTABRIA
EL REY PALOMA BOLTON/S A T COGU-EL REY - CANTABRIA

j/a 226 Frisona Española 77
EL SOLAR CARPINTERA CASTREÑO/LAISU, C B - VIZCAYA
EL CAMPO CHELIOS SHERPA/EL CAMPO - VIZCAYA
EL HAYA HAMPTON ARABIA/EL HAYA MATIENZO, C B - VIZCAYA
EROLES DURCY 1173-1597/GRANJA CASES S COOP C L - LLEIDA
FAGEDA KARLOTA SHOPPING/LA FAGEDA FUNDACIO - GIRONA
FELE LAWRENCE CHATI/GANADERÍA FELE S C - ASTURIAS
FERRERU EMMETT CARETA/CASA EL FERRERU - ASTURIAS
FRESER 1901 OCONNORS/GRANJA AULET BATLLE S L - GIRONA
GAN-ETXEBERRI PICK-UP 4022/S A T Nº 653 GAN ETXEBERRI - NAVARRA
GENER BOMBERO ZEA 1380/MAS GENER S C P - GIRONA
GUELL 68/EL GUELL - BARCELONA
GUTIERREZ DOORMAN TOÑY 639/BARBERENA ECHARRI Y REDIN - NAVARRA
HERMANOS LAVANGUAR/HERMANOS ZUBI,S C - ÁLAVA
INDELANTE BICHA ATWOOD/S A T INDELANTE 39140 - CANTABRIA
INDELANTE GLORY SEAVER/S A T INDELANTE 39140 - CANTABRIA
INES/GRANJA CAMPABADAL - LLEIDA
INFINIE/S A T CRUZ LEZAMA 39120 - CANTABRIA
JETBOW/BENITO CAMATS OLIVES - LLEIDA
JM HEFTY OLYMPIC/JMD ALLUE S L - LLEIDA
JM JETT AIR WINDBROOK/JMD ALLUE S L - LLEIDA
JM KRUSADER DEVON/JMD ALLUE S L - LLEIDA
JM LIELS WIN/JMD ALLUE S L - LLEIDA
JM MCCUTCHEN MARCUS/JMD ALLUE S L - LLEIDA
JOGU 8375 DURABLE/S A T JOGU N 8293 - CANTABRIA
JOGU SANDOKAN 6722/S A T JOGU N 8293 - CANTABRIA
JONQUIL 59/GRANJA EL SOTO, SLL - HUESCA
JYDHAUTORI/LASTAOLA Baserria - GUIPÚZCOA
KATARAN S FEVER 534 FEVER/KATARAN, S C - ÁLAVA
KATTABURU DURBIN DONATELLA/S C KATTABURU - NAVARRA
L MEGAGENIO 5987/GANADERÍA LAINZ - CANTABRIA
LANDA GAM CONTROL/LANDA GAMBOA, S L - ÁLAVA
LANDA GAM FLASHBACK/LANDA GAMBOA S L - ÁLAVA
LANDA GAM LAUTHORIT/LANDA GAMBOA S L - ÁLAVA
LANDETXE PICK-UP/LANDETXE S C - ÁLAVA
LAPRI 0007 BOTIN/CAPRI - CANTABRIA
LARRATE DELTA DESIRE/S A T LARRATE Nº 626 - NAVARRA
LARRATE METEOR MERTXE/S A T LARRATE Nº 626 - NAVARRA
LARRATE SHOT MOSTO/S A T LARRATE Nº 626 - NAVARRA
LARREA S FEVER ESTIGMA/LARREA S C - ÁLAVA
LARREA S FEVER ESTRADA/LARREA S C - ÁLAVA
LARREA S PICK-UP 417 GASTE/LARREA S C - ÁLAVA
LAVENTA SAILING 44/S C ENRIQUE ARIZA Y SOLA ROMANOS M - NAVARRA
LENGUSUEK EXPLODE NEKEA/S A T LENGUSUEK Nº 356 - NAVARRA
LOS TEJOS AFTERSHOC SOU/LOS TEJOS C B - VIZCAYA
LOS TEJOS EXPLODE ZORE/LOS TEJOS C B - VIZCAYA
LOS TEJOS GABOR FATIMA/LOS TEJOS C B - VIZCAYA
LOS TEJOS SUDAN NIC/LOS TEJOS C B - VIZCAYA
MACAYA BURT 393/JUAN IGNACIO MACAYA ZANDIO - NAVARRA
MENDIBURU BUXTON 548/S C MENDIBURU - NAVARRA
MIJARES ANDALUCIA BRADNICK/LOS MIJARES - CANTABRIA
MIÑANES SEADA SEAVER/GARCIA DEL BUSTO, S C - ASTURIAS
MONTARIBE ALFREDO ATASI/UNIÓN MONTARIBE, S C A - NAVARRA
MONTARIBE BRAWLER OZOLOTE/UNIÓN MONTARIBE, S C A - NAVARRA
MONTARIBE CHELIOS MONIKA/UNIÓN MONTARIBE, S C A - NAVARRA
MONTARIBE JETT AIR SILVIA/UNIÓN MONTARIBE, S C A - NAVARRA
MONTARIBE LOFFICIEL FIGAROL/UNIÓN MONTARIBE, S C A - NAVARRA
MONTARIBE STANLEYCUP 3019/UNIÓN MONTARIBE S C A - NAVARRA
MURRIETA ALTA5G ARWEN ET/MURRIETA - VIZCAYA
MURRIETA BIARRIZ DUNIA/MURRIETA - VIZCAYA
MURRIETA WINDBROOK FABULA/MURRIETA - VIZCAYA
NIEVES DEMPSEY/S A T FINCA EL CALERON 9746 - CANTABRIA
NIEVES GOLDEN DREAMS INRA/LAS NIEVES S C - CANTABRIA
NOZALIN JEANETE YORICK/NOZALIN - ASTURIAS
O1095/AGROPECUARIA QUATRE VENTS,SL - GIRONA
ONDARTZA PROMETEO 9079/ONDARTZA BITARTE SC - GUIPÚZCOA
OYAMBRE AZUCENA CONTROL/MURRIETA - VIZCAYA
PARRA MAYA 8589/S A T Nº 638NA PARRA MORENO - NAVARRA
PILAR GALEON PATRICK-559/PRESMANES CAGIGÁS, S C - CANTABRIA
PINOS TATA STANLEYCUP/EL PINOS NOU - BARCELONA
PLANILLO DUPLEX SONIA/PLANILLO HOLSTEIN - NAVARRA
PLANILLO SEAGUAL SARRICK/PLANILLO HOLSTEIN - NAVARRA
POU IMMA YORIK/CAN POU - GIRONA
POU SANDRA SUPER/CAN POU - GIRONA
POYU SC ATWOOD BAT/POIU BASERRIA S C - VIZCAYA
POYU SC LAUTHORITY TUTILA/POIU BASERRIA S C - VIZCAYA
PRAT BRAXTON TIMBRE/S PRAT PRAT C F - NAVARRA
PRAT MOGUL 846/S PRAT PRAT C F - NAVARRA
PRAT WINDHAMMER 825/S PRAT PRAT C F - NAVARRA
Q1016/AGROPECUARIA QUATRE VENTS,SL - GIRONA
Q950/AGROPECUARIA QUATRE VENTS,SL - GIRONA
REDIN CHELIOS 4007/BARBERENA ECHARRI Y REDIN - NAVARRA
RIBALTA MANIFOLD TUTI/RIBALTA LLANES,S C P - LLEIDA
ROQUET XACOBEO 1697/RAMADERIA ROQUET S C P - LLEIDA
RUT BOW/BENITO CAMATS OLIVES - LLEIDA
S A T ET PAYTON ETXA-PAYT/S A T ETXALDE - ÁLAVA
S A T ET SERGIO ETXA-SERG/S A T ETXALDE - ÁLAVA
S M VALENTINA/LA BODEGA - CANTABRIA
SAINZ AJA AIRRAID 168/S C MADRAZO R J Y SAÍNZ AJA TRUEBA - NAVARRA
SAINZ-AJA PROMISO 285/S C MADRAZO R J Y SAÍNZ AJA TRUEBA - NAVARRA
SAINZ-AJA SHOTTLE 243/S C MADRAZO R J Y SAÍNZ AJA TRUEBA - NAVARRA
SAINZ-AJA SHOTTLE 244/S C MADRAZO R J Y SAÍNZ AJA TRUEBA - NAVARRA
SAINZAJA WINDHAMMER 1081/S C SAINZ AJA TRUEBA Y SAÍNZ MAZA G - NAVARRA
SAIRETA MERIDIAN ESCOSIA/LA SAIRETA, S C P - LLEIDA
SAIRETA WINDBROOK SILLEDA/LA SAIRETA, S C P - LLEIDA
SALBIDE B DUPLEX 9914/IBARRA - VIZCAYA
SANJOSE HILL MANIFOLD/GRANJA SAN JOSÉ S A - HUESCA
SANJOSE JACEY RALSTORM I/GRANJA SAN JOSÉ S A - HUESCA
SANJOSE JEEVES LOMAX/GRANJA SAN JOSÉ S A - HUESCA
SANJOSE MASSEY MANIFOLD/GRANJA SAN JOSÉ S A - HUESCA
SANJOSE MOGUL MANIFOLD/GRANJA SAN JOSÉ S A - HUESCA
SANJOSE MOGUL MANIFOLD/GRANJA SAN JOSÉ S A - HUESCA
SANJOSE MOGUL MANIFOLD/GRANJA SAN JOSÉ S A - HUESCA
SANJOSE MOGUL RDK/GRANJA SAN JOSÉ S A - HUESCA
SANJOSE MOGUL SUPER/GRANJA SAN JOSÉ S A - HUESCA
SANJOSE MOGUL SUPER/GRANJA SAN JOSÉ S A - HUESCA
SANJOSE NUMERO UNO SUPER/GRANJA SAN JOSÉ S A - HUESCA
SANJOSE NUMEROUNO TOYSTORY/GRANJA SAN JOSÉ S A - HUESCA
SANJOSE ROSS TOYSTORY/GRANJA SAN JOSÉ S A - HUESCA
SARGAITZ DOORMAN 398/UNIÓN MONTARIBE S C A - NAVARRA
SCUGARTE DANDY 5922/S C UGARTE EGUILLOR A M Y J L - NAVARRA
SERJA ANA DOORMAN/GANADERÍA CARRILES S L - CANTABRIA
SERJA CRISTINA DOORMAN/GANADERÍA CARRILES, S L - CANTABRIA
SERRET ROLAND 1686/CAL SERRET, S C C L - LLEIDA
SICO 7195 GARRETT/GANADERÍA SICO S C - CANTABRIA
SISA GERARD/LA PARAYA, S C - CANTABRIA
SOL/LAS LLERAS - CANTABRIA
SOLAPEÑA FEVER KATI/SOLAPEÑA - VIZCAYA
SOMALERA JENNY L DAKOTA ET/S A T SOMALERA Nº 39090 - CANTABRIA
SOMALERA KATY DOORMAN/S A T SOMALERA Nº 39090 - CANTABRIA
SOMOBOO AMAYA BLADE/S A T SIERRA VILLA N 39155 - CANTABRIA
SOMOBOO CRISS LAUTHORITY/S A T SIERRA VILLA N 39155 - CANTABRIA
SOMOBOO DONATA LAVANGUARD/SOMOBOO - CANTABRIA
SOMOBOO ROBLEDA FEVER/SOMOBOO - CANTABRIA
SOMOBOO YASMINA FEVER/SOMOBOO - CANTABRIA
SOPEÑA ATLANTIC MINNIE/FINCA SOPEÑA CM, S C - CANTABRIA
SOPEÑA IOTA CAMPURRIANA/FINCA SOPEÑA CM, S C - CANTABRIA
SOPEÑA IOTA NUCA/FINCA SOPEÑA CM, S C - CANTABRIA
SOPEÑA IOTA RUPERTA/FINCA SOPEÑA CM, S C - CANTABRIA
STA ANA MICHINA/GANADERÍA SANTA ANA, S C - CANTABRIA
STA. ANA DORITA WINDBRUX/LAZAGABASTER - CANTABRIA
TONJOVI JULIA YORICK/TONJOVI - ASTURIAS
TRAVESÍA HAMPTON ARIEL/S A T LA TRAVESÍA 896 - NAVARRA
TRAVESÍA JETSET MARIEL/S A T LA TRAVESÍA 896 - NAVARRA
TRAVESÍA JORDAN AGUSTINA/S A T LA TRAVESÍA 896 - NAVARRA
V NUMERO UNO CORINA/S A T SIERRA VILLA N 39155 - CANTABRIA
VILATORTELLA 2868 SID/S A T VILATORTELLA 544 CAT - BARCELONA
VILATORTELLA 3348 MERIDIAN/S A T VILATORTELLA 544 CAT - BARCELONA
VILLANUEVA MARUJA SATURN ROJA/GANADERÍA VILLANUEVA, S C - ASTURIAS
VIÑA SHOTTLE SUNNY/CASA VIÑA, S C - ASTURIAS
ZALDUBITX BRAWLER ZALDUBITX/ZALDUBITXI,S COOP PEQUEÑA - ÁLAVA
ZALDUMEND SUDOKU 9708/ZALDUMENDI, S C - GUIPÚZCOA
ZAZPE DEFENDER LARRA 190/ANDRES ZAZPE - NAVARRA
ZIGA BROKAW 0171/S C ZIGA - NAVARRA
HEMBRAS MB DE 2º PAR TO - 85 PUNTOS
0256 OTTAWA/REVUELTA ORTIZ S C - CANTABRIA
04113418/BIDARTE Baserria - GUIPÚZCOA
0690 GILLESPY/S A T DISAMA Nº 39014 - CANTABRIA
1228 MADRILEÑA JORDAN/RUFACO - CANTABRIA
123-2013/MAS EL COLOMER - GIRONA
1241 JJ CRUZ MANIFOLD/PAULORENA HOLSTEIN,S L - LLEIDA
1264/RODRIGUEZ PALACIO, S C - CANTABRIA
1310 JJ ELVIRA BURNS/PAULORENA HOLSTEIN,S L - LLEIDA
1400 JJ ROSA BRAWLER/PAULORENA HOLSTEIN,S L - LLEIDA
1501/RODRIGUEZ PALACIO S C - CANTABRIA
1619 JJ MARTINA METEOR/PAULORENA HOLSTEIN S L - LLEIDA
20 PICK-UP 203/MAS LA TORRE - GIRONA
2508 BES CHELIOS 2080/AGROPECUARIA MAS BES S L - GIRONA
2994 BES HAMPTON 2278/AGROPECUARIA MAS BES S L - GIRONA
3096 XERMADE/SALVARREY S C - CANTABRIA
3495 WYZER/S A T M LAVIN-LOREDO - CANTABRIA
36 BIARRIZ 232/MAS LA TORRE - GIRONA
361 JEICE 237/MAS LA TORRE - GIRONA
3852 GOLONDRINA 9 SANTOS/SALVARREY, S C - CANTABRIA
623 DURAN SPIRTE SPECTRUM/MAS GELAT VELL, S L - GIRONA
677 DURAN LAKOTA FACEBOOK/MAS GELAT VELL, S L - GIRONA
697 DURAN MONTREAL ELBURN/MAS GELAT VELL, S L - GIRONA
7832/RODRIGUEZ PALACIO S C - CANTABRIA
876 JJ CLARA BLITZ/PAULORENA HOLSTEIN S L - LLEIDA
9991/HNOS GANDARA DIEGO S C - CANTABRIA
A 9975 OREGON/ALBERTO RUIZ MUÑOZ - CANTABRIA
A MONET LUNA/LA ABADIA - CANTABRIA
ACEBO BUGLER ORIGEN/S A T ACEBO CORRALES 8252 - CANTABRIA
ACEBO LARA HEFTY/S A T ACEBO CORRALES 8252 - CANTABRIA
ACEBO MARINA DORCY/S A T ACEBO CORRALES 8252 - CANTABRIA
AFRICA BOKERON/GANADERÍA PUENTE, S C - CANTABRIA
AGIRRESOR SANTURCE 224/AGIRRESOROAUNDI,S C - GUIPÚZCOA
AGR JETT AIR GUINEA/TAUSTE GANADERA S A - ZARAGOZA
AGR KRUSADER HARMONIE/TAUSTE GANADERA S A - ZARAGOZA
ALBA ACRES MANIFOLD/TAUSTE GANADERA S A - ZARAGOZA
ALBA IGINA MASCALESE/TAUSTE GANADERA S A - ZARAGOZA
ALBA MARYLAND KATANA/TAUSTE GANADERA S A - ZARAGOZA
ALBA PILLA MASCALESE/TAUSTE GANADERA S A - ZARAGOZA
ALBA PROGET MASCALESE/TAUSTE GANADERA S A - ZARAGOZA
ALBA RASI JETT AIR/TAUSTE GANADERA S A - ZARAGOZA
ALBA REDUKE KRUSADER/TAUSTE GANADERA S A - ZARAGOZA
ALBA TERRA SHADOW/TAUSTE GANADERA S A - ZARAGOZA
ALMONT ESMERALDA SANDOKAN/ALMONT, S C - CANTABRIA
ALMONT LOURDES HUNTER 3952/ALMONT, S C - CANTABRIA
AMARA 143/GANADERÍA ORTIZ, S C - CANTABRIA
ANDALORREA ATWOOD 1032/S A T ANDALORREA, Nº 4322 - NAVARRA
ANDALORREA DELTA 1026/S A T ANDALORREA, Nº 4322 - NAVARRA
ANDALORREA EXPLODE 1029/S A T ANDALORREA, Nº 4322 - NAVARRA
ANDIKOETX JETT AIR 43 NIZA/ANDIKOETXALDE S C - ÁLAVA
AORMI BELLA SHOPPING/AORMI - CANTABRIA
AORMI JOSEFINA GABOR/AORMI - CANTABRIA
AORMI NARDA JETT AIR/AORMI - CANTABRIA
APEZTEGI PICK-UP 5014/APEZTEGI Baserria - GUIPÚZCOA
AR MOLINO CHELIOS MAIA/EL MOLINO S C - VIZCAYA
AR MOLINO FACEBOOK GADEA/EL MOLINO, S C - VIZCAYA
AR MOLINO JORDAN BI/EL MOLINO, S C - VIZCAYA
ARAGON 86 BRENDAL AMY/ARAGÓN 86 - HUESCA
ARAGON 86 GERARD LINDA/ARAGÓN 86 - HUESCA
ARAGON 86 GERARD XUAS/ARAGÓN 86 - HUESCA
ARAGON 86 GILLESPY LOLYTA/ARAGÓN 86 - HUESCA
ARAGON 86 HARMONY DELY/ARAGÓN 86 - HUESCA
ARAGON 986 GAMEDAY DAMA/ARAGÓN 86 - HUESCA
ARANGAS ZIPI CARL/S A T RUYFER EL CONVENTO - CANTABRIA
ARCE ARTES LERCHE/S A T ARCE III - CANTABRIA
ARCE AVALON LERCHE/S A T ARCE III - CANTABRIA
ARCE MEGAGENIO HANNA/S A T ARCE III - CANTABRIA
ARCE MOSCU ROSA/AJAPALACIO S C - CANTABRIA
ARCE TRIGGER LERCHE/S A T ARCE III - CANTABRIA
ARDEO METEOR 1342/C B MIREN ARDEO Y OTROS - VIZCAYA
ARMENDARIZ ORMSBY 301/JOAQUÍN Mª ARMENDARIZ TELLETXEA - NAVARRA
ARMONTIN TONIDU MASCA/GANADERÍA ARMONTÍN, S C - CANTABRIA
ARRIAS SC GOFAST 6229/ARRIAGA - VIZCAYA
ARRILLAGA STREET 8923/ARRILLAGA Baserria - GUIPÚZCOA
ARTATXU B PICK-UP DORI/MIREN Y FERNANDO EGOZ- ITURRALDE - NAVARRA
ARTIZAR L TRAILER/ARTIZAR-LATZA S L - ÁLAVA
AYMERICH 635 DOM 457/MAS CIURANA - GIRONA
BARRINA 1120 SUPER/AGROPECUARIA CAN BARRINA S L - BARCELONA
78
Española 226 j/a (Pasa pag 80)
Frisona

BARRINA GABOR 1106/AGROPECUARIA CAN BARRINA, S L - BARCELONA
BATZABALEA BUXTON KENIA/S A T MENDICOA - NAVARRA
BATZABALEA FEVER SARITA/S A T MENDICOA - NAVARRA
BATZABALEA GULF TURCANA/S A T MENDICOA - NAVARRA
BEDOLLO CAMILA GERARD/GANADERÍA BEDOLLO, S C - CANTABRIA
BEDOLLO DOLCE SUPERSIRE/GANADERÍA BEDOLLO S C - CANTABRIA
BEDOLLO MAIKA MOGUL/GANADERÍA BEDOLLO S C - CANTABRIA
BEDOLLO MARA GOLD CHIP/GANADERÍA BEDOLLO S C - CANTABRIA
BEDOLLO NATY MOCOW/GANADERÍA BEDOLLO S C - CANTABRIA
BEDOLLO NOA MCCUTCHEN/GANADERÍA BEDOLLO S C - CANTABRIA
BEDOLLO SALMA SOCCER/GANADERÍA BEDOLLO S C - CANTABRIA
BEHI-ALDE BEHOBIA 6474/COOPERATIVA BEHI-ALDE - ÁLAVA
BEHI-ALDE BEHOBIA 6478/COOPERATIVA BEHI-ALDE - ÁLAVA
BEHI-ALDE BIARRIZ 6495/COOPERATIVA BEHI-ALDE - ÁLAVA
BEHI-ALDE BIARRIZ 6541/COOPERATIVA BEHI-ALDE - ÁLAVA
BEHI-ALDE BIARRIZ 6665/COOPERATIVA BEHI-ALDE - ÁLAVA
BEHI-ALDE BIKILA 6578/COOPERATIVA BEHI-ALDE - ÁLAVA
BEHI-ALDE BIXI 6580/COOPERATIVA BEHI-ALDE - ÁLAVA
BEHI-ALDE BOTOX 6270/COOPERATIVA BEHI-ALDE - ÁLAVA
BEHI-ALDE CARL 6626/COOPERATIVA BEHI-ALDE - ÁLAVA
BEHI-ALDE CARL 6656/COOPERATIVA BEHI-ALDE - ÁLAVA
BEHI-ALDE LEXUS 6640/COOPERATIVA BEHI-ALDE - ÁLAVA
BEHI-ALDE LEXUS 6660/COOPERATIVA BEHI-ALDE - ÁLAVA
BEHI-ALDE NISSAN 6516/COOPERATIVA BEHI-ALDE - ÁLAVA
BEHI-ALDE SANDOKAN 6304/COOPERATIVA BEHI-ALDE - ÁLAVA
BEHI-ALDE SCOLA 6583/COOPERATIVA BEHI-ALDE - ÁLAVA
BEHI-ALDE SUDOKU 6221/COOPERATIVA BEHI-ALDE - ÁLAVA
BERBIARAN JORDAN 496/F JAVIER ANDUEZA SANZ DE GALDEANO - NAVARRA
BERBIARAN LONGTIME 9802/F JAVIER ANDUEZA SANZ DE GALDEANO - NAVARRA
BEREKOTXEA PICK-UP 6577/S C HNOS IRIGOYEN AGUIRRE - NAVARRA
BERNABE ORFEO MILAGROS/GANADERÍA BERNABE, S C - ASTURIAS
BERNABE WONDER LAURI/GANADERÍA BERNABE S C - ASTURIAS
BIDARTE B CARSON 6160/BIDARTE Baserria - GUIPÚZCOA
BIDARTE BRAWLER IDOINE/BIDARTE Baserria - GUIPÚZCOA
BIDEGAIN PICK-UP 347/S A T BIDEGAIN - NAVARRA
BIDEGAIN PICK-UP 396/S A T BIDEGAIN - NAVARRA
BLANCANIEVES/S A T GANADERÍA HERGU - CANTABRIA
BLITZ MAZURKA/GANADERÍA ARMONTÍN, S C - CANTABRIA
BORDA ZAH BOTIN 6232/BORDA ZAHAR Baserria-ALZA - GUIPÚZCOA
BORDA ZAH MURAL 1138/BORDA ZAHAR Baserria-ALZA - GUIPÚZCOA
BUSTO REDFOX CATA/GARCIA DEL BUSTO, S C - ASTURIAS
C B S I BEHOBIA FAMARA/SAN ISIDRO - VIZCAYA
C B S I DOORMAN ANAIS/CALSECA - CANTABRIA
C V DEBORA GRATIS/S A T N 39001 CUATROVIENTOS - CANTABRIA
CALSECA LISTA BRAXTON/CALSECA - CANTABRIA
CALSECA MARQUESA GOLDEN DREAMS/CALSECA - CANTABRIA
CALSECA PERLA LAUTAMIC/CALSECA - CANTABRIA
CAMPABADAL PLANET RITA/GRANJA CAMPABADAL - LLEIDA
CAMPGRAN IRA LAKOTA/EXP PECUARIAS COVE S L (EL CAMPGRAN) - BARCELONA
CAMPGRAN MURA PLANET/EXP PECUARIAS COVE S L (EL CAMPGRAN) - BARCELONA
CAN SERRA 819 SHAME/GRANJA SERRA - BARCELONA
CAPRI 0103 SIETE/CAPRI - CANTABRIA
CAPRI 4639 BOTIN/CAPRI - CANTABRIA
CARDOSA SEAVER 8924/S A T LOS LLARES N 7530 - CANTABRIA
CARETA/LA BEREZOSA - CANTABRIA
CARMENCHU/NUFER, S C - CANTABRIA
CASABLANCA CASHCOIN GRETA/S A T CASABLANCA - CANTABRIA
CASABLANCA MOGUL CHULA/S A T CASABLANCA - CANTABRIA
CASABLANCA ROSS INA/S A T CASABLANCA - CANTABRIA
CASIMIRA EMIRAT CHANEL/GANADERÍA CASIMIRA - ASTURIAS
CAVALLERIA DEDUCTIVE PUNXA/MAS LA CAVALLERIA - BARCELONA
CAVALLERIA DORCY UNGLA/MAS LA CAVALLERIA - BARCELONA
CAVALLERIA JETSET BRANCA/MAS LA CAVALLERIA - BARCELONA
CAVALLERIA MOGUL MASCARA/MAS LA CAVALLERIA - BARCELONA
CAVALLERIA SUPERSTITION ROGENT/MAS LA CAVALLERIA - BARCELONA
CBHERNAIZ ATLANTIC 88/HERNAIZ, C B - VIZCAYA
CBHERNAIZ SMOKIN 74/HERNAIZ, C B - VIZCAYA
CECILIA/LA VILOÑESA, S L - CANTABRIA
CELIA BOLIVIA/S A T FINCA EL CALERON 9746 - CANTABRIA
COOP. LAG LOTTA-HIL L.K.-HILL/COOP LAGUNAK - ÁLAVA
COOP LAG PICK-UP L K -PICK/COOP LAGUNAK - ÁLAVA
COOP LAG PICK-UP L K -PICK/COOP LAGUNAK - ÁLAVA
COOP LAG SPRITE L K -SPRI/COOP LAGUNAK - ÁLAVA
COOP LAG SUDAN LAGUNAK S/COOP LAGUNAK - ÁLAVA
CORDOBESA/EL BARRIO - CANTABRIA
CRUZ LEZAMA AROHE BRONSON/S A T CRUZ LEZAMA 39120 - CANTABRIA
CRUZ LEZAMA LOYOLA SAILING/S A T CRUZ LEZAMA 39120 - CANTABRIA
CRUZ LEZAMA MAURA SATELITE/S A T CRUZ LEZAMA 39120 - CANTABRIA
CRUZ LEZAMA MAXIEL XACOBEO/S A T CRUZ LEZAMA 39120 - CANTABRIA
DE LA VEGA 2262 AMAPOLO/S A T DE LA VEGA SOTA 39075 - CANTABRIA
DOLABERRI FRIST 103/S A T DOLABERRI NA 643 - NAVARRA
DUCASSE JAVELLE/RAMADERIA HORTETS - LLEIDA
DUPRE JUANITA/GRANJA JADO GTRREZ S C - CANTABRIA
EDESA KELY DOORMAN ET/GRANJA LA FUENTE S C - CANTABRIA
EDESA LULY ATWOOD/GRANJA LA FUENTE S C - CANTABRIA
EDESA TEQUILA ATWOOD/GRANJA LA FUENTE S C - CANTABRIA
EDESA YASIRA CINZANO/GRANJA LA FUENTE S C - CANTABRIA
EL CIERRO 9516 JARRIO/EL CIERRO - CANTABRIA
EL CORSO GRANADA 3 SID/S A T F J SALCINES-EL CORSO 9804 - CANTABRIA
EL PUENTE PITY BAXTER/EL PUENTE - CANTABRIA
EL REY DILA JERRICK/S A T COGU-EL REY - CANTABRIA
EL REY VALERIA KRUSADER/S A T COGU-EL REY - CANTABRIA
EL SOLAR LUISA FEVER/EL SOLAR - CANTABRIA
EL CAMPO GOLD CHIP JULIA/EL CAMPO - VIZCAYA
EL HAYA BEHOBIA GALANA/EL HAYA MATIENZO C B - VIZCAYA
EL HAYA BOTIN SIENA/EL HAYA MATIENZO C B - VIZCAYA
EL HAYA CINZANO ROSA ROJA/EL HAYA MATIENZO C B - VIZCAYA
EL HAYA DOORMAN SIKA/EL HAYA MATIENZO C B - VIZCAYA
EL JOYO SUDOKU 2362/EL JOYO - VIZCAYA
ELISE IOTA/SAN PEDRO - CANTABRIA
ELIZALDE NAIROBI 2822/S C ELIZALDE A A /ELIZALDE C A - NAVARRA
ERA 1048 MERIDIAN/L'ERA D'EN SOLA - BARCELONA
ERA 756 SHOUT/L'ERA D'EN SOLA - BARCELONA
ERA 877 WILDTHING/L'ERA D'EN SOLA - BARCELONA
ERA 918 CHASE/L'ERA D'EN SOLA - BARCELONA
ERIKA JORDAN/GANADERÍA PEÑAGEMIL - CANTABRIA
ERTXIN BA SUDOKU 5386/ERTXIN Baserria - GUIPÚZCOA
ESMERALDA/GARLUSER S C - CANTABRIA
ESTAKUA ROUMARE EDURNE/ESTAKUA - VIZCAYA
ETXALAR XACOBEO 3620/ETXALAR TUDELA S C A - NAVARRA
ETXART BOTIN 7657/S C ETCHART MAYA-JIMÉNEZ MUGICA - NAVARRA
FAGEDA COSMO RUBLE/LA FAGEDA FUNDACIO - GIRONA
FELE BARBIOTA AGUEDA/GANADERÍA FELE, S C - ASTURIAS
FELE BEAUTY NATALIA/GANADERÍA FELE, S C - ASTURIAS
FELE PEDRO AROA/GANADERÍA FELE, S C - ASTURIAS
FERRERU GOMEZ LINDA/CASA EL FERRERU - ASTURIAS
FISURE.CB ATWOOD MARAGDA/FISURE PORTILLO C B - VIZCAYA
FISURE CB MAN-O-MAN CEREZA/FISURE PORTILLO C B - VIZCAYA
FISURE CB MERIDIAN RUPERTA/FISURE PORTILLO C B - VIZCAYA
FISURE CB SEAVER MAITANE/FISURE PORTILLO C B - VIZCAYA
FISURE CB WINDBROOK ANDES/FISURE PORTILLO C B - VIZCAYA
FRANCIA ZELGADIS JIANDUZA/LASTAOLA Baserria - GUIPÚZCOA
G S STRUNK 1305/GERMÁN SARABIA - CANTABRIA
GALDOS SIRIUS ZANDRA/GALDOS GARCÍA - VIZCAYA
GARBIÑE BRADNICK 558/S A T GARBIÑE Nº 6353 - NAVARRA
GAVIOTA/S A T GANADERÍA HERGU - CANTABRIA
GENER BLEISA BOMBERO 1388 ET/MAS GENER S C P - GIRONA
GENER BLUNA TOUCHDOWN 1374 ET/MAS GENER S C P - GIRONA
GENER COSMOPOLITA OHARE 135 ET/MAS GENER S C P - GIRONA
GENER SHENIA SHAMROCK 1261 ET/MAS GENER S C P - GIRONA
GIMFERRER URBANA SIOUX/CAN GIMFERRER SCP - GIRONA
GUNDA/FRISIONAS S L - GIRONA
GURI RIX PHOENIX 5120/MAS GURI SAT Nº 4756 - GIRONA
GUTIERREZ CHELIOS COLOMBIA 629/BARBERENA ECHARRI Y REDÍN - NAVARRA
GUTIERREZ LAVANGUARD SIBERIA 6/S A T GARBIÑE Nº 6353 - NAVARRA
HECHADERA AUSTIN ALIENA/LA HECHADERA, C B - VIZCAYA
HERBARFER IMPRESSIO ISLA/HERBARFER - VIZCAYA
HERBARFER SID DOROTY/HERBARFER - VIZCAYA
HERMANOS BIARRIZ/HERMANOS ZUBI,S C - ÁLAVA
HNOS GUTIERREZ PRIMA/HNOS GUTIÉRREZ MADRAZO, S C - CANTABRIA
HORTETS GOLDDAY SINIA 1093/RAMADERIA HORTETS - LLEIDA
HORTETS JETT AIR OLEAREA 1066/RAMADERIA HORTETS - LLEIDA
IBARRA SHERATON ASCENSION/IBARRA - VIZCAYA
IMAGE 2712/GRANJA JADO GTRREZ S C - CANTABRIA
INCLAN FEVER TELVA/GANADERÍA INCLÁN S C - ASTURIAS
INDELANTE BONITA HEFTY/S A T INDELANTE 39140 - CANTABRIA
INDELANTE ELSA SEAVER/S A T INDELANTE 39140 - CANTABRIA
INDELANTE JOSEFA DELETE/S A T INDELANTE 39140 - CANTABRIA
INDELANTE TRISTE SUDOKU/S A T INDELANTE 39140 - CANTABRIA
IRAZABAL JORDAN MARGARETH/AHEDO IRAZABAL - VIZCAYA
IRAZABAL SPIRTE SABRINA/AHEDO IRAZABAL - VIZCAYA
IRURE WINDHAMMER 1007/S C IRURE ETULAIN A IRURE IBERO A - NAVARRA
IRURE WINDHAMMER 1011/S C IRURE ETULAIN A IRURE IBERO A - NAVARRA
IVOIRE/GRANJA JADO GTRREZ,S C - CANTABRIA
J 628/GRANJA BARRAGUER PENA S L - HUESCA
JABELLE 277/FONTFERRI S C P - BARCELONA
JACKSON 2058/HNOS GANDARA S C - CANTABRIA
JADE/S A T DE LA VEGA SOTA 39075 - CANTABRIA
JAIMERENA MANIX 7009/JUAN MARI JAIMERENA HARAN - NAVARRA
JESUS Mª BONUS/JESUS MARÍA ALBIZUA PINEDO - ÁLAVA
JM GRODEN JAMES/JMD ALLUE S L - LLEIDA
JM IMPRESSION DEANN/JMD ALLUE, S L - LLEIDA
JM MERIDIAN DON/JMD ALLUE, S L - LLEIDA
JM MILLION GOLI/JMD ALLUE, S L - LLEIDA
JM MINCIO DEANN/JMD ALLUE, S L - LLEIDA
JM STOP LIESL/JMD ALLUE, S L - LLEIDA
JOGU ATLANTIC 4355/S A T JOGU N 8293 - CANTABRIA
JOGU DOM 2957/S A T JOGU N 8293 - CANTABRIA
JOGU MCCUTCHEN 6393/S A T JOGU N 8293 - CANTABRIA
JUANA/S A T GANADERÍA HERGU - CANTABRIA
JUPETTE/CAN RIBAS - GIRONA
KATTABURU BRADY KATTAGORRI/S C KATTABURU - NAVARRA
KATTABURU MERIDIAN NICOL/S C KATTABURU - NAVARRA
L ALEGRIA GARRETT/LAZA FERNÁNDEZ S C - CANTABRIA
L BILBAO 7309/GANADERÍA LAINZ - CANTABRIA
L CARLOS 4612/GANADERÍA LAINZ - CANTABRIA
L BARCENA SAM ADE/LA BARCENA - VIZCAYA
L C TANUCA BRAWLER/LAVÍN-COLINA, S C - CANTABRIA
L SALCES ALTAOAK ORIOL/LOS SALCES, C B - VIZCAYA
LA CASONA VERMUT CINZANO ROJA/LA CASONA - CANTABRIA
LA MARNIA BOZATA RAZOR/LA MARNIA S C - CANTABRIA
LA MARNIA JOYA MEGAGENIO/LA MARNIA S C - CANTABRIA
LA RIA NESCA IMPRESSION/LA RÍA - CANTABRIA
LA RIA RUMBA SIRIUS/LA RÍA - CANTABRIA
LA RIA SAMARA MANIFOLD/LA RÍA - CANTABRIA
LA RIA SEVENUT TOYSTORY/LA RÍA - CANTABRIA
LA MIMOSA AIRBAG GISELA/LA MIMOSA, S C - VIZCAYA
LA RIGADA STALLION DAILA/LA RIGADA - VIZCAYA
LABIÑUELA MERIDIAN 467/LA BIÑUELA - VIZCAYA
LACTEOS B BOTIN 8669/LACTEOS BORDATXO,S L - GUIPÚZCOA
LAISU FEVER ELORTZ/LAISU, C B - VIZCAYA
LANDA GAM BRAWLER/LANDA GAMBOA, S L - ÁLAVA
LANDA GAM BRAWLER/LANDA GAMBOA, S L - ÁLAVA
LANDA GAM EPIC/LANDA GAMBOA S L - ÁLAVA
LANDA GAM EPIC/LANDA GAMBOA S L - ÁLAVA
LANDA GAM JERRICK/LANDA GAMBOA S L - ÁLAVA
LANDA GAM JETT AIR/LANDA GAMBOA S L - ÁLAVA
LANDA GAM JETT AIR/LANDA GAMBOA S L - ÁLAVA
LANDAKO FEVER ROSI/LANDAKO - VIZCAYA
LANZALEDA LONGTIME PIQUITA/LANZALEDA, C B - VIZCAYA
LARREA S DUPLEX BELANDIA/LARREA S C - ÁLAVA
LARREA S IMPRESSIO 475 GOMEL/LARREA S C - ÁLAVA
LARREA S KINGLY AITZIBER/LARREA S C - ÁLAVA
LASTAOLA CARL CAROL/LASTAOLA Baserria - GUIPÚZCOA
LAVENTA BEHOBIA 101/S C ENRIQUE ARIZA Y SOLA ROMANOS M - NAVARRA
LAVENTA SAILING 5/S C ENRIQUE ARIZA Y SOLA ROMANOS M - NAVARRA
LENGUSUEK DORN ANTTONI/S A T LENGUSUEK Nº 356 - NAVARRA
LENGUSUEK EXPLODE EPELA/S A T LENGUSUEK Nº 356 - NAVARRA
LEZCANO 5633 TALON/LEZCANO - CANTABRIA
LIMONERA 49/CIFP LA GRANJA - CANTABRIA
LLUISA BUCKEYE CANDELA/LLUISA S C - ASTURIAS
LOITZAMEN LAVANGUAR/LOITZAMENDI S C - ÁLAVA
LOS CURTOS TOPANGA/LOS CURTOS, S C - CANTABRIA
LOS CURTOS ZAIRA/LOS CURTOS, S C - CANTABRIA
LOS VALLEJOS LIANA POKER/LAISU, C B - VIZCAYA
LOS VALLEJOS SABRINA BAXTER/EL PUENTE - CANTABRIA
LOS TEJOS AFTERSHOC HONDARI/LOS TEJOS, C B - VIZCAYA
LOS TEJOS DELETE FRESA/LOS TEJOS, C B - VIZCAYA
LOS.TEJOS JETT AIR PANDORA/LOS TEJOS C B - VIZCAYA
LUNA BRADNICK/SOMAPANDO S C - CANTABRIA
MANZANILLO CARETA MILLION/MANZANILLO - CANTABRIA
MARIBEL DEDUCTIVE CAMELIA/MARIBEL - VIZCAYA
80 Frisona Española 226 j/a
MARIBEL MAGISTRAA LELY/MARIBEL - VIZCAYA
MARIBEL NEBRASKA DANIELA/MARIBEL - VIZCAYA
MARIBEL SMOKIN MILA/MARIBEL - VIZCAYA
MARICELA/LA TEJA - CANTABRIA
MARIEZCURRENA COLDER 7532/S C MARIEZCURRENA V Y V MIHURA - NAVARRA
MARIEZKURRENA CHICAGO 5083/S C MARIEZCURRENA V Y V MIHURA - NAVARRA
MAS RUART SHOPPING 156/MAS RUART - GIRONA
MENDIBURU FEVER 437/S C MENDIBURU - NAVARRA
MIJARES BLANQUITA OREGON/LOS MIJARES - CANTABRIA
MIJARES CLEO JETT AIR/LOS MIJARES - CANTABRIA
MIJARES DIAMANTE IOTA/LOS MIJARES - CANTABRIA
MIJARES DUQUESA CHARRUA/LOS MIJARES - CANTABRIA
MIJARES ELISABET MAZDA/LOS MIJARES - CANTABRIA
MIJARES MARQUESA IOTA/LOS MIJARES - CANTABRIA
MOBO 3524 SOCCER/S A T MOBO N 39077 - CANTABRIA
MOLINAR GREENWAY 216/S A T EL MOLINAR Nº 5409 - NAVARRA
MONTARIBE AFTERSHOCK ARAXE/UNIÓN MONTARIBE, S C A - NAVARRA
MONTARIBE BRADY BASARA/UNIÓN MONTARIBE, S C A - NAVARRA
MONTARIBE BRADY CORA/UNIÓN MONTARIBE S C A - NAVARRA
MONTARIBE CHASSITY CIRIZA/UNIÓN MONTARIBE S C A - NAVARRA
MONTARIBE CHELIOS ANOZ/UNIÓN MONTARIBE S C A - NAVARRA
MONTARIBE ELIXARTE AZKONA/UNIÓN MONTARIBE S C A - NAVARRA
MONTARIBE GABOR LEGARIA/UNIÓN MONTARIBE S C A - NAVARRA
MONTARIBE GAMEDAY MIHELE/UNIÓN MONTARIBE S C A - NAVARRA
MONTARIBE LIQUID GOLD BINE/UNIÓN MONTARIBE, S C A - NAVARRA
MONTARIBE LOVERMAN OLAZUZ/UNIÓN MONTARIBE, S C A - NAVARRA
MONTARIBE MAXIMUS GEAXI/UNIÓN MONTARIBE, S C A - NAVARRA
MONTARIBE MAXIMUS LEXUTI/UNIÓN MONTARIBE, S C A - NAVARRA
MURRIETA CHELIOS ZELDA/MURRIETA - VIZCAYA
MURUCUC ASHLAR SUSTAIN/EL MURUCUC, S L - BARCELONA
MURUCUC MAGOT AZURE/EL MURUCUC, S L - BARCELONA
N S H 4468 GOSPELL 3998/ÁNGEL NAVARRO SEGURA E HIJOS S C - ZARAGOZA
NACHI MILLION TERESA/S A T FINCA EL CALERON 9746 - CANTABRIA
NAVIDAD BLITZ/GANADERÍA LAZA - CANTABRIA
NIEVES FEVER SHEYOA/LAS NIEVES S C - CANTABRIA
NIEVES GOSPEL/GANADERÍA PEÑAGEMIL - CANTABRIA
NOVALES A FILA/NOVALES ALDAY S C - ÁLAVA
OCEJO PEA BEACON/S A T SIERRA VILLA N 39155 - CANTABRIA
OJO PINTO/LA PADRIZA, S C - CANTABRIA
ONDARTZA ARTES 7252/ONDARTZA BITARTE SC - GUIPÚZCOA
ONDARTZA BRAXTON 5301/ONDARTZA BITARTE SC - GUIPÚZCOA
ONDARTZA DOORMAN/ONDARTZA BITARTE SC - GUIPÚZCOA
ONDARTZA XACOBEO 3775/ONDARTZA BITARTE SC - GUIPÚZCOA
ONDARTZA XACOBEO 8551/ONDARTZA BITARTE SC - GUIPÚZCOA
ONDAZARTE BRADNICK ESTELADA/ONDAZARTE GAIN S L - GUIPÚZCOA
ONDAZARTE GOLD CHIP TXIRRITO/ONDAZARTE GAIN S L - GUIPÚZCOA
ONDAZARTE MCCUTCHEN MANICALIG/ONDAZARTE GAIN S L - GUIPÚZCOA
ORIOL BOUTLAND 477/MANSO ORIOL - BARCELONA
ORTIZ BELLA FEVER/GANADERÍA ORTIZ S C - CANTABRIA
OTIDES CB BEHOBIA 715/OTIDES C B - VIZCAYA
OYARZUN EPIC 4767/S C OYARZUN BENGOETXEA G Y J - NAVARRA
PANADERO GABOR SANTA/LA PARAYA, S C - CANTABRIA
PANADERO ROSSY BRADNICK/LA PARAYA, S C - CANTABRIA
PANADERO SANCHEZ NOA/LA PARAYA, S C - CANTABRIA
PEDREGAL PEDRO PERLA/EL PEDREGAL, S C - ASTURIAS
PEÑARROYA 1231/GRANJA BARRAGUER PENA, S L - HUESCA
PEÑARROYA 1267/GRANJA BARRAGUER PENA, S L - HUESCA
PEÑARROYA 1512/GRANJA BARRAGUER PENA, S L - HUESCA
PERLA JORDAN/LA LOMBA S C - CANTABRIA
PEROJO NOIRA MOSCOW/PEROJO - CANTABRIA
PEROJO ZAPA TALON/PEROJO - CANTABRIA
PINOS BARLA RICHMAN/EL PINOS NOU - BARCELONA
PINOS DEIVA EXPLODE/EL PINOS NOU - BARCELONA
PINOS FORAE RAMROCK/EL PINOS NOU - BARCELONA
PINOS JENI FABI/EL PINOS NOU - BARCELONA
PINOS MERI MERIDIAN/EL PINOS NOU - BARCELONA
PINOS NANA ALTA AVALON/EL PINOS NOU - BARCELONA
PINOS NORMA DIGGER/EL PINOS NOU - BARCELONA
PINOS NYICA AITA CALIBER/EL PINOS NOU - BARCELONA
PLANILLO ACME ELSI ET/PLANILLO HOLSTEIN - NAVARRA
PLANILLO CONTROL GREETEL/PLANILLO HOLSTEIN - NAVARRA
PLANILLO CONTROL MELISA/PLANILLO HOLSTEIN - NAVARRA
PLANILLO DOORMAN EDURNE/PLANILLO HOLSTEIN - NAVARRA
PLANILLO MERIDIAN MONICA-ET/PLANILLO HOLSTEIN - NAVARRA
PLANILLO WINDBROOK SARIÑA/PLANILLO HOLSTEIN - NAVARRA
PLATERA/LA BEREZOSA - CANTABRIA
POLLEO RISING ESTRELLA/CASA POLLEDO - ASTURIAS
PONDEROSA BRADNICK GINESA/GANADERÍA INCLAN,S C - ASTURIAS
POYU SC AUSTIN BOST/POIU BASERRIA, S C - VIZCAYA
POYU SC MCCUTCHEN DANI/POIU BASERRIA, S C - VIZCAYA
PRAT MOGUL 826/S PRAT PRAT C F - NAVARRA
PUENTE FLOR CRISTIAN/GANADERÍA PUENTE, S C - CANTABRIA
QUIRCH WATERLOO CHAMONIX/CAN QUIRCH - GIRONA
RABRE EIMY MAYFIELD/RABRE MAZPULE - CANTABRIA
RABRE STEY BRADNICK/RABRE MAZPULE - CANTABRIA
RAMORENA EPIC ERIKA/SCDAD COOP LTDA RAMORENA - NAVARRA
RAMORENA FEVER ELURTE/SCDAD COOP LTDA RAMORENA - NAVARRA
REBECA GOFAST/S A T CRESPO LAVIN-BARCEÑA - CANTABRIA
REGATO SPRINT 2502/REGATO GONZÁLEZ - CANTABRIA
RESONDA/CARMEN SOLEDAD PÉREZ ORTIZ - CANTABRIA
RIANA/FUENTE ISEÑA, S C - CANTABRIA
RIBALTA JADON ESTEL/RIBALTA LLANES,S C P - LLEIDA
RIBAS 532 SHOPPING 327/CAN RIBAS - GIRONA
RIBATXENT IMPRESSIO DAMARIS/RIBATXENTA S L - ÁLAVA
RIBATXENT SILEX BETISA/RIBATXENTA S L - ÁLAVA
ROQUET DOBERMAN 1742/RAMADERIA ROQUET, S C P - LLEIDA
ROQUET HEFTY 1766/RAMADERIA ROQUET S C P - LLEIDA
S POTTER 7915/EL SOLAR S C - CANTABRIA
S STITION 3702/SARRAGA - CANTABRIA
S A T ET ALTAIOTA ETXA-ALTA/S A T ETXALDE - ÁLAVA
S A T ET IMPRESSIO ETXALDE S/S A T ETXALDE - ÁLAVA
S A T ET JACEY CRI ETXALDE J/S A T ETXALDE - ÁLAVA
S A T ET PAYTON ETXA-PAYT/S A T ETXALDE - ÁLAVA
S A T ET SAKUM ETXA-SAKU/S A T ETXALDE - ÁLAVA
S A T ET STREET ETXA-STRE/S A T ETXALDE - ÁLAVA
S A T ET SUPERSIRE ETXA-SUPE/S A T ETXALDE - ÁLAVA

SAINZAJA EPIC 1082/S C SAINZ AJA TRUEBA Y SAINZ MAZA G - NAVARRA
SAINZ-AJA HILARI 317/S C MADRAZO R J Y SAINZ AJA TRUEBA - NAVARRA
SAINZ-AJA LONGTIME 235/S C MADRAZO R J Y SAINZ AJA TRUEBA - NAVARRA
SAINZ-AJA MIZUNO 261/S C MADRAZO R J Y SAINZ AJA TRUEBA - NAVARRA
SAIRETA CALIBER AACHEN/LA SAIRETA, S C P - LLEIDA
SAIRETA CALIBER SEPIA/LA SAIRETA S C P - LLEIDA
SAIRETA WINDBROOK CALSADA/LA SAIRETA S C P - LLEIDA
SALBIDE B IMPRESSIO 6469/SALBIDE BASERRÍA - GUIPÚZCOA
SANJOSE DANACOL FRANCIA/GRANJA SAN JOSÉ S A - HUESCA
SANJOSE ECOYNE ISY POTTER/GRANJA SAN JOSÉ S A - HUESCA
SANJOSE EDELWEISS FRANCIA/GRANJA SAN JOSÉ S A - HUESCA
SANJOSE JACEY SUPER/GRANJA SAN JOSÉ S A - HUESCA
SANJOSE JETTAIR SUPER/GRANJA SAN JOSÉ S A - HUESCA
SANJOSE JORDAN DEANN/GRANJA SAN JOSÉ S A - HUESCA
SANJOSE JORDAN TOYSTORY/GRANJA SAN JOSÉ S A - HUESCA
SANJOSE MANIFOLD BOLIVER/GRANJA SAN JOSÉ S A - HUESCA
SANJOSE MASSEY JORDAN/GRANJA SAN JOSÉ S A - HUESCA
SANJOSE MASSEY ROSS/GRANJA SAN JOSÉ S A - HUESCA
SANJOSE MASSEY SUPER/GRANJA SAN JOSÉ S A - HUESCA
SANJOSE MASSEY SUPER/GRANJA SAN JOSÉ S A - HUESCA
SANJOSE MASSEY SUPER/GRANJA SAN JOSÉ S A - HUESCA
SANJOSE MAXUM DEANN/GRANJA SAN JJOSÉ S A - HUESCA
SANJOSE MIRACLE MANIFOLD/GRANJA SAN JOSÉ S A - HUESCA
SANJOSE MOGUL BONAIR/GRANJA SAN JOSÉ S A - HUESCA
SANJOSE MOGUL JINGLES/GRANJA SAN JOSÉ S A - HUESCA
SANJOSE MOGUL MANIFOLD/GRANJA SAN JOSÉ S A - HUESCA
SANJOSE MOGUL MANIFOLD/GRANJA SAN JOSÉ S A - HUESCA
SANJOSE MOGUL SUPER/GRANJA SAN JOSÉ S A - HUESCA
SANJOSE MOGUL TOYSTORY/GRANJA SAN JOSÉ S A - HUESCA
SANJOSE NUMERO UNO PLANET/GRANJA SAN JOSÉ S A - HUESCA
SANJOSE NUMERO UNO RDK/GRANJA SAN JOSÉ S A - HUESCA
SANJOSE ONSIDE JESTHER/GRANJA SAN JOSÉ S A - HUESCA
SANJOSE SUPERSTITION MODEST/GRANJA SAN JOSÉ S A - HUESCA
SANJOSE TOYSTORY FIBRAX/GRANJA SAN JOSÉ S A - HUESCA
SANT MER 4417 BRADY 5470/S A T SANT MER 1916 - GIRONA
SANT MER 4734 AARON 5405/S A T SANT MER 1916 - GIRONA
SANT MER URANIE SUPER 4345/S A T SANT MER 1916 - GIRONA
SANTAISABEL MANIFOLD BRUNO/S A T GRANJA SANTA ISABEL Nº - NAVARRA
SANTAISABEL SHOUT CARTUJA/S A T GRANJA SANTA ISABEL Nº - NAVARRA
SANTAISABEL SOCRATES GUINDA/S A T GRANJA SANTA ISABEL Nº - NAVARRA
SANTAISABEL URSUS NENA/S A T GRANJA SANTA ISABEL Nº - NAVARRA
SANTANA FEVER 392/EL ARROYO - VIZCAYA
SANZANCIN GORCH FOCK 7072/S A T SANZ ANCÍN - NAVARRA
SANZANCIN LIBRA 7070/S A T SANZ ANCÍN - NAVARRA
SARA/S A T QUINTANA-RODRÍGUEZ - CANTABRIA
SARGAITZ DAY 361/BIDARTE BASERRÍA - GUIPÚZCOA
SAT SOLIUS 1152 MANIFOLD/MAS PIJOAN - GIRONA
SENA/LAS LLERAS - CANTABRIA
SICO 0922 JEEVES/GANADERÍA SICO S C - CANTABRIA
SICO 6284 GERARD/GANADERÍA SICO S C - CANTABRIA
SICO 6742 TOJO/GANADERÍA SICO S C - CANTABRIA
SIDRA/CARCOBA LAVÍN - CANTABRIA
SOLAPEÑA SUDOKU LIBA/SOLAPEÑA - VIZCAYA
SOMALERA INDIA HEFTY/S A T SOMALERA Nº 39090 - CANTABRIA
SOMOBOO ALY BLADE/SOMOBOO - CANTABRIA
SOMOBOO RABONA TRUENO/SOMOBOO - CANTABRIA
STA ANA RIANA MEGAGENIO/GANADERÍA SANTA ANA S C - CANTABRIA
SUESKUN IOTA 1682/S C SUESCUN PUERTA - NAVARRA
SUESKUN NIRVANA 2010/S C SUESCUN PUERTA - NAVARRA

TEJERA/RUFACO - CANTABRIA
TEJERIA MEDELLIN LINDA/SEQUILLA - VIZCAYA
THIO ALTAOAK EUDINA 778 ET/CAN THIO DE BAIX (EFA AYMERICH S C P ) - GIRONA
THIO TANGO ANGELA 802/CAN THIO DE BAIX (EFA AYMERICH S C P ) - GIRONA
THIO TANGO BEAUTY 790/CAN THIO DE BAIX (EFA AYMERICH S C P ) - GIRONA
TONJOVI BEAUTY NEGRA/TONJOVI - ASTURIAS
TOSTADITA GOLDEN DREAMS/SOMAPANDO S C - CANTABRIA
TOYBOY 9738/REVUELTA ORTIZ S C - CANTABRIA
TRAVESÍA FACEBOOK NOARA/S A T LA TRAVESÍA 896 - NAVARRA
TRAVESÍA FACEBOOK SABINA/S A T LA TRAVESÍA 896 - NAVARRA
TRAVESÍA FERNAND DULCE/S A T LA TRAVESÍA 896 - NAVARRA
TRAVESÍA JABIR SHEYLA/S A T LA TRAVESÍA 896 - NAVARRA
TRAVESÍA JETT AIR CAMIA/S A T LA TRAVESÍA 896 - NAVARRA
TRAVESÍA JETT AIR RAMONA/S A T LA TRAVESÍA 896 - NAVARRA
TRAVESÍA SHOCKER ALFONSINA/S A T LA TRAVESÍA 896 - NAVARRA
TRAVESÍA SMURF BUFFY/S A T LA TRAVESÍA 896 - NAVARRA
TRAVESÍA SMURF CARLA/S A T LA TRAVESÍA 896 - NAVARRA
TRAVESÍA SMURF CATA/S A T LA TRAVESÍA 896 - NAVARRA
TRAVESÍA SNOW ALABAMA/S A T LA TRAVESÍA 896 - NAVARRA
TRAVESÍA SNOW TAIS/S A T LA TRAVESÍA 896 - NAVARRA
TRAVESÍA STANLEYCUP CANELA/S A T LA TRAVESÍA 896 - NAVARRA
TRIAS BUTZE 83/GRANJA MAS TRIAS S L - GIRONA
URIBURU S ATWOOD/URIBURU S C - ÁLAVA
URIBURU S LEXUS/URIBURU S C - ÁLAVA
URRUTIA R BOTIN GIUSE-BOT/URRUTIA RUEDA S C - ÁLAVA
V GOLD CHIP ENERITZ/S A T SIERRA VILLA N 39155 - CANTABRIA
V MESSI ANTONELA/S A T SIERRA VILLA N 39155 - CANTABRIA
VAILARINA STANLEYCUP/SOMAPANDO, S C - CANTABRIA
VALERA SC AUTOMATIC MARIANA/VISTA ALEGRE - VIZCAYA
VALERA SC OSAKA DULCE/VISTA ALEGRE - VIZCAYA
VILAR-ALAXE JETT AIR 966/TAUSTE GANADERA S A - ZARAGOZA
VILATORTELLA 2945 GABOR/S A T VILATORTELLA 544 CAT - BARCELONA
VILATORTELLA 2984 GABOR/S A T VILATORTELLA 544 CAT - BARCELONA
VILATORTELLA 3102 KOLTON/S A T VILATORTELLA 544 CAT - BARCELONA
VILATORTELLA 3205 EXPLODE/S A T VILATORTELLA 544 CAT - BARCELONA
VILATORTELLA 3323 IMPRESSION/S A T VILATORTELLA 544 CAT - BARCELONA
VILATORTELLA 3352 MERIDIAN/S A T VILATORTELLA 544 CAT - BARCELONA
VILATORTELLA 3360 MERIDIAN/S A T VILATORTELLA 544 CAT - BARCELONA
VILATORTELLA 3371 SPUR/S A T VILATORTELLA 544 CAT - BARCELONA
VILATORTELLA 3379 MCCUTCHEN/S A T VILATORTELLA 544 CAT - BARCELONA
VILATORTELLA 3398 JETT AIR/S A T VILATORTELLA 544 CAT - BARCELONA
VILLANUEVA SUSI COWLAND ROJA/GANADERÍA VILLANUEVA, S C - ASTURIAS
VILLASIERRA 1151 CHELIOS/S A T 2038 VILLASIERRA - ZARAGOZA
VILLASIERRA 1164 CHELIOS/S A T 2038 VILLASIERRA - ZARAGOZA
VIÑA DUSK LOLA/CASA VIÑA S C - ASTURIAS
VIÑA LEKON LIA/CASA VIÑA S C - ASTURIAS
ZABAL ERR BIARRIZ 4991/ZABAL ERREKONDO S C - GUIPÚZCOA
ZALDUBITX JETT AIR ZALDUBITX/ZALDUBITXI S COOP PEQUEÑA - ÁLAVA
ZALDUBITX JORDAN ZALDUBITX/ZALDUBITXI S COOP PEQUEÑA - ÁLAVA
ZALDUBITX JORDAN ZALDUBITX/ZALDUBITXI S COOP PEQUEÑA - ÁLAVA
ZALDUBITX XACOBEO ZALDUBITX/ZALDUBITXI,S COOP PEQUEÑA - ÁLAVA
ZALDUBITX XACOBEO ZALDUBITX/ZALDUBITXI,S COOP PEQUEÑA - ÁLAVA
ZALDUMEND JORDAN 0737/ZALDUMENDI, S C - GUIPÚZCOA
ZALDUMEND SPECTRUM 3347/ZALDUMENDI, S C - GUIPÚZCOA
ZALDUMEND XACOBEO 4762/ZALDUMENDI, S C - GUIPÚZCOA
ZAZPE EXPLODE TTAKUN 181/ANDRÉS ZAZPE - NAVARRA
ZIGA JORDAN 0051/S C ZIGA - NAVARRA
ZIGA MILLION 0032/S C ZIGA - NAVARRA
ZUBELTZU BIARRIZ 6325/ZUBELTZU TORRE BASERRÍA - GUIPÚZCOA

Septiembre

Zamora, Valladolid, Madr id, Toledo, Albacete, Ciudad Real, Cádiz, Sevilla, Granada, Almería y Málaga.
Octubre

Córdoba, A Cor uña y Lugo

82 Frisona Española 226 j/a
Resumen de Calificación por tipo 2018. Categorías Meses Excelentes Muy Buenos Más que Buenos Buenos Regulares Insuficientes A p t a s H e m b r a s Totales M a c h o s H e m b r a s M a c h o s H e m b r a s M a c h o s H e m b r a s M a c h o s H e m b r a s M a c h o s H e m b r a s M a c h o s H e m b r a s Machos Hembras Animales Ganaderías visitadas Enero 0 24 0 640 3 4 949 3 4 951 0 457 0 8 859 5 11 888 11 894 651 Febrero 0 13 1 448 7 4 305 1 4 206 0 401 0 11 521 9 9 945 9 954 530 Marzo 0 51 5 870 3 5 372 3 4 562 0 367 0 6 692 11 11 920 11 931 667 Abril 0 84 4 1.231 15 5.591 1 3.748 0 237 0 2 1.021 20 11.914 11 934 720 Mayo 1 38 4 793 8 5 888 2 5 361 0 464 0 8 857 15 13 409 13 424 542 Junio 0 28 2 481 3 4 854 0 5 056 0 431 0 14 1 107 5 11 971 11 976 315 TOTAL 1 238 16 4.503 39 30.959 10 27.884 0 2.357 0 49 5.057 66 71.047 71.113 3.425
Calendar io de Calificación

37
1.105 VETERINARIOS especialistas en medicina bovina
23 Congresos Internacionales,
11.171 Congresistas,
443 Ponencias nacionales y extranjeras
Jornadas, Seminarios y Simposios con 5.009 asistentes
A n e m b e R e s p o n d e
Confor t de los tra bajadores en las granjas lecheras

¿Me gusta ría sa ber s i cua ndo se proyecta y diseña nuevas insta la ciones, se tiene en cuenta el confort de los tra baja dores y cua les seria n los pu ntos principa les a cons idera r?
Responde: Manuel V Morales* - ANEMBE
En los últimos años se ha hablado mucho del diseño de instalaciones en base al confort animal y productividad de los mismos, todos sabemos que este factor es de vital importancia en el negocio de la producción de leche, pero efectivamente, también hay que empezar a considerar el bienestar de los trabajadores a la hora del diseño, mantenimiento y organización de una explotación La gestión de recursos humanos está comenzando a ser uno de los factores más limitantes en el sector
Actualmente uno de los principales problemas en las granjas es la dificultad para reclutar trabajadores, for marlos y fidelizarlos. Es difícil de cuantificar, pero el costo económico de tener malos trabajadores en la granja es enor me La falta de motivación, la poca cualificación, la falta de organización etc son factores que nos van a influir en todas las áreas de producción (ordeño, alimentación salud reproducción etc)
Por ello plantear esta cuestión me parece muy interesante y debería empezar a tenerse en

cuenta desde el momento en que se proyecta una instalación nueva, una ampliación o mejora Alguien puede pensar que esto es solamente para las granjas grandes pero desde mi punto de vista es igual o más importante para las granjas familiares si queremos tener relevo generacional. Actualmente los jóvenes, no solo buscan tener trabajo, sino que sea un trabajo de calidad, con horarios sensatos y tiempo libre
Pensemos en lo que hemos conseguido durante años trabajando en el confort de nuestros animales dando como fruto altas productividades.
¿Por qué no hacerlo también con las personas?
La noción de bienestar hace referencia al conjunto de aquellas cosas que se necesitan para vivir bien: dinero para satisfacer las necesidades materiales, salud, tiempo para el ocio y, relaciones afectivas sanas son algunas de las cuestiones que hacen el bienestar de una persona
Partiendo de la base de que el bienestar es un estado subjetivo y por tanto diferente para cada individuo, si queremos cuidar este aspecto en nuestras granjas, cuidaremos los siguientes puntos:
1 Zona de trabajo
Pasamos, al menos una tercera parte de nuestro tiempo en el puesto de trabajo por lo que al menos deberíamos facilitar:
1. a. - Per mitir al trabajador encontrarse física mente a gusto Luz, Temperatura, hume dad etc Serán factores a tener en cuenta
1 b - Tur nos de trabajo coherentes, con hora rios definidos y en caso de horas extra que sean remuneradas
1. c.- Facilitar ropa y herramientas adecuada a la labor exigida.
La sala de ordeño es uno de los lugares donde más tiempo pasa el trabajador, debemos cuidar el diseño en cuanto a orientación y aislamientos, diseño de los fosos de ordeño, anchuras y alturas etc Suelos antideslizantes no solo para las vacas, también para las personas
* OCEVA Zamora
84 Frisona Española 226 j/a
Climatizar la sala de ordeño mejora el rendimiento de operarios
Los patios donde se efectúan labores de manejo reproductivo y sanitario de animales también merecen especial atención. A tener en cuenta la sujeción de los animales, suelos antideslizantes y ausencia de desniveles facilitaran estas tareas
Área de alimentación: En las zonas de elaboración de alimentos también buscaremos el bienestar de los trabajadores, han de ser zonas amplias, evitar ruidos innecesarios maquinaria en buen estado y protocolos claros de cómo elaborar las diferentes raciones.
2 - Zonas de transito, aseo y vestuarios
Moverse por la granja, no debe convertirse en una carrera de obstáculos Los trabajadores tienen que entrar en los patios, salir a las salas de espera, entrar en los patios de los ter neros etc Es fácil a la hora de proyectar las instalaciones dejar previsto el instalar pasos para las personas, ello aportará comodidad en el trabajo y evitará lesiones y/o accidentes
En cuanto a los aseos y vestuarios, en mi opinión, son zonas imprescindibles en las instalaciones de las granjas actuales, así como su mantenimiento en óptimas condiciones Debemos proporcionar al trabajador facilidades para el cuidado personal, ello dignificará la profesión y mejorará la imagen social.
3 - Zonas de descanso y esparcimiento
En todas las empresas deberían existir espacios de descanso y esparcimiento
Ello mejora la interrelación de las personas, aumentara la motivación y les hará sentir que su trabajo es valorado y reconocido.
Un pequeño local o habitación donde los trabajadores puedan cómodamente tomar un café, el bocadillo de media mañana o simplemente comentar incidencias del trabajo o noticias cotidianas, da solidez a los equipos y genera confianza entre los operarios y los responsables de la explotación
El objetivo de estas zonas es demostrar a las personas que: te importan, creas interés, controlas, facilitas relaciones y creas vínculos
4 - Gestión del tiempo libre
En el presente no podemos hablar de bienestar sin tratar el tema del tiempo libre
Organizaremos la granja con el objetivo de aumentar eficiencia y eficacia de la mano de obra pero también buscando facilitar el tiempo libre que les corresponda. Vacaciones, fines de semana, días festivos



Transitar por la granja no debe convertirse en una carrera de obstáculos; por comodidad y seguridad hay alter nativas
Para conseguirlo planificaremos bien las tareas, protocolos, tur nos de trabajo y tur nos de sustitución
En definitiva:
• No nos confor memos solamente con “estar” en esta profesión tenemos que “bienestar”
• Apliquemos el concepto de “ergonomía” , que significa buscar la manera de que el puesto de trabajo se adapte al trabajador en lugar de obligar a este a adaptarse a aquel Debemos hacer todo lo posible por suprimir del ámbito laboral las situaciones que puedan provocar en los trabajadores incomodidad, fatiga o mala salud
• No debemos y no tenemos derecho a poner a nuestros jóvenes en la tesitura de elegir un trabajo que les gusta (ganadero) y/o renunciar al tiempo libre y a la sociedad del bienestar que por suerte nos toca vivir
• Promover el Bienestar dentro de una empresa muestra sus verdaderos beneficios en el momento en el que es comprendido e integrado dentro de la estrategia global De acuerdo con las nuevas investigaciones, los trabajadores tienen 8 veces más probabilidades de sentirse comprometidos y 3,5 de sentirse motivados cuando el BIENESTAR es una prioridad dentro del lugar de trabajo
• Y por último, como propietarios de una granja, démonos cuenta que invertir en mejorar las condiciones de trabajo significa invertir en mejorar nuestro negocio y sin duda mejorar nuestro propio bienestar ya que en la mayoría de las granjas de España somos nosotros, los que más horas pasamos en ellas
ANEMBE y Fr isona Española colaboran en este foro infor mativo que pretende ser la sección ANEMBE RESPONDE Aquí tienen cabida las preguntas que nor malmente se plantean al veter inar io en su actuación cotidiana en el campo



Aquellos ganaderos interesados en plantear cuestiones , las pueden enviar a la redacción de la revista Fr isona Española Desde aquí se trasmitirán a ANEMBE que las dir igirá a profesionales de prestigio de las diferentes áreas de la clínica y producción bovina y cuyas respuestas se publicarán en estas páginas
j/a 226 Frisona Española 85
El buen ambiente en el equipo de trabajo aumenta la productividad
T e m a r i o
El cultivo en granja: una herramienta para mejorar la salud de la ubre
La mastitis es la enfer medad que más pérdidas ocasiona en una explotación lechera; el simple hecho de tener una infección intramamaria hace perder mucho dinero a los productores de leche
Las pérdidas más importantes se deben a la pérdida en la producción de leche
Un hecho indudable es que la prevención de las infecciones intramamarias es lo más importante dentro de un Programa de Mejora de la Calidad de la Leche, de ahí que sea necesario controlar todos y cada uno de los factores que influyen en la mastitis Uno de los puntos dentro del Plan de los 5 Puntos desarrollado en los años setenta en el NIRD (National Institute for Research in Dairying), es el tratamiento precoz de todos los casos de mastitis; con esto se pretende intentar curar lo más rápidamente posible los casos de mastitis una vez que se ha producido una mastitis clínica También el NMC (National Mastitits Council) ha adoptado esta medida en su Plan de los 10 Puntos

Debemos conocer per fectamente cuáles son los patógenos mamarios principales de la explotación Esto deter minará en gran medida el tipo de antibiótico a usar a la hora de tratar el caso de mastitis clínica Un hecho al cual nos enfrentamos en
Luís Miguel Jiménez y Nuria Roger Servet Talavera. luismi-che@servettalavera.es
nuestra práctica diaria y que además es responsabilidad nuestra, es que debemos hacer un uso prudente de los antibióticos Nuestra obligación como veterinarios es usar cada uno de los antibióticos que tenemos a nuestro alcance con responsabilidad; hay que deter minar en cada momento cuál es el mejor antibiótico para el tratamiento de la mastitis Para esto es fundamental realizar un diagnóstico de la enfer medad y tratarla o prescribir el antibiótico adecuado Para ello, no solo debemos hacer diagnóstico; también debemos realizar algún antibiograma con el fin de conocer no solo la sensibilidad de los gér menes causantes de la mastitis, sino a qué antibióticos son resistentes esas bacterias
Desde hace unos años se conoce de la existencia de gran número de microorganismos que se están haciendo resistentes a deter minados antibióticos, principalmente debido a cambios o mutaciones en su material genético Esto va a acarrear problemas en la salud humana Desde la medicina veterinaria una medida de prevención sería intentar contribuir a la reducción de las resistencias antimicrobianas precisamente haciendo un uso prudente de los antimicrobianos
Organizaciones mundiales como la Organización Mundial de la Salud (OMS), la Organización de las Naciones Unidas para la Alimentación y la Agr icultura (FAO) y la Organización Mundial de Epizootías (OIE) han deter minado que los antibióticos son un bien público y que, por tanto, hay que usarlos racionalmente y preservarlos para el futuro por lo que pudiese ocurrir De esta manera se establecieron las listas CIA (Critically Important Antimicrobials), que contienen antibióticos por orden de importancia, basadas en el uso que se hace de ellos en medicina humana Mediante este criterio se establece el orden de prioridad y, por tanto, la importancia de preservarlos; en consecuencia, se debe reducir su uso en medicina veterinaria Ya no solo se trata de un problema de salud pública sino que también está involucrada la medicina veterinaria, es por eso que este gran reto debe afrontarse desde un frente común que en definitiva es la Salud como un gran todo
Dentro de la medicina bovina, aquí en España se pretende abordar el problema de las resistencias desde varios frentes Por un lado se espera que se retiren antibióticos a los cuales estamos acostumbrados a usar no solo para tratar mastitis sino otras muchas enfer medades como la metritis por ejem-
86 Frisona Española 226 j/a
Mastitis clínica)
plo Estamos hablando de las fluoroquinolonas y cefalosporinas (3ª y 4ª generación). Desde 2018 a 2021 se empezará con la reducción de fluoroquinolonas y desde 2022 a 2025 se seguirá con las cefalosporinas de 3ª y 4ª generación Por otro lado, dentro de las pautas de manejo se pretende limitar el uso metafiláctico que se hace, por ejemplo cuando se secan vacas, debido al hecho de que se están usando antimicrobianos en vacas que probablemente no estén infectadas.
Se necesitan herramientas de diagnóstico rápido, a ser posible en la propia explotación, que nos ayuden tanto a los veterinarios como a los productores a mejorar la salud del rebaño Este es uno de los puntos del Plan Nacional Frente a las Resistencias a los Antibióticos
El tratamiento de los casos de mastitis clínica en teoría es fácil; simplemente hay que saber a qué microorganismo nos enfrentamos, qué antibiótico usar en cada caso y, por último, conocer el historial de la vaca con mastitis para saber si es rentable o no tratarla Uno de los mayores problemas que existe no solo en España, sino en el resto de países del mundo, es el de no disponer de un sistema correcto de registros de los casos de mastitis Es imprescindible conocer el historial de las vacas en lo que a mastitis clínica se refiere, una vaca que ha tenido su primer caso de mastitis tiene cinco veces más probabilidades de que se repitan más casos que otra vaca que nunca tuvo un caso Por tanto, el objetivo es prevenir el primer caso de mastitis Sin un buen sistema de registro, es probable que tengamos vacas en nuestra explotación con más de 5 casos de mastitis en una sola lactación haciendo muy poco rentable esa vaca.
un caso de mastitis clínica se toma una muestra de leche, se siembra o cultiva y se incuba en la propia granja. Esto se puede realizar, por supuesto, en una cooperativa o en un centro veterinario y lo puede realizar cualquier persona que previamente ha sido entrenada para hacerlo sin necesidad de grandes aparatos El instrumental necesario es una estufa de cultivo e hisopos estériles para realizar la muestra El objetivo del cultivo no es otro que saber con qué antibiótico se debe tratar la mastitis dependiendo del microorganismo que crezca, es decir, dirigir de manera eficiente el tratamiento No se trata de deter minar qué microorganismo creció, es decir, llegar a deter minar el género y especie del microorganismo, esto lo hará posterior mente el laboratorio especializado en mastitis Por otro lado, sirve para concienciar y for mar al productor u ordeñador en materia de mastitis ya que él mismo va a ver el crecimiento bacteriano.
Las ventajas que tenemos al usar el cultivo en granja son las siguientes:
1- Toma rápida de decisiones en cuanto a qué antibiótico usar
2- Aumento de la tasa de curación de los casos de mastitis
3- Menor repetición de casos
4- Un menor uso de antimicrobianos .
5- Aumento de la rentabilidad debido a una menor repetición de casos y a un menor uso de antibióticos
6- Menos leche desechada
7- Mejora de la salud de la ubre
Un hecho indiscutible es que mediante este método precoz de diagnóstico la salud de la ubre mejorará y sobre todo repercutirá en la rentabilidad

Registro de casos de mamitis
Un hecho frustrante que ocurre ante un caso de mastitis es que en la mayoría de los casos no podemos esperar a tener un resultado laboratorial que nos diga qué microorganismo es el causante de la mastitis y con qué tratarla Esto se debe a que en el mejor de los casos, una muestra de leche que llega al laboratorio tarda un tiempo en procesarse, de 48 a 72 horas como mínimo sin contar el transporte Lógicamente cualquier mastitis se debe tratar antes esto es posible desde hace unos años con el denominado Cultivo en Granja , este tér mino viene del inglés “Culture on far m ” Esto quiere decir que ante

económica de la explotación Otra ventaja que influirá en la economía es el aumento en el ingreso de venta de la leche debido a que la leche descartada como consecuencia de un menor uso de antibióticos, será menor En resumen, podemos decir que mediante el uso del cultivo en granja disminuirán las pérdidas generadas por la mastitis y por tanto aumentará la rentabilidad de la explotación
El método consiste en sembrar una muestra de leche procedente de una vaca que tiene una mastitis clínica en una placa de cultivo con un hisopo de siembra estéril
j/a 226 Frisona Española 87
El cultivo en granja...


Biplaca
Las placas de cultivo nor malmente son biplacas o triplacas dependiendo de cuántas sean las divisiones de la placa, en esas divisiones es donde va alojado el medio de cultivo selectivo para el crecimiento de cada microorganismo Una vez que se ha sembrado la leche se deja incubar durante 1224 horas de media a 37,5 grados centígrados Transcurrido ese tiempo se procede a la lectura de la siembra En el caso de ser una biplaca en una parte

Tomar una muestra de un tubo estér il
Identificar la muestra con Nº de vaca y cuar to afectado
Sembrar las biplacas e incubar en la estufa a 37º
Congelar la muestra para envío al laborator io
Leer a las 12-18 horas
Sin crecimiento
Incubar 12-18 horas más
Sin crecimiento GRAM + GRAM -
Triplaca
crecerán los gér menes gram positivos y en la otra lo harán los microorganismos gram negativos. Dentro de los microorganismos gram negativos están la familia de las enterobacterias, tales como E coli, Klebsiella spp , Serratia spp , Enterobacter spp y Proteus entre otros, todos ellos patógenos mamarios mayores Los microorganismos gram positivos más representativos son los estafilococos y los estreptococos, dentro de los estafilococos están el Staphylococcus aureus y los estafilococos coagulasa negativos (SCN), los estreptococos más importantes causantes de mastitis son el Streptococcus agalactiae, el Streptococcus dysgalactiae, el Streptococcus uberis y los enterococos También hay otros microorganismos que crecen que no son bacterias, estos pueden ser Prototheca spp , que es un alga unicelular y hongos y levaduras todos estos crecen en el lado de los gram positivos.
En ocasiones se pueden utilizar triplacas de cultivo, en este caso existen tres divisiones, está indicado cuando en la explotación existe una problemática específica, por ejemplo cuando hay un problema de mastitis causada por Prototheca spp o por Staphylococcus aureus En estos casos se reserva un medio para los gram negativos otro para los gram positivos y un tercer medio selectivo o específico para el microorganismo en cuestión, con la finalidad de separar la vaca por ejemplo a un corral aparte y no tratarla
Una vez más la toma de las muestras de leche es fundamental, garantizando en todo momento la asepsia No se trata, como dijimos antes, de clasificar en género y especie a los microorganismos causantes de mastitis sino dirigir los tratamientos para aumentar la tasa de curación. Una vez que ha transcurrido un periodo de tiempo de entre 12 y 24 horas, podemos estar frente a tres escenarios diferentes: en el caso de haber crecimiento, bien es un gram positivo o un gram negativo o por el contrario no hay crecimiento Una vez que tenemos los resultados se debe proceder con el protocolo que haya en la explotación Cada granja deberá establecer los diferentes protocolos de tratamientos y estos deben ser realizados por el veterinario que asesore en temas de calidad de leche en la explotación, por el veterinario de la explotación o por el veterinario clínico (Ver esquema del protocolo junto a estas líneas)
Existe un elevado porcentaje de muestras en las que tenemos un resultado negativo o sin crecimiento estamos hablando de aproximadamente el
88 Frisona Española 226 j/a
GRAM + GRAM -
30% de los muestras En el laboratorio de Servet Talavera durante los años 2013, 2014 y 2015 se realizaron una media de 1 936 muestras de leche por año procedentes de casos de mastitis clínica hubo un 21,6%, un 19,3% y un 20,2% de cultivos negativos respectivamente en estos tres años. Muchos de estos casos se corresponden con casos de mastitis que en principio fueron causados por un gram negativo, lo que ocurre es que el ger men o no está o está en una baja concentración, lo que implica que no crezca; también puede ocurrir en el caso de trabajar con muestras congeladas
En teoría los casos en los que no hay crecimiento y muchos de los casos en los que crece un gram negativo no se deberían tratar con antimicrobianos, simplemente se pueden tratar con antiinflamatorios no esteroideos y con fluidoterapia En este caso, nosotros recomendamos tratar con un antibiótico ya que se incrementa la tasa de curación en más de un 10%; pero esta decisión una vez más hay que valorarla desde el punto de vista económico a nivel de granja por todos los actores implicados
Otra duda que se nos puede plantear y que preocupa a muchos productores es la necesidad de tratar el caso de mastitis lo más rápido posible, es decir, tratar la vaca nada más detectar el caso de mastitis Se podría pensar que las vacas tratadas en el momento en el que se ve la mastitis podrían tener un mayor éxito en la curación y, sobre todo, una menor tasa de repetición que las mastitis clínicas que se tratan transcurridas 24 horas (hasta que tenemos el resultado del cultivo) Esto no es así; en un estudio realizado en Estados Unidos en 4 rebaños comerciales de Dakota del Norte y Michigan demostraron que las vacas que se trataron nada más detectar la mastitis y aquellas en las que se realizó un cultivo en granja y se trataron a las 24 horas tuvieron una tasa de repetición de los casos muy parecidas
La eficacia del método del cultivo en granja está demostrada por muchos estudios Uno de los primeros trabajos realizados se hizo en la Universidad
de Madison-Wisconsin por Martín Pol En este estudio se estudió la especificidad y sensibilidad del sistema con un total de 189 cuartos con mastitis clínica La sensibilidad del método fue del 74% (la probabilidad de detectar una bacteria susceptible de tratar con antibióticos) y la especificidad fue del 82% (en el 82% de los casos se detectó una bacteria que no era susceptible de tratar con antibiótico) Por otro lado se estudió la tasa de curación bacteriológica en los cuartos tratados y en los que no se trataron ya que fueron cultivos negativos Para ello se tomó una muestra a los 14 y a los 21 días de haber ocurrido el caso la tasa de curación fue de un 77% en los casos en los que se no se trataron con antibiótico y de un 87% en los casos en que se usó antibioterapia
Si se decide no tratar a aquellas vacas en las que no haya crecimiento cuando usamos el cultivo en granja obtendremos una indudable rentabilidad económica debido a un menor coste en los tratamientos En el estudio de Martín Pol fueron 3 300 dólares de ahorro debido a un menor consumo de antibióticos y también debido a un menor desecho o descarte de la leche
En un estudio realizado por el equipo de Servet Talavera en una explotación con aproximadamente 1 000 vacas en ordeño se evaluó los beneficios del uso del cultivo en granja Por un lado se estudió la sensibilidad y la especificidad del sistema y, por último, la tasa de curación basándose en el recuento celular en vacas en las que se usó cultivo en granja comparándola con otras vacas en las que no se usó el método, siendo un grupo control En esta explotación se usó una triplaca con un medio específico para Prototheca spp debido a que la prevalencia de los casos causada por este alga era alta y de esta manera, si crecía el alga, la vaca se segregaba sin tratar Se tomaron muestras de 173 casos de mastitis clínicas una vez que las muestras fueron cultivadas en la granja inmediatamente se congelaron para su posterior envío a nuestro laboratorio de diagnóstico para proceder a un análisis microbiológico completo La sensibilidad del método de diagnóstico del cultivo en granja fue del 75,6% y la especificidad fue del 90,1%

2.
3.
Método Efica z, Ráp ido y Económ ico pa ra el d iag nóstico de las mastitis, en la prop ia g ra nja.
1.
Resu lta dos en 12-24 horas.
Con tres sencil los pasos, decida el m ejor trata m iento pa ra sus a n ima les MÁS INFORMACIÓN: TLF. 657 914 574 m/j 226 Frisona Española 89
El cultivo en granja...

Para demostrar la eficacia del método del cultivo en granja se evaluó la tasa de curación de los casos de mastitis clínica, de este modo se establecieron dos grupos diferentes de vacas: las que se trataron con un cultivo previo conocido y las que se trataron sin saber el agente causal, este último grupo actuó como grupo control Se usó el recuento celular posterior al caso de mastitis clínica, estableciendo como una vaca curada aquella que tenía un recuento celular por debajo de 200.000 cel/ml. En cuanto a la curación de los casos, se comprobó que en el caso de los animales en los que se usó el cultivo en granja previo al tratamiento la tasa de curación fue del 50% y solamente el 20% de los animales en los que se trataron directamente sin saber el microorganismo causante de la mastitis
La herramienta del cultivo en granja tiene más utilidades, no solamente para dirigir los tratamientos de los casos de mastitis clínica. Por un lado, se puede usar para la selección de vacas a la hora de aplicar en la explotación un secado selectivo y por otro para dirigir los tratamientos de los casos de metritis en las vacas recién paridas
El secado selectivo es una estrategia que repercute en directamente en un menor uso de antibióticos es decir entra dentro del uso prudente de los antibióticos establecido por el Plan Nacional Frente a las Resistencias a los Antibióticos Para llevar a cabo un secado selectivo se necesitan herramientas y datos para poder hacerlo y, sobre todo, con el menor riesgo posible para la salud de la ubre De esta manera si una explotación es de bajo riesgo con respecto a la salud de la glándula mamaria, esto es si tiene un recuento regular en la leche de tanque por debajo de 250.000 cel/ml, no tiene problemas de patógenos mamarios contagiosos como Streptococccus agalactiae o Staphylococcus aureus, tiene buenos registros de mastitis y datos de recuentos celulares individuales, el secado selectivo es una opción de manejo La selección de vacas
para secar con y sin antibióticos dependerá de varios parámetros, por ejemplo que no haya tenido casos de mastitis en los tres últimos meses, últimos recuentos celulares por debajo de 200 000 cel/ml y en este caso un cultivo realizado en la explotación previo al secado con resultado de no crecimiento
Otra utilidad del cultivo en granja es para dirigir los tratamientos de los casos de metritis en las vacas recién paridas En muchos casos se hacen tratamientos parenterales con antibióticos, lavados intrauterinos con antibióticos o desinfectantes o simplemente se usan prostaglandinas o la combinación de estos Los microorganismos más representativos causantes de la metritis son los gér menes gram negativos E coli, Fusobacterium necrophorum, Fusobacterium nucleatum y Prevotella melaninogenicus y el representante de los gram positivos es Truperella pyogenes
La metodología es igual de sencilla que para el caso de la mastitis En este caso se toma una muestra de la secreción vaginal, se siembra en la biplaca y se incuba a 37,5 ºC, se espera de 12 a 24 horas y se hace la lectura Dependiendo que sea uno u otro el tratamiento de la metritis, puede ser completamente diferente y de esta manera si usamos el antibiótico adecuado estaremos aumentando la tasa de curación clínica, habrá menos días de periodo de supresión y mejorará también la fertilidad puesto que la vaca se podrá inseminar antes
El cultivo en granja es una herramienta eficaz que tienen a su disposición tanto los productores de leche como los propios veterinarios, la finalidad es dirigir de una manera eficiente los tratamientos de mastitis clínica de secado y de metritis con el objetivo de aumentar la tasa de curación de todos estos casos. De esta manera en el caso de la mastitis aumentaremos la tasa de curación, disminuiremos la repetición de los casos, se reducirá el consumo de antibióticos, se tendrá un menor periodo de supresión y por tanto una cantidad menor de leche descartada En el caso del secado, nos ayudará a hacer una mejor selección de las vacas elegidas para secar con y sin antibióticos Por último en el caso de las metritis, se hará un mejor diagnóstico que en la mayoría de los casos no se realiza, se hace un mejor tratamiento y se conseguirá un aumento de la fertilidad
La metodología es muy simple, el aparataje también y una persona entrenada puede realizar el cultivo en granja sin problemas y siempre debe estar supervisado por un veterinario responsable que en última instancia será el que establezca el protocolo de tratamientos a realizar.
Un hecho relevante es que de esta manera estaremos haciendo un uso responsable de los antibióticos que sin duda redundará no solo en la rentabilidad de la explotación, sino también en la responsabilidad social de la reducción de posibles resistencias a los antibióticos
Referencias
Alfonso Lago y col Use of On-far m Culture Systems in Mastitis Control Proceedings NMC Regional Meeting 2007
Martín Pol y col On-Far m Culture: Characteristics Of The Test Proceedings NMC Annual Meeting 2009
Nuria Roger y col Valoración del cultivo de muestras de leche en granja: resultados preliminares. Libro de ponencias, Congreso Inter nacional Anembe 2011
90 Frisona Española 226 j/a
Descarga vaginal

T e m a r i o
Conser vación de forrajes (VIII): Silos hor izontales y ver ticales
Introducción
La buena calidad del forraje recogido debe mantenerse durante su conservación Para ello, no sólo es necesario realizar el proceso de llenado y cierre del silo de manera correcta y eficiente sino que también es preciso disponer de un sistema de almacenamiento adecuado para minimizar las pérdidas de Materia Seca (MS) y de calidad Estas pérdidas son debidas a una respiración excesiva (sobrecalentamiento), producción de efluentes y deterioro aeróbico; pérdidas que pueden minimizarse durante el proceso de ensilaje y durante el almacenamiento y que serán objeto de un próximo artículo.
Hay una amplia variedad de sistemas para almacenar el forraje ensilado, tanto para forraje picado como para forraje empacado Todos ellos son capaces de mantener una buena calidad del forraje, si bien los sistemas dispuestos sobre la super ficie del suelo y basados en una cubierta de plástico para el mantenimiento de las condiciones anaerobias son habitualmente más adecuados para un almacenamiento a corto plazo, donde el forraje se va a utilizar en el año siguiente a su ensilado Este almacenamiento puede prolongarse añadiendo una segunda cobertura plástica para reducir la radiación ultravioleta En cualquier caso, si el plástico

Antonio Callejo Ramos Dr Ingeniero Agrónomo Dpto Producción Agraria
E.T.S.I. Agronómica, A. y de B.-U.P.M. antonio.callejo@upm.es
www linkedin com/in/antoniocallejoramos
http://blogs upm es/acallejo/
no se daña o deteriora, el almacenamiento puede ser muy prolongado (3-5 años)
El sistema elegido dependerá del equipamiento disponible, experiencia, coste económico (de construcción y de operatividad) sistema de alimentación, preferencia personal, tipo de forraje ensilado, tamaño del rebaño, flexibilidad y necesidades futuras
Hay un interesante trabajo de B J Holmes, de la Universidad de Wisconsin, donde propone un diagrama de flujo que puede ayudar a tomar la decisión adecuada Este trabajo puede encontrase en el siguiente enlace web: https://fyi uwex edu/forage/files/2014/01/DecidingSilo-1.pdf, donde también pueden encontrarse otras útiles referencias al respecto
T ipos de silos Tradicionalmente, los silos se han dividido en dos tipos: horizontales y verticales, donde se almacenan grandes volúmenes de forraje ensilado Sin embargo desde que aparecieron las máquinas que hacen grandes pacas, redondas o prismáticas, y la posibilidad de envolver estas pacas con plástico, se abrió la alter nativa de elaborar microsilos (cada paca) y flexibilizar su utilización, abriendo las bolsas que se necesitan diariamente
Por otra parte, la no muy antigua aparición de máquinas para introducir en largas bolsas cilíndricas el forraje a ensilar abrió otra interesante y económica posibilidad, que evitaba la gran inversión que suele suponer la construcción o instalación de silos con paredes de hor migón o silos verticales de material metálico resistente al ácido láctico del ensilado
Silos horizontales
Sus principales características son:
• Altura inferior a la menor de sus otras dimensiones.
• Coste inferior a los silos verticales
• Mayor necesidad de mano de obra y de maquinaria para su llenado
• Necesidad de cubrirlos con un material que evite la entrada de aire (plástico)
• Elevadas pérdidas en MS (10-30%)
El silo almiar es el modelo más elemental. Consiste en amontonar el forraje sobre el suelo, compactándolo y recubriéndolo con un plástico Se debe realizar sobre zonas elevadas con el fin de facilitar el escurrido de los jugos También es interesante colocar sobre el suelo una capa de paja que evite la posterior contaminación con tierra al utilizarlos y que pueda absorber total o parcialmente los
92 Frisona Española 226 j/a
efluentes generados si es que no se hor migona el suelo (Figuras 1 y 2). Pueden ser de tamaño y altura muy variables.
Su coste es bajo pero dejan penetrar fácilmente el aire en su interior, por lo que las pérdidas pueden ser elevadas Su empleo no es recomendable más que para forrajes fácilmente ensilables como la planta entera de maíz o de gramíneas Cuando éstas se ensilan con un bajo porcentaje de MS la producción de efluentes es elevada.
Si los extremos no están bien saneados, se for ma barro fácilmente, no siendo posible el consumo directo del ensilado por el ganado (autoservicio) y se hace difícil el empleo de desensiladores mecánicos
Cuando estos silos son de pequeña a mediana capacidad (<200 m3) ocupan una super ficie relativamente grande (unos 10 m2/t de MS de hierba) ya que su altura máxima no suele exceder de 1 5 m (para poder compactar con suficiente seguridad). Su rendimiento de llenado es bajo por el tiempo que se emplea en el reparto y apisonado del forraje, cuando se realiza de for ma correcta
El silo zanja consiste en una excavación de sección trapezoidal practicada en el terreno cuya base inferior es de menor anchura Aunque su coste es bajo, presenta algunos inconvenientes como riesgos de infiltración de agua, dificultades de drenaje y riesgos de contaminación del ensilado con tierra
Estos problemas pueden evitarse revistiendo las paredes y el suelo con un plástico u otros materiales que eviten desmoronamientos y humedades
Cuanto menos consistencia tenga el terreno, menos pendiente tendrá que tener el talud; es decir las paredes laterales deben ser menos verticales.
El silo trinchera (Figura 3) está constituido por una solera de hor migón sobre la que van dos muros paralelos, habitualmente también de hor migón armado u hor migón prefabricado, de hasta 1,2-1,5 m ó 1,8-2,0 m de altura, en el caso de autoservicio de ovino o vacuno respectivamente Estos muros pueden llegar hasta los 4-5 m de altura cuando se utilizan desensiladoras (o el propio cargador frontal del tractor) El suelo de hor migón, deberá tener una pendiente suficiente (1-2%) hacia el frente de ataque El extremo opuesto puede ser cerrado o abierto
En el extremo de ataque es aconsejable prolongar el suelo de hor migón unos 5-10 m con el fin de facilitar la descarga del alimento evitar la for mación de barro, facilitar, en su caso, el acceso al ganado, y evitar el contacto del forraje con la tierra.
La anchura mínima será de 5 m para poder apisonar correctamente con un tractor, necesitándose unos 25 cm por cabeza de bovino si se utiliza el autoservicio
Ubicación de silos horizontales
A diferencia de otros sistemas de almacenamiento, los silos zanja y trinchera son estructuras permanentes y no pueden ser cambiados de ubicación1 Por ello, deben considerarse los siguientes factores cuando se decida su ubicación:
• Deben situarse próximos a donde van a ser utilizados, es decir, cerca de la ubicación del ganado
1 Los silos trinchera construidos mediante paneles de hor migón prefabricados podrían ser una excepción En todo caso mover estos pesados paneles requiere tiempo, maquinaria apropiada y corren el riesgo de deteriorarse


• Evitar zonas bajas, las cuales pueden inundarse o estar demasiado húmedas y blandas en tiempo lluvioso
• Fácil acceso a la maquinaria cuando se llena y cuando se vacía
• Alejados de manantiales y de cursos de agua que pudieran contaminarse por la escorrentía de los efluentes generados en el silo.
• Evitar colocarlos bajo líneas telefónicas o eléctricas y sobre conducciones de suministro enterradas (agua, gas, etc ) Evitar también la cercanía de fuertes pendientes
• En zona libre de árboles
• Evitar zonas donde pueda llegar el agua de escorrentía Si es inevitable habrá que colocar sistemas de drenaje alrededor del silo o, al menos, por el lado desde el que pueda llegar el agua.

j/a 226 Frisona Española 93
Figuras 1 y 2 Silos almiares
Figura 3 Silo trinchera
Silos hor izontales y ver ticales
Dimensionamiento de silos horizontales
El adecuado dimensionamiento de un silo es de gran importancia, pues de ello dependerá conseguir un consumo diario suficiente de alimento para limitar las pérdidas por oxidación de parte del forraje ensilado Para un correcto dimensionamiento es necesario deter minar, en primer lugar, las necesidades de los animales a los que se va a alimentar, deter minando la cantidad de forraje a ensilar a partir de dichas necesidades. Siempre hay que considerar que va a haber pérdidas de material ensilado, por lo que, en rigor, habría que dividir esas necesidades de consumo de forraje entre el tanto por uno de forraje utilizable O lo que es lo mismo, dividir entre 1 menos el tanto por uno de pérdidas consideradas)
También se puede fijar el volumen de ensilado conociendo el forraje producido en la explotación si es este el caso.
Conviene que la anchura del silo sea, al menos, de 5-6 m, para facilitar la compactación del forraje por el tractor o maquinaria empleada Asimismo, si el silo va a ser utilizado en régimen de autoservicio, la altura del silo también estará limitada a 1,2-1,3 m (en ovino) o a 1 8-2 0 m (en bovino)
Brian y Holmes (1997) propusieron un método para dimensionar silos horizontales, zanja o trinchera, asumiendo que las paredes laterales del silo son verticales Este método consta de los siguientes pasos:
1 Establecer la cantidad total diaria de ensilado que necesitan los animales, considerando el porcentaje de pérdidas inevitables
Cantidad de ensilado necesar ia (kg MS/rebaño) = Ingestión (kg MS/rebaño)
Cantidad de ensilado necesar ia (kg MS/día) = Ingestión diar ia (kg MS) 1- (% pérdidas)⁄100)
2 Deter minar una tasa de utilización del silo (cm/día) es decir velocidad de avance del frente de ataque.
3 Deter minar un altura del silo (m)
4 Calcular la anchura del silo mediante la siguiente ecuación:
Cantidad de silo necesaria
Anchura (m) =
Avance diario Kg día cm m x densidad x altura silo (m) ( ) cm día ( ) x 100 kg m3 ( )
Si la anchura resultante es inferior a 5 m, rehacer el cálculo con una menor altura de silo
5 Deter minar el período de almacenamiento (días)
6 Calcular la longitud del silo mediante la siguiente ecuación:
que debe calcularse la super ficie de ataque teniendo en cuenta la fór mula del área de un trapecio2 .
Densidad del silo
Para minimizar las pérdidas en silos horizontales, ya hemos comentado en trabajos anteriores que el forraje debe compactarse lo máximo posible para eliminar rápidamente el oxígeno contenido en la masa de forraje que se está ensilando. Cuanto más se compacte el forraje, mayor será la densidad que se alcanza y menores serán las pérdidas de MS (Tabla 1)
Cuanto mayor es la densidad, menor será la porosidad de la masa del silo Esta porosidad podría definirse como la medida de huecos vacíos existentes entre las partículas sólidas del forraje Si el gas que llena estos huecos es CO2 éste desplaza al oxígeno y contribuye a mantener un medio anaerobio, por lo que es preciso expulsar el oxígeno al ensilar y que el mínimo remanente sea consumido rápidamente en la actividad respiratoria del forraje al inicio del proceso de ensilado
Tabla 1

Medir la porosidad no es sencillo en el laboratorio y probablemente imposible en condiciones de campo Richard y col (2004) desarrollaron una ecuación que relaciona la porosidad (en %) con la densidad (en kg de MF/m3) Esta ecuación sirvió para elaborar el gráfico de la figura 4 De esta figura se concluye que la porosidad depende fundamentalmente de la densidad del forraje en el rango de contenido en MS recomendado (30-40%) para el ensilado en silos horizontales y en bolsas.
Figura 4. Gráfico que relaciona la porosidad frente al contenido en MS para distintas densidades de forraje ensilado
Porosidad vs % de MS
Longitud (m) =
Avance del silo 100 cm /m cm día ( ) período de almacenamiento (días)
Si la longitud es mayor de 50 m, considerar la construcción de varios silos de menor longitud Cuando las paredes del silo son completamente verticales, la sección es rectangular. Si las paredes no son verticales, la sección es trapezoidal, por lo
Materia Seca
2 Área de un trapecio: (B+b)*h/2, donde B es la longitud de la base mayor, b la longitud de la base menor, y h la altura.
94 Frisona Española 226 j/a
Densidad (kg MS/m3) % de pérdidas de MS (180 días) 160 20,2 225 16,8 240 15,9 255 15,1 290 13 4 350 10,0
x
. Densidad del silo y pérdidas de MS
0 80 0 70 0 60 0 50 0 40 0 30 0 20 0 10 0 00 0 3 0 35 0 4 0 45 0 5 0 55 0 6 0 65 0 7 P o r o s i d a d
Densidad (kg MF/m3)
Tabla 2 Porosidad y Densidad (kg MS/m3)

Holmes y Muck (2004) recomendaron una densidad mínima de 225-240 kg MS/m3 como un valor razonable de alcanzar y evitar una excesiva pérdida de MS y de calidad. De la Tabla 2 se infiere que la porosidad varía considerablemente (20-60%) para distintas combinaciones de contenido en MS y de densidad del forraje que dan lugar a ese valor recomendado de densidad o superior (valores en negrita) Teniendo en cuenta los valores de la tabla, parece recomendable conseguir una porosidad del 30 al 40%. Sin embargo, dado que la porosidad es relativamente más constante para un valor dado de densidad (en kg MF/m3) que para valores de densidad (en kg MS/m3) y que la densidad del silo es más fácil de medir que la porosidad, es preferible hacer recomendaciones en base a la densidad del silo (en kg MF/m3) Un valor mínimo de 700 kg MF/m3 mantiene la porosidad por debajo del 40% dentro del rango recomendado de contenido en MS
Ejemplo: Si se quiere alcanzar una densidad en el silo de 800 kg MF/m3, ¿qué densidad (en kg MS/m3) debería conseguirse? De la Tabla 2 se deduce que un forraje con el 30% de MS puede ser compactado hasta alcanzar 240 kg MS/m3, pero si ese forraje tiene un 40% de MS tendría que ser compactado hasta alcanzar un valor de 320 kg MS/m3, lo que es una tarea bastante más difícil En ambos casos, la porosidad se sitúa alrededor del 30%.
Para mantener una porosidad inferior al 40%, se necesita un mínimo de 700 kg MF/m3
Holmes (1999) propuso un interesante método para deter minar si las condiciones de ensilado permiten alcanzar esa densidad mínima de 240 kg MS/m3, teniendo en cuenta que la compactación
(y, por tanto, la densidad) está positivamente correlacionada con el peso de la maquinaria empleada en la misma, el tiempo de compactación y con el propio contenido en MS del forraje. Asimismo, la densidad está negativamente correlacionada con el espesor de las capas de forraje que se van extendiendo para su compactación
Según este método, si no se alcanza esa densidad mínima, deberían adoptarse alguna o algunas de las siguientes medidas:
a) Reducir la tasa de llenado del silo (t/h) para así aumentar la tiempo de compactación (min/t).
b) Incrementar el porcentaje de MS per mitiendo un mayor tiempo de secado en el campo
c) Incrementar la altura de llenado del silo
d) Incrementar el peso de los tractores añadiendo contrapesos o agua en las ruedas, o sustituirlos por tractores de mayor peso
e) Añadir más tractores compactando sin reducir el peso de los mismos.
f) Reducir el espesor de las capas de forraje que se distribuyen y compactan
g) Compactar durante más tiempo
Silos verticales
No son muy habituales en España, pero son muy populares en Estados Unidos (Figura 5) Presentan las siguientes características generales:
• Suelen ser cilíndricos, predominando la altura sobre sus otras dimensiones
• El espacio de terreno que ocupan es 6-8 veces inferior al de los silos horizontales
• Per miten la mecanización de todas las operaciones de carga, descarga y distribución

j/a 226 Frisona Española 95 Densidad del silo (kg MF/m3) 480 560 640 720 800 880 % MS Densidad Máx (kg MS/m3) Densidad Máx (kg MF/m3) Porosidad (%)(Densidad, kg MS/m3) 25 270 1 090 56 (120) 49 (140) 41 (160) 34 (180) 27 (200) 19 (220) 30 330 1.110 57 (145) 50 (170) 42 (190) 35 (215) 28 (240) 21 (265) 35 385 1 130 58 (170) 51 (195) 43 (225) 36 (255) 29 (280) 22 (310) 40 460 1 155 58 (190) 51 (225) 45 (255) 38 (290) 31 (320) 24 (350) 45 480 1 175 559 (215) 52 (255) 46 (290) 39 (325) 32 (360) 25 (400) 50 600 1 200 60 (240) 53 (280) 47 (320) 40 (360) 33 (400) 27 (440)
en función de la densidad del silo (kg MF/m3) y del contenido en MS

• La masa ensilada es compactada por su propio peso
• Fácil protección frente a lluvias y escorrentías
• Per miten una mejor conservación del alimento que los horizontales por su menor super ficie de contacto con el aire y su mayor her meticidad.
• El coste por metro cúbico es 3-4 veces más elevado que el de los silos horizontales, a los que hay que añadir los mecanismos de extracción y distribución Por ello, su coste de instalación debe ser compensado por el menor coste de las operaciones de llenado vaciado y distribución y por un período largo de amortización (al menos, 30 años).
El diámetro de estos silos verticales oscila entre 4,5 y 9 m, interesando que la altura sea la mayor posible para asegurar un buen prensado (15 metros es una altura habitual) El material más habitual actualmente es el acero, generalmente galvanizado o con esmalte vitrificado para resistir la acidez del ensilado
El flujo de ensilado puede ser continuo, para lo que se requiere que se vaya desensilando por la parte inferior y cargando por la superior, o discontinuo, donde la carga y descarga se realiza por la parte superior El flujo continuo aumenta su rentabilidad de uso, pudiéndose llenar en cualquier momento del año La desensiladora, colocada en la pate inferior debe ser mecánicamente robusta para soportar la gran presión de la masa forrajera que tiene encima. El interés mayor de estos silos verticales está en la conservación de forraje semiseco (40-45% de MS), que deberá estar adecuadamente picado para no dificultar la “autocompactación”
Dimensionamiento de silos verticales
El dimensionamiento de los silos verticales sigue un procedimiento similar asumiendo una utilización de al menos 10 cm diarios de espesor de silo de la zona inferior del mismo (cuando el vaciado es por esta zona) Ya que la densidad varía con la altura del silo (sobre todo en la mitad superior), cuando el vaciado se realiza por esta zona debe avanzarse más de 10 cm/día
1 La ecuación usada en el paso 1 en el caso de silos horizontales puede utilizarse también aquí aunque el porcentaje de pérdidas de MS es probablemente menor en silos verticales que en los horizontales
2 Si el silo tiene más de 10 m de altura, se asume que la densidad en la base del silo estará en tor no a 340 kg MS/m3
3. El diámetro del silo se obtiene de la siguiente ecuación:
Necesidades de MS
3,14 x 340 kg D = Kg día cm m MS m3 ( ) x 100 x 10 cm/día x 4
Si D >9 m, habrá que recalcular el diámetro introduciendo un valor más alto en el avance del silo, excepto si hay posibilidad de encontrar desensiladoras con el diámetro obtenido
4 Deter minar el período de almacenamiento (días)
5. Calcular la cantidad necesaria a almacenar utilizando la ecuación siguiente:
Q(kg MS) = Necesidades diarias (kg MS/día) x período de almacenamiento (días)
Considerando que un silo es un cilindro cuyo volumen se calcula mediante la fór mula:
V(m3) = 3 14 x (D/2)2 x h
siendo D el diámetro (m) y h la altura del silo (m) y que la densidad del forraje ensilado oscilará entre 240 y 340 kg MS/m3, es fácil deter minar la cantidad de MS que se puede almacenar en un silo de diámetro y altura deter minados Es cierto que la densidad del forraje en un silo vertical se ve afectada por la altura del silo, su diámetro, el contenido en humedad y por la fricción con las paredes del mismo Sin embargo una estimación simplificada de la densidad (kg MS/m3) como función únicamente de la altura puede ser suficiente.
La ecuación siguiente estima la densidad media en un silo vertical, tanto para silo de maíz, de hierba o de alfalfa, en un rango de alturas (H) entre 9,1 y 33,5 m:
Densidad (kg MS/m3) = 350 – 150-0,07(H-9,1)
La capacidad del silo (kg MS) puede ser estimada conociendo el diámetro interior del mismo:
C (kg/MS) = Densidad (kgMS/m3) x (πD2H/4)
Resumen
En este trabajo hemos explicado los dos sistemas de almacenamiento más clásicos si bien los silos verticales no son muy frecuentes en nuestro país. Se han comentado las principales características de estos sistemas, así como algunas metodologías de cálculo para su dimensionamiento y la deter minación de su capacidad En un próximo trabajo abordaremos el sistema de ensilado en bolsas, tanto en grandes bolsas como el embolsado individual de rotopacas; ambos sistemas son cada vez más frecuentes por su competitivo coste su flexibilidad de uso y su fácil adaptación a diversos tamaños de rebaño
hor izontales y ver ticales 96 Frisona Española 226 j/a
Silos
Figura 5 Silos verticales
Información y solicitudes en CONAFE
Tlf.: 91 895 24 12 y en la web
www.conafe.com

Incluye:
Filiación con progenitores genotipados
Determinación de Genes Recesivos (BLAD, DUMPS, CVM, Citrulinemia y Mulefoot)
Determinación de Haplotipos (HH1, HH2, HH3, HH4, HH5, HDC)
Factor Rojo y Rojo Dominante
Infertilidad
Polled
Proteínas (Beta Caseína, Kappa caseína y Beta-Lactaglobulina)
Obtenga las valoraciones más fiables de sus novillas al integrar toda la información recogida en granja
* Precio para muestras de sangre o cartílago Muestras de pelo: 35€ IVA no incluido
T e m a r i o Mycoplasma bovis, “una bacter ia de moda”
Recientemente en los medios de comunicación, tanto especializados como generalistas, apareció la noticia de que la primera ministra de Nueva Zelanda, Jacinda Ardern, había tomado la decisión de sacrificar más de 150 000 vacas y ter neros para erradicar la bacteria Mycoplasma bovis. La bacteria se detectó por primera vez en la Isla Sur hace jus-

Juan Vicente González Martín.
DVM, PhD, Dipl. ECBHM.
Profesor T itular Dpto. de Medicina y Cirugía Animal, Facultad de Veterinaria, UCM TRIALVET Asesoría e Investigación Veterinaria, S.L. www.trialvet.com.
tamente un año y en el momento de tomar la decisión se había identificado su presencia en 192 de las 200 000 granjas del país Para llevar a cabo la erradicación se consensuó un plan con la asociación de ganaderos lecheros DairyNZ y la de productores de carne Beef+Lamb New Zealand. El programa tendrá una duración de 10 años y un coste de 526 millones de euros, sufragado en dos tercios por el gobierno y el tercio restante por los ganaderos
Nueva Zelanda, con aproximadamente la mitad de extensión que España y con diez veces menos habitantes, 4,5 millones, tiene en la ganadería su principal industria Los productos lácteos representaron en el 2009 el 21% de sus exportaciones (9100 millones de dólares) y los cár nicos el 13,2 %. Unas medidas tan drásticas sólo se justificarían por la importancia del sector y por la gravedad del problema Que en ese país el sector ganadero es importantísimo no cabe la menor duda, pero el problema ¿Es tan grave como para tomar esas medidas?
Todo el mundo ha oído hablar de otras enfermedades del ganado bovino en las que su control supone costes enor mes Enfer medades que se decide erradicar bien sea por su riesgo zoonótico como por ejemplo la tuberculosis, la brucelosis, la enfer medad de las vacas locas, etc ; o bien por su riesgo epizoótico como la perineumonía, la glosopeda, la lengua azul, etc
¿Pero qué tipo de r iesgo supone la bacter ia Micoplasma bovis?
Micoplasma bovis no causa ninguna enfer medad en los seres humanos, no es una zoonosis No afecta a la seguridad alimentaria, la carne, la leche y derivados de los animales portadores puede ser consumida sin problema, en ese aspecto podemos estar completamente tranquilos Tampoco causa epizootias en el ganado por la sencilla razón de que es ubicua, se encuentra en todo el mundo y en muchas granjas, especialmente en cebaderos La bacteria es endémica en todo el mundo menos en Noruega y hasta el año pasado en Nueva Zelanda
Esta bacteria se identificó por primera vez en 1961 en un cultivo de leche de una vaca con mastitis en los Estados Unidos de América Desde entonces se ha ido identificando por todo el mundo incluida, claro está, España.
¿Qué enfer medades tan impor tantes causa esa bacter ia para que Nueva Zelanda decida afrontar esa costosísima erradicación?
Como ya hemos dicho causa mastitis en las vacas adultas También da lugar a neumonía, otitis y artritis especialmente en los ter neros tanto de re-
98 Frisona Española 226 j/a
Ter nera con otitis en los dos oidos
cría lechera como de cebo Y en menor medida infecciones reproductivas y abortos.
Mycoplasma bovis pertenece a la clase de los Mollicutes, son bacterias pequeñísimas, sin pared celular –en su lugar tienen una membrana- que no les per mite vivir libres, por lo que son parásitos intracelulares Y aunque pueden encontrarse en animales sanos, cuando producen enfer medad, esta es muy difícil de curar y en muchas ocasiones imposible, dando lugar a enfer medades crónicas que dejan a los animales totalmente improductivos. Además, los animales que superan la enfer medad, al igual que los sanos, per manecen portadores y por lo tanto con capacidad para contagiar a otros
Puesto que no tienen pared celular, los antibióticos que ejercen su efecto dañando la pared bacteriana no les afectan ese es el caso de los betalactámicos como la penicilina amoxicilina ampicilina o las cefalosporinas. Pero incluso los antibióticos que in vitro, o sea en cultivos de laboratorio, muestran efecto frente a los micoplasmas, en la práctica no son muy eficaces, siendo necesarios tratamientos muy largos que en la mayoría de las ocasiones no tienen mucho sentido ya que los animales no recuperarán su productividad Además como su tratamiento conlleva aplicaciones durante mucho tiempo de antibióticos, se corre el riesgo de generar más resistencias. Por si todo esto no fuera suficiente, tampoco existen vacunas realmente eficaces
El contagio se produce de diversas maneras Los ter neros no se contagian en el útero de la madre, pero si lo hacen por vía oral al tomar el calostro o leche de vacas enfer mas En el contagio por vía

Entre los animales crónicos muertos se encuentra con frecuencia a bacteria
oral el primer signo de enfer medad que se suele observar es la otitis, veremos terneros con una o las dos orejas caídas Posterior mente el contagio es por contacto directo de un animal a otro Y aunque la bacteria no sobrevive fuera de su hospedador puede transmitirse en el momento del ordeño a través de las manos del ordeñador o por la máquina de ordeño Hay animales sanos portadores de la bacteria, especialmente en ter neros En ellos la bacteria puede encontrarse en la garganta, pero si enfer man de neumonía por otro virus o bacteria el micoplasma actuará como complicación secundaría Alrededor de uno de cada tres ter neros porta-

“Mycoplasma bovis”

dores puede llegar a desarrollar neumonía especialmente si el manejo no es adecuado. Las vacas adultas contagiadas de micoplasma pueden permanecer sanas incluso más de un año y después, ante una bajada de defensas como puede ser la que acompaña al parto, enfer mar de mastitis y contagiar a otras vacas
Por todo ello lo nor mal es que cuando se diagnostica un animal enfer mo lo más común es que se le envíe al matadero, si ello es posible.
La mastitis por micoplasma puede presentar distintos cuadros clínicos y epidemiológicos, pero suele ser altamente contagiosa, puede afectar a los cuatro cuarterones y produce un cese casi total de la producción láctea Muchas veces la vaca continúa comiendo nor malmente, aunque en ocasiones presentará también cojera por artritis
En ter neros mamones que se contagian al tomar leche o calostro de vacas infectadas puede aparecer otitis media en uno o ambos oídos

Los nódulos caseonecróticos son muy característicos de la enfer medad
En ter neros de recría y de cebadero puede darse la for ma respiratoria por contagio directo entre ellos. Puede originar neumonía primaria o, como hemos dicho antes, secundaria a infecciones pulmonares por bacterias más comunes como Pasteurella multocida o Mannheimia haemolytica Estos ter neros con neumonía por micoplasma también pueden desarrollar otitis y artritis El contagio se ve favorecido por el estrés siendo especialmente problemáticos la alta densidad de animales, el ambiente frio y húmedo, la mala ventilación y la presencia de neumonías previas En los cebaderos de ter neros es muy común encontrar nos casos de neumonía por micoplasma en los animales crónicos de las enfer merías y en los fallecidos
A nivel de granja son factores de riesgo el tamaño de esta cuanto más grande más riesgo y sobre todo la compra de animales Teniendo en cuenta que los animales enfer mos no tienen cura, la bioseguridad es de capital importancia en el control de las micoplasmosis La identificación temprana de los animales enfer mos y su posterior aislamiento o sacrificio son las medidas profilácticas recomendadas y en las granjas que no esté presente la bacteria la bioseguridad estricta es fundamental Estas son las medidas que va a aplicar Nueva Zelanda.
Diagnóstico
Se puede diagnosticar la enfer medad de muy diversas maneras A nivel de rebaño se puede muestrear la leche del tanque, tomando una muestra y haciendo cultivos microbiológicos o PCR para detectar la bacteria o bien detectar anticuerpos frente a micoplasma por ELISA.
A nivel individual, en las vacas se pueden hacer los mismos análisis en leche y ELISA en suero sanguíneo En los ter neros se puede hacer ELISA en suero, se pueden tomar muestras con hisopos nasales de la nasofaringe y hacer cultivos o PCR y en el animal muerto tenemos que realizar la necropsia y observar las lesiones de pulmón oído medio o articulaciones y hacer estudios histológicos inmunohistoquímicos cultivos o PCR. Las lesiones, especialmente las de pulmón, son muy características ya que estos presentan nódulos de dos a diez milímetros de diámetro –a veces más grande por confluencia de varios pequeños– de pus espeso, sólido, blanco amarillentos, semejante a queso, denominados nódulos caseonecróticos muy característicos
Para evitar el contagio oral la mejor medida es pasteurizar el calostro y la leche que se les da a las ter neras Prácticas muy peligrosas en la alimentación de los ter neros son la mezcla de calostros o leche y el uso de leche de vacas enfer mas, especialmente por mastitis, estos animales son los que más micoplasma excretan por la leche, salvo que esta esté pasteurizada
Si no tenemos pasteurizadora podemos usar leche en polvo o, como último recurso, acidificar la leche con ácido cítrico Manteniendo la leche ácida, con un pH por debajo de 5 durante más de ocho horas se controla la infección Para ello se añadirá el ácido en la leche hasta alcanzar un pH de 4,5 que se puede medir con un pehachímetro o con tiras de papel reactivo Un pH menor de 4 hace que la leche se coagule y además las terneras la rechazan. La dosificación es de 5,5 gramos de ácido cítrico por litro de leche entera que deberá estar a una temperatura de 10 a 24 grados centígrados o incluso menor El ácido se debe echar pulverizándolo por encima mientras la leche se remueve sua-
100 Frisona Española 226 j/a
El micoplasma en el pulmón produce una bronconeumonía
vemente para evitar la coagulación El yogur también acidifica la leche, pero necesita calor y más tiempo. El uso de sorbato potásico como conservante no es eficaz frente a los micoplasmas
El contagio es por contacto directo entre animales, la bacteria no se transmite por vía aérea Por ello mantener el aislamiento de nuestros animales es fundamental, especialmente en los animales más jóvenes y en las vacas en lactación Los animales enfer mos y los sanos portadores deben separarse, las ter neras a una enfer mería y si se llegan a curar no destinarlas a la producción láctea; las vacas positivas, si no son productivas, hay que enviarlas directamente al matadero; si son muchas, y aún producen leche, hay que tenerlas en corrales separados y ordeñarlas las últimas, e idealmente en otra sala de ordeño; una vez acabada la lactación también se enviarán al matadero
Si la granja está libre de la presencia de micoplasma hay que aplicar medidas de seguridad que servirán también para muchas otras enfer medades Con las granjas vecinas es necesario un doble vallado de al menos dos metros de separación que evite el contacto morro con morro
Igual que sucede con otras enfer medades infectocontagiosas el mayor riesgo es la compra de animales. Si se compran de una única explotación el riesgo es menor que si se hace la compra en varias granjas, en mercados, en centros de recogida, subastas, etc En la granja de origen se puede analizar la leche de tanque como se ha indicado anterior mente
Los animales individuales también pueden ser analizados antes de la compra o en nuestra granja pero deben ser alojados en cuarentena hasta que se compruebe que están sanos. Existe el problema de la excreción inter mitente en la leche, un animal portador, en una muestra única de leche puede no excretar bacterias y por lo tanto no crecer en un cultivo Para evitar esto se puede hacer análisis de ELISA en sangre o repetir cultivos o PCR en leche De todas for mas siempre que se introduzcan animales nuevos en la granja o si los nuestro pueden tener contacto con animales vecinos, hacer análisis periódicos de leche de tanque es una opción fácil y barata Cualquier animal nuestro que salga de la granja y después regrese debería tratarse como un animal comprado
La bacteria no se transmite con otros animales, aunque existen dudas con las ovejas y las cabras Tampoco se transmite por medio de alimentos como pienso, heno o silo. Pero los utensilios utilizados para dar la leche a los ter neros pueden servir de vector si se contaminan con leche de animales positivos
Si el nivel de células somáticas de nuestra leche de tanque es bajo y en la recría no tenemos problemas de neumonías, otitis y artritis que no se curan, con una gran probabilidad en nuestra granja no habrá micoplasma. No introduciendo animales nuevos en la granja, unas medidas nor males de bioseguridad serán suficientes Pero si compramos animales Mycoplasma bovis es uno de los gér menes que deberemos tener en consideración sino queremos sufrir graves pérdidas en la explotación




















El precio: por solo tengo toda la infor mación de las ter neras genotipadas Además, con el incrementado del número de evaluaciones, los animales pueden tener su prueba con menos edad.
Confir mo la genealogía y se arreglan errores, si los hubiera, ya que el genotipo per mite identificar correctamente más del 95% de las muestras problemáticas.
Las hembras se reevalúan tres veces al año, lo que per mite incorporar toda esa nueva infor mación y que la prueba sea lo más fiable en cada momento de su vida.
Las evaluaciones de mis vacas superarán el 80% de fiabilidad, lo que per mitirá mejorar también las valoraciones de su descendencia tanto antes de genotiparse como posterior mente
Es la única evaluación genómica que puede incorporar la infor mación de la granja a través de la combinación con la prueba tradicional Así tiene en cuenta cómo se comporta esa familia de vacas en mi explotación.
Cada año aumenta la infor mación de recesivos y otras características genéticas importantes.
Tendré mis animales evaluados para todos los nuevos caracteres que se evalúen y de todos los índices que se publiquen, porque los genotipos estarán integrados en la base de datos de la Asociación.
Toda la infor mación se actualiza automáticamente en el CONAFEMAT y está disponible para usarla en cualquier programa de acoplamientos.
Puedo comparar el nivel de mis animales con el resto de la población a través de la infor mación que proporciona la Asociación.
Soy el dueño del genotipo


1ª 2ª 3ª 4ª 5ª 6ª 7ª 8ª 9ª 10ª 30€ Ser vicio de Genotipado Tlf.: 91 895 24 12 / 62 / 68 conafe@conafe.com / www.conafe.com j/a 226 Frisona Española 101



Aberekin .......................Int. Contraportada AFS 89 Albaitaritza - GenerVations ....................53 Anembe .....................................................83 Ascol ..........................................Int. Portada CL AS ..........................................................15 Concurso Nacional CONAFE’18 ................7 Curso de Podología CONAFE 2018 ...........41 DeLaval Equipos, S.A ......................70 y 71 Durán Maquinaria .........................................81 Embriovet .................................................95 Emporvet, S.L. ..........................................99 Gea Farm Technologies Ibérica, S L 91 Lallemand .................................................73 Lely ..................................................36 y 37 MGA ..........................................................67 Nanta .........................................................79 Nutricor 75 Setna .........................................................77 Valoración Genómica CONAFE ...............97 World Wide Sires España ...Contraportada Xenética Fontao .......................................23 Índice de Anunciantes





• Altísima fertilidad de sus hijas. • Alta longevidad y velocidad de ordeño.



? Disponible en: Prolonga la vida del semen hasta 48 horas Otros toros disponibles: www.aberekin.com/spermvital VIDA ÚTIL SEMEN CONVENCIONAL: 24 HORAS VIDA ÚTIL SEMEN SPERMVITAL: 48 HORAS Alta fertilidad Genética de Confianza www.aberekin.com
• Mucha leche con componentes. • Muy buenas patas y ubres. • Bajo recuento células somáticas.
Nissan Nº1 ICO LIBRE DE BRACHYSPINA
BEHI-ALDE NISSAN 6446 (BB-83) Coop. Behi-Alde - Aramaiona - Araba
Niagra x Oman x Convincer

La herencia de MODESTY Hnos. Falcó 4 Bajo. 02002 Albacete • Tel: 967 218 218 • Fax: 967 218 272 Email: wwsires@wwsires.es • www.wwsires.es • www.facebook.com/wwsires.es JUAN JOSE MARTÍNEZ Email: juanjo@wwsires.es • Móvil: 647.47.25.45 W ORLD WIDE SIRES ESPAÑA Excelentes hijos de MODESTY con: • Rentable Producción • Tipo Excelente • Fantástica Fertilidad de las Hijas • Alta TPI






































































 Lorenç Bosch 16 años (Baleares)
Miguel Rodríguez, 16 años (Córdoba)
Alberto Ríos, 12 años (Pontevedra)
Joxan Etxeberría, 13 años (Guipúzcoa)
Eduardo Ávila, 18 años (Toledo)
Hugo González, 15 años (Toledo)
Jon Vivanco, 17 años (Cantabria)
Aner Peñagaricano 14 años (Guipúzcoa)
Xubán Peñagaricano 15 años (Guipúzcoa)
Nerea Otza, 15 años (Cantabria)
David Pons, 18 años (Baleares)
Xabier Montes 11 años (Pontevedra) Pau Sabrià 14 años (Girona) 12 Frisona Española 226 j/a
Lluís Femenías, 20 años (Baleares)
Marcos Miyar, 16 años (Asturias)
María Mon, 15 años (Asturias)
Aida Moll 15 años (Baleares)
Alba Carreira, 20 años (A Coruña)
Lorenç Bosch 16 años (Baleares)
Miguel Rodríguez, 16 años (Córdoba)
Alberto Ríos, 12 años (Pontevedra)
Joxan Etxeberría, 13 años (Guipúzcoa)
Eduardo Ávila, 18 años (Toledo)
Hugo González, 15 años (Toledo)
Jon Vivanco, 17 años (Cantabria)
Aner Peñagaricano 14 años (Guipúzcoa)
Xubán Peñagaricano 15 años (Guipúzcoa)
Nerea Otza, 15 años (Cantabria)
David Pons, 18 años (Baleares)
Xabier Montes 11 años (Pontevedra) Pau Sabrià 14 años (Girona) 12 Frisona Española 226 j/a
Lluís Femenías, 20 años (Baleares)
Marcos Miyar, 16 años (Asturias)
María Mon, 15 años (Asturias)
Aida Moll 15 años (Baleares)
Alba Carreira, 20 años (A Coruña)















































 Tezanillos Braxton Toscana (S A T Tezanillos)
Llinde Ariel Jordan (S A T Ceceño)
Tezanillos Stanleycup Mirona (S A T Tezanillos)
Vaca Adulta Subcampeona y Vaca Gran Campeona Reserva
Vaca Inter media Campeona
Vaca Adulta Campeona, Vaca Gran Campeona Regional y Mejor Ubre
Ger mán de la Vega, Jesús Oria, Consejero de Medio Rural, Pesca y Alimentación de Cantabria y José Manuel Cruz, Alcalde de Torrelavega
Tezanillos Braxton Toscana (S A T Tezanillos)
Llinde Ariel Jordan (S A T Ceceño)
Tezanillos Stanleycup Mirona (S A T Tezanillos)
Vaca Adulta Subcampeona y Vaca Gran Campeona Reserva
Vaca Inter media Campeona
Vaca Adulta Campeona, Vaca Gran Campeona Regional y Mejor Ubre
Ger mán de la Vega, Jesús Oria, Consejero de Medio Rural, Pesca y Alimentación de Cantabria y José Manuel Cruz, Alcalde de Torrelavega




































































































 Ganadería Badiola (Asturias) Septiembre/Octubre 2017
La Novilla Gran Campeona Celis Andrea Bulería Atwood (Hnos Celis Gutiérrez, Cantabria) y la Vaca Gran Campeona, Badiola Atwood Koketa (Ganadería Badiola, Asturias)
Ganadería Badiola (Asturias) Septiembre/Octubre 2017
La Novilla Gran Campeona Celis Andrea Bulería Atwood (Hnos Celis Gutiérrez, Cantabria) y la Vaca Gran Campeona, Badiola Atwood Koketa (Ganadería Badiola, Asturias)